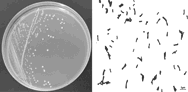

²Ä 34 ´Á
°Ó¼Ðªº«OÅ@
¤G¹s¤G¤¦~¤K¤ë¤G¤Q¤é¡A¬P´Á¤T
¸gÀ٤άì§Þµo®i§½
³q§i
°Ó¼Ðªº«OÅ@
N/234149 ... N/241930 - N/241932 ... N/242152
[210] ½s¸¹ : N/241932
[220] ¥Ó½Ð¤é : 2025/06/26
[730] ¥Ó½Ð¤H : Kerzner International Limited
¦a§} : Atlantis Paradise Island, Coral Towers Executive Office, Nassau, Bahamas
°êÄy : ¤Ú«¢°¨
¬¡°Ê : °Ó·~¤Î¤u·~
[511] Ãþ§O : 43
[511] ªA°È : Fornecimento de alojamento temporário; fornecimento de alojamento em hotéis; serviços hoteleiros; fornecimento de serviços de resort e alojamento; organização de alojamento em resorts; fornecimento de instalações e serviços para convenções; serviços de reserva de alojamento em hotéis; fornecimento de instalações (alojamento) para eventos e reuniões; fornecimento de instalações para convenções, fornecimento de instalações para eventos sociais e reuniões; serviços de agência de viagens, nomeadamente reservas e marcações para alojamento temporário; serviços de restaurante e bar; serviços de fornecimento de alimentos e bebidas; reservas e marcações para refeições.
[540] °Ó¼Ð :

[210] ½s¸¹ : N/241933
[220] ¥Ó½Ð¤é : 2025/06/26
[730] ¥Ó½Ð¤H : Kerzner International Limited
¦a§} : Atlantis Paradise Island, Coral Towers Executive Office, Nassau, Bahamas
°êÄy : ¤Ú«¢°¨
¬¡°Ê : °Ó·~¤Î¤u·~
[511] Ãþ§O : 44
[511] ªA°È : Serviços de estações termais/spa, nomeadamente, serviços de cuidados cosméticos do corpo; serviços de cabeleireiro; serviços de salão de beleza; serviços de spa de beleza, nomeadamente, cuidados cosméticos do corpo; reservas e marcações para terceiros para tratamentos em spas de saúde e salões de beleza; serviços de spa de saúde para a saúde e bem-estar do corpo e da mente; fornecimento de informações na área da saúde; fornecimento de informações na área dos spas de saúde destinados ao bem-estar e cuidados de beleza destinados ao bem-estar.
[540] °Ó¼Ð :

[210] ½s¸¹ : N/241934
[220] ¥Ó½Ð¤é : 2025/06/26
[730] ¥Ó½Ð¤H : Caesars License Company, LLC
¦a§} : One Caesars Palace Drive, Las Vegas, NV 89109, United States of America
°êÄy : ¬ü°ê
¬¡°Ê : °Ó·~¤Î¤u·~
[511] Ãþ§O : 35
[511] ªA°È : Publicidade; serviços de consultoria em administração de empresas e gestão de empresas; assistência na direção de negócios comerciais; consultoria em organização de negócios comerciais; gerência administrativa de hotéis e restaurantes; serviços de assistência às empresas fornecidos por hotéis; administração de hotéis; gestão de hotéis; consultoria em gestão hoteleira; promoção de produtos e serviços através de patrocínio eventos desportivos e de entretenimento; administração de um programa de prémios de incentivo que permite aos participantes obter descontos e prémios complementares em artigos e serviços através da inscrição como sócio; organização de programas de incentivo de sócio para fins comerciais ou publicitários; apresentação comercial de artigos e serviços relativos aos médios de comunicação, com fins de venda a retalho; preparação, organização e condução de exposições para fins de publicidade, comerciais ou de comércio; arrendamento e aluguer de espaço publicitário; arrendamento e aluguer de tempo de publicidade nos meios de comunicação; organização de concursos para fins publicitários; assistência na gestão industrial ou comercial; administração comercial para o licenciamento de bens e serviços para terceiros; promoção de vendas para terceiros; consultadoria em gestão de pessoal; serviços de relocalização para empresas; compilação de informação numa base de dados informática; compilação e atualização de catálogos de bens; processamento (administrativo) de ordens de compra; serviços de compras electrónicas; serviços de compras on-line; serviços de lojas de venda a retalho e de centro comercial; serviços de retalho relativos a ficheiros de imagens digitais descarregáveis autenticados por tokens não fungíveis (NFTs); disponibilização de um espaço de mercado online para compradores e vendedores de produtos e serviços; operação e administração de centros comerciais e de pontos de venda; contabilidade; aluguer de máquinas de venda automáticas.
[540] °Ó¼Ð :

[210] ½s¸¹ : N/241935
[220] ¥Ó½Ð¤é : 2025/06/26
[730] ¥Ó½Ð¤H : Caesars License Company, LLC
¦a§} : One Caesars Palace Drive, Las Vegas, NV 89109, United States of America
°êÄy : ¬ü°ê
¬¡°Ê : °Ó·~¤Î¤u·~
[511] Ãþ§O : 41
[511] ªA°È : Serviços de casino; serviços de jogo; serviços de jogos de fortuna ou azar; fornecimento de instalações para jogos de aposta e jogos; fornecimento de instalações para jogos de fortuna ou azar; fornecimento de instalações de casino (jogos de fortuna ou azar); jogo interactivo; fornecimento de um portal na Internet no sector de jogos de computador e jogos; serviços de entretenimento; serviços de entretenimento de televisão; organização e fornecimento de jogos e concursos para fins de entretenimento; fornecimento ambientes virtuais nos quais os usuários podem interagir através de jogos sociais para fins de recreação, lazer ou entretenimento; organização de entretenimento para celebrações de casamentos; organização e condução de espectáculos e eventos de entretenimento ao vivo; fornecimento de instalações para entretenimento; serviços de clube noturno (entretenimento); serviços de discotecas; cabarés; serviços de teatro e entretenimento apresentando música, dança, comédia, peças de teatro e magia; serviços de clubes de saúde; clubes recreativos e desportivos; clubes de praia e de piscinas; serviços de clube de golfe; fornecimento de instalações de golfe; organizando torneios de golfe; serviços de clubes sociais; fornecimento de instalações desportivas; serviços de parques de diversões; serviços de parques temáticos; salões de jogos; centros recreativos; reserva de espectáculos de música, comédia, dança, peças de teatro e magia; fornecimento de instalações para actividades recreativas; fornecimento de instalações para espectáculos de música, comédia, dança, peças de teatro e magia; organização e condução de provas de atletismo, concursos de atletismo e provas desportivas; organização e promoção de actividades e concursos desportivos; produção de programas de rádio e televisão; produção de vídeos, filmes, fitas de áudio e jogos e equipamentos electrónicos; fornecimento de publicações electrónicas; publicação de livros electrónicos e jornais on-line; fornecimento de informações online relacionadas com jogos de entretenimento; organização de corrida de cavalos; gestão de instalações desportivas e provas desportivas; fornecimento de instalações para educação física e ginástica; produção de espectáculos; reserva de bilhetes para espectáculos; serviços de agências de bilhetes para teatro; organização de reuniões e conferências; serviços de educação; prestação de formação e treino nos sectores de jogos de fortuna e azar, desporto e entretenimento; formação em gestão hoteleira; serviços de casino que caracterizam descontos e serviços gratuitos para clientes frequentes com o uso de um cartão de identificação; serviços de informação, consultoria e assessoria relacionados com os serviços acima referidos.
[540] °Ó¼Ð :

[210] ½s¸¹ : N/241936
[220] ¥Ó½Ð¤é : 2025/06/26
[730] ¥Ó½Ð¤H : Caesars License Company, LLC
¦a§} : One Caesars Palace Drive, Las Vegas, NV 89109, United States of America
°êÄy : ¬ü°ê
¬¡°Ê : °Ó·~¤Î¤u·~
[511] Ãþ§O : 43
[511] ªA°È : Alojamentos temporários; apartamentos com serviços domésticos; serviços de hotel, motel e estância turística (resort); serviços de pensões, casas de hóspedes; alojamentos de férias, pousadas e casas turísticas; residências de marca; serviços de acampamento de férias (alojamentos); lares para idosos; serviços de reservas para alojamento em hotéis, motéis e estâncias turísticas (resort); serviços de reservas para aluguer de alojamento temporário; serviços de reservas de alojamento de pensões, casas de hóspedes, férias, pousadas e casas turísticas; reserva de residências de marca e apartamentos com serviços domésticos; agência de alojamento temporário; serviços de clubes sociais (fornecimento de alojamento, comida e bebida); fornecimento de instalações e amenidades para reuniões, conferências, seminários, eventos especiais (casamentos, celebrações) e banquetes; fornecimento de instalações e amenidades para exposições; serviços de restaurante; preparação de alimentos e bebidas para fora (take-away); salas (bares) de cocktails; serviços de bar; salas de jantar temporárias; serviço de restaurante serve a si próprio; cafés; restaurantes de comida rápida; lojas de café; serviços de fornecimento de refeições (banquetes); cantinas de sirva-se a si próprio; infantários de dia; alojamento para animais; aluguer de quartos para realização banquetes, conferências, convenções, exposições, seminários e reuniões; aluguer de salas de reuniões; fornecimento de instalações de parques de campismo e aluguer de construções transportáveis; serviços de informação, consultoria e assessoria relacionados com os serviços acima referidos.
[540] °Ó¼Ð :

[210] ½s¸¹ : N/241946
[220] ¥Ó½Ð¤é : 2025/06/27
[730] ¥Ó½Ð¤H : °ê«°ÂåÃĦ³¤½¥q
¦a§} : ¿Dªù¬Ý¥xµó305-311¸¹»B»A¼s³õ1-4®y1¼ÓAF®y
°êÄy : ®Ú¾Ú¿Dªùªk¨Ò¦¨¥ß
¬¡°Ê : °Ó·~
[511] Ãþ§O : 3
[511] ²£«~ : ºëªo¡FÓ¤H¥Îºëªo¡F«DÂåÀø¥Î»ªo¡F«ö¼¯ªo¡F«ö¼¯»I¡C
[540] °Ó¼Ð :

[591] °Ó¼ÐÃC¦â : ¶À¡B¾í¶À¡B¾í¬õ¡B¶Â¡B¥Õ¦â¡A¦p¹Ï©Ò¥Ü¡C
[210] ½s¸¹ : N/241947
[220] ¥Ó½Ð¤é : 2025/06/27
[730] ¥Ó½Ð¤H : °ê«°ÂåÃĦ³¤½¥q
¦a§} : ¿Dªù¬Ý¥xµó305-311¸¹»B»A¼s³õ1-4®y1¼ÓAF®y
°êÄy : ®Ú¾Ú¿Dªùªk¨Ò¦¨¥ß
¬¡°Ê : °Ó·~
[511] Ãþ§O : 5
[511] ²£«~ : Ãľ¯¡F¯óÃÄ»s¾¯¡F¤¤ÂåÃİt¤è¡FÃĪo¡FÃĥγn»I¡F¤H¥ÎÃÄ¡FÃĪ«¶¼®Æ¡FÂå¥ÎÃĪ«¡FÂå¥ÎÃĤY¡FÃĥν¦Ån¡F¤¤ÃĦ¨ÃÄ¡FÂå¥ÎÀç¾i«~¡FÂå¥Î°·±d¹«~¡C
[540] °Ó¼Ð :

[591] °Ó¼ÐÃC¦â : ¶À¡B¾í¶À¡B¾í¬õ¡B¶Â¡B¥Õ¦â¡A¦p¹Ï©Ò¥Ü¡C
[210] ½s¸¹ : N/241948
[220] ¥Ó½Ð¤é : 2025/06/27
[730] ¥Ó½Ð¤H : °ê«°ÂåÃĦ³¤½¥q
¦a§} : ¿Dªù¬Ý¥xµó305-311¸¹»B»A¼s³õ1-4®y1¼ÓAF®y
°êÄy : ®Ú¾Ú¿Dªùªk¨Ò¦¨¥ß
¬¡°Ê : °Ó·~
[511] Ãþ§O : 30
[511] ²£«~ : «DÂå¥Î«O°·¹«~¡A«DÂå¥ÎÀç¾i¤fªA²G¡A«DÂå¥ÎÀç¾i«~¡A«DÂå¥ÎÀç¾i²G¡A«DÂå¥ÎÀç¾i¤ù¡A«DÂå¥ÎÀç¾i¯»¡A«DÂå¥ÎÀç¾i½¦Ån¡A«DÂå¥ÎÀç¾i»I¡A«DÂå¥ÎÀç¾iºë¡C
[540] °Ó¼Ð :

[591] °Ó¼ÐÃC¦â : ¶À¡B¾í¶À¡B¾í¬õ¡B¶Â¡B¥Õ¦â¡A¦p¹Ï©Ò¥Ü¡C
[210] ½s¸¹ : N/241949
[220] ¥Ó½Ð¤é : 2025/06/27
[730] ¥Ó½Ð¤H : °ê«°ÂåÃĦ³¤½¥q
¦a§} : ¿Dªù¬Ý¥xµó305-311¸¹»B»A¼s³õ1-4®y1¼ÓAF®y
°êÄy : ®Ú¾Ú¿Dªùªk¨Ò¦¨¥ß
¬¡°Ê : °Ó·~
[511] Ãþ§O : 3
[511] ²£«~ : ºëªo¡FÓ¤H¥Îºëªo¡F«DÂåÀø¥Î»ªo¡F«ö¼¯ªo¡F«ö¼¯»I¡C
[540] °Ó¼Ð :

[591] °Ó¼ÐÃC¦â : ¶Â¥Õ¦â¡A¦p¹Ï©Ò¥Ü¡C
[210] ½s¸¹ : N/241950
[220] ¥Ó½Ð¤é : 2025/06/27
[730] ¥Ó½Ð¤H : °ê«°ÂåÃĦ³¤½¥q
¦a§} : ¿Dªù¬Ý¥xµó305-311¸¹»B»A¼s³õ1-4®y1¼ÓAF®y
°êÄy : ®Ú¾Ú¿Dªùªk¨Ò¦¨¥ß
¬¡°Ê : °Ó·~
[511] Ãþ§O : 30
[511] ²£«~ : «DÂå¥Î«O°·¹«~¡A«DÂå¥ÎÀç¾i¤fªA²G¡A«DÂå¥ÎÀç¾i«~¡A«DÂå¥ÎÀç¾i²G¡A«DÂå¥ÎÀç¾i¤ù¡A«DÂå¥ÎÀç¾i¯»¡A«DÂå¥ÎÀç¾i½¦Ån¡A«DÂå¥ÎÀç¾i»I¡A«DÂå¥ÎÀç¾iºë¡C
[540] °Ó¼Ð :

[591] °Ó¼ÐÃC¦â : ¶Â¡B¥Õ¦â¡A¦p¹Ï©Ò¥Ü¡C
[210] ½s¸¹ : N/241951
[220] ¥Ó½Ð¤é : 2025/06/27
[730] ¥Ó½Ð¤H : °ê«°ÂåÃĦ³¤½¥q
¦a§} : ¿Dªù¬Ý¥xµó305-311¸¹»B»A¼s³õ1-4®y1¼ÓAF®y
°êÄy : ®Ú¾Ú¿Dªùªk¨Ò¦¨¥ß
¬¡°Ê : °Ó·~
[511] Ãþ§O : 3
[511] ²£«~ : ºëªo¡FÓ¤H¥Îºëªo¡F«DÂåÀø¥Î»ªo¡F«ö¼¯ªo¡F«ö¼¯»I¡C
[540] °Ó¼Ð :

[591] °Ó¼ÐÃC¦â : ¶Â¥Õ¦â¡A¦p¹Ï©Ò¥Ü¡C
[210] ½s¸¹ : N/241952
[220] ¥Ó½Ð¤é : 2025/06/27
[730] ¥Ó½Ð¤H : °ê«°ÂåÃĦ³¤½¥q
¦a§} : ¿Dªù¬Ý¥xµó305-311¸¹»B»A¼s³õ1-4®y1¼ÓAF®y
°êÄy : ®Ú¾Ú¿Dªùªk¨Ò¦¨¥ß
¬¡°Ê : °Ó·~
[511] Ãþ§O : 5
[511] ²£«~ : Ãľ¯¡F¯óÃÄ»s¾¯¡F¤¤ÂåÃİt¤è¡FÃĪo¡FÃĥγn»I¡F¤H¥ÎÃÄ¡FÃĪ«¶¼®Æ¡FÂå¥ÎÃĪ«¡FÂå¥ÎÃĤY¡FÃĥν¦Ån¡F¤¤ÃĦ¨ÃÄ¡FÂå¥ÎÀç¾i«~¡FÂå¥Î°·±d¹«~¡C
[540] °Ó¼Ð :

[591] °Ó¼ÐÃC¦â : ¶Â¥Õ¦â¡A¦p¹Ï©Ò¥Ü¡C
[210] ½s¸¹ : N/241953
[220] ¥Ó½Ð¤é : 2025/06/27
[730] ¥Ó½Ð¤H : °ê«°ÂåÃĦ³¤½¥q
¦a§} : ¿Dªù¬Ý¥xµó305-311¸¹»B»A¼s³õ1-4®y1¼ÓAF®y
°êÄy : ®Ú¾Ú¿Dªùªk¨Ò¦¨¥ß
¬¡°Ê : °Ó·~
[511] Ãþ§O : 5
[511] ²£«~ : Ãľ¯¡F¯óÃÄ»s¾¯¡F¤¤ÂåÃİt¤è¡FÃĪo¡FÃĥγn»I¡F¤H¥ÎÃÄ¡FÃĪ«¶¼®Æ¡FÂå¥ÎÃĪ«¡FÂå¥ÎÃĤY¡FÃĥν¦Ån¡F¤¤ÃĦ¨ÃÄ¡FÂå¥ÎÀç¾i«~¡FÂå¥Î°·±d¹«~¡C
[540] °Ó¼Ð :

[591] °Ó¼ÐÃC¦â : ¶Â¥Õ¦â¡A¦p¹Ï©Ò¥Ü¡C
[210] ½s¸¹ : N/241954
[220] ¥Ó½Ð¤é : 2025/06/27
[730] ¥Ó½Ð¤H : °ê«°ÂåÃĦ³¤½¥q
¦a§} : ¿Dªù¬Ý¥xµó305-311¸¹»B»A¼s³õ1-4®y1¼ÓAF®y
°êÄy : ®Ú¾Ú¿Dªùªk¨Ò¦¨¥ß
¬¡°Ê : °Ó·~
[511] Ãþ§O : 5
[511] ²£«~ : Ãľ¯¡F¯óÃÄ»s¾¯¡F¤¤ÂåÃİt¤è¡FÃĪo¡FÃĥγn»I¡F¤H¥ÎÃÄ¡FÃĪ«¶¼®Æ¡FÂå¥ÎÃĪ«¡FÂå¥ÎÃĤY¡FÃĥν¦Ån¡F¤¤ÃĦ¨ÃÄ¡FÂå¥ÎÀç¾i«~¡FÂå¥Î°·±d¹«~¡C
[540] °Ó¼Ð :

[591] °Ó¼ÐÃC¦â : ¶Â¥Õ¦â¡A¦p¹Ï©Ò¥Ü¡C
[210] ½s¸¹ : N/241955
[220] ¥Ó½Ð¤é : 2025/06/27
[730] ¥Ó½Ð¤H : °ê«°ÂåÃĦ³¤½¥q
¦a§} : ¿Dªù¬Ý¥xµó305-311¸¹»B»A¼s³õ1-4®y1¼ÓAF®y
°êÄy : ®Ú¾Ú¿Dªùªk¨Ò¦¨¥ß
¬¡°Ê : °Ó·~
[511] Ãþ§O : 5
[511] ²£«~ : Ãľ¯¡F¯óÃÄ»s¾¯¡F¤¤ÂåÃİt¤è¡FÃĪo¡FÃĥγn»I¡F¤H¥ÎÃÄ¡FÃĪ«¶¼®Æ¡FÂå¥ÎÃĪ«¡FÂå¥ÎÃĤY¡FÃĥν¦Ån¡F¤¤ÃĦ¨ÃÄ¡FÂå¥ÎÀç¾i«~¡FÂå¥Î°·±d¹«~¡C
[540] °Ó¼Ð :

[591] °Ó¼ÐÃC¦â : ¶Â¥Õ¦â¡A¦p¹Ï©Ò¥Ü¡C
[210] ½s¸¹ : N/241956
[220] ¥Ó½Ð¤é : 2025/06/27
[730] ¥Ó½Ð¤H : °ê«°ÂåÃĦ³¤½¥q
¦a§} : ¿Dªù¬Ý¥xµó305-311¸¹»B»A¼s³õ1-4®y1¼ÓAF®y
°êÄy : ®Ú¾Ú¿Dªùªk¨Ò¦¨¥ß
¬¡°Ê : °Ó·~
[511] Ãþ§O : 30
[511] ²£«~ : «DÂå¥Î«O°·¹«~¡A«DÂå¥ÎÀç¾i¤fªA²G¡A«DÂå¥ÎÀç¾i«~¡A«DÂå¥ÎÀç¾i²G¡A«DÂå¥ÎÀç¾i¤ù¡A«DÂå¥ÎÀç¾i¯»¡A«DÂå¥ÎÀç¾i½¦Ån¡A«DÂå¥ÎÀç¾i»I¡A«DÂå¥ÎÀç¾iºë¡C
[540] °Ó¼Ð :

[591] °Ó¼ÐÃC¦â : ¶Â¥Õ¦â¡A¦p¹Ï©Ò¥Ü¡C
[210] ½s¸¹ : N/241957
[220] ¥Ó½Ð¤é : 2025/06/27
[730] ¥Ó½Ð¤H : °ê«°ÂåÃĦ³¤½¥q
¦a§} : ¿Dªù¬Ý¥xµó305-311¸¹»B»A¼s³õ1-4®y1¼ÓAF®y
°êÄy : ®Ú¾Ú¿Dªùªk¨Ò¦¨¥ß
¬¡°Ê : °Ó·~
[511] Ãþ§O : 5
[511] ²£«~ : Ãľ¯¡F¯óÃÄ»s¾¯¡F¤¤ÂåÃİt¤è¡FÃĪo¡FÃĥγn»I¡F¤H¥ÎÃÄ¡FÃĪ«¶¼®Æ¡FÂå¥ÎÃĪ«¡FÂå¥ÎÃĤY¡FÃĥν¦Ån¡F¤¤ÃĦ¨ÃÄ¡FÂå¥ÎÀç¾i«~¡FÂå¥Î°·±d¹«~¡C
[540] °Ó¼Ð :

[591] °Ó¼ÐÃC¦â : ¶Â¥Õ¦â¡A¦p¹Ï©Ò¥Ü¡C
[210] ½s¸¹ : N/241958
[220] ¥Ó½Ð¤é : 2025/06/27
[730] ¥Ó½Ð¤H : °ê«°ÂåÃĦ³¤½¥q
¦a§} : ¿Dªù¬Ý¥xµó305-311¸¹»B»A¼s³õ1-4®y1¼ÓAF®y
°êÄy : ®Ú¾Ú¿Dªùªk¨Ò¦¨¥ß
¬¡°Ê : °Ó·~
[511] Ãþ§O : 5
[511] ²£«~ : Ãľ¯¡F¯óÃÄ»s¾¯¡F¤¤ÂåÃİt¤è¡FÃĪo¡FÃĥγn»I¡F¤H¥ÎÃÄ¡FÃĪ«¶¼®Æ¡FÂå¥ÎÃĪ«¡FÂå¥ÎÃĤY¡FÃĥν¦Ån¡F¤¤ÃĦ¨ÃÄ¡FÂå¥ÎÀç¾i«~¡FÂå¥Î°·±d¹«~¡C
[540] °Ó¼Ð :

[591] °Ó¼ÐÃC¦â : ¶Â¥Õ¦â¡A¦p¹Ï©Ò¥Ü¡C
[210] ½s¸¹ : N/241959
[220] ¥Ó½Ð¤é : 2025/06/27
[730] ¥Ó½Ð¤H : °ê«°ÂåÃĦ³¤½¥q
¦a§} : ¿Dªù¬Ý¥xµó305-311¸¹»B»A¼s³õ1-4®y1¼ÓAF®y
°êÄy : ®Ú¾Ú¿Dªùªk¨Ò¦¨¥ß
¬¡°Ê : °Ó·~
[511] Ãþ§O : 5
[511] ²£«~ : Ãľ¯¡F¯óÃÄ»s¾¯¡F¤¤ÂåÃİt¤è¡FÃĪo¡FÃĥγn»I¡F¤H¥ÎÃÄ¡FÃĪ«¶¼®Æ¡FÂå¥ÎÃĪ«¡FÂå¥ÎÃĤY¡FÃĥν¦Ån¡F¤¤ÃĦ¨ÃÄ¡FÂå¥ÎÀç¾i«~¡FÂå¥Î°·±d¹«~¡C
[540] °Ó¼Ð :

[591] °Ó¼ÐÃC¦â : ¶Â¥Õ¦â¡A¦p¹Ï©Ò¥Ü¡C
[210] ½s¸¹ : N/241960
[220] ¥Ó½Ð¤é : 2025/06/27
[730] ¥Ó½Ð¤H : °ê«°ÂåÃĦ³¤½¥q
¦a§} : ¿Dªù¬Ý¥xµó305-311¸¹»B»A¼s³õ1-4®y1¼ÓAF®y
°êÄy : ®Ú¾Ú¿Dªùªk¨Ò¦¨¥ß
¬¡°Ê : °Ó·~
[511] Ãþ§O : 5
[511] ²£«~ : Ãľ¯¡F¯óÃÄ»s¾¯¡F¤¤ÂåÃİt¤è¡FÃĪo¡FÃĥγn»I¡F¤H¥ÎÃÄ¡FÃĪ«¶¼®Æ¡FÂå¥ÎÃĪ«¡FÂå¥ÎÃĤY¡FÃĥν¦Ån¡F¤¤ÃĦ¨ÃÄ¡FÂå¥ÎÀç¾i«~¡FÂå¥Î°·±d¹«~¡C
[540] °Ó¼Ð :

[591] °Ó¼ÐÃC¦â : ¶Â¥Õ¦â¡A¦p¹Ï©Ò¥Ü¡C
[210] ½s¸¹ : N/241961
[220] ¥Ó½Ð¤é : 2025/06/27
[730] ¥Ó½Ð¤H : °ê«°ÂåÃĦ³¤½¥q
¦a§} : ¿Dªù¬Ý¥xµó305-311¸¹»B»A¼s³õ1-4®y1¼ÓAF®y
°êÄy : ®Ú¾Ú¿Dªùªk¨Ò¦¨¥ß
¬¡°Ê : °Ó·~
[511] Ãþ§O : 5
[511] ²£«~ : Ãľ¯¡F¯óÃÄ»s¾¯¡F¤¤ÂåÃİt¤è¡FÃĪo¡FÃĥγn»I¡F¤H¥ÎÃÄ¡FÃĪ«¶¼®Æ¡FÂå¥ÎÃĪ«¡FÂå¥ÎÃĤY¡FÃĥν¦Ån¡F¤¤ÃĦ¨ÃÄ¡FÂå¥ÎÀç¾i«~¡FÂå¥Î°·±d¹«~¡C
[540] °Ó¼Ð :

[591] °Ó¼ÐÃC¦â : ¶Â¥Õ¦â¡A¦p¹Ï©Ò¥Ü¡C
[210] ½s¸¹ : N/241962
[220] ¥Ó½Ð¤é : 2025/06/27
[730] ¥Ó½Ð¤H : °ê«°ÂåÃĦ³¤½¥q
¦a§} : ¿Dªù¬Ý¥xµó305-311¸¹»B»A¼s³õ1-4®y1¼ÓAF®y
°êÄy : ®Ú¾Ú¿Dªùªk¨Ò¦¨¥ß
¬¡°Ê : °Ó·~
[511] Ãþ§O : 5
[511] ²£«~ : Ãľ¯¡F¯óÃÄ»s¾¯¡F¤¤ÂåÃİt¤è¡FÃĪo¡FÃĥγn»I¡F¤H¥ÎÃÄ¡FÃĪ«¶¼®Æ¡FÂå¥ÎÃĪ«¡FÂå¥ÎÃĤY¡FÃĥν¦Ån¡F¤¤ÃĦ¨ÃÄ¡FÂå¥ÎÀç¾i«~¡FÂå¥Î°·±d¹«~¡C
[540] °Ó¼Ð :

[591] °Ó¼ÐÃC¦â : ¶Â¥Õ¦â¡A¦p¹Ï©Ò¥Ü¡C
[210] ½s¸¹ : N/241963
[220] ¥Ó½Ð¤é : 2025/06/27
[730] ¥Ó½Ð¤H : °ê«°ÂåÃĦ³¤½¥q
¦a§} : ¿Dªù¬Ý¥xµó305-311¸¹»B»A¼s³õ1-4®y1¼ÓAF®y
°êÄy : ®Ú¾Ú¿Dªùªk¨Ò¦¨¥ß
¬¡°Ê : °Ó·~
[511] Ãþ§O : 5
[511] ²£«~ : Ãľ¯¡F¯óÃÄ»s¾¯¡F¤¤ÂåÃİt¤è¡FÃĪo¡FÃĥγn»I¡F¤H¥ÎÃÄ¡FÃĪ«¶¼®Æ¡FÂå¥ÎÃĪ«¡FÂå¥ÎÃĤY¡FÃĥν¦Ån¡F¤¤ÃĦ¨ÃÄ¡FÂå¥ÎÀç¾i«~¡FÂå¥Î°·±d¹«~¡C
[540] °Ó¼Ð :

[591] °Ó¼ÐÃC¦â : ¶Â¥Õ¦â¡A¦p¹Ï©Ò¥Ü¡C
[210] ½s¸¹ : N/241964
[220] ¥Ó½Ð¤é : 2025/06/27
[730] ¥Ó½Ð¤H : °ê«°ÂåÃĦ³¤½¥q
¦a§} : ¿Dªù¬Ý¥xµó305-311¸¹»B»A¼s³õ1-4®y1¼ÓAF®y
°êÄy : ®Ú¾Ú¿Dªùªk¨Ò¦¨¥ß
¬¡°Ê : °Ó·~
[511] Ãþ§O : 5
[511] ²£«~ : Ãľ¯¡F¯óÃÄ»s¾¯¡F¤¤ÂåÃİt¤è¡FÃĪo¡FÃĥγn»I¡F¤H¥ÎÃÄ¡FÃĪ«¶¼®Æ¡FÂå¥ÎÃĪ«¡FÂå¥ÎÃĤY¡FÃĥν¦Ån¡F¤¤ÃĦ¨ÃÄ¡FÂå¥ÎÀç¾i«~¡FÂå¥Î°·±d¹«~¡C
[540] °Ó¼Ð :

[591] °Ó¼ÐÃC¦â : ¶Â¥Õ¦â¡A¦p¹Ï©Ò¥Ü¡C
[210] ½s¸¹ : N/241965
[220] ¥Ó½Ð¤é : 2025/06/27
[730] ¥Ó½Ð¤H : °ê«°ÂåÃĦ³¤½¥q
¦a§} : ¿Dªù¬Ý¥xµó305-311¸¹»B»A¼s³õ1-4®y1¼ÓAF®y
°êÄy : ®Ú¾Ú¿Dªùªk¨Ò¦¨¥ß
¬¡°Ê : °Ó·~
[511] Ãþ§O : 30
[511] ²£«~ : «DÂå¥Î«O°·¹«~¡A«DÂå¥ÎÀç¾i¤fªA²G¡A«DÂå¥ÎÀç¾i«~¡A«DÂå¥ÎÀç¾i²G¡A«DÂå¥ÎÀç¾i¤ù¡A«DÂå¥ÎÀç¾i¯»¡A«DÂå¥ÎÀç¾i½¦Ån¡A«DÂå¥ÎÀç¾i»I¡A«DÂå¥ÎÀç¾iºë¡C
[540] °Ó¼Ð :

[591] °Ó¼ÐÃC¦â : ¶Â¡B¥Õ¦â¡A¦p¹Ï©Ò¥Ü¡C
[210] ½s¸¹ : N/241966
[220] ¥Ó½Ð¤é : 2025/06/27
[730] ¥Ó½Ð¤H : YOHO¦W³Ó¥@¬É´ç°²§ø¦³¤½¥q
¦a§} : ¿Dªù´òÀظô12¸¹YOHOª÷»È®q¦W³Ó¥@¬É°s©±¿ì¤½¤j¼Ó16¼Ó
°êÄy : ®Ú¾Ú¿Dªùªk¨Ò¦¨¥ß
¬¡°Ê : °Ó·~
[511] Ãþ§O : 43
[511] ªA°È : ¦í©Ò¡]®ÈÀ]¡B¨Ñ¿¯±H±J³B¡^¡F³Æ¿ì®b®u¡F©@°ØÀ]¡F¦Û§UÀ\ÆU¡F´£¨Ñ³¥Àç³õ¦a³]¬I¡F´£¨ÑÀç¦a³]¬I¡FÀ\ÆU¡FÁ{®É¦í±J³B¥X¯²¡F±H±J³B¡F®È¹C©Ð«Î¥X¯²¡F¶º©±¡FÀ\À]¡F±H±J³B¹wq¡F®ÈÀ]¹wq¡F¦Û§UÀ\À]¡F§ÖÀ\À]¡F°s§a¡F°²¤é³¥Àç¦í±JªA°È¡F¬¡°Ê©Ð«Î¥X¯²¡F¹w©wÁ{®É¦í©Ò¡F¨T¨®®ÈÀ]¡F¥X¯²´È¤l¡B®à¤l¡B®à¥¬©M¬Á¼þ¾¹¥×¡F·|ij«Ç¥X¯²¡F±bÁO¥X¯²¡C
[540] °Ó¼Ð :

[591] °Ó¼ÐÃC¦â : ¦Ì¦â C8 M14 Y28 K0¡B¤g¶À¦â C18 M30 Y54 K0¡B°Ø¦â C38 M58 Y57 K0¡B¶Â¦â C91 M87 Y87 K78¡A¦p¹Ï©Ò¥Ü¡C
[210] ½s¸¹ : N/241967
[220] ¥Ó½Ð¤é : 2025/06/27
[730] ¥Ó½Ð¤H : YOHO¦W³Ó¥@¬É´ç°²§ø¦³¤½¥q
¦a§} : ¿Dªù´òÀظô12¸¹YOHOª÷»È®q¦W³Ó¥@¬É°s©±¿ì¤½¤j¼Ó16¼Ó
°êÄy : ®Ú¾Ú¿Dªùªk¨Ò¦¨¥ß
¬¡°Ê : °Ó·~
[511] Ãþ§O : 43
[511] ªA°È : ¦í©Ò¡]®ÈÀ]¡B¨Ñ¿¯±H±J³B¡^¡F³Æ¿ì®b®u¡F©@°ØÀ]¡F¦Û§UÀ\ÆU¡F´£¨Ñ³¥Àç³õ¦a³]¬I¡F´£¨ÑÀç¦a³]¬I¡FÀ\ÆU¡FÁ{®É¦í±J³B¥X¯²¡F±H±J³B¡F®È¹C©Ð«Î¥X¯²¡F¶º©±¡FÀ\À]¡F±H±J³B¹wq¡F®ÈÀ]¹wq¡F¦Û§UÀ\À]¡F§ÖÀ\À]¡F°s§a¡F°²¤é³¥Àç¦í±JªA°È¡F¬¡°Ê©Ð«Î¥X¯²¡F¹w©wÁ{®É¦í©Ò¡F¨T¨®®ÈÀ]¡F¥X¯²´È¤l¡B®à¤l¡B®à¥¬©M¬Á¼þ¾¹¥×¡F·|ij«Ç¥X¯²¡F±bÁO¥X¯²¡C
[540] °Ó¼Ð :

[591] °Ó¼ÐÃC¦â : ¦Ì¦â C8 M14 Y28 K0¡B¤g¶À¦â C18 M30 Y54 K0¡B°Ø¦â C38 M58 Y57 K0¡B¶Â¦â C91 M87 Y87 K78¡A¦p¹Ï©Ò¥Ü¡C
[210] ½s¸¹ : N/241968
[220] ¥Ó½Ð¤é : 2025/06/27
[730] ¥Ó½Ð¤H : YOHO¦W³Ó¥@¬É´ç°²§ø¦³¤½¥q
¦a§} : ¿Dªù´òÀظô12¸¹YOHOª÷»È®q¦W³Ó¥@¬É°s©±¿ì¤½¤j¼Ó16¼Ó
°êÄy : ®Ú¾Ú¿Dªùªk¨Ò¦¨¥ß
¬¡°Ê : °Ó·~
[511] Ãþ§O : 43
[511] ªA°È : ¦í©Ò¡]®ÈÀ]¡B¨Ñ¿¯±H±J³B¡^¡F³Æ¿ì®b®u¡F©@°ØÀ]¡F¦Û§UÀ\ÆU¡F´£¨Ñ³¥Àç³õ¦a³]¬I¡F´£¨ÑÀç¦a³]¬I¡FÀ\ÆU¡FÁ{®É¦í±J³B¥X¯²¡F±H±J³B¡F®È¹C©Ð«Î¥X¯²¡F¶º©±¡FÀ\À]¡F±H±J³B¹wq¡F®ÈÀ]¹wq¡F¦Û§UÀ\À]¡F§ÖÀ\À]¡F°s§a¡F°²¤é³¥Àç¦í±JªA°È¡F¬¡°Ê©Ð«Î¥X¯²¡F¹w©wÁ{®É¦í©Ò¡F¨T¨®®ÈÀ]¡F¥X¯²´È¤l¡B®à¤l¡B®à¥¬©M¬Á¼þ¾¹¥×¡F·|ij«Ç¥X¯²¡F±bÁO¥X¯²¡C
[540] °Ó¼Ð :

[591] °Ó¼ÐÃC¦â : ¦Ì¥Õ¦â C4 M7 Y16 K0¡B¦Ì¶À¦â C9 M17 Y33 K0¡B¤g¶À¦â C28 M45 Y78 K0¡B°Ø¦â C44 M67 Y96 K5¡B¬õ´Ä¦â C55 M96 Y99 K45¡B¶Â¦â C91 M87 Y87 K78¡A¦p¹Ï©Ò¥Ü¡C
[210] ½s¸¹ : N/241969
[220] ¥Ó½Ð¤é : 2025/06/27
[730] ¥Ó½Ð¤H : YOHO¦W³Ó¥@¬É´ç°²§ø¦³¤½¥q
¦a§} : ¿Dªù´òÀظô12¸¹YOHOª÷»È®q¦W³Ó¥@¬É°s©±¿ì¤½¤j¼Ó16¼Ó
°êÄy : ®Ú¾Ú¿Dªùªk¨Ò¦¨¥ß
¬¡°Ê : °Ó·~
[511] Ãþ§O : 43
[511] ªA°È : ¦í©Ò¡]®ÈÀ]¡B¨Ñ¿¯±H±J³B¡^¡F³Æ¿ì®b®u¡F©@°ØÀ]¡F¦Û§UÀ\ÆU¡F´£¨Ñ³¥Àç³õ¦a³]¬I¡F´£¨ÑÀç¦a³]¬I¡FÀ\ÆU¡FÁ{®É¦í±J³B¥X¯²¡F±H±J³B¡F®È¹C©Ð«Î¥X¯²¡F¶º©±¡FÀ\À]¡F±H±J³B¹wq¡F®ÈÀ]¹wq¡F¦Û§UÀ\À]¡F§ÖÀ\À]¡F°s§a¡F°²¤é³¥Àç¦í±JªA°È¡F¬¡°Ê©Ð«Î¥X¯²¡F¹w©wÁ{®É¦í©Ò¡F¨T¨®®ÈÀ]¡F¥X¯²´È¤l¡B®à¤l¡B®à¥¬©M¬Á¼þ¾¹¥×¡F·|ij«Ç¥X¯²¡F±bÁO¥X¯²¡C
[540] °Ó¼Ð :

[591] °Ó¼ÐÃC¦â : ¦Ì¥Õ¦â C4 M7 Y16 K0¡B¦Ì¶À¦â C9 M17 Y33 K0¡B¤g¶À¦â C28 M45 Y78 K0¡B°Ø¦â C44 M67 Y96 K5¡B¬õ´Ä¦â C55 M96 Y99 K45¡B¶Â¦â C91 M87 Y87 K78¡A¦p¹Ï©Ò¥Ü¡C
[210] ½s¸¹ : N/241970
[220] ¥Ó½Ð¤é : 2025/06/27
[730] ¥Ó½Ð¤H : YOHO¦W³Ó¥@¬É´ç°²§ø¦³¤½¥q
¦a§} : ¿Dªù´òÀظô12¸¹YOHOª÷»È®q¦W³Ó¥@¬É°s©±¿ì¤½¤j¼Ó16¼Ó
°êÄy : ®Ú¾Ú¿Dªùªk¨Ò¦¨¥ß
¬¡°Ê : °Ó·~
[511] Ãþ§O : 43
[511] ªA°È : ¦í©Ò¡]®ÈÀ]¡B¨Ñ¿¯±H±J³B¡^¡F³Æ¿ì®b®u¡F©@°ØÀ]¡F¦Û§UÀ\ÆU¡F´£¨Ñ³¥Àç³õ¦a³]¬I¡F´£¨ÑÀç¦a³]¬I¡FÀ\ÆU¡FÁ{®É¦í±J³B¥X¯²¡F±H±J³B¡F®È¹C©Ð«Î¥X¯²¡F¶º©±¡FÀ\À]¡F±H±J³B¹wq¡F®ÈÀ]¹wq¡F¦Û§UÀ\À]¡F§ÖÀ\À]¡F°s§a¡F°²¤é³¥Àç¦í±JªA°È¡F¬¡°Ê©Ð«Î¥X¯²¡F¹w©wÁ{®É¦í©Ò¡F¨T¨®®ÈÀ]¡F¥X¯²´È¤l¡B®à¤l¡B®à¥¬©M¬Á¼þ¾¹¥×¡F·|ij«Ç¥X¯²¡F±bÁO¥X¯²¡C
[540] °Ó¼Ð :

[591] °Ó¼ÐÃC¦â : ¦Ì¶À¦â C7 M13 Y33 K0¡B¤g¶À¦â C25 M39 Y75 K0¡B°Ø¦â C55 M64 Y91 K15¡BÀn«Ëºñ¦â C61 M63 Y91 K21¡B¶À¦Ç¦â C75 M72 Y82 K50¡B²`¦Ç¦â C87 M83 Y83 K72¡B¶À¦â C16 M30 Y76 K0¡B¾í¦â C23 M54 Y89 K0¡B¬õ´Ä¦â C52 M72 Y98 K24¡B²`°Ø¦â C66 M72 Y95 K44¡B¶Â¦â C91 M87 Y87 K78¡A¦p¹Ï©Ò¥Ü¡C
[210] ½s¸¹ : N/241971
[220] ¥Ó½Ð¤é : 2025/06/27
[730] ¥Ó½Ð¤H : YOHO¦W³Ó¥@¬É´ç°²§ø¦³¤½¥q
¦a§} : ¿Dªù´òÀظô12¸¹YOHOª÷»È®q¦W³Ó¥@¬É°s©±¿ì¤½¤j¼Ó16¼Ó
°êÄy : ®Ú¾Ú¿Dªùªk¨Ò¦¨¥ß
¬¡°Ê : °Ó·~
[511] Ãþ§O : 43
[511] ªA°È : ¦í©Ò¡]®ÈÀ]¡B¨Ñ¿¯±H±J³B¡^¡F³Æ¿ì®b®u¡F©@°ØÀ]¡F¦Û§UÀ\ÆU¡F´£¨Ñ³¥Àç³õ¦a³]¬I¡F´£¨ÑÀç¦a³]¬I¡FÀ\ÆU¡FÁ{®É¦í±J³B¥X¯²¡F±H±J³B¡F®È¹C©Ð«Î¥X¯²¡F¶º©±¡FÀ\À]¡F±H±J³B¹wq¡F®ÈÀ]¹wq¡F¦Û§UÀ\À]¡F§ÖÀ\À]¡F°s§a¡F°²¤é³¥Àç¦í±JªA°È¡F¬¡°Ê©Ð«Î¥X¯²¡F¹w©wÁ{®É¦í©Ò¡F¨T¨®®ÈÀ]¡F¥X¯²´È¤l¡B®à¤l¡B®à¥¬©M¬Á¼þ¾¹¥×¡F·|ij«Ç¥X¯²¡F±bÁO¥X¯²¡C
[540] °Ó¼Ð :

[591] °Ó¼ÐÃC¦â : ¦Ì¶À¦â C7 M13 Y33 K0¡B¤g¶À¦â C25 M39 Y75 K0¡B°Ø¦â C55 M64 Y91 K15¡BÀn«Ëºñ¦â C61 M63 Y91 K21¡B¶À¦Ç¦â C75 M72 Y82 K50¡B²`¦Ç¦â C87 M83 Y83 K72¡B¶À¦â C16 M30 Y76 K0¡B¾í¦â C23 M54 Y89 K0¡B¬õ´Ä¦â C52 M72 Y98 K24¡B²`°Ø¦â C66 M72 Y95 K44¡B¶Â¦â C91 M87 Y87 K78¡A¦p¹Ï©Ò¥Ü¡C
[210] ½s¸¹ : N/241972
[220] ¥Ó½Ð¤é : 2025/06/27
[730] ¥Ó½Ð¤H : °¢¦è»ñ¤¦¥¿¤¸¥Íª«¬ì§Þ¦³¤½¥q
¦a§} : ¤¤°ê°¢¦è¬Ù¦è¦w¥«°ª·s°ÏÀA·~¸ô32¸¹ÀA·~®É¥N4¼l3³æ¤¸25¼h32503¸¹
°êÄy : ¤¤°ê
¬¡°Ê : °Ó·~¤Î¤u·~
[511] Ãþ§O : 29
[511] ²£«~ : ¦×¡F³½¡]«D¬¡¡^¡F¦×ÅøÀY¡F¥[¤u¹Lªº¤ôªG¡F¥[¤u¹Lªº½µæ¡F³J¡F¨Å»s«~¡F¹¥Îªo¡F¥[¤u¹Lªº°íªG¡F°®¹¥Îµß¡C
[540] °Ó¼Ð :

[210] ½s¸¹ : N/241973
[220] ¥Ó½Ð¤é : 2025/06/27
[730] ¥Ó½Ð¤H : °¢¦è»ñ¤¦¥¿¤¸¥Íª«¬ì§Þ¦³¤½¥q
¦a§} : ¤¤°ê°¢¦è¬Ù¦è¦w¥«°ª·s°ÏÀA·~¸ô32¸¹ÀA·~®É¥N4¼l3³æ¤¸25¼h32503¸¹
°êÄy : ¤¤°ê
¬¡°Ê : °Ó·~¤Î¤u·~
[511] Ãþ§O : 30
[511] ²£«~ : ©@°Ø¡F¯ù¡F¿}¡F¸Á»e¡F¿|ÂI¡F¦×À`»æ¡F½\Ãþ»s«~¡FÄѱø¡F¹¥Î¾ý¯»¡F½Õ¨ý«~¡C
[540] °Ó¼Ð :

[210] ½s¸¹ : N/241974
[220] ¥Ó½Ð¤é : 2025/06/27
[730] ¥Ó½Ð¤H : °¢¦è»ñ¤¦¥¿¤¸¥Íª«¬ì§Þ¦³¤½¥q
¦a§} : ¤¤°ê°¢¦è¬Ù¦è¦w¥«°ª·s°ÏÀA·~¸ô32¸¹ÀA·~®É¥N4¼l3³æ¤¸25¼h32503¸¹
°êÄy : ¤¤°ê
¬¡°Ê : °Ó·~¤Î¤u·~
[511] Ãþ§O : 32
[511] ²£«~ : °à°s¡FµL°sºëªG¥Ä¶¼®Æ¡F½µæ¥Ä¡]¶¼®Æ¡^¡F¤ô¡]¶¼®Æ¡^¡FµL°sºë¶¼®Æ¡F´I§t³J¥Õ½èªº¹B°Ê¶¼®Æ¡F³n¶¼®Æ¡F¯à¶q¶¼®Æ¡F¨Å²M¶¼®Æ¡F»sµL°sºë¶¼®Æ¥Î°t®Æ¡C
[540] °Ó¼Ð :

[210] ½s¸¹ : N/241975
[220] ¥Ó½Ð¤é : 2025/06/27
[730] ¥Ó½Ð¤H : °¢¦è»ñ¤¦¥¿¤¸¥Íª«¬ì§Þ¦³¤½¥q
¦a§} : ¤¤°ê°¢¦è¬Ù¦è¦w¥«°ª·s°ÏÀA·~¸ô32¸¹ÀA·~®É¥N4¼l3³æ¤¸25¼h32503¸¹
°êÄy : ¤¤°ê
¬¡°Ê : °Ó·~¤Î¤u·~
[511] Ãþ§O : 35
[511] ªA°È : ¼s§i«Å¶Ç¡F¯S³\¸gÀ窺°Ó·~ºÞ²z¡F¶i¥X¤f¥N²z¡F¥«³õ¦æ¾P¡F¬°°Ó«~©MªA°Èªº¶R½æÂù¤è´£¨Ñ½u¤W¥«³õ¡F¤H¨ÆºÞ²z¿Ô¸ß¡F¹q¸£¸ê®Æ®w¸ê°T¨t²Î¤Æ¡F·|p¡F´M§äÃÙ§U¡FÃĥΡBÃ~Âå¥Î¡B½Ã¥Í¥Î»s¾¯©MÂåÀø¥Î«~ªº¹s°âªA°È¡C
[540] °Ó¼Ð :

[210] ½s¸¹ : N/241976
[220] ¥Ó½Ð¤é : 2025/06/27
[730] ¥Ó½Ð¤H : °¢¦è»ñ¤¦¥¿¤¸¥Íª«¬ì§Þ¦³¤½¥q
¦a§} : ¤¤°ê°¢¦è¬Ù¦è¦w¥«°ª·s°ÏÀA·~¸ô32¸¹ÀA·~®É¥N4¼l3³æ¤¸25¼h32503¸¹
°êÄy : ¤¤°ê
¬¡°Ê : °Ó·~¤Î¤u·~
[511] Ãþ§O : 29
[511] ²£«~ : ¦×¡F³½¡]«D¬¡¡^¡F¦×ÅøÀY¡F¥[¤u¹Lªº¤ôªG¡F¥[¤u¹Lªº½µæ¡F³J¡F¨Å»s«~¡F¹¥Îªo¡F¥[¤u¹Lªº°íªG¡F°®¹¥Îµß¡C
[540] °Ó¼Ð :

[210] ½s¸¹ : N/241977
[220] ¥Ó½Ð¤é : 2025/06/27
[730] ¥Ó½Ð¤H : °¢¦è»ñ¤¦¥¿¤¸¥Íª«¬ì§Þ¦³¤½¥q
¦a§} : ¤¤°ê°¢¦è¬Ù¦è¦w¥«°ª·s°ÏÀA·~¸ô32¸¹ÀA·~®É¥N4¼l3³æ¤¸25¼h32503¸¹
°êÄy : ¤¤°ê
¬¡°Ê : °Ó·~¤Î¤u·~
[511] Ãþ§O : 30
[511] ²£«~ : ©@°Ø¡F¯ù¡F¿}¡F¸Á»e¡F¿|ÂI¡F¦×À`»æ¡F½\Ãþ»s«~¡FÄѱø¡F¹¥Î¾ý¯»¡F½Õ¨ý«~¡C
[540] °Ó¼Ð :

[210] ½s¸¹ : N/241978
[220] ¥Ó½Ð¤é : 2025/06/27
[730] ¥Ó½Ð¤H : °¢¦è»ñ¤¦¥¿¤¸¥Íª«¬ì§Þ¦³¤½¥q
¦a§} : ¤¤°ê°¢¦è¬Ù¦è¦w¥«°ª·s°ÏÀA·~¸ô32¸¹ÀA·~®É¥N4¼l3³æ¤¸25¼h32503¸¹
°êÄy : ¤¤°ê
¬¡°Ê : °Ó·~¤Î¤u·~
[511] Ãþ§O : 32
[511] ²£«~ : °à°s¡FµL°sºëªG¥Ä¶¼®Æ¡F½µæ¥Ä¡]¶¼®Æ¡^¡F¤ô¡]¶¼®Æ¡^¡FµL°sºë¶¼®Æ¡F´I§t³J¥Õ½èªº¹B°Ê¶¼®Æ¡F³n¶¼®Æ¡F¯à¶q¶¼®Æ¡F¨Å²M¶¼®Æ¡F»sµL°sºë¶¼®Æ¥Î°t®Æ¡C
[540] °Ó¼Ð :

[210] ½s¸¹ : N/241979
[220] ¥Ó½Ð¤é : 2025/06/27
[730] ¥Ó½Ð¤H : °¢¦è»ñ¤¦¥¿¤¸¥Íª«¬ì§Þ¦³¤½¥q
¦a§} : ¤¤°ê°¢¦è¬Ù¦è¦w¥«°ª·s°ÏÀA·~¸ô32¸¹ÀA·~®É¥N4¼l3³æ¤¸25¼h32503¸¹
°êÄy : ¤¤°ê
¬¡°Ê : °Ó·~¤Î¤u·~
[511] Ãþ§O : 35
[511] ªA°È : ¼s§i«Å¶Ç¡F¯S³\¸gÀ窺°Ó·~ºÞ²z¡F¶i¥X¤f¥N²z¡F¥«³õ¦æ¾P¡F¬°°Ó«~©MªA°Èªº¶R½æÂù¤è´£¨Ñ½u¤W¥«³õ¡F¤H¨ÆºÞ²z¿Ô¸ß¡F¹q¸£¸ê®Æ®w¸ê°T¨t²Î¤Æ¡F·|p¡F´M§äÃÙ§U¡FÃĥΡBÃ~Âå¥Î¡B½Ã¥Í¥Î»s¾¯©MÂåÀø¥Î«~ªº¹s°âªA°È¡C
[540] °Ó¼Ð :

[210] ½s¸¹ : N/241980
[220] ¥Ó½Ð¤é : 2025/06/27
[730] ¥Ó½Ð¤H : ¤W®ü¸¬ì§ë¸ê¦³¤½¥q
¦a§} : ¤¤°ê¤W®ü¥«ªQ¦¿°Ï¼s´IªLªF¸ô555¸¹1¼l7¼Ó
°êÄy : ¤¤°ê
¬¡°Ê : °Ó·~¤Î¤u·~
[511] Ãþ§O : 3
[511] ²£«~ : «cލm¡F¬~¾v²G¡F¬~¦ç¾¯¡F²M¼ä»s¾¯¡F¿i«c¤M¥Ö±a¥Î³n»I¡F¬ã¿i§÷®Æ¡F»ºëªo¡FÄGŽ¥ÎÄú¡F«cŽ«á¥Î²G¡F¤ú»I¡C
[540] °Ó¼Ð :

[210] ½s¸¹ : N/241981
[220] ¥Ó½Ð¤é : 2025/06/27
[730] ¥Ó½Ð¤H : ¤W®ü¸¬ì§ë¸ê¦³¤½¥q
¦a§} : ¤¤°ê¤W®ü¥«ªQ¦¿°Ï¼s´IªLªF¸ô555¸¹1¼l7¼Ó
°êÄy : ¤¤°ê
¬¡°Ê : °Ó·~¤Î¤u·~
[511] Ãþ§O : 7
[511] ²£«~ : ¯uªÅ§l¹Ð¾¹¡FµL÷¹q°Ê±½¦a¾÷¡F¼p©Ð¥Î¹q°Ê¾÷¾¹¡F¹q°Ê½V¿i¾÷¡F¹q°Êº^¥Ä¾÷¡FÅͩվ÷¡F²V¦X¾÷¡]¾÷¾¹¡^¡F¬~¸J¾÷¡F»s¹«~¥Î¹q°Ê¾÷±ñ¡F«D³°¦a¨®½ø¥Î¹q°Ê¾÷¡C
[540] °Ó¼Ð :

[210] ½s¸¹ : N/241982
[220] ¥Ó½Ð¤é : 2025/06/27
[730] ¥Ó½Ð¤H : ¤W®ü¸¬ì§ë¸ê¦³¤½¥q
¦a§} : ¤¤°ê¤W®ü¥«ªQ¦¿°Ï¼s´IªLªF¸ô555¸¹1¼l7¼Ó
°êÄy : ¤¤°ê
¬¡°Ê : °Ó·~¤Î¤u·~
[511] Ãþ§O : 8
[511] ²£«~ : ¹q°Ê©Î«D¹q°Ê¨íÄG¤M¡F¹q°Ê©M«D¹q°Ê²æ¤ò¾¹¡F¹q°Ê»ó¤òװž¹¡FÓ¤H¥Î²z¾v±À¤l¡]¹q°Ê©M«D¹q°Ê¡^¡F¨íÄG¤M¤ù¡F¨÷¾v¥Î¤â¤u¨ã¡F²z¾v°Å¤M¡F«D¹q°Ê׬ܾ¹¡Fª½¾v§¨ªO¡F¼÷¤æ¡F¿S¾v¹X¡F¿S¾v¥ÎÅK§¨¡F׫ü¥Ò¤u¨ã¡F¤â°Êªº¤â¤u¨ã¡F«cޤM¡C
[540] °Ó¼Ð :

[210] ½s¸¹ : N/241983
[220] ¥Ó½Ð¤é : 2025/06/27
[730] ¥Ó½Ð¤H : ¤W®ü¸¬ì§ë¸ê¦³¤½¥q
¦a§} : ¤¤°ê¤W®ü¥«ªQ¦¿°Ï¼s´IªLªF¸ô555¸¹1¼l7¼Ó
°êÄy : ¤¤°ê
¬¡°Ê : °Ó·~¤Î¤u·~
[511] Ãþ§O : 9
[511] ²£«~ : ¯¯¡FÅ髯¯¡F«KÄ⦡¼Æ¦r¹q¤l¯¯¡F¼p©Ð¥Î¹q¤l¯¯¡F±a¨Åé½è¶q¤ÀªR»öªº¯¯¡F®a¥ÎÅé¯×¯¯¡FUSB½u¡F¹q½u¡F¹q¶}Ãö¡F´¡½uªO¡F¹q¬yÂà´«¾¹¡F¹q·½¾A°t¾¹¡FUSB¥R¹q¾¹¡F»»±±¸Ë¸m¡F®a¥Î»»±±¾¹¡F¹q¤OÂà´«¾¹¡F²¾°Ê¹q·½¡]¥i¥R¹q¹q¦À¡^¡F¹q¦À¡F¹q¦À¥R¹q¾¹¡F¤â¾÷¥R¹q¾¹¡FµL½u¥R¹q¾¹¡F«KÄ⦡¥R¹q¾¹¡C
[540] °Ó¼Ð :

[210] ½s¸¹ : N/241984
[220] ¥Ó½Ð¤é : 2025/06/27
[730] ¥Ó½Ð¤H : ¤W®ü¸¬ì§ë¸ê¦³¤½¥q
¦a§} : ¤¤°ê¤W®ü¥«ªQ¦¿°Ï¼s´IªLªF¸ô555¸¹1¼l7¼Ó
°êÄy : ¤¤°ê
¬¡°Ê : °Ó·~¤Î¤u·~
[511] Ãþ§O : 10
[511] ²£«~ : «ö¼¯¾¹±ñ¡F®¶°Ê«ö¼¯¾¹¡F¦åÀ£p¡F脉·ip¡FÂå¥ÎÅé·Åp¡F¦å¿}»ö¡F§UÅ¥¾¹¡F«õ¦Õ¤c¡F´Ó¾v¥Î¤ò¾v¡F¹qÀø¾¹±ñ¡C
[540] °Ó¼Ð :

[210] ½s¸¹ : N/241985
[220] ¥Ó½Ð¤é : 2025/06/27
[730] ¥Ó½Ð¤H : ¤W®ü¸¬ì§ë¸ê¦³¤½¥q
¦a§} : ¤¤°ê¤W®ü¥«ªQ¦¿°Ï¼s´IªLªF¸ô555¸¹1¼l7¼Ó
°êÄy : ¤¤°ê
¬¡°Ê : °Ó·~¤Î¤u·~
[511] Ãþ§O : 11
[511] ²£«~ : ²O¯D¼ö¤ô¾¹¡F·LªiÄl¡]¼p©Ð¥Î¨ã¡^¡F¦B½c¡F¼p©Ð¥Î©âªo·Ï¾÷¡FÀY¾v¥Î§j·¾÷¡F·®°¡]ªÅ®ð½Õ¸`¡^¡FªÅ®ð½Õ¸`¸Ë¸m¡FªÅ®ð½Õ¸`³]³Æ¡F¤ô²b¤Æ³]³Æ©M¾÷¾¹¡F²i½Õ¥Î¸Ë¸m©M³]³Æ¡F¶¼¤ô¾÷¡F¹q¶ºÞs¡F¹qÀ£¤OÁç¡]°ªÀ£Áç¡^¡F¹q»]Áç¡F²i¶¹¯N½c¡F¹q¼ö¤ô³ý¡F¹q©@°Ø¾÷¡F¯NÄÑ¥]¾÷¡F´ª«»]¨T±¾¿S¾÷¡C
[540] °Ó¼Ð :

[210] ½s¸¹ : N/241986
[220] ¥Ó½Ð¤é : 2025/06/27
[730] ¥Ó½Ð¤H : ¤W®ü¸¬ì§ë¸ê¦³¤½¥q
¦a§} : ¤¤°ê¤W®ü¥«ªQ¦¿°Ï¼s´IªLªF¸ô555¸¹1¼l7¼Ó
°êÄy : ¤¤°ê
¬¡°Ê : °Ó·~¤Î¤u·~
[511] Ãþ§O : 21
[511] ²£«~ : ¼p©Ð¥Î¨ã¡F¦çªA¼÷¤æÀÁ¬[¡F®Þ¡F¨ê¤l¡F¤Æ§©¥Î¨ã¡F¤ò²y¥h°£¾¹¡]¹q°Ê©Î«D¹q°Ê¡^¡F¤ú¨ê¡F¹q°Ê¤ú¨ê¡F¦ÞÀY²M¼ä¨ê¡F¹q°Ê¤ú¨ê´À´«ÀY¡F¤ú¤Î¤ú§É²M¼ä¥Î§l¤ô¾¹¡F¤ô¤ú½u¡C
[540] °Ó¼Ð :

[210] ½s¸¹ : N/241987
[220] ¥Ó½Ð¤é : 2025/06/27
[730] ¥Ó½Ð¤H : ¤W®ü¸¬ì§ë¸ê¦³¤½¥q
¦a§} : ¤¤°ê¤W®ü¥«ªQ¦¿°Ï¼s´IªLªF¸ô555¸¹1¼l7¼Ó
°êÄy : ¤¤°ê
¬¡°Ê : °Ó·~¤Î¤u·~
[511] Ãþ§O : 3
[511] ²£«~ : «cލm¡F¬~¾v²G¡F¬~¦ç¾¯¡F²M¼ä»s¾¯¡F¿i«c¤M¥Ö±a¥Î³n»I¡F¬ã¿i§÷®Æ¡F»ºëªo¡FÄGŽ¥ÎÄú¡F«cŽ«á¥Î²G¡F¤ú»I¡C
[540] °Ó¼Ð :

[210] ½s¸¹ : N/241988
[220] ¥Ó½Ð¤é : 2025/06/27
[730] ¥Ó½Ð¤H : ¤W®ü¸¬ì§ë¸ê¦³¤½¥q
¦a§} : ¤¤°ê¤W®ü¥«ªQ¦¿°Ï¼s´IªLªF¸ô555¸¹1¼l7¼Ó
°êÄy : ¤¤°ê
¬¡°Ê : °Ó·~¤Î¤u·~
[511] Ãþ§O : 7
[511] ²£«~ : ¯uªÅ§l¹Ð¾¹¡FµL÷¹q°Ê±½¦a¾÷¡F¼p©Ð¥Î¹q°Ê¾÷¾¹¡F¹q°Ê½V¿i¾÷¡F¹q°Êº^¥Ä¾÷¡FÅͩվ÷¡F²V¦X¾÷¡]¾÷¾¹¡^¡F¬~¸J¾÷¡F»s¹«~¥Î¹q°Ê¾÷±ñ¡F«D³°¦a¨®½ø¥Î¹q°Ê¾÷¡C
[540] °Ó¼Ð :

[210] ½s¸¹ : N/241989
[220] ¥Ó½Ð¤é : 2025/06/27
[730] ¥Ó½Ð¤H : ¤W®ü¸¬ì§ë¸ê¦³¤½¥q
¦a§} : ¤¤°ê¤W®ü¥«ªQ¦¿°Ï¼s´IªLªF¸ô555¸¹1¼l7¼Ó
°êÄy : ¤¤°ê
¬¡°Ê : °Ó·~¤Î¤u·~
[511] Ãþ§O : 8
[511] ²£«~ : ¹q°Ê©Î«D¹q°Ê¨íÄG¤M¡F¹q°Ê©M«D¹q°Ê²æ¤ò¾¹¡F¹q°Ê»ó¤òװž¹¡FÓ¤H¥Î²z¾v±À¤l¡]¹q°Ê©M«D¹q°Ê¡^¡F¨íÄG¤M¤ù¡F¨÷¾v¥Î¤â¤u¨ã¡F²z¾v°Å¤M¡F«D¹q°Ê׬ܾ¹¡Fª½¾v§¨ªO¡F¼÷¤æ¡F¿S¾v¹X¡F¿S¾v¥ÎÅK§¨¡F׫ü¥Ò¤u¨ã¡F¤â°Êªº¤â¤u¨ã¡F«cޤM¡C
[540] °Ó¼Ð :

[210] ½s¸¹ : N/241990
[220] ¥Ó½Ð¤é : 2025/06/27
[730] ¥Ó½Ð¤H : ¤W®ü¸¬ì§ë¸ê¦³¤½¥q
¦a§} : ¤¤°ê¤W®ü¥«ªQ¦¿°Ï¼s´IªLªF¸ô555¸¹1¼l7¼Ó
°êÄy : ¤¤°ê
¬¡°Ê : °Ó·~¤Î¤u·~
[511] Ãþ§O : 9
[511] ²£«~ : ¯¯¡FÅ髯¯¡F«KÄ⦡¼Æ¦r¹q¤l¯¯¡F¼p©Ð¥Î¹q¤l¯¯¡F±a¨Åé½è¶q¤ÀªR»öªº¯¯¡F®a¥ÎÅé¯×¯¯¡FUSB½u¡F¹q½u¡F¹q¶}Ãö¡F´¡½uªO¡F¹q¬yÂà´«¾¹¡F¹q·½¾A°t¾¹¡FUSB¥R¹q¾¹¡F»»±±¸Ë¸m¡F®a¥Î»»±±¾¹¡F¹q¤OÂà´«¾¹¡F²¾°Ê¹q·½¡]¥i¥R¹q¹q¦À¡^¡F¹q¦À¡F¹q¦À¥R¹q¾¹¡F¤â¾÷¥R¹q¾¹¡FµL½u¥R¹q¾¹¡F«KÄ⦡¥R¹q¾¹¡C
[540] °Ó¼Ð :

[210] ½s¸¹ : N/241991
[220] ¥Ó½Ð¤é : 2025/06/27
[730] ¥Ó½Ð¤H : ¤W®ü¸¬ì§ë¸ê¦³¤½¥q
¦a§} : ¤¤°ê¤W®ü¥«ªQ¦¿°Ï¼s´IªLªF¸ô555¸¹1¼l7¼Ó
°êÄy : ¤¤°ê
¬¡°Ê : °Ó·~¤Î¤u·~
[511] Ãþ§O : 10
[511] ²£«~ : «ö¼¯¾¹±ñ¡F®¶°Ê«ö¼¯¾¹¡F¦åÀ£p¡F脉·ip¡FÂå¥ÎÅé·Åp¡F¦å¿}»ö¡F§UÅ¥¾¹¡F«õ¦Õ¤c¡F´Ó¾v¥Î¤ò¾v¡F¹qÀø¾¹±ñ¡C
[540] °Ó¼Ð :

[210] ½s¸¹ : N/241992
[220] ¥Ó½Ð¤é : 2025/06/27
[730] ¥Ó½Ð¤H : ¤W®ü¸¬ì§ë¸ê¦³¤½¥q
¦a§} : ¤¤°ê¤W®ü¥«ªQ¦¿°Ï¼s´IªLªF¸ô555¸¹1¼l7¼Ó
°êÄy : ¤¤°ê
¬¡°Ê : °Ó·~¤Î¤u·~
[511] Ãþ§O : 11
[511] ²£«~ : ²O¯D¼ö¤ô¾¹¡F·LªiÄl¡]¼p©Ð¥Î¨ã¡^¡F¦B½c¡F¼p©Ð¥Î©âªo·Ï¾÷¡FÀY¾v¥Î§j·¾÷¡F·®°¡]ªÅ®ð½Õ¸`¡^¡FªÅ®ð½Õ¸`¸Ë¸m¡FªÅ®ð½Õ¸`³]³Æ¡F¤ô²b¤Æ³]³Æ©M¾÷¾¹¡F²i½Õ¥Î¸Ë¸m©M³]³Æ¡F¶¼¤ô¾÷¡F¹q¶ºÞs¡F¹qÀ£¤OÁç¡]°ªÀ£Áç¡^¡F¹q»]Áç¡F²i¶¹¯N½c¡F¹q¼ö¤ô³ý¡F¹q©@°Ø¾÷¡F¯NÄÑ¥]¾÷¡F´ª«»]¨T±¾¿S¾÷¡C
[540] °Ó¼Ð :

[210] ½s¸¹ : N/241993
[220] ¥Ó½Ð¤é : 2025/06/27
[730] ¥Ó½Ð¤H : ¤W®ü¸¬ì§ë¸ê¦³¤½¥q
¦a§} : ¤¤°ê¤W®ü¥«ªQ¦¿°Ï¼s´IªLªF¸ô555¸¹1¼l7¼Ó
°êÄy : ¤¤°ê
¬¡°Ê : °Ó·~¤Î¤u·~
[511] Ãþ§O : 21
[511] ²£«~ : ¼p©Ð¥Î¨ã¡F¦çªA¼÷¤æÀÁ¬[¡F®Þ¡F¨ê¤l¡F¤Æ§©¥Î¨ã¡F¤ò²y¥h°£¾¹¡]¹q°Ê©Î«D¹q°Ê¡^¡F¤ú¨ê¡F¹q°Ê¤ú¨ê¡F¦ÞÀY²M¼ä¨ê¡F¹q°Ê¤ú¨ê´À´«ÀY¡F¤ú¤Î¤ú§É²M¼ä¥Î§l¤ô¾¹¡F¤ô¤ú½u¡C
[540] °Ó¼Ð :

[210] ½s¸¹ : N/241994
[220] ¥Ó½Ð¤é : 2025/06/27
[730] ¥Ó½Ð¤H : ¼s¦{ºq¬¥Íº¥Íª«¬ì§Þ¦³¤½¥q
¦a§} : ¤¤°ê¼sªF¬Ù¼s¦{¥«ªá³£°Ï·sµØµó¯¸«e¸ô26¸¹¼C¿³°Ó°È¤¤¤ß322«Ç
°êÄy : ¤¤°ê
¬¡°Ê : °Ó·~¤Î¤u·~
[511] Ãþ§O : 3
[511] ²£«~ : ¼ä½§¨Å²G¡F²M¼ä»s¾¯¡F©ß¥ú»s¾¯¡F¬ã¿i¾¯¡F¤Æ§©«~¥Î»®Æ¡F¤Æ§©«~¡F¤f®ð²M·s¼QÃú¡F»®Æ¡F°Êª«¥Î¤Æ§©«~¡FªÅ®ðªÚ»¾¯¡C
[540] °Ó¼Ð :

[210] ½s¸¹ : N/241995
[220] ¥Ó½Ð¤é : 2025/06/27
[730] ¥Ó½Ð¤H : ÃÓ¿³´f
¦a§} : ¥|¤t¬Ù¦¨³£¥«×¦¹Îµ²Âí¥Õ°¨§ø4²Õ89¸¹
°êÄy : ¤¤°ê
¬¡°Ê : °Ó·~
[511] Ãþ§O : 30
[511] ²£«~ : »¶´Ôªo¡F½Õ¨ýÂæ¥Ä¡F»Ä»¶ªwµæ¡]½Õ¨ý«~¡^¡F¨§Âæ¡]½Õ¨ý«~¡^¡F½Õ¨ý®Æ¡F¡]¦L«×¦¡¡^»Ä»¶Âæ¡]½Õ¨ý«~¡^¡F½Õ¨ýÂæ¡F»¶´Ô¡]½Õ¨ý«~¡^¡F»¶´Ô¯»¡F½Õ¨ý«~¡C
[540] °Ó¼Ð :

[210] ½s¸¹ : N/242000
[220] ¥Ó½Ð¤é : 2025/06/27
[730] ¥Ó½Ð¤H : ALIKA CO., LTD.
¦a§} : 8, Hannam-daero 40-gil, Yongsan-gu, Seoul, Republic of Korea
°êÄy : Áú°ê
¬¡°Ê : °Ó·~¤Î¤u·~
[511] Ãþ§O : 3
[511] ²£«~ : Cosméticos; produtos cosméticos para crianças; perfumes; champôs; preparações sem ser para fim medicinais destinadas ao cuidado da pele, do cabelo e do couro cabeludo; pasta de dentes; detergentes para uso doméstico; preparações para o banho, não sendo para fins medicinais; máscaras faciais; discos de limpeza impregnados de cosméticos, lenços pré-humedecidos para cosméticos; panos ou lenços de papel impregnados com um produto de limpeza da pele.
[540] °Ó¼Ð :

[210] ½s¸¹ : N/242001
[220] ¥Ó½Ð¤é : 2025/06/27
[730] ¥Ó½Ð¤H : ALIKA CO., LTD.
¦a§} : 8, Hannam-daero 40-gil, Yongsan-gu, Seoul, Republic of Korea
°êÄy : Áú°ê
¬¡°Ê : °Ó·~¤Î¤u·~
[511] Ãþ§O : 14
[511] ²£«~ : Porta-chaves em pele; ornamentos para sapatos em metais preciosos; brincos em metais preciosos; jóias de metais preciosos; estátuas em metais preciosos; colares como jóias; anéis como jóias; jóias e metais preciosos; broches como jóias; relógios de pulso e suas partes.
[540] °Ó¼Ð :

[210] ½s¸¹ : N/242002
[220] ¥Ó½Ð¤é : 2025/06/27
[730] ¥Ó½Ð¤H : ALIKA CO., LTD.
¦a§} : 8, Hannam-daero 40-gil, Yongsan-gu, Seoul, Republic of Korea
°êÄy : Áú°ê
¬¡°Ê : °Ó·~¤Î¤u·~
[511] Ãþ§O : 18
[511] ²£«~ : Sacos; porta-cartões de visita; mochilas; sacos de praia; pastas [malas]; porta-moedas pequenos; malas de viagem; chapéus-de-sol [sombrinhas]; sacos de viagem; baús de viagem; porta-chaves; chapéus-de-chuva; arneses para bebés; imitações de couro; carteiras; carteiras para cartões [estojos para cartões]; estojos para bilhetes [de couro]; mochilas escolares; malas de mão; bolsas de cintura.
[540] °Ó¼Ð :

[210] ½s¸¹ : N/242003
[220] ¥Ó½Ð¤é : 2025/06/27
[730] ¥Ó½Ð¤H : ALIKA CO., LTD.
¦a§} : 8, Hannam-daero 40-gil, Yongsan-gu, Seoul, Republic of Korea
°êÄy : Áú°ê
¬¡°Ê : °Ó·~¤Î¤u·~
[511] Ãþ§O : 25
[511] ²£«~ : Vestuário; cintos [vestuário]; perneiras [aquecedores de pernas]; cintos para guardar dinheiro [vestuário]; chapéus; máscaras térmicas [vestuário]; fatos de banho; calçado; vestuário para a chuva; luvas [vestuário].
[540] °Ó¼Ð :

[210] ½s¸¹ : N/242006
[220] ¥Ó½Ð¤é : 2025/06/27
[730] ¥Ó½Ð¤H : JOHNSON & JOHNSON
¦a§} : One Johnson & Johnson Plaza, New Brunswick, New Jersey, 08933 E.U.A.
°êÄy : ¬ü°ê
¬¡°Ê : °Ó·~¤Î¤u·~
[511] Ãþ§O : 5
[511] ²£«~ : Preparações farmacêuticas para uso humano para doenças virais, doenças autoimunes e inflamatórias, doenças cardiovasculares e pulmonares, doenças do sistema nervoso central, doenças do sistema nervoso periférico, dor, doenças dermatológicas, doenças gastrointestinais, doenças infecciosas, doenças metabólicas, doenças oncológicas, doenças oftálmicas, doenças respiratórias, doenças hematológicas, doenças urológicas, distúrbios materno-fetais, úlceras digitais.
[540] °Ó¼Ð :

[210] ½s¸¹ : N/242007
[220] ¥Ó½Ð¤é : 2025/06/27
[730] ¥Ó½Ð¤H : JOHNSON & JOHNSON
¦a§} : One Johnson & Johnson Plaza, New Brunswick, New Jersey, 08933 E.U.A.
°êÄy : ¬ü°ê
¬¡°Ê : °Ó·~¤Î¤u·~
[511] Ãþ§O : 5
[511] ²£«~ : Preparações farmacêuticas para uso humano para doenças virais, doenças autoimunes e inflamatórias, doenças cardiovasculares e pulmonares, doenças do sistema nervoso central, doenças do sistema nervoso periférico, dor, doenças dermatológicas, doenças gastrointestinais, doenças infecciosas, doenças metabólicas, doenças oncológicas, doenças oftálmicas, doenças respiratórias, doenças hematológicas, doenças urológicas, distúrbios materno-fetais, úlceras digitais.
[540] °Ó¼Ð :

[210] ½s¸¹ : N/242008
[220] ¥Ó½Ð¤é : 2025/06/27
[730] ¥Ó½Ð¤H : JOHNSON & JOHNSON
¦a§} : One Johnson & Johnson Plaza, New Brunswick, New Jersey, 08933 E.U.A.
°êÄy : ¬ü°ê
¬¡°Ê : °Ó·~¤Î¤u·~
[511] Ãþ§O : 5
[511] ²£«~ : Preparações farmacêuticas para uso humano para doenças virais, doenças autoimunes e inflamatórias, doenças cardiovasculares e pulmonares, doenças do sistema nervoso central, doenças do sistema nervoso periférico, dor, doenças dermatológicas, doenças gastrointestinais, doenças infecciosas, doenças metabólicas, doenças oncológicas, doenças oftálmicas, doenças respiratórias, doenças hematológicas, doenças urológicas, distúrbios materno-fetais, úlceras digitais.
[540] °Ó¼Ð :

[210] ½s¸¹ : N/242009
[220] ¥Ó½Ð¤é : 2025/06/27
[730] ¥Ó½Ð¤H : JOHNSON & JOHNSON
¦a§} : One Johnson & Johnson Plaza, New Brunswick, New Jersey, 08933 E.U.A.
°êÄy : ¬ü°ê
¬¡°Ê : °Ó·~¤Î¤u·~
[511] Ãþ§O : 5
[511] ²£«~ : Preparações farmacêuticas para uso humano para doenças virais, doenças autoimunes e inflamatórias, doenças cardiovasculares e pulmonares, doenças do sistema nervoso central, doenças do sistema nervoso periférico, dor, doenças dermatológicas, doenças gastrointestinais, doenças infecciosas, doenças metabólicas, doenças oncológicas, doenças oftálmicas, doenças respiratórias, doenças hematológicas, doenças urológicas, distúrbios materno-fetais, úlceras digitais.
[540] °Ó¼Ð :

[210] ½s¸¹ : N/242012
[220] ¥Ó½Ð¤é : 2025/06/27
[730] ¥Ó½Ð¤H : ¥Ì¹Å»Ê
¦a§} : ¿Dªù氹¥J¼é¦{µó¼ÖÂ@¬Õ°a²Ä¤G®y19¼ÓAD
°êÄy : ¤¤°ê
¬¡°Ê : °Ó·~
[511] Ãþ§O : 35
[511] ªA°È : ¼s§i¡A¹ê·~¸gÀç¡A¹ê·~ºÞ²z¡A¿ì¤½¨Æ°È¡C
[540] °Ó¼Ð :

[591] °Ó¼ÐÃC¦â : ²LÂŦâ¡Bµµ¦â¡B²`ÂŦâ¡A¦p¹Ï©Ò¥Ü¡C
[210] ½s¸¹ : N/242013
[220] ¥Ó½Ð¤é : 2025/06/27
[730] ¥Ó½Ð¤H : ¥Ì¹Å»Ê
¦a§} : ¿Dªù氹¥J¼é¦{µó¼ÖÂ@¬Õ°a²Ä¤G®y19¼ÓAD
°êÄy : ¤¤°ê
¬¡°Ê : °Ó·~
[511] Ãþ§O : 42
[511] ªA°È : ¬ì¾Ç§Þ³NªA°È©M»P¤§¬ÛÃöªº¬ã¨s»P³]pªA°È¡A¤u·~¤ÀªR»P¬ã¨s¡Apºâ¾÷µw¥ó»P³n¥óªº³]p»P¶}µo¡C
[540] °Ó¼Ð :

[591] °Ó¼ÐÃC¦â : ²LÂŦâ¡Bµµ¦â¡B²`ÂŦâ¡A¦p¹Ï©Ò¥Ü¡C
[210] ½s¸¹ : N/242014
[220] ¥Ó½Ð¤é : 2025/06/27
[730] ¥Ó½Ð¤H : ¥Ì¹Å»Ê
¦a§} : ¿Dªù氹¥J¼é¦{µó¼ÖÂ@¬Õ°a²Ä¤G®y19¼ÓAD
°êÄy : ¤¤°ê
¬¡°Ê : °Ó·~
[511] Ãþ§O : 45
[511] ªA°È : ªk«ßªA°È¡A¥Ñ¥L¤H´£¨Ñªº¬°º¡¨¬Ó¤H»Ýnªº¨p¤H©MªÀ·|ªA°È¡A¬°«OÅ@°]²£©M¤H¨¦w¥þªºªA°È¡C
[540] °Ó¼Ð :

[591] °Ó¼ÐÃC¦â : ²LÂŦâ¡Bµµ¦â¡B²`ÂŦâ¡A¦p¹Ï©Ò¥Ü¡C
[210] ½s¸¹ : N/242015
[220] ¥Ó½Ð¤é : 2025/06/27
[730] ¥Ó½Ð¤H : Lemon Inc.
¦a§} : P.O. Box 31119 Grand Pavilion, Hibiscus Way, 802 West Bay Road, Grand Cayman, KY1 ¡V 1205, Cayman Islands
°êÄy : ¶}°Ò¸s®q
¬¡°Ê : °Ó·~¤Î¤u·~
[511] Ãþ§O : 9
[511] ²£«~ : pºâ¾÷µ{§Ç¡]¥i¤U¸ü³n¥ó¡^¡F¨ã¦³¤H¤u´¼¯àªº¤H§Î¾÷¾¹¤H¡F¤j¼Æ¾ÚºÞ²z³n¥ó¡F¤H¤u´¼¯à³n¥ó¡F°ò©ó¤H¤u´¼¯àªº¥æ¤¬¦¡³n¥ó¡F´¼¯à¤â¾÷À³¥Î³n¥ó¡F¥i¤U¸üpºâ¾÷À³¥Î³n¥ó¡F¥Î©ó±N¤H¤u´¼¯à©M¾÷¾¹¾Ç²ß¶°¦¨©ó¤j¼Æ¾Ú»â°ìªº³n¥ó¡F¥Î©ó¼ÒÀÀ¹ï¸Üªº¥i¤U¸üpºâ¾÷²á¤Ñ¾÷¾¹¤H³n¥ó¡F¤w¿ý»sªºpºâ¾÷¾Þ§@µ{§Ç¡F¤w¿ý»sªºpºâ¾÷µ{§Ç¡F¼Æ¾Ú³B²z³]³Æ¡Fpºâ¾÷µw¥ó¡F¥i¤U¸ü¾Þ§@¨t²Î³n¥ó¡F¥i¤U¸ü¥Î§@µêÀÀ§U¤âªº³n¥ó¡F¥i¤U¸ü²¾°Ê³]³ÆÀ³¥Î³n¥ó¡F¥i¤U¸ü°ò©ó¤H¤u´¼¯àªº²á¤Ñ¾÷¾¹¤H³n¥ó¡F¥i¤U¸ü¦ÛµM»y¨¥³B²z³n¥ó¡F¥Î©ó¼ÒÀÀ»P¤H¤u´¼¯à¹ï¸Üªº¥i¤U¸üªº²á¤Ñ¾÷¾¹¤Hpºâ¾÷µ{§Ç©M³n¥ó¡F¥i¤U¸üªº¤â¾÷À³¥Î³n¥ó¡F¼Æ¾Ú³B²z¸Ë¸m©Mpºâ¾÷¡F¤¤¥¡³B²z¾¹¡]CPU¡^¡F¤w¿ý»sªº©Î¥i¤U¸üªºpºâ¾÷³n¥ó¥¥x¡F³Ð«Ø«H®§¯Á¤Þ¡Bºô¯¸¯Á¤Þ©M¨ä¥L«H®§¸ê·½¯Á¤Þ¥Î¥i¤U¸ü³n¥ó¡F·j¯Á¡B¶×½s¡B¯Á¤Þ©M²Õ´pºâ¾÷ºôµ¸«H®§¥Îpºâ¾÷³n¥ó¡F³Ð«Ø«H®§¯Á¤Þ¡Bºô¯¸¯Á¤Þ©M¨ä¥L«H®§¸ê·½¯Á¤Þ¥Îpºâ¾÷³n¥ó¡Fpºâ¾÷³n¥ó¡F¥æ¤¬¦¡³n¥ó¡F¥Î©ó¤H¤u´¼¯àªºpºâ¾÷³n¥óÀ³¥Îµ{§Ç¡F§Q¥Î¤H¤u´¼¯à¶i¦æ¼Æ¾Ú¤ÀªRªº¥i¤U¸üpºâ¾÷µ{§Ç©M³n¥ó¡F¾÷¾¹¤H§Ypºâ¾÷µ{§Ç©M³n¥ó¡F¤H¤u´¼¯à¥Î¥i¤U¸üpºâ¾÷µ{§Ç¤Î¥i¤U¸üpºâ¾÷³n¥ó¡F¥Î©ó¨Ï¥Î»y¨¥¼Ò«¬ªº¥i¤U¸üpºâ¾÷³n¥ó¡F¦b¤H¤u´¼¯à¡Bpºâ¾÷¬ì¾Ç©Mpºâ¾÷³n¥ó³]p©M¶}µo»â°ìªº¤å³¹¡B¬ã¨s½×¤å¡B³ø§i©M·s»D²³øªº¥i¤U¸ü¹q¤l¥Xª©ª«¡C
[540] °Ó¼Ð :

[210] ½s¸¹ : N/242016
[220] ¥Ó½Ð¤é : 2025/06/27
[730] ¥Ó½Ð¤H : Lemon Inc.
¦a§} : P.O. Box 31119 Grand Pavilion, Hibiscus Way, 802 West Bay Road, Grand Cayman, KY1 ¡V 1205, Cayman Islands
°êÄy : ¶}°Ò¸s®q
¬¡°Ê : °Ó·~¤Î¤u·~
[511] Ãþ§O : 38
[511] ªA°È : pºâ¾÷²×ºÝ³q°T¡Fpºâ¾÷»²§U«H®§©M¹Ï¹³¶Ç°e¡F´£¨Ñ»P¥þ²ypºâ¾÷ºôµ¸ªº¹q°TÁp±µªA°È¡F´£¨Ñ¥þ²ypºâ¾÷ºôµ¸¥Î¤á±µ¤JªA°È¡F´£¨Ñ¼Æ¾Ú®w±µ¤JªA°È¡F½Ã¬P¶Ç°e¡F¹q°TªA°È¡Fpºâ¾÷³q°T©M¤¬Ápºô±µ¤JªA°È¡F¶Ç°e¸ê°Tªº³q°TªA°È¡Fpºâ¾÷¶Ç°eªA°È¡F´£¨Ñ¤º®e¡Bºô¯¸¤Îªù¤áºô¯¸±µ¹F¡F´£¨Ñ¹q¸£¸ê®Æ®w±µ¹F¡F¦bµêÀÀÀô¹Ò¤¤´£¨Ñ²á¤Ñ«Ç¡F´£¨Ñ¦b½u¦h´CÅ餺®e±µ¤JªA°È¡F´£¨Ñ¤¬Ápºô¥¥x±µ¤JªA°È¡F´£¨Ñ³q°Tºôµ¸¼Æ¾Ú±µ¹F¡F´£¨Ñ¤¬Ápºô¤WµÀW¤ÎµøÀW¤º®e¹q°T±µ¤JªA°È¡F¼Æ¾Ú¶Ç°e¡FÁnµ¡B¹Ï¹³¡B¤å¥ó¡B°T®§¤Î¼Æ¾Úªº¹q¤l¶Ç°e¤Î¦A¶Ç°e¡F¦b½u°T®§ªA°È¡FµøÀW¶Ç°eªA°È¡FµL½u³q°TªA°È¡F¾Þ§@¹q¤l³q°T¨t²Î¡F´£¨Ñ¤¬Ápºô²á¤Ñ«Ç¡F³q¹Lpºâ¾÷¤Î³q°Tºôµ¸¶Ç¿é¼Æ¾Ú¤Î¸ê°T¡F¬°¥Î¤á´£¨Ñ¥þ²ypºâ¾÷ºôµ¸±µ¤JªA°È¡F¤¬Ápºô»yµ¨óij¡]VoIP¡^ªA°È¡F¬°¥Î¤á´£¨Ñ¶³ºÝpºâ¥¥x±µ¤J¡C
[540] °Ó¼Ð :

[210] ½s¸¹ : N/242017
[220] ¥Ó½Ð¤é : 2025/06/27
[730] ¥Ó½Ð¤H : Lemon Inc.
¦a§} : P.O. Box 31119 Grand Pavilion, Hibiscus Way, 802 West Bay Road, Grand Cayman, KY1 ¡V 1205, Cayman Islands
°êÄy : ¶}°Ò¸s®q
¬¡°Ê : °Ó·~¤Î¤u·~
[511] Ãþ§O : 42
[511] ªA°È : ³n¥óªº¶}µo¡B½sµ{¤Î¹ê²{¡F³n¥ó§YªA°È¡]SaaS¡^¡F³]p©M¶}µo¾Þ§@¨t²Î³n¥ó¡F¹q¤l¼Æ¾Ú¦sÀx¡F¦b½u¦P¨B¦sÀx¡F´£¨Ñ¦b½u¤£¥i¤U¸üªº³n¥ó¡F³]p©M¶}µo¥Î©ó¶³pºâºôµ¸ªº¾Þ§@³n¥ó¡F´£¨Ñ¦b½u¤£¥i¤U¸ü³n¥ó¤§¼È®É¨Ï¥ÎªA°È¡A¥Î©ó³X°Ý©M¨Ï¥Î¶³pºâºôµ¸¡F¬°¥L¤HºûÅ@ºô¯¸©M°UºÞ¦b½uºôµ¸³]¬I¡F³]p©M¶}µo¤H¤u´¼¯à³n¥ó¡F¨Ïpºâ¾÷©M²¾°Ê³]³Æ¼Ò¥é¤HÃþ¤ÏÀ³ªº¥¥x§YªA°È¡]PaaS¡^¡F³]p©M¶}µo²á¤Ñ¾÷¾¹¤H³n¥ó¡Fpºâ¾÷½sµ{¡F´£¨Ñ¦b½u¤£¥i¤U¸üªº¾Þ§@¨t²Î³n¥ó¡F¨Ï¥Î¤H¤u´¼¯à¶}µopºâ¾÷³n¥ó¡F¼Æ¾Ú¥[±KªA°È¡F´£¨Ñ¤H¤u´¼¯à¤Îpºâ¾÷³n¥ó³]p»P¶}µo»â°ìªº§Þ³N¿Ô¸ß¡F¶³pºâªA°È¡F¥H¤H¤u´¼¯àpºâ¾÷³n¥ó¥¥x¬°¯S¦âªº³n¥ó§YªA°È[SaaS]¡F¤H¤u´¼¯à»â°ìªº§Þ³N¿Ô¸ß¡F¦b¼Æ¾Úºôµ¸¤W´£¨Ñ¤H¤u´¼¯àpºâ¾÷µ{§Ç¡F´£¨Ñ¾÷¾¹¾Ç²ß³n¥ó¬°¯S¦âªº³n¥ó§YªA°È[SaaS]¡Fpºâ¾÷µ{§Ç½s¿èªA°È¡FÀ³¥Î³n¥ó¯²¸îªA°È¡Fpºâ¾÷µw¥ó©M³n¥óªº³]p»P¶}µo¡Fpºâ¾÷³n¥óªº§ó·s»PºûÅ@¡F«H®§§Þ³N«t¸ßªA°È¡F¥¥x§YªA°È¡]PaaS¡^¡Fpºâ¾÷¥¥xªº¶}µo¡Fpºâ¾÷³n¥ó¥X¯²¡B¦w¸Ë©M¿Ô¸ß¡Fpºâ¾÷µ{§Ç©M¼Æ¾Úªº¼Æ¾ÚÂà´«¡]«D¦³§ÎÂà´«¡^¡F¼¶¼g¬ì§Þ¤å½Z¡F§Þ³N¬ã¨s¡F´À¥L¤H¬ã¨s©M¶}µo·s²£«~¡F´£¨Ñ¤H¤u´¼¯à¥Î¦b½u¤£¥i¤U¸ü³n¥ó¡F´£¨ÑÀ³¥Îµ{¦¡³]p¤¶±¡]API¡^³n¥ó¤§À³¥ÎªA°È¨ÑÀ³°Ó¡]ASP¡^ªA°È¡F³q¹L¥þ²ypºâ¾÷ºôµ¸´£¨ú¡BÀ˯Á«H®§¤Î«õ±¸¼Æ¾Ú¡]«H®§§Þ³NªA°È¡^¡F³Ð«Ø»P¥þ²ypºâ¾÷ºôµ¸ÃöÁpªº«H®§¯Á¤Þ¡Bºô¯¸¯Á¤Þ©M¨ä¥L«H®§¸ê·½¯Á¤Þ¡]«H®§§Þ³NªA°È¡^¡F³q¹L¥þ²ypºâ¾÷«H®§ºôµ¸´£¨Ñ«H®§¡A¥]¬A¤å¥»¡B¹q¤l¤å¥ó¡B¼Æ¾Ú®w¡B¹Ï§Î©MµøÅ¥«H®§¡A«H®§¨Ó·½©ó¥i·j¯Áªº«H®§¯Á¤Þ©M¼Æ¾Ú®w¡]«H®§§Þ³NªA°È¡^¡F¥Hpºâ¾÷³n¥ó¬°¯S¦âªºÀ³¥ÎªA°È´£¨Ñ°ÓªA°È¡]ASP¡^¡F´£¨Ñ¦b½u¤£¥i¤U¸üªº²á¤Ñ¾÷¾¹¤H³n¥ó¡F´£¨Ñ¤¬Ápºô·j¯Á¤ÞÀº¡F¥HÀ³¥Îµ{§Ç½sµ{±µ¤f¡]API¡^³n¥ó¬°¯S¦âªºÀ³¥ÎªA°È´£¨Ñ°Ó¡Fpºâ¾÷µ{§Ç©M³n¥óªº¬ã¨s¡B³]p»P¶}µo¡F´£¨Ñ¤H¤u´¼¯à¡Bpºâ¾÷¬ì¾Ç©Mpºâ¾÷µw¥ó»P³n¥ó³]p©M¶}µo»â°ìªº§Þ³N³]p©M¶}µo¡C
[540] °Ó¼Ð :

[210] ½s¸¹ : N/242018
[220] ¥Ó½Ð¤é : 2025/06/27
[730] ¥Ó½Ð¤H : ¤è¦t½÷
¦a§} : ºÖ«Ø¬Ù¥P¹C¿¤ÃU«nÂí¥É¥Ð§øªF¤@Àô¸ô2288¸¹Äõ·Ë·s¤Ñ¦a6¸¹¼Ó3±è301«Ç
°êÄy : ¤¤°ê
¬¡°Ê : °Ó·~¤Î¤u·~
[511] Ãþ§O : 10
[511] ²£«~ : ¤À®Y¿È¹Ô¡F¥¥°ü¦«¸¡±a¡F¥~¬ì»ö¾¹©M¾¹±ñ¡F¹q¼ö¼Å¥¬¡]¥~¬ì¡^¡F¤ú¬ì³]³Æ©M»ö¾¹¡F¹qÀø¾¹±ñ¡F«ö¼¯¾¹±ñ¡FÂåÀø¾¹±ñ©M»ö¾¹¡F§U²£¾¹±ñ¡FÂÀª·±a¡F¥~¬ì¥Î¤H³y¥Ö½§¡FÁ×¥¥®M¡F³±¹D¨R¬~¾¹¡F§¿¹Dª`®g¾¹¡F®¶°Ê«ö¼¯¾¹¡FÂå¥Î¥R®ð§É¹Ô¡FµLµß¸n¥¬¡]¥~¬ì¥Î¡^¡F«D¤Æ¾ÇÁ×¥¥¥Î¨ã¡F²zÀø³]³Æ¡FÂå¥Î§N¼Å¶K¡C
[540] °Ó¼Ð :

[210] ½s¸¹ : N/242019
[220] ¥Ó½Ð¤é : 2025/06/27
[730] ¥Ó½Ð¤H : ¤Ñ¬z¥«¹çªe¿¤°ê¬x½\ª«ºØ´Ó®a®x¹A³õ
¦a§} : ¤¤°ê¤Ñ¬z¥«¹çªe°ÏÂ×»OÂí¥_®I¯]§ø§ø¦è
°êÄy : ¤¤°ê
¬¡°Ê : °Ó·~¤Î¤u·~
[511] Ãþ§O : 31
[511] ²£«~ : ¬¡°Êª«¡F°Êª«¹«~¡FÁR¡F¬¹¯b¥Î»æ¡F°Êª«¹}料¥Î®ñ¤Æ¶t¡F°Êª«¹¥ÎÁR料¡F½Þ¹}料¡F¬¹¯b±j§§¹}料¡F¬¹¤f¹¥Î¥É¦Ì»æ¡F¹}¾i³Æ料¡C
[540] °Ó¼Ð :

[210] ½s¸¹ : N/242020
[220] ¥Ó½Ð¤é : 2025/06/27
[730] ¥Ó½Ð¤H : ³¢«i
¦a§} : ¿Dªù氹¥J®]¶h¥P³Õ¤h¤j°¨¸ô75¸¹°Ò§J¹y¥_¶ð31¼ÓD®y
°êÄy : ¤¤°ê
¬¡°Ê : °Ó·~
[511] Ãþ§O : 33
[511] ²£«~ : «O°·°s¡A¥Õ°s¡C
[540] °Ó¼Ð :

[591] °Ó¼ÐÃC¦â : ª÷¦â¡A¦p¹Ï©Ò¥Ü¡C
[210] ½s¸¹ : N/242021
[220] ¥Ó½Ð¤é : 2025/06/27
[730] ¥Ó½Ð¤H : SAMSUNG ELECTRONICS CO., LTD.
¦a§} : 129, Samsung-ro, Yeongtong-gu, Suwon-si, Gyeonggi-do, Republic of Korea
°êÄy : Áú°ê
¬¡°Ê : °Ó·~¤Î¤u·~
[511] Ãþ§O : 9
[511] ²£«~ : Televisões; monitores de vídeo; aparelhos de televisão; monitores de vídeo para usar no corpo; monitores com ecrãs de cristais líquidos; monitores LED; monitores de sinalizações digitais; monitores de ecrã táctil; interfaces de visualização em série para condutores de automóveis; ecrãs de visualização de vídeo para aparelhos de navegação para veículos; ecrãs de díodos emissores de luz [LED]; painéis de visualização OLED (díodos emissores de luz orgânicos); ecrãs planos.
[540] °Ó¼Ð :

[300] Àu¥ýÅv : 2025/01/24¡AÁú°ê Coreana¡A½s¸¹N.º 40-2025-0013883
[210] ½s¸¹ : N/242023
[220] ¥Ó½Ð¤é : 2025/06/27
[730] ¥Ó½Ð¤H : Dong-A Pharmaceutical Co., Ltd.
¦a§} : 64 Cheonho-daero, Dongdaemun-gu, Seoul 02587, Republic of Korea
°êÄy : Áú°ê
¬¡°Ê : °Ó·~¤Î¤u·~
[511] Ãþ§O : 35
[511] ªA°È : Serviços de publicidade relacionados com cosméticos; serviços de loja de vendas por grosso de preparações para cuidados da pele para fins medicinais; serviços de loja de vendas a retalho de preparações para cuidados da pele para fins medicinais; serviços de loja de vendas por grosso de cremes medicinais; serviços de loja de vendas por grosso de nutracêuticos para utilização como suplemento alimentar; serviços de loja de vendas por grosso de sabonetes medicinais; fornecimento de informações ao consumidor relativas a produtos cosméticos; estudos de mercado nos domínios dos cosméticos, perfumaria e produtos de beleza; serviços de loja de vendas por grosso de desodorizantes para o ar; serviços de loja de vendas por grosso de lenços e toalhetes impregnados com loções e cremes farmacêuticos; serviços de loja de vendas por grosso de cosméticos; serviços de loja de vendas a retalho de cosméticos; serviços de loja de vendas por grosso de cosméticos funcionais, nomeadamente preparações para cuidados da pele; serviços de loja de vendas por grosso de cosméticos para cuidados do corpo e de beleza; serviços de loja de vendas por grosso de preparações cosméticas para o cabelo e couro cabeludo; serviços de loja de vendas por grosso de lenços impregnados com loções cosméticas; serviços de loja de vendas por grosso de aromáticos (perfumes) para uso pessoal; serviços de loja de vendas por grosso de utensílios cosméticos; serviços de loja de vendas por grosso de preparações de higiene pessoal; serviços de loja de vendas a retalho de preparações de higiene pessoal; serviços de loja de vendas por grosso de preparações cosméticas para o cuidado da boca e dos dentes; fornecimento de um centro comercial abrangente na internet; serviços de intermediação comercial relativos a vendas por correspondência através de telecomunicações; serviços de publicidade; publicidade em linha através de uma rede de comunicações por computador; apresentação de produtos em meios de comunicação, para fins de venda a retalho; promoção de vendas para terceiros; serviços de publicidade relacionados com produtos farmacêuticos; serviços de encomenda de vendas a grosso de produtos farmacêuticos; serviços de loja de vendas por grosso de produtos farmacêuticos; serviços de loja de vendas a retalho de produtos farmacêuticos.
[540] °Ó¼Ð :

[210] ½s¸¹ : N/242024
[220] ¥Ó½Ð¤é : 2025/06/27
[730] ¥Ó½Ð¤H : Dong-A Pharmaceutical Co., Ltd.
¦a§} : 64 Cheonho-daero, Dongdaemun-gu, Seoul 02587, Republic of Korea
°êÄy : Áú°ê
¬¡°Ê : °Ó·~¤Î¤u·~
[511] Ãþ§O : 35
[511] ªA°È : Serviços de publicidade relacionados com cosméticos; serviços de loja de vendas por grosso de preparações para cuidados da pele para fins medicinais; serviços de loja de vendas a retalho de preparações para cuidados da pele para fins medicinais; serviços de loja de vendas por grosso de cremes medicinais; serviços de loja de vendas por grosso de nutracêuticos para utilização como suplemento alimentar; serviços de loja de vendas por grosso de sabonetes medicinais; fornecimento de informações ao consumidor relativas a produtos cosméticos; estudos de mercado nos domínios dos cosméticos, perfumaria e produtos de beleza; serviços de loja de vendas por grosso de desodorizantes para o ar; serviços de loja de vendas por grosso de lenços e toalhetes impregnados com loções e cremes farmacêuticos; serviços de loja de vendas por grosso de cosméticos; serviços de loja de vendas a retalho de cosméticos; serviços de loja de vendas por grosso de cosméticos funcionais, nomeadamente preparações para cuidados da pele; serviços de loja de vendas por grosso de cosméticos para cuidados do corpo e de beleza; serviços de loja de vendas por grosso de preparações cosméticas para o cabelo e couro cabeludo; serviços de loja de vendas por grosso de lenços impregnados com loções cosméticas; serviços de loja de vendas por grosso de aromáticos (perfumes) para uso pessoal; serviços de loja de vendas por grosso de utensílios cosméticos; serviços de loja de vendas por grosso de preparações de higiene pessoal; serviços de loja de vendas a retalho de preparações de higiene pessoal; serviços de loja de vendas por grosso de preparações cosméticas para o cuidado da boca e dos dentes; fornecimento de um centro comercial abrangente na internet; serviços de intermediação comercial relativos a vendas por correspondência através de telecomunicações; serviços de publicidade; publicidade em linha através de uma rede de comunicações por computador; apresentação de produtos em meios de comunicação, para fins de venda a retalho; promoção de vendas para terceiros; serviços de publicidade relacionados com produtos farmacêuticos; serviços de encomenda de vendas a grosso de produtos farmacêuticos; serviços de loja de vendas por grosso de produtos farmacêuticos; serviços de loja de vendas a retalho de produtos farmacêuticos.
[540] °Ó¼Ð :

[210] ½s¸¹ : N/242025
[220] ¥Ó½Ð¤é : 2025/06/27
[730] ¥Ó½Ð¤H : ¤¤°ê²±¥@¥¿¼w°ó¥Íª«»sÃĦ³¤½¥q
¦a§} : ¿Dªù«nÆW¤j°¨¸ô762-804¸¹¤¤µØ¼s³õ14¼ÓG®y
°êÄy : ®Ú¾Ú¿Dªùªk¨Ò¦¨¥ß
¬¡°Ê : °Ó·~
[511] Ãþ§O : 5
[511] ²£«~ : Âå¥Î©MÃ~Âå¥Î»s¾¯¡AÂå¥Î½Ã¥Í»s¾¯¡AÂå¥ÎÀç¾i«~¡AÀ¦¨à¹«~¡A»IÃÄ¡AÁ^¼Å§÷®Æ¡A¶ñ¶ë¤ú¤Õ©M¤ú¼Ò¥Î®Æ¡A®ø¬r¾¯¡A®ø·À¦³®`°Êª«»s¾¯¡A±þ¯uµß¾¯¡A°£²û¾¯¡C
[540] °Ó¼Ð :

[591] °Ó¼ÐÃC¦â : ¶À¦â C25 M45 Y90 K0¡A¥Õ¦â³¡¥÷¬°³z©ú©³¦â¡A¦p¹Ï©Ò¥Ü¡C
[210] ½s¸¹ : N/242026
[220] ¥Ó½Ð¤é : 2025/06/27
[730] ¥Ó½Ð¤H : ·Ï¥x¦N´µªiº¸ÆC°s¦³¤½¥q
¦a§} : ¤¤°ê¤sªF¬Ù·Ï¥x¥«¦È¥°ÏªZ¤¸ô555¸¹
°êÄy : ¤¤°ê
¬¡°Ê : °Ó·~¤Î¤u·~
[511] Ãþ§O : 33
[511] ²£«~ : Âû§À°s¡F¸²µå°s¡F¯P°s¡]¶¼®Æ¡^¡F¥ÕÄõ¦a¡F«Â¤h§Ò¡F°sºë¶¼®Æ¡]°à°s°£¥~¡^¡F¹w¥ý²V¦Xªº°sºë¶¼®Æ¡]¥H°à°s¬°¥Dªº°£¥~¡^¡F²M°s¡]¤é¥»¦Ì°s¡^¡F¥ñ¯S¥[°s¡C
[540] °Ó¼Ð :

[210] ½s¸¹ : N/242027
[220] ¥Ó½Ð¤é : 2025/06/27
[730] ¥Ó½Ð¤H : Almirall, S.A.
¦a§} : Ronda General Mitre, 151, 08022 Barcelona, Spain
°êÄy : ¦è¯Z¤ú
¬¡°Ê : °Ó·~¤Î¤u·~
[511] Ãþ§O : 41
[511] ªA°È : Serviços de instrução, serviços educativos; organização e condução de seminários, organização e condução de simpósios, organização e condução de workshops [formação]; fornecimento de publicações eletrónicas em linha, não descarregáveis.
[540] °Ó¼Ð :

[210] ½s¸¹ : N/242028
[220] ¥Ó½Ð¤é : 2025/06/27
[730] ¥Ó½Ð¤H : Almirall, S.A.
¦a§} : Ronda General Mitre, 151, 08022 Barcelona, Spain
°êÄy : ¦è¯Z¤ú
¬¡°Ê : °Ó·~¤Î¤u·~
[511] Ãþ§O : 44
[511] ªA°È : Aconselhamento em farmácia, aconselhamento sobre medicação, serviços de consultadoria relacionados com cuidados de saúde, prestação de informações médicas, consultas médicas, prestação de informações médicas através de websites.
[540] °Ó¼Ð :

[210] ½s¸¹ : N/242029
[220] ¥Ó½Ð¤é : 2025/06/27
[730] ¥Ó½Ð¤H : Almirall, S.A.
¦a§} : Ronda General Mitre, 151, 08022 Barcelona, Spain
°êÄy : ¦è¯Z¤ú
¬¡°Ê : °Ó·~¤Î¤u·~
[511] Ãþ§O : 5
[511] ²£«~ : Preparações farmacêuticas, preparações químico-farmacêuticas, medicamentos para uso humano, medicamentos para uso médico, pomadas para uso farmacêutico, preparações biológicas para uso médico, preparações de microrganismos para uso médico ou veterinário, produtos de microrganismos para uso médico ou veterinário, meios para culturas bacteriológicas para fins médicos ou veterinários, preparações de diagnóstico para fins médicos, reagentes químicos para fins médicos ou veterinários.
[540] °Ó¼Ð :

[210] ½s¸¹ : N/242030
[220] ¥Ó½Ð¤é : 2025/06/27
[730] ¥Ó½Ð¤H : Almirall, S.A.
¦a§} : Ronda General Mitre, 151, 08022 Barcelona, Spain
°êÄy : ¦è¯Z¤ú
¬¡°Ê : °Ó·~¤Î¤u·~
[511] Ãþ§O : 35
[511] ªA°È : Assistência na direção de negócios comerciais, consultadoria profissional em negócios comerciais, pesquisas comerciais, investigações em negócios comerciais, serviços de intermediação comercial; serviços de agência de importação e exportação, marketing, promoção de vendas para terceiros, serviços de aquisição para terceiros [compra de bens e serviços para outras empresas], fornecimento de um mercado em linha para compradores e vendedores de bens e serviços; serviços de venda a retalho de preparações farmacêuticas, veterinárias e higiénicas e de material médico, serviços de venda por grosso de preparações farmacêuticas, veterinárias e higiénicas e de material médico.
[540] °Ó¼Ð :

[210] ½s¸¹ : N/242031
[220] ¥Ó½Ð¤é : 2025/06/27
[730] ¥Ó½Ð¤H : Almirall, S.A.
¦a§} : Ronda General Mitre, 151, 08022 Barcelona, Spain
°êÄy : ¦è¯Z¤ú
¬¡°Ê : °Ó·~¤Î¤u·~
[511] Ãþ§O : 41
[511] ªA°È : Serviços de instrução, serviços educativos; organização e condução de seminários, organização e condução de simpósios, organização e condução de workshops [formação]; fornecimento de publicações eletrónicas em linha, não descarregáveis.
[540] °Ó¼Ð :

[210] ½s¸¹ : N/242032
[220] ¥Ó½Ð¤é : 2025/06/27
[730] ¥Ó½Ð¤H : Almirall, S.A.
¦a§} : Ronda General Mitre, 151, 08022 Barcelona, Spain
°êÄy : ¦è¯Z¤ú
¬¡°Ê : °Ó·~¤Î¤u·~
[511] Ãþ§O : 42
[511] ªA°È : Investigação tecnológica, realização de estudos de projetos técnicos, investigação científica; investigação e desenvolvimento de medicamentos, desenvolvimento de formulações farmacêuticas e medicamentos, serviços de desenvolvimento de medicamentos, avaliação de medicamentos, investigação técnica na área da investigação de medicamentos, investigação bacteriológica, investigação biológica, ensaios clínicos, investigação médica; testes farmacêuticos, testes de produtos, testes de produtos químicos; design industrial, design de embalagens, estilismo [design industrial].
[540] °Ó¼Ð :

[210] ½s¸¹ : N/242033
[220] ¥Ó½Ð¤é : 2025/06/27
[730] ¥Ó½Ð¤H : Almirall, S.A.
¦a§} : Ronda General Mitre, 151, 08022 Barcelona, Spain
°êÄy : ¦è¯Z¤ú
¬¡°Ê : °Ó·~¤Î¤u·~
[511] Ãþ§O : 44
[511] ªA°È : Aconselhamento em farmácia, aconselhamento sobre medicação, serviços de consultadoria relacionados com cuidados de saúde, prestação de informações médicas, consultas médicas, prestação de informações médicas através de websites.
[540] °Ó¼Ð :

[210] ½s¸¹ : N/242034
[220] ¥Ó½Ð¤é : 2025/06/27
[730] ¥Ó½Ð¤H : Almirall, S.A.
¦a§} : Ronda General Mitre, 151, 08022 Barcelona, Spain
°êÄy : ¦è¯Z¤ú
¬¡°Ê : °Ó·~¤Î¤u·~
[511] Ãþ§O : 5
[511] ²£«~ : Preparações farmacêuticas, preparações químico-farmacêuticas, medicamentos para uso humano, medicamentos para uso médico, pomadas para uso farmacêutico, preparações biológicas para uso médico, preparações de microrganismos para uso médico ou veterinário, produtos de microrganismos para uso médico ou veterinário, meios para culturas bacteriológicas para fins médicos ou veterinários, preparações de diagnóstico para fins médicos, reagentes químicos para fins médicos ou veterinários.
[540] °Ó¼Ð :

[210] ½s¸¹ : N/242035
[220] ¥Ó½Ð¤é : 2025/06/27
[730] ¥Ó½Ð¤H : Almirall, S.A.
¦a§} : Ronda General Mitre, 151, 08022 Barcelona, Spain
°êÄy : ¦è¯Z¤ú
¬¡°Ê : °Ó·~¤Î¤u·~
[511] Ãþ§O : 35
[511] ªA°È : Assistência na direção de negócios comerciais, consultadoria profissional em negócios comerciais, pesquisas comerciais, investigações em negócios comerciais, serviços de intermediação comercial; serviços de agência de importação e exportação, marketing, promoção de vendas para terceiros, serviços de aquisição para terceiros [compra de bens e serviços para outras empresas], fornecimento de um mercado em linha para compradores e vendedores de bens e serviços; serviços de venda a retalho de preparações farmacêuticas, veterinárias e higiénicas e de material médico, serviços de venda por grosso de preparações farmacêuticas, veterinárias e higiénicas e de material médico.
[540] °Ó¼Ð :

[210] ½s¸¹ : N/242036
[220] ¥Ó½Ð¤é : 2025/06/27
[730] ¥Ó½Ð¤H : Almirall, S.A.
¦a§} : Ronda General Mitre, 151, 08022 Barcelona, Spain
°êÄy : ¦è¯Z¤ú
¬¡°Ê : °Ó·~¤Î¤u·~
[511] Ãþ§O : 41
[511] ªA°È : Serviços de instrução, serviços educativos; organização e condução de seminários, organização e condução de simpósios, organização e condução de workshops [formação]; fornecimento de publicações eletrónicas em linha, não descarregáveis.
[540] °Ó¼Ð :

[210] ½s¸¹ : N/242037
[220] ¥Ó½Ð¤é : 2025/06/27
[730] ¥Ó½Ð¤H : Almirall, S.A.
¦a§} : Ronda General Mitre, 151, 08022 Barcelona, Spain
°êÄy : ¦è¯Z¤ú
¬¡°Ê : °Ó·~¤Î¤u·~
[511] Ãþ§O : 42
[511] ªA°È : Investigação tecnológica, realização de estudos de projetos técnicos, investigação científica; investigação e desenvolvimento de medicamentos, desenvolvimento de formulações farmacêuticas e medicamentos, serviços de desenvolvimento de medicamentos, avaliação de medicamentos, investigação técnica na área da investigação de medicamentos, investigação bacteriológica, investigação biológica, ensaios clínicos, investigação médica; testes farmacêuticos, testes de produtos, testes de produtos químicos; design industrial, design de embalagens, estilismo [design industrial].
[540] °Ó¼Ð :

[210] ½s¸¹ : N/242038
[220] ¥Ó½Ð¤é : 2025/06/27
[730] ¥Ó½Ð¤H : Almirall, S.A.
¦a§} : Ronda General Mitre, 151, 08022 Barcelona, Spain
°êÄy : ¦è¯Z¤ú
¬¡°Ê : °Ó·~¤Î¤u·~
[511] Ãþ§O : 44
[511] ªA°È : Aconselhamento em farmácia, aconselhamento sobre medicação, serviços de consultadoria relacionados com cuidados de saúde, prestação de informações médicas, consultas médicas, prestação de informações médicas através de websites.
[540] °Ó¼Ð :

[210] ½s¸¹ : N/242039
[220] ¥Ó½Ð¤é : 2025/06/27
[730] ¥Ó½Ð¤H : Almirall, S.A.
¦a§} : Ronda General Mitre, 151, 08022 Barcelona, Spain
°êÄy : ¦è¯Z¤ú
¬¡°Ê : °Ó·~¤Î¤u·~
[511] Ãþ§O : 5
[511] ²£«~ : Preparações farmacêuticas, preparações químico-farmacêuticas, medicamentos para uso humano, medicamentos para uso médico, pomadas para uso farmacêutico, preparações biológicas para uso médico, preparações de microrganismos para uso médico ou veterinário, produtos de microrganismos para uso médico ou veterinário, meios para culturas bacteriológicas para fins médicos ou veterinários, preparações de diagnóstico para fins médicos, reagentes químicos para fins médicos ou veterinários.
[540] °Ó¼Ð :

[591] °Ó¼ÐÃC¦â : Reivindica as cores verde e azul tal como representado na figura.
[210] ½s¸¹ : N/242040
[220] ¥Ó½Ð¤é : 2025/06/27
[730] ¥Ó½Ð¤H : Almirall, S.A.
¦a§} : Ronda General Mitre, 151, 08022 Barcelona, Spain
°êÄy : ¦è¯Z¤ú
¬¡°Ê : °Ó·~¤Î¤u·~
[511] Ãþ§O : 35
[511] ªA°È : Assistência na direção de negócios comerciais, consultadoria profissional em negócios comerciais, pesquisas comerciais, investigações em negócios comerciais, serviços de intermediação comercial; serviços de agência de importação e exportação, marketing, promoção de vendas para terceiros, serviços de aquisição para terceiros [compra de bens e serviços para outras empresas], fornecimento de um mercado em linha para compradores e vendedores de bens e serviços; serviços de venda a retalho de preparações farmacêuticas, veterinárias e higiénicas e de material médico, serviços de venda por grosso de preparações farmacêuticas, veterinárias e higiénicas e de material médico.
[540] °Ó¼Ð :

[591] °Ó¼ÐÃC¦â : Reivindica as cores verde e azul tal como representado na figura.
[210] ½s¸¹ : N/242041
[220] ¥Ó½Ð¤é : 2025/06/27
[730] ¥Ó½Ð¤H : Almirall, S.A.
¦a§} : Ronda General Mitre, 151, 08022 Barcelona, Spain
°êÄy : ¦è¯Z¤ú
¬¡°Ê : °Ó·~¤Î¤u·~
[511] Ãþ§O : 41
[511] ªA°È : Serviços de instrução, serviços educativos; organização e condução de seminários, organização e condução de simpósios, organização e condução de workshops [formação]; fornecimento de publicações eletrónicas em linha, não descarregáveis.
[540] °Ó¼Ð :

[591] °Ó¼ÐÃC¦â : Reivindica as cores verde e azul tal como representado na figura.
[210] ½s¸¹ : N/242042
[220] ¥Ó½Ð¤é : 2025/06/27
[730] ¥Ó½Ð¤H : Almirall, S.A.
¦a§} : Ronda General Mitre, 151, 08022 Barcelona, Spain
°êÄy : ¦è¯Z¤ú
¬¡°Ê : °Ó·~¤Î¤u·~
[511] Ãþ§O : 42
[511] ªA°È : Investigação tecnológica, realização de estudos de projetos técnicos, investigação científica; investigação e desenvolvimento de medicamentos, desenvolvimento de formulações farmacêuticas e medicamentos, serviços de desenvolvimento de medicamentos, avaliação de medicamentos, investigação técnica na área da investigação de medicamentos, investigação bacteriológica, investigação biológica, ensaios clínicos, investigação médica; testes farmacêuticos, testes de produtos, testes de produtos químicos; design industrial, design de embalagens, estilismo [design industrial].
[540] °Ó¼Ð :

[591] °Ó¼ÐÃC¦â : Reivindica as cores verde e azul tal como representado na figura.
[210] ½s¸¹ : N/242043
[220] ¥Ó½Ð¤é : 2025/06/27
[730] ¥Ó½Ð¤H : Almirall, S.A.
¦a§} : Ronda General Mitre, 151, 08022 Barcelona, Spain
°êÄy : ¦è¯Z¤ú
¬¡°Ê : °Ó·~¤Î¤u·~
[511] Ãþ§O : 44
[511] ªA°È : Aconselhamento em farmácia, aconselhamento sobre medicação, serviços de consultadoria relacionados com cuidados de saúde, prestação de informações médicas, consultas médicas, prestação de informações médicas através de websites.
[540] °Ó¼Ð :

[591] °Ó¼ÐÃC¦â : Reivindica as cores verde e azul tal como representado na figura.
[210] ½s¸¹ : N/242044
[220] ¥Ó½Ð¤é : 2025/06/27
[730] ¥Ó½Ð¤H : Almirall, S.A.
¦a§} : Ronda General Mitre, 151, 08022 Barcelona, Spain
°êÄy : ¦è¯Z¤ú
¬¡°Ê : °Ó·~¤Î¤u·~
[511] Ãþ§O : 5
[511] ²£«~ : Preparações farmacêuticas, preparações químico-farmacêuticas, medicamentos para uso humano, medicamentos para uso médico, pomadas para uso farmacêutico, preparações biológicas para uso médico, preparações de microrganismos para uso médico ou veterinário, produtos de microrganismos para uso médico ou veterinário, meios para culturas bacteriológicas para fins médicos ou veterinários, preparações de diagnóstico para fins médicos, reagentes químicos para fins médicos ou veterinários.
[540] °Ó¼Ð :

[210] ½s¸¹ : N/242045
[220] ¥Ó½Ð¤é : 2025/06/27
[730] ¥Ó½Ð¤H : Almirall, S.A.
¦a§} : Ronda General Mitre, 151, 08022 Barcelona, Spain
°êÄy : ¦è¯Z¤ú
¬¡°Ê : °Ó·~¤Î¤u·~
[511] Ãþ§O : 35
[511] ªA°È : Assistência na direção de negócios comerciais, consultadoria profissional em negócios comerciais, pesquisas comerciais, investigações em negócios comerciais, serviços de intermediação comercial; serviços de agência de importação e exportação, marketing, promoção de vendas para terceiros, serviços de aquisição para terceiros [compra de bens e serviços para outras empresas], fornecimento de um mercado em linha para compradores e vendedores de bens e serviços; serviços de venda a retalho de preparações farmacêuticas, veterinárias e higiénicas e de material médico, serviços de venda por grosso de preparações farmacêuticas, veterinárias e higiénicas e de material médico.
[540] °Ó¼Ð :

[210] ½s¸¹ : N/242046
[220] ¥Ó½Ð¤é : 2025/06/27
[730] ¥Ó½Ð¤H : Almirall, S.A.
¦a§} : Ronda General Mitre, 151, 08022 Barcelona, Spain
°êÄy : ¦è¯Z¤ú
¬¡°Ê : °Ó·~¤Î¤u·~
[511] Ãþ§O : 41
[511] ªA°È : Serviços de instrução, serviços educativos; organização e condução de seminários, organização e condução de simpósios, organização e condução de workshops [formação]; fornecimento de publicações eletrónicas em linha, não descarregáveis.
[540] °Ó¼Ð :

[210] ½s¸¹ : N/242047
[220] ¥Ó½Ð¤é : 2025/06/27
[730] ¥Ó½Ð¤H : Almirall, S.A.
¦a§} : Ronda General Mitre, 151, 08022 Barcelona, Spain
°êÄy : ¦è¯Z¤ú
¬¡°Ê : °Ó·~¤Î¤u·~
[511] Ãþ§O : 42
[511] ªA°È : Investigação tecnológica, realização de estudos de projetos técnicos, investigação científica; investigação e desenvolvimento de medicamentos, desenvolvimento de formulações farmacêuticas e medicamentos, serviços de desenvolvimento de medicamentos, avaliação de medicamentos, investigação técnica na área da investigação de medicamentos, investigação bacteriológica, investigação biológica, ensaios clínicos, investigação médica; testes farmacêuticos, testes de produtos, testes de produtos químicos; design industrial, design de embalagens, estilismo [design industrial].
[540] °Ó¼Ð :

[210] ½s¸¹ : N/242048
[220] ¥Ó½Ð¤é : 2025/06/27
[730] ¥Ó½Ð¤H : Almirall, S.A.
¦a§} : Ronda General Mitre, 151, 08022 Barcelona, Spain
°êÄy : ¦è¯Z¤ú
¬¡°Ê : °Ó·~¤Î¤u·~
[511] Ãþ§O : 44
[511] ªA°È : Aconselhamento em farmácia, aconselhamento sobre medicação, serviços de consultadoria relacionados com cuidados de saúde, prestação de informações médicas, consultas médicas, prestação de informações médicas através de websites.
[540] °Ó¼Ð :

[210] ½s¸¹ : N/242053
[220] ¥Ó½Ð¤é : 2025/06/27
[730] ¥Ó½Ð¤H : ì¤lÃÄ·~¤@¤H¦³¤½¥q
¦a§} : ¿Dªù¬Ý¥xµó158¸¹¬uºÑªá¶é¡]²Ä1¡B2´Á¡^¦a¤US®y
°êÄy : ®Ú¾Ú¿Dªùªk¨Ò¦¨¥ß
¬¡°Ê : °Ó·~
[511] Ãþ§O : 35
[511] ªA°È : ¼s§i¡A¹ê·~¸gÀç¡A¹ê·~ºÞ²z¡A¿ì¤½¨Æ°È¡C
[540] °Ó¼Ð :

[591] °Ó¼ÐÃC¦â : ¾í¦â¡B¥Õ¦â¡A¦p¹Ï©Ò¥Ü¡C
[210] ½s¸¹ : N/242054
[220] ¥Ó½Ð¤é : 2025/06/27
[730] ¥Ó½Ð¤H : ì¤lÃÄ·~¤@¤H¦³¤½¥q
¦a§} : ¿Dªù¬Ý¥xµó158¸¹¬uºÑªá¶é¡]²Ä1¡B2´Á¡^¦a¤US®y
°êÄy : ®Ú¾Ú¿Dªùªk¨Ò¦¨¥ß
¬¡°Ê : °Ó·~
[511] Ãþ§O : 5
[511] ²£«~ : Âå¥Î©MÃ~Âå¥Î»s¾¯¡AÂå¥Î½Ã¥Í»s¾¯¡AÂå¥ÎÀç¾i«~¡AÀ¦¨à¹«~¡A»IÃÄ¡AÁ^¼Å§÷®Æ¡A¶ñ¶ë¤ú¤Õ©M¤ú¼Ò¥Î®Æ¡A®ø¬r¾¯¡A®ø·À¦³®`°Êª«»s¾¯¡A±þ¯uµß¾¯¡A°£²û¾¯¡C
[540] °Ó¼Ð :

[591] °Ó¼ÐÃC¦â : ºñ¦â¡BÂŦâ¡A¦p¹Ï©Ò¥Ü¡C
[210] ½s¸¹ : N/242055
[220] ¥Ó½Ð¤é : 2025/06/27
[730] ¥Ó½Ð¤H : ì¤lÃÄ·~¤@¤H¦³¤½¥q
¦a§} : ¿Dªù¬Ý¥xµó158¸¹¬uºÑªá¶é¡]²Ä1¡B2´Á¡^¦a¤US®y
°êÄy : ®Ú¾Ú¿Dªùªk¨Ò¦¨¥ß
¬¡°Ê : °Ó·~
[511] Ãþ§O : 29
[511] ²£«~ : ¥¤¤Î¥¤»s«~¡A¥]¬AÅø¸Ë¥¤¯»¡B³U¸Ë¥¤¯»¡B²°¸Ë¥¤¯»¡B²°¸Ë¤ô¥¤¡B³U¸Ë¤ô¥¤¡B¤û¥¤¤ù¡C
[540] °Ó¼Ð :

[591] °Ó¼ÐÃC¦â : ÂŦâ¡Bºñ¦â¡A¦p¹Ï©Ò¥Ü¡C
[210] ½s¸¹ : N/242057
[220] ¥Ó½Ð¤é : 2025/06/27
[730] ¥Ó½Ð¤H : §D¤@µ¦¹º¦³¤½¥q
¦a§} : »´ä¯þÆW®ü²±¸ô11¸¹ONE MIDTOWN 12¼Ó01«Ç
°êÄy : ®Ú¾Ú»´äªk¨Ò¦¨¥ß
¬¡°Ê : °Ó·~¤Î¤u·~
[511] Ãþ§O : 24
[511] ²£«~ : ¤j¯D¤y¡F§É³æ©MªE®M¡F§É³æ®M¸Ë¡F§É¹Ô«OÅ@®M¡]§É¤W¥Î«~¡^¡F§É¥Î»\³Q¡F§É³Q¡F·b¾þ¤y¡FªE®M¡FªE¤y¡FªEÀY®M¡F¤ò¤y¡F¤ò¤y¥¬¡F¤ò¤y³Q¡F¬~Áy¤ò¤y¡F¯D¤y¡F¯¼Â´«~¤ò¤y¡F¯¼Â´«~¬~Áy¤y¡F¯¼Â´«~»s°¨±í»\¸n¡F»\³Q®M¡F³Q®M¡F³Q¤l¡F³Q³U¡F³Q±¡F¤@¦¸©Ê¤ò¤y¡F¥R®ðºÎ³U¡F¤k¤h¤º¦ç¥Î°w´¼u©Ê´ª«¡F¬~¸J¤y¡FµL¯¼¥¬¡F¼p©Ð¥Î¤ò¤y¡C
[540] °Ó¼Ð :

[210] ½s¸¹ : N/242058
[220] ¥Ó½Ð¤é : 2025/06/27
[730] ¥Ó½Ð¤H : ©¾À\¶¼¤å¤Æ¦³¤½¥q
¦a§} : »´ä¤EÀs¦y¨F©C»®¼w¹D8¸¹25¼ÓC«Ç
°êÄy : ®Ú¾Ú»´äªk¨Ò¦¨¥ß
¬¡°Ê : °Ó·~¤Î¤u·~
[511] Ãþ§O : 43
[511] ªA°È : ©@°ØÀ]ªA°È¡F³J¿|ã÷ªá¡F¾Ç®Õ¹°óªA°È¡F¦bÀ\À]¤º¬°»««È¨ÑÀ³¹«~©M¶¼®Æ¡F¹ª«ÂIµûªA°È¡]´£¨Ñ¦³Ãö¹ª«©M¶¼®Æªº«H®§¡^¡F¹ª«ÀJ¨è¡F¥~½æÀ\À]ªA°È¡F¨p¤H¼p®vªA°È¡FÀ\ÆU¡F¦Û§UÀ\ÆUªA°È¡F§ÖÀ\©±ªA°È¡F¥~½æÀ\ÆUªA°È¡F¨ÑÀ³¯Q¥VÄÑ©MëL³ÁÄѪºÀ\À]¡F¤é¦¡À\À]ªA°È¡C
[540] °Ó¼Ð :

[210] ½s¸¹ : N/242065
[220] ¥Ó½Ð¤é : 2025/06/30
[730] ¥Ó½Ð¤H : GUERLAIN
¦a§} : 68, Avenue Des Champs-Elysees, 75008 Paris, France
°êÄy : ªk°ê
¬¡°Ê : °Ó·~¤Î¤u·~
[511] Ãþ§O : 1
[511] ²£«~ : Substâncias químicas e ingredientes como parte da composição de produtos cosméticos.
[540] °Ó¼Ð :

[300] Àu¥ýÅv : 2025/01/15¡Aªk°ê França¡A½s¸¹N.º 255112777
[210] ½s¸¹ : N/242066
[220] ¥Ó½Ð¤é : 2025/06/30
[730] ¥Ó½Ð¤H : ^¯Sºû¤u¨ã¦³¤½¥q
¦a§} : ·s¥[©Y¯Q¬ü1µó55¸¹2¼Ó5«Ç¡A¶l½s408935
°êÄy : ·s¥[©Y
¬¡°Ê : °Ó·~¤Î¤u·~
[511] Ãþ§O : 6
[511] ²£«~ : ¥¼¥[¤u©Î¥b¥[¤u´¶³qª÷ÄÝ¡Fª÷ÄݺޡFª÷ÄÝ®Mµ©¡]ª÷ÄÝ»s«~¡^¡F«Ø¿v¥Îª÷Äݪþ¥ó¡FÅK¸ôª÷Äݧ÷®Æ¡F®¹²Ï¥Îª÷Äݱa¡FÆl÷©MºÞ¹D¥Îª÷Äݧ¨¡F¤ª÷¾¹¨ã¡F´¶³qª÷Äݦ©¡]¤ª÷¾¹¨ã¡^¡Fª÷Äݰv¡F³ÃѥΪ÷Äݪþ¥ó¡Fª÷Äݪù¹a¡]«D¹q°Ê¡^¡Fª÷ÄÝÂê¡]«D¹q¡^¡Fª÷Äݱ¾Âê¡]«D¹q¤l¡^¡Fª÷ÄÝÆ_°Í¡F«OÀIÂd¡Fª÷Äݪê¹X¤ö¡Fª÷Äݤu¨ã½c¡]ªÅ¡^¡Fª÷ÄݼÐÅÒ¡F°Êª«±¾¹a¡Fª÷Äݲk±ø¡FÁã¡Fª÷ÄÝ»s¨¥÷ų§O¤âÀô¡Fª÷ÄÝ·¦V¼Ð¡F¾ð¤ìª÷ÄÝ«OÅ@¾¹¡F®·³¥Ã~³´¨À¡F´¶³qª÷ÄÝÃÀ³N«~¡FÅKÄq¥Û¡Fª÷Äݬö©À¸O¡Fª÷Äݨ¤ÅK¡Fª÷Äݤä¬[¡FºÞ¹D¥Îª÷ÄÝÅsÀY¡FºÞ¹D¥Îª÷ÄݱµÀY¡Fª÷Äݻ֪ù¡]«D¾÷¾¹³¡¥ó¡^¡FºÞ¹D¥Îª÷ÄÝ¥[©T§÷®Æ¡Fºò©TºÞ¹D¥Îª÷ÄÝÀô¡Fª÷Äݼӱè¡F¥i²¾°Êª÷Äݫؿvª«¡Fª÷Äݬ]Äæ¡Fª÷Äݫؿv§÷®Æ¡Fª÷Äݸ}¤â¬[¡F¿ûµ·¡Fª÷ÄÝ÷¯Á¡Fª÷ÄÝ¿±µÈÁ³®ê¡Fª÷ÄÝÁ³µ·¡Fª÷ÄݦX¶¡F鈎¤l¡]ª÷Äݾ¹¨ã¡^¡Fª÷Äݷƽü¡]«D¾÷¾¹¥Î¡^¡Fª÷ÄÝ»O¶¥¡]±è¤l¡^¡Fª÷Äݲkµ·¡Fª÷ÄݼQÀY¡F´¶³qª÷ÄݦXª÷¡C
[540] °Ó¼Ð :

[300] Àu¥ýÅv : 2025/02/14¡A·s¥[©Y Singapura¡A½s¸¹N.º 40202503721P
[210] ½s¸¹ : N/242067
[220] ¥Ó½Ð¤é : 2025/06/30
[730] ¥Ó½Ð¤H : ^¯Sºû¤u¨ã¦³¤½¥q
¦a§} : ·s¥[©Y¯Q¬ü1µó55¸¹2¼Ó5«Ç¡A¶l½s408935
°êÄy : ·s¥[©Y
¬¡°Ê : °Ó·~¤Î¤u·~
[511] Ãþ§O : 7
[511] ²£«~ : ¹A·~¾÷±ñ¡F³Î¯ó¾÷¡F¤ô±Ú¦À³q®ð¬¦¡F¯ó®Æ¤Á³Î¾÷¡FÀ½¥¤¾÷¡F¹q°Ê°Å¤ò¾÷¡F¤ì§÷¥[¤u¾÷¡F¾÷¿÷¡]¾÷¾¹¡^¡F¯ÈªO¾÷¡F¦L¨ê¾÷¾¹¡F»s¹«~¥Î¹q°Ê¾÷±ñ¡F·Ï¯ó¥[¤u¾÷¡FÁ_¦X¾÷¡F¦Û¦æ¨®²Õ¸Ë¾÷±ñ¡FÀJ¨è¾÷¡F¹q¦À¾÷±ñ¡F¥]¸Ë¾÷±ñ¡F¼p©Ð¥Î¹q°Ê¾÷¾¹¡F¬~¦ç¾÷¡FÂ÷¤ß½V¿i¾÷¡FÂH½¦¾÷¡F¤ÁÂ_¾÷¡]¾÷¾¹¡^¡F¥Ûªo±M¥Î©âªo¬¦¡FÅͩվ÷¡F¯»¸H¾÷¡F°_«¸¬Äª¡F®ðÁè¡F¾ã×¾÷¡]¾÷±ñ¥[¤u¸Ë¸m¡^¡Fű³y¾÷±ñ¡Fª÷ÄÝ¥[¤u¾÷±ñ¡F¤º¿U¾÷ÂI¤õ¸Ë¸m¡F¾÷±ñ¥x¬[¡F¤Á³Î¾÷¡F»s³y¹q½u¡B¹qÆl¥Î¾÷±ñ¡F¤M¨ã¡]¾÷¾¹³¡¥ó¡^¡F©ß¥ú¾÷¾¹©M³]³Æ¡]¹q°Êªº¡^¡FÆpÀY¡]¾÷¾¹³¡¥ó¡^¡F«D¤â°Êªº¤â«ù¤u¨ã¡F¨¤¦V¿i¥ú¾÷¡F¼Qº£¾÷¡Fµo¹q¾÷¡F«D³°¦a¨®½ø¥Î°¨¹F¡F¬¦¡]¾÷¾¹¡^¡F»Ö¡]¾÷¾¹³¡¥ó¡^¡FªÅ®ðÀ£ÁY¾÷¡F®ðÀ£¬û¡]¾÷¾¹³¡¥ó¡^¡F«D³°¦a¨®½ø¥Î±À¶i¸Ë¸m¡F¶b©Ó¡]¾÷¾¹³¡¥ó¡^¡F¾÷¾¹¶Ç°Ê±a¡F¹q²k¾÷¡F¹q°Ê²M¼ä¾÷±ñ©M³]³Æ¡F°ªÀ£¬~º°¾÷¡F¯uªÅ§l¹Ð¾¹¡FÀ£Âo¾÷¡F¹q°Ê¨÷ªù¾÷¡F¹q°ÊÀ¿¾c¾÷¡F¹q°Ê¶}ªù¾¹¡F¹q°Ê°Å¤M¡F¤â¹qÆp¡]¤£¥]¬A¹q·ÑÆp¡^¡F®ð°Ê¥´°vºj¡Fªoº£¼Qºj¡F¹q°ÊÃöªù¾¹¡F¹q°Ê¶}µ¡¾¹¡F¹q°ÊÃöµ¡¾¹¡F»]¨T©ì§â¡F¯uªÅ§l¹Ð¾¹¥Î¼QÅx»¤ô©M®ø¬r²Gªºªþ¥ó¡F»]¨T²M¼ä¾¹±ñ¡F²M¬~¦a´à¥Î¹q°Ê¾÷¾¹©M¸Ë¸m¡F§l¹Ð¾¹¥Î¨ê¡Fµ±¦×¾÷¡]¾÷±ñ¡^¡F¤d¤ç³»¡]¾÷¾¹¡^¡F·°Ê¤â¤u¨ã¡F¥¤ªo¾÷¡F¤ÁÄÑ¥]¾÷¡F©MÄѾ÷¡F¿i±¾÷¡F¹q°Êº^¥Ä¾÷¡F¹q°Ê»s¶¼®Æ¾÷¡F°®¬~¾÷¡FÀ£¸ô¾÷¡F¤u·~¾÷¾¹¤H¡F®a¥Î¹q°Ê¥´³J¾¹¡F®a¥Î«D¤â°Ê¬ã¿i¾÷¡F«D¤â°Ê¿i©@°Ø¾÷¡C
[540] °Ó¼Ð :

[300] Àu¥ýÅv : 2025/02/14¡A·s¥[©Y Singapura¡A½s¸¹N.º 40202503721P
[210] ½s¸¹ : N/242068
[220] ¥Ó½Ð¤é : 2025/06/30
[730] ¥Ó½Ð¤H : ^¯Sºû¤u¨ã¦³¤½¥q
¦a§} : ·s¥[©Y¯Q¬ü1µó55¸¹2¼Ó5«Ç¡A¶l½s408935
°êÄy : ·s¥[©Y
¬¡°Ê : °Ó·~¤Î¤u·~
[511] Ãþ§O : 8
[511] ²£«~ : ¿i¨ã¡]¤â¤u¨ã¡^¡F¹A·~¾¹¨ã¡]¤â°Êªº¡^¡F¶éÃÀ¤u¨ã¡]¤â°Êªº¡^¡F¤â¤u¾Þ§@¤â¤u¨ã¥Î¤u¨ã¬`¡F¤â°Êªº¤â¤u¨ã¡F°Êª«é¥Ö¥Î¾¹¨ã©M¤u¨ã¡F³½¤e¡F׫ü¥Ò¦¨®M¤u¨ã¡FÆpÀY¡]¤â¤u¨ã³¡¥ó¡^¡F¬ï¤Õ¤u¨ã¡]¤â¤u¨ã¡^¡F¹g°vºj¡]¤â¤u¨ã¡^¡F¤â°Ê¤d¤ç³»¡F¤â°Ê½¦ÂH¾¯À½À£ºj¡FÀJ¨è¤u¨ã¡]¤â¤u¨ã¡^¡F¿j¥Ë¦K¥Îªd¤M¡FתK°Å¡F¨Ø¤M¡FÀ\¨ã¡]¤M¡B¤e©M°Í¡^¡F«cޤM¡F¨÷¾v¥Î¤â¤u¨ã¡F¼÷¤æ¡C
[540] °Ó¼Ð :

[300] Àu¥ýÅv : 2025/02/14¡A·s¥[©Y Singapura¡A½s¸¹N.º 40202503721P
[210] ½s¸¹ : N/242069
[220] ¥Ó½Ð¤é : 2025/06/30
[730] ¥Ó½Ð¤H : ^¯Sºû¤u¨ã¦³¤½¥q
¦a§} : ·s¥[©Y¯Q¬ü1µó55¸¹2¼Ó5«Ç¡A¶l½s408935
°êÄy : ·s¥[©Y
¬¡°Ê : °Ó·~¤Î¤u·~
[511] Ãþ§O : 9
[511] ²£«~ : pºâ¾÷µ{§Ç¡]¥i¤U¸ü³n¥ó¡^¡Fp¼Æ¾¹¡FÅç¶r¾÷¡F¹q¤l¥X²¼¾÷¡F§ë²¼¾÷¡F¤HÁyÃѧO³]³Æ¡F¿Å¶q¾¹¨ã¡F´ú¶q¸Ë¸m¡F¹q¤l¤½§iµP¡F¹q¤Î¹q¤lµøÀWºÊ±±³]³Æ¡F·Ó¬Û¾÷¡]Äá¼v¡^¡F´ú¶q¾¹±ñ©M»ö¾¹¡F¤ô¥»ö¡]´ú¤ô¥½u»ö¾¹¡^¡F¹B¸ü¤u¨ã¥Î´ú³t»ö¡F´úÀ£»ö¾¹¡F¹q´ú¶q»ö¾¹¡F«DÂå¥Î¿E¥ú¾¹¡F¥ú¾Ç¾¹±ñ©M»ö¾¹¡F¹q·½§÷®Æ¡]¹q½u¡B¹qÆl¡^¡F¥b¾ÉÅé¡F¹q¤lªä¤ù¡F¹q®e¾¹¡F¹q¶}Ãö¡F¹q¾¹±µ´¡¥ó¡F¹q´¡ÀY¡F±±¨îªO¡]¹q¡^¡F¹q·½´¡®y¸n¡FµøÀWÅã¥Ü«Ì¡F»»±±¸Ë¸m¡F¥ú¾ÇÅÖºû¡]¥ú¾ÉÅÖºû¡^¡F¼ö½Õ¸`¸Ë¸m¡FÁ×¹p¾¹¡F¹êÅç«Ç¥Î¹q¸Ñ¸Ë¸m¡F·À¤õ³]³Æ¡FÓ¤H¥Î¨¾¨Æ¬G¸Ë¸m¡F¨¾¨Æ¬G¡B¨¾¿ç®g¡B¨¾¤õ¥ÎªA¸Ë¡F¤u¤H¥Î¨¾Å@±¸n¡F¨¾¨Æ¬G¥Î¤â®M¡F¤u¤H¥ÎÅ@½¥¹Ô¡F¹q¤l¨¾µs¸Ë¸m¡F¹qÂê¡F²´Ãè¡F¹q¦À¡F¹q¦À¥R¹q¾¹¡F¤u·~¦w¥þ¹u¡F¹q´¡®y¡F¹q±µÄ²¾¹¡F¼ç¤ô¥Î¦Õ¶ë¡F¥Íª««ü¯¾ªùÂê¡F¤u·~¥Î¤º¿sÃèÄá¹³ÀY¡F¹B¸ü¤u¨ã¥Î«áµøÄá¹³ÀY¡F¶Ç·P¾¹¡F³øÄµ¾¹¡F´Án¾¹µ½c¡F²¾°Ê¹q·½¡]¥i¥R¹q¹q¦À¡^¡F¦æ¨®°O¿ý»ö¡FÅ髯¯¡FµL½u¹q±µ¦¬¾÷©Mµo®g¾÷¡FµL½u¹q«H¸¹½Õ¿Ó¾¹¡F¹qªù¹a¡F¹ïÁ¿¾÷¡F¥iµø¹q¸Ü¾÷¡FµøÀWºÊ±±¾¹¡FªÅ®ð¤ÀªR»ö¾¹¡FµL½u¸ô¥Ñ¾¹¡F¶q¨ã¡F¤Ø¡]¶q¾¹¡^¡F¹q¤l¹C¼Ð¥d¤Ø¡F¤d¤À¤Ø¡F¹C¼Ð¥d¤Ø¡F¨÷¤Ø¡FµL½u¹q³]³Æ¡F´¼¼z¤â¿ö¡]¼Æ¾Ú³B²z¡^¡F´¼¼z²´Ãè¡]¼Æ¾Ú³B²z¡^¡F¥i¤U¸üªº¤â¾÷À³¥Î³n¥ó¡F¹qµø¾÷¡F«DÂå¥Î·Å«×p¡FÂ_¸ô¾¹¡F·ÏÃú±´´ú¾¹¡FÁpÂêªù¥Î¹q¤lªù¸T¸Ë¸m¡F®ðÅéÀË´ú»ö¡F¨¾¨Æ¬G¡B¨¾¿ç®g¡B¨¾¤õ¥Î¾c¡C
[540] °Ó¼Ð :

[300] Àu¥ýÅv : 2025/02/14¡A·s¥[©Y Singapura¡A½s¸¹N.º 40202503721P
[210] ½s¸¹ : N/242070
[220] ¥Ó½Ð¤é : 2025/06/30
[730] ¥Ó½Ð¤H : ^¯Sºû¤u¨ã¦³¤½¥q
¦a§} : ·s¥[©Y¯Q¬ü1µó55¸¹2¼Ó5«Ç¡A¶l½s408935
°êÄy : ·s¥[©Y
¬¡°Ê : °Ó·~¤Î¤u·~
[511] Ãþ§O : 11
[511] ²£«~ : ¹q¿O¡F·Ó©ú³]³Æ©M¸Ë¸m¡F¤é¥ú¿OºÞ¡F¹B¸ü¤u¨ã¥Î¿O¡FªÅ®ð²b¤Æ¥Î±þµß¿O¡F¿S¾v¥Î¿O¡Fªo¿O¡F²i½Õ¥Î¸Ë¸m©M³]³Æ¡F§N«o³]³Æ©M¸Ë¸m¡FªÅ®ð²b¤Æ¸Ë¸m©M¾÷¾¹¡F·®°¡]ªÅ®ð½Õ¸`¡^¡FÀY¾v¥Î§j·¾÷¡F¹q¥[¼ö¸Ë¸m¡F»R»O·ÏÃú¾÷¡FÀsÀY¡FºÞ¹D¡]½Ã¥Í³]³Æ³¡¥ó¡^¡F¦Û°Ê¼å¤ô¸Ë¸m¡F¯D«Ç¸Ë¸m¡F½Ã¥Í¾¹±ñ©M³]³Æ¡F¤ô²b¤Æ¸Ë¸m¡F¹q·x¾¹¡FµJÄl·Ñ®ðÂI¤õ¾¹¡F¿Oªw¡F±´·Ó¿O¡F¤â¹qµ©¡F§Ná³]³Æ©M¸Ë¸m¡FªÅ®ð½Õ¸`³]³Æ¡F¤ô²b¤Æ³]³Æ©M¾÷¾¹¡F«KÄ⦡¨ú·x¾¹¡FªÅ®ð²b¤Æ¾¹¡]®a¥Î¡^¡F®a¥Î¹q²b¤ô¾¹¡F®a¥Î¥[Àã¾¹¡F¹q¼ö¤ô³ý¡F¼p©Ð¥Î©âªo·Ï¾÷¡F·Ñ®ð¨_¡F¼ö·ºj¡F±Û¶ë¡]ºÞ©MºÞ¹D¥Î¡^¡F®ø¬r³]³Æ¡F¹q¼öªA¸Ë¡F¹qª¤¨ã¡F¯NÄÑ¥]¤ù¾÷¡F¯N½L¡]²i¶¹³]³Æ¡^¡F§NÂÃÂd¡F»s¦B¾÷©M³]³Æ¡FªÅ®ð¦A¼ö¾¹¡FªÅ®ð°®Àê¾¹¡FªÅ®ð®ø¬r¾¹¡F®ðÅé§N¾®¾¹¡]«D¾÷¾¹³¡¥ó¡^¡F´ª«»]¨T±¾¿S¾÷¡F¼Q¤ô¾¹¡F¶i¤ô¸Ë¸m¡F¤ô¹LÂo¾¹¡F¿U®ðÄl¡F¼p©ÐÄl¨_¡]¯M½c¡^¡F¹q¥[À£ª¤¨ã¡F¥¤²~¥Î¹q¥[¼ö¾¹¡F¹q©@°Øº¯Âo³ý¡F¹qªo¬µÁç¡F·LªiÄl¡]¼p©Ð¥Î¨ã¡^¡F¹q¼ö»s»Ä¥¤¾¹¡F¹q»]Áç¡F§N¼ö¶¼®Æ¾÷¡]¥[¼ö©Î»s§N¡^¡FªÅ®ð¬µÁç¡F¹q¨§¼ß¾÷¡F¹q©@°Ø¾÷¥ÎªÅ©@°Ø½¦Ån¡F¥[Àã¾¹¡FÀsÀY¨¾Âq¼Q¼L¡F¿O¡F®a¥Î¯N½c¡F®a¥Î¹q¶ºÁç¡F¹q°Ê©@°Ø¾÷¡C
[540] °Ó¼Ð :

[300] Àu¥ýÅv : 2025/02/14¡A·s¥[©Y Singapura¡A½s¸¹N.º 40202503721P
[210] ½s¸¹ : N/242071
[220] ¥Ó½Ð¤é : 2025/06/30
[730] ¥Ó½Ð¤H : ^¯Sºû¤u¨ã¦³¤½¥q
¦a§} : ·s¥[©Y¯Q¬ü1µó55¸¹2¼Ó5«Ç¡A¶l½s408935
°êÄy : ·s¥[©Y
¬¡°Ê : °Ó·~¤Î¤u·~
[511] Ãþ§O : 35
[511] ªA°È : ¼s§i¡Fpºâ¾÷ºôµ¸¤Wªº¦b½u¼s§i¡F²Õ´°Ó·~©Î¼s§i®iÄý¡F¶i¥X¤f¥N²z¡F´À¥L¤H±À¾P¡F´À¥L¤H±ÄÁÊ¡]´À¨ä¥L¥ø·~ÁʶR°Ó«~©ÎªA°È¡^¡F¿ì¤½¾÷¾¹©M³]³Æ¥X¯²¡F¦Û°Ê°â³f¾÷¥X¯²¡F¾P°â®i¥Ü¬[¥X¯²¡F¥«³õÀç¾P¡F¬°°Ó«~©MªA°Èªº¶R½æÂù¤è´£¨Ñ¦b½u¥«³õ¡C
[540] °Ó¼Ð :

[300] Àu¥ýÅv : 2025/02/14¡A·s¥[©Y Singapura¡A½s¸¹N.º 40202503721P
[210] ½s¸¹ : N/242072
[220] ¥Ó½Ð¤é : 2025/06/30
[730] ¥Ó½Ð¤H : ÂE´®a©~¦³¤½¥q
¦a§} : ¤¤°ê´ò«n¬Ùªø¨F¥««Bªá°ÏªF¶íµó¹DªÜ»T¤¤¸ô¤T¬q567¸¹¿³·~»È¦æ¤j·H2101©Ð
°êÄy : ¤¤°ê
¬¡°Ê : °Ó·~¤Î¤u·~
[511] Ãþ§O : 20
[511] ²£«~ : ¦çÂd¡F¿ì¤½³ÃÑ¡F®ÑÂd¡F¦³©â±PªºÃo¡F¨Fµo¡Fª÷ÄÝÃoÂd¡FÃoÂd¡FÀ\¨ãÂd¡F®Ñ®à¡F«Dª÷Äݤj±í¡F¦Ë¤ì¤uÃÀ«~¡F§É¥Î¹Ô¿È¡]§É¥Î´«~°£¥~¡^¡F³ÃѥΫDª÷Äݪþ¥ó¡Fªù¥Î«Dª÷Äݪþ¥ó¡F¶ì®Æ¤ôºÞ»Ö¡C
[540] °Ó¼Ð :

[210] ½s¸¹ : N/242073
[220] ¥Ó½Ð¤é : 2025/06/30
[730] ¥Ó½Ð¤H : ÂE´®a©~¦³¤½¥q
¦a§} : ¤¤°ê´ò«n¬Ùªø¨F¥««Bªá°ÏªF¶íµó¹DªÜ»T¤¤¸ô¤T¬q567¸¹¿³·~»È¦æ¤j·H2101©Ð
°êÄy : ¤¤°ê
¬¡°Ê : °Ó·~¤Î¤u·~
[511] Ãþ§O : 35
[511] ªA°È : ¼s§i¡F°Ó·~Ãoµ¡§G¸m¡F¬°¥L¤H±ÄÁÊ¡]¬°¨ä¥L¥ø·~ÁʶR°Ó«~©ÎªA°È¡^¡F°Ó·~ºÞ²z¿Ô¸ß¡F¬°«Ø¿v¶µ¥Ø¶i¦æ°Ó·~¶µ¥ØºÞ²zªA°È¡F¶º©±°Ó·~ºÞ²z¡F¬°¥L¤H±À¾P¡F¶i¥X¤f¥N²z¡Fºtûªº°Ó·~ºÞ²z¡FÃĥΡBÃ~Âå¥Î¡B½Ã¥Í¥Î»s¾¯©MÂåÀø¥Î«~ªº¹s°âªA°È¡C
[540] °Ó¼Ð :

[210] ½s¸¹ : N/242074
[220] ¥Ó½Ð¤é : 2025/06/30
[730] ¥Ó½Ð¤H : ÂE´®a©~¦³¤½¥q
¦a§} : ¤¤°ê´ò«n¬Ùªø¨F¥««Bªá°ÏªF¶íµó¹DªÜ»T¤¤¸ô¤T¬q567¸¹¿³·~»È¦æ¤j·H2101©Ð
°êÄy : ¤¤°ê
¬¡°Ê : °Ó·~¤Î¤u·~
[511] Ãþ§O : 37
[511] ªA°È : «Ø¿v¡F¤u¼t«Ø³y¡F«Ç¤º¸ËæC¡F«Ç¤º¸ËæCײz¡F¼p©Ð³]³Æ¦w¸Ë¡F³ÃÑ«O¾i¡F¦w¸Ë³ÃѮɪº²Õ¸ËªA°È¡F«Ø¿v¬I¤uºÊ·þ¡F«Ø¿v¿Ô¸ß¡F®ø¬r¡C
[540] °Ó¼Ð :

[210] ½s¸¹ : N/242075
[220] ¥Ó½Ð¤é : 2025/06/30
[730] ¥Ó½Ð¤H : ÂE´®a©~¦³¤½¥q
¦a§} : ¤¤°ê´ò«n¬Ùªø¨F¥««Bªá°ÏªF¶íµó¹DªÜ»T¤¤¸ô¤T¬q567¸¹¿³·~»È¦æ¤j·H2101©Ð
°êÄy : ¤¤°ê
¬¡°Ê : °Ó·~¤Î¤u·~
[511] Ãþ§O : 42
[511] ªA°È : «Ç¤º¸Ë¹¢³]p¡F«Ç¤º³]p¡F«Ø¿v»s¹Ï¡F«Ø¿v»â°ìªº¬ã¨s¡F¤H¤u´¼¯à§Þ³N¿Ô¸ß¡F§Þ³N¬ã¨s¡Fpºâ¾÷³n¥ó³]p¡F¥]¸Ë³]p¡F¬°¥L¤H¬ã¨s©M¶}µo·s²£«~¡F§÷®Æ´ú¸Õ¡C
[540] °Ó¼Ð :

[210] ½s¸¹ : N/242076
[220] ¥Ó½Ð¤é : 2025/06/30
[730] ¥Ó½Ð¤H : ÂE´®a©~¦³¤½¥q
¦a§} : ¤¤°ê´ò«n¬Ùªø¨F¥««Bªá°ÏªF¶íµó¹DªÜ»T¤¤¸ô¤T¬q567¸¹¿³·~»È¦æ¤j·H2101©Ð
°êÄy : ¤¤°ê
¬¡°Ê : °Ó·~¤Î¤u·~
[511] Ãþ§O : 20
[511] ²£«~ : ¦çÂd¡F¿ì¤½³ÃÑ¡F®ÑÂd¡F¦³©â±PªºÃo¡F¨Fµo¡Fª÷ÄÝÃoÂd¡FÃoÂd¡FÀ\¨ãÂd¡F®Ñ®à¡F«Dª÷Äݤj±í¡F¦Ë¤ì¤uÃÀ«~¡F§É¥Î¹Ô¿È¡]§É¥Î´«~°£¥~¡^¡F³ÃѥΫDª÷Äݪþ¥ó¡Fªù¥Î«Dª÷Äݪþ¥ó¡F¶ì®Æ¤ôºÞ»Ö¡C
[540] °Ó¼Ð :

[210] ½s¸¹ : N/242077
[220] ¥Ó½Ð¤é : 2025/06/30
[730] ¥Ó½Ð¤H : ÂE´®a©~¦³¤½¥q
¦a§} : ¤¤°ê´ò«n¬Ùªø¨F¥««Bªá°ÏªF¶íµó¹DªÜ»T¤¤¸ô¤T¬q567¸¹¿³·~»È¦æ¤j·H2101©Ð
°êÄy : ¤¤°ê
¬¡°Ê : °Ó·~¤Î¤u·~
[511] Ãþ§O : 35
[511] ªA°È : ¼s§i¡F°Ó·~Ãoµ¡§G¸m¡F¬°¥L¤H±ÄÁÊ¡]¬°¨ä¥L¥ø·~ÁʶR°Ó«~©ÎªA°È¡^¡F°Ó·~ºÞ²z¿Ô¸ß¡F¬°«Ø¿v¶µ¥Ø¶i¦æ°Ó·~¶µ¥ØºÞ²zªA°È¡F¶º©±°Ó·~ºÞ²z¡F¬°¥L¤H±À¾P¡F¶i¥X¤f¥N²z¡Fºtûªº°Ó·~ºÞ²z¡FÃĥΡBÃ~Âå¥Î¡B½Ã¥Í¥Î»s¾¯©MÂåÀø¥Î«~ªº¹s°âªA°È¡C
[540] °Ó¼Ð :

[210] ½s¸¹ : N/242078
[220] ¥Ó½Ð¤é : 2025/06/30
[730] ¥Ó½Ð¤H : ÂE´®a©~¦³¤½¥q
¦a§} : ¤¤°ê´ò«n¬Ùªø¨F¥««Bªá°ÏªF¶íµó¹DªÜ»T¤¤¸ô¤T¬q567¸¹¿³·~»È¦æ¤j·H2101©Ð
°êÄy : ¤¤°ê
¬¡°Ê : °Ó·~¤Î¤u·~
[511] Ãþ§O : 37
[511] ªA°È : «Ø¿v¡F¤u¼t«Ø³y¡F«Ç¤º¸ËæC¡F«Ç¤º¸ËæCײz¡F¼p©Ð³]³Æ¦w¸Ë¡F³ÃÑ«O¾i¡F¦w¸Ë³ÃѮɪº²Õ¸ËªA°È¡F«Ø¿v¬I¤uºÊ·þ¡F«Ø¿v¿Ô¸ß¡F®ø¬r¡C
[540] °Ó¼Ð :

[210] ½s¸¹ : N/242079
[220] ¥Ó½Ð¤é : 2025/06/30
[730] ¥Ó½Ð¤H : ÂE´®a©~¦³¤½¥q
¦a§} : ¤¤°ê´ò«n¬Ùªø¨F¥««Bªá°ÏªF¶íµó¹DªÜ»T¤¤¸ô¤T¬q567¸¹¿³·~»È¦æ¤j·H2101©Ð
°êÄy : ¤¤°ê
¬¡°Ê : °Ó·~¤Î¤u·~
[511] Ãþ§O : 42
[511] ªA°È : «Ç¤º¸Ë¹¢³]p¡F«Ç¤º³]p¡F«Ø¿v»s¹Ï¡F«Ø¿v»â°ìªº¬ã¨s¡F¤H¤u´¼¯à§Þ³N¿Ô¸ß¡F§Þ³N¬ã¨s¡Fpºâ¾÷³n¥ó³]p¡F¥]¸Ë³]p¡F¬°¥L¤H¬ã¨s©M¶}µo·s²£«~¡F§÷®Æ´ú¸Õ¡C
[540] °Ó¼Ð :

[210] ½s¸¹ : N/242080
[220] ¥Ó½Ð¤é : 2025/06/30
[730] ¥Ó½Ð¤H : ÂE´®a©~¦³¤½¥q
¦a§} : ¤¤°ê´ò«n¬Ùªø¨F¥««Bªá°ÏªF¶íµó¹DªÜ»T¤¤¸ô¤T¬q567¸¹¿³·~»È¦æ¤j·H2101©Ð
°êÄy : ¤¤°ê
¬¡°Ê : °Ó·~¤Î¤u·~
[511] Ãþ§O : 20
[511] ²£«~ : ¦çÂd¡F¿ì¤½³ÃÑ¡F®ÑÂd¡F¦³©â±PªºÃo¡F¨Fµo¡Fª÷ÄÝÃoÂd¡FÃoÂd¡FÀ\¨ãÂd¡F®Ñ®à¡F«Dª÷Äݤj±í¡F¦Ë¤ì¤uÃÀ«~¡F§É¥Î¹Ô¿È¡]§É¥Î´«~°£¥~¡^¡F³ÃѥΫDª÷Äݪþ¥ó¡Fªù¥Î«Dª÷Äݪþ¥ó¡F¶ì®Æ¤ôºÞ»Ö¡C
[540] °Ó¼Ð :

[210] ½s¸¹ : N/242081
[220] ¥Ó½Ð¤é : 2025/06/30
[730] ¥Ó½Ð¤H : ÂE´®a©~¦³¤½¥q
¦a§} : ¤¤°ê´ò«n¬Ùªø¨F¥««Bªá°ÏªF¶íµó¹DªÜ»T¤¤¸ô¤T¬q567¸¹¿³·~»È¦æ¤j·H2101©Ð
°êÄy : ¤¤°ê
¬¡°Ê : °Ó·~¤Î¤u·~
[511] Ãþ§O : 35
[511] ªA°È : ¼s§i¡F°Ó·~Ãoµ¡§G¸m¡F¬°¥L¤H±ÄÁÊ¡]¬°¨ä¥L¥ø·~ÁʶR°Ó«~©ÎªA°È¡^¡F°Ó·~ºÞ²z¿Ô¸ß¡F¬°«Ø¿v¶µ¥Ø¶i¦æ°Ó·~¶µ¥ØºÞ²zªA°È¡F¶º©±°Ó·~ºÞ²z¡F¬°¥L¤H±À¾P¡F¶i¥X¤f¥N²z¡Fºtûªº°Ó·~ºÞ²z¡FÃĥΡBÃ~Âå¥Î¡B½Ã¥Í¥Î»s¾¯©MÂåÀø¥Î«~ªº¹s°âªA°È¡C
[540] °Ó¼Ð :

[210] ½s¸¹ : N/242082
[220] ¥Ó½Ð¤é : 2025/06/30
[730] ¥Ó½Ð¤H : ÂE´®a©~¦³¤½¥q
¦a§} : ¤¤°ê´ò«n¬Ùªø¨F¥««Bªá°ÏªF¶íµó¹DªÜ»T¤¤¸ô¤T¬q567¸¹¿³·~»È¦æ¤j·H2101©Ð
°êÄy : ¤¤°ê
¬¡°Ê : °Ó·~¤Î¤u·~
[511] Ãþ§O : 37
[511] ªA°È : «Ø¿v¡F¤u¼t«Ø³y¡F«Ç¤º¸ËæC¡F«Ç¤º¸ËæCײz¡F¼p©Ð³]³Æ¦w¸Ë¡F³ÃÑ«O¾i¡F¦w¸Ë³ÃѮɪº²Õ¸ËªA°È¡F«Ø¿v¬I¤uºÊ·þ¡F«Ø¿v¿Ô¸ß¡F®ø¬r¡C
[540] °Ó¼Ð :

[210] ½s¸¹ : N/242083
[220] ¥Ó½Ð¤é : 2025/06/30
[730] ¥Ó½Ð¤H : ÂE´®a©~¦³¤½¥q
¦a§} : ¤¤°ê´ò«n¬Ùªø¨F¥««Bªá°ÏªF¶íµó¹DªÜ»T¤¤¸ô¤T¬q567¸¹¿³·~»È¦æ¤j·H2101©Ð
°êÄy : ¤¤°ê
¬¡°Ê : °Ó·~¤Î¤u·~
[511] Ãþ§O : 42
[511] ªA°È : «Ç¤º¸Ë¹¢³]p¡F«Ç¤º³]p¡F«Ø¿v»s¹Ï¡F«Ø¿v»â°ìªº¬ã¨s¡F¤H¤u´¼¯à§Þ³N¿Ô¸ß¡F§Þ³N¬ã¨s¡Fpºâ¾÷³n¥ó³]p¡F¥]¸Ë³]p¡F¬°¥L¤H¬ã¨s©M¶}µo·s²£«~¡F§÷®Æ´ú¸Õ¡C
[540] °Ó¼Ð :

[210] ½s¸¹ : N/242084
[220] ¥Ó½Ð¤é : 2025/06/30
[730] ¥Ó½Ð¤H : ÂE´®a©~¦³¤½¥q
¦a§} : ¤¤°ê´ò«n¬Ùªø¨F¥««Bªá°ÏªF¶íµó¹DªÜ»T¤¤¸ô¤T¬q567¸¹¿³·~»È¦æ¤j·H2101©Ð
°êÄy : ¤¤°ê
¬¡°Ê : °Ó·~¤Î¤u·~
[511] Ãþ§O : 20
[511] ²£«~ : ¦çÂd¡F¿ì¤½³ÃÑ¡F®ÑÂd¡F¦³©â±PªºÃo¡F¨Fµo¡Fª÷ÄÝÃoÂd¡FÃoÂd¡FÀ\¨ãÂd¡F®Ñ®à¡F«Dª÷Äݤj±í¡F¦Ë¤ì¤uÃÀ«~¡F§É¥Î¹Ô¿È¡]§É¥Î´«~°£¥~¡^¡F³ÃѥΫDª÷Äݪþ¥ó¡Fªù¥Î«Dª÷Äݪþ¥ó¡F¶ì®Æ¤ôºÞ»Ö¡C
[540] °Ó¼Ð :

[210] ½s¸¹ : N/242085
[220] ¥Ó½Ð¤é : 2025/06/30
[730] ¥Ó½Ð¤H : ÂE´®a©~¦³¤½¥q
¦a§} : ¤¤°ê´ò«n¬Ùªø¨F¥««Bªá°ÏªF¶íµó¹DªÜ»T¤¤¸ô¤T¬q567¸¹¿³·~»È¦æ¤j·H2101©Ð
°êÄy : ¤¤°ê
¬¡°Ê : °Ó·~¤Î¤u·~
[511] Ãþ§O : 35
[511] ªA°È : ¼s§i¡F°Ó·~Ãoµ¡§G¸m¡F¬°¥L¤H±ÄÁÊ¡]¬°¨ä¥L¥ø·~ÁʶR°Ó«~©ÎªA°È¡^¡F°Ó·~ºÞ²z¿Ô¸ß¡F¬°«Ø¿v¶µ¥Ø¶i¦æ°Ó·~¶µ¥ØºÞ²zªA°È¡F¶º©±°Ó·~ºÞ²z¡F¬°¥L¤H±À¾P¡F¶i¥X¤f¥N²z¡Fºtûªº°Ó·~ºÞ²z¡FÃĥΡBÃ~Âå¥Î¡B½Ã¥Í¥Î»s¾¯©MÂåÀø¥Î«~ªº¹s°âªA°È¡C
[540] °Ó¼Ð :

[210] ½s¸¹ : N/242086
[220] ¥Ó½Ð¤é : 2025/06/30
[730] ¥Ó½Ð¤H : ÂE´®a©~¦³¤½¥q
¦a§} : ¤¤°ê´ò«n¬Ùªø¨F¥««Bªá°ÏªF¶íµó¹DªÜ»T¤¤¸ô¤T¬q567¸¹¿³·~»È¦æ¤j·H2101©Ð
°êÄy : ¤¤°ê
¬¡°Ê : °Ó·~¤Î¤u·~
[511] Ãþ§O : 37
[511] ªA°È : «Ø¿v¡F¤u¼t«Ø³y¡F«Ç¤º¸ËæC¡F«Ç¤º¸ËæCײz¡F¼p©Ð³]³Æ¦w¸Ë¡F³ÃÑ«O¾i¡F¦w¸Ë³ÃѮɪº²Õ¸ËªA°È¡F«Ø¿v¬I¤uºÊ·þ¡F«Ø¿v¿Ô¸ß¡F®ø¬r¡C
[540] °Ó¼Ð :

[210] ½s¸¹ : N/242087
[220] ¥Ó½Ð¤é : 2025/06/30
[730] ¥Ó½Ð¤H : ÂE´®a©~¦³¤½¥q
¦a§} : ¤¤°ê´ò«n¬Ùªø¨F¥««Bªá°ÏªF¶íµó¹DªÜ»T¤¤¸ô¤T¬q567¸¹¿³·~»È¦æ¤j·H2101©Ð
°êÄy : ¤¤°ê
¬¡°Ê : °Ó·~¤Î¤u·~
[511] Ãþ§O : 42
[511] ªA°È : «Ç¤º¸Ë¹¢³]p¡F«Ç¤º³]p¡F«Ø¿v»s¹Ï¡F«Ø¿v»â°ìªº¬ã¨s¡F¤H¤u´¼¯à§Þ³N¿Ô¸ß¡F§Þ³N¬ã¨s¡Fpºâ¾÷³n¥ó³]p¡F¥]¸Ë³]p¡F¬°¥L¤H¬ã¨s©M¶}µo·s²£«~¡F§÷®Æ´ú¸Õ¡C
[540] °Ó¼Ð :

[210] ½s¸¹ : N/242096
[220] ¥Ó½Ð¤é : 2025/06/30
[730] ¥Ó½Ð¤H : ´IºaÃÄ·~¦³¤½¥q
¦a§} : ¿Dªù¼}©Ô¤h«e¦a120¸¹¥Ã°í¤u·~¤j·H4¼ÓF®y
°êÄy : ®Ú¾Ú¿Dªùªk¨Ò¦¨¥ß
¬¡°Ê : °Ó·~
[511] Ãþ§O : 5
[511] ²£«~ : ²´ÃĤô¡C
[540] °Ó¼Ð :

[591] °Ó¼ÐÃC¦â : ¶Â¦â¡A¦p¹Ï©Ò¥Ü¡C
[210] ½s¸¹ : N/242097
[220] ¥Ó½Ð¤é : 2025/06/30
[730] ¥Ó½Ð¤H : GE WILLIAM WEI
¦a§} : ¿Dªù¤W®üµó175¸¹¿Dªù¤¤µØÁ`°Ó·|¤j·H16¼ÓA
°êÄy : ¬ü°ê
¬¡°Ê : °Ó·~¤Î¤u·~
[511] Ãþ§O : 9
[511] ²£«~ : Ó¤H¥Î¨¾¨Æ¬G¸Ë¸m¡FÁnµÄµ³ø¾¹¡F³øÄµ¾¹¡F¨¾¨Æ¬G¥Î¥Û´Ö¤â®M¡F¨¾¤õ¥Û´Ö¦ç¡F·À¤õ¾¹¡F¤õ¨a³øÄµ¾¹¡F¸¦æû¨¾Å@ªA¡F¸¦æû¦w¥þªA¡F¤õ¨a¼³¥´¾¹¡F¨¾Å@´U¡F«D¤H¤u©I§l¥Î¨¾¬r±¨ã¡F«H¸¹¹a¡F¤u¤H¥Î¨¾Å@±¸n¡F¦w¥þºô¡F¨¾¨Æ¬G¥Î¤â®M¡F¨¾¤õªA¸Ë¡F¨¾¤õ¦ç¡F±Ï¥Í¾¹±ñ©M³]³Æ¡F¤º³¡³q°T¸Ë¸m¡F¨¾Å@±¸n¡F¦w¥þ±¸n¡F²´Ãè¡F¹a¡]³øÄµ¸Ë¸m¡^¡F¨¾¤õªA¡Fĵ²Ã¡F¹q¤l¨¾µs¸Ë¸m¡F¨¾µs³øÄµ¾¹¡F±Ï¥Í°é¡F«H¸¹¯B¼Ð¡F±Ï¥Í¦ç¡F¨¾¼uI¤ß¡F¤u¤H¥ÎÅ@½¥¹Ô¡F®ø¨¾´à¡F¨¾¨Æ¬G¡B¨¾¿ç®g¡B¨¾¤õ¥Î¾c¡FºÏ©Ê½s½X¨¥÷ų§O¤âÀô¡C
[540] °Ó¼Ð :

[210] ½s¸¹ : N/242098
[220] ¥Ó½Ð¤é : 2025/06/30
[730] ¥Ó½Ð¤H : GE WILLIAM WEI
¦a§} : ¿Dªù¤W®üµó175¸¹¿Dªù¤¤µØÁ`°Ó·|¤j·H16¼ÓA
°êÄy : ¬ü°ê
¬¡°Ê : °Ó·~¤Î¤u·~
[511] Ãþ§O : 18
[511] ²£«~ : ¿ú¥]¡F¤â§ú¡F«B³Ê©Î¶§³Ê³Ê¬[¡F¾Ç¥Í¥Î®Ñ¥]¡F®Ñ¥]¡F¤p®Ñ¥]¡F®È¦æ¥Î¤j¦ç½c¡F¼u®¥Î¥Ö®M¡FI¥]¡F¿ú¥]¡F¤½¤å½c¡Fª¦¤s¥Î¤â´£³U¡F³¥Àç¤â´£³U¡F¤â´£¥]¡F®È¦æ¥]¡F¤½¤å¥]¡F®È¦æ¥Î¨ã¡]¥Ö¥ó¡^¡F®È¦æ¥]¡]½c¡^¡F¤â´£½c´£¤â¡FÃ즡ºô²´¿ú¥]¡F¥Î©ó¸Ë¤Æ§©¥Î«~ªº¤â´£¥]¡]ªÅªº¡^¡F¡]±×±¾¦bªÓ¤Wªº¡^¤l¼u±a¡F¦|¥¬I¥]¡F¹B°Ê¥]¡C
[540] °Ó¼Ð :

[210] ½s¸¹ : N/242099
[220] ¥Ó½Ð¤é : 2025/06/30
[730] ¥Ó½Ð¤H : GE WILLIAM WEI
¦a§} : ¿Dªù¤W®üµó175¸¹¿Dªù¤¤µØÁ`°Ó·|¤j·H16¼ÓA
°êÄy : ¬ü°ê
¬¡°Ê : °Ó·~¤Î¤u·~
[511] Ãþ§O : 35
[511] ªA°È : ±i¶K¼s§i¡F¤á¥~¼s§i¡F¼s§i¶Ç¼½¡F¼s§i«Å¶ÇÄæªº»s³Æ¡F³fª«®i¥X¡Fª½±µ¶l¥ó¼s§i¡F¼s§i§÷®Æ§ó·s¡F¼Ë«~´²µo¡F©ç½æ¡F¼s§i¡F¼s§i«Å¶Ç¡F¹qµø¼s§i¡F¹qµø°Ó·~¼s§i¡F¼s§i¥N²z¡F¬°¼s§i©Î±À¾P´£¨Ñ¼Ò¯S¡F¬°¥L¤H±À¾P¡F³q¹L¶lÁÊq³æ¶i¦æªº¼s§i«Å¶Ç¡Fpºâ¾÷ºôµ¸¤Wªº¦b½u¼s§i¡F¬°¹s°â¥Øªº¦b³q°T´CÅé¤W®i¥Ü°Ó«~¡F¬°®ø¶OªÌ´£¨Ñ°Ó·~«H®§©M«ØÄ³¡]®ø¶OªÌ«ØÄ³¾÷ºc¡^¡C
[540] °Ó¼Ð :

[210] ½s¸¹ : N/242101
[220] ¥Ó½Ð¤é : 2025/06/30
[730] ¥Ó½Ð¤H : GE WILLIAM WEI
¦a§} : ¿Dªù¤W®üµó175¸¹¿Dªù¤¤µØÁ`°Ó·|¤j·H16¼ÓA
°êÄy : ¬ü°ê
¬¡°Ê : °Ó·~¤Î¤u·~
[511] Ãþ§O : 5
[511] ²£«~ : Âå¥Î´îªÎ¯ù¡F¨¾·Àã¤âÅN¡F¨¾·Àã«üÀô¡F¨¾·Àã¯f°éÀô¡FÂå¥Î¯D¾¯¡F¯D¥ÎªvÀø¾¯¡FÂå¥Î»»I¡FÃÄ»s¿}ªG¡FÂå¥Î¤âÅN¡F°£¤f¯äÃĤù¡FÂåÃĥο}¼ß¡FÃÄ«~½¦Ån¡FÂåÃÄ»s¾¯¡FÂÈ»]´Î¡F·Î¦nªºÃÄ¡FÂå¥Î¼Å®Æ¡F½Ã¥Í®ø¬r¾¯¡FÃĥΧU®ø¤Æ¾¯¡FÂå¥ÎÃĪ«¡FÂå¥ÎÄq¬u¤ô¡F¥Ì»°s¡]ÃĪ«»s¾¯¡^¡FÃįù¡FÂå¥Îªo¯×¡FÃĪo¡FÂå¥ÎÃįó¡FÂå¥Î¤f»¿}¡FÂåÃĥοõ¾¯¡FÂå¥ÎÃÄ»I¡F¤ë¸g¹Ô¡F½Ã¥Í¹Ô¡F½Ã¥Í¤y¡FÂå¥ÎÃĤY¡FÅ@½§Ãľ¯¡FÃĥίóÃįù¡FÃĥν¦Ån¡FÃĥο}¡F®ê¾¯¡FÂå¥ÎÀç¾i¹«~¡F¨¾¤éÅÎÃÄ»I¡FÂå¥Î¨N¯DÆQ¡FÂå¥ÎÀç¾i¶¼«~¡F´îªÎ¥ÎÃľ¯¡F¤H¥ÎÃÄ¡FÃĪ«¶¼®Æ¡FÃĥλïÀ¡FÂå¥Î·ÏâÀ¯óÃÄ¡FÂå¥ÎÂÈ»]»s¾¯¡FÂå¥Î¤Z¤hªL¡FÂå¥ÎÀç¾i«~¡FÂå¥Îº¤¤f¾¯¡FÂå¥ÎÀç¾i²K¥[¾¯¡F³±¹D²M¬~²G¡FÂå¥ÎÀY¾v¼Wªø¾¯¡FÂå¥Î²´¸n¡C
[540] °Ó¼Ð :

[210] ½s¸¹ : N/242102
[220] ¥Ó½Ð¤é : 2025/06/30
[730] ¥Ó½Ð¤H : GE WILLIAM WEI
¦a§} : ¿Dªù¤W®üµó175¸¹¿Dªù¤¤µØÁ`°Ó·|¤j·H16¼ÓA
°êÄy : ¬ü°ê
¬¡°Ê : °Ó·~¤Î¤u·~
[511] Ãþ§O : 10
[511] ²£«~ : Âå¥Î¼ö®ðŸ®¶¾¹¡FÂå¥Î¹q¼ö¹Ô¡FÂå¥Î¹Ô¡F«õ¦Õ¤c¡FÂå¥Î«ü®M¡F¹qÀø¾¹±ñ¡F«ö¼¯¤â®M¡F¸¡³¡Å@¹Ô¡F¥¢¯v¥Î¶Ê¯vªEÀY¡FÂå¥Î¼QÃú¾¹¡F«ö¼¯¾¹±ñ¡FÂåÀø¾¹±ñ©M»ö¾¹¡F¼ÅÃĥξ¹¨ã¡FÂåÀø¾¹±ñ½c¡FÂå¥Î¯S»s³ÃÑ¡F¤õÅø¡F®¶°Ê«ö¼¯¾¹¡FÂå¥Î¼QÃú¾¹¡]«ö¶s¦¡¡^¡FÂå¥Î®ðªE¡FÂå¥Î®ð¹Ô¡FÂå¥Î®ð¿È¹Ô¡FÂå¥Î»]Âȳ]³Æ¡F²zÀø³]³Æ¡F°w¨b°w¡FÂå¥Î¶EÂ_³]³Æ¡C
[540] °Ó¼Ð :

[210] ½s¸¹ : N/242105
[220] ¥Ó½Ð¤é : 2025/06/30
[730] ¥Ó½Ð¤H : GE WILLIAM WEI
¦a§} : ¿Dªù¤W®üµó175¸¹¿Dªù¤¤µØÁ`°Ó·|¤j·H16¼ÓA
°êÄy : ¬ü°ê
¬¡°Ê : °Ó·~¤Î¤u·~
[511] Ãþ§O : 20
[511] ²£«~ : ¹Ô¿È¡]¨È³Â»s«~°£¥~¡^¡F³n¹Ô¡F¹Ô¤l¡]§É¹Ô¡^¡FªEÀY¡F«DÂå¥Î®ðªE¡F¯ó¹Ô¡F¹ÔªE¡F«DÂå¥Î®ð¹Ô¡F«DÂå¥Î®ð¹Ô¿È¡F¤ì¡BÄú¡B¥Û»I©Î¶ì®ÆÃÀ³N«~¡C
[540] °Ó¼Ð :

[210] ½s¸¹ : N/242108
[220] ¥Ó½Ð¤é : 2025/06/30
[730] ¥Ó½Ð¤H : GE WILLIAM WEI
¦a§} : ¿Dªù¤W®üµó175¸¹¿Dªù¤¤µØÁ`°Ó·|¤j·H16¼ÓA
°êÄy : ¬ü°ê
¬¡°Ê : °Ó·~¤Î¤u·~
[511] Ãþ§O : 35
[511] ªA°È : ±i¶K¼s§i¡F¤á¥~¼s§i¡F¼s§i¶Ç¼½¡F¼s§i«Å¶ÇÄæªº»s³Æ¡F³fª«®i¥X¡Fª½±µ¶l¥ó¼s§i¡F¼s§i§÷®Æ§ó·s¡F¼Ë«~´²µo¡F©ç½æ¡F¼s§i¡F¼s§i«Å¶Ç¡F¹qµø¼s§i¡F¹qµø°Ó·~¼s§i¡F¼s§i¥N²z¡F¬°¼s§i©Î±À¾P´£¨Ñ¼Ò¯S¡F¬°¥L¤H±À¾P¡F³q¹L¶lÁÊq³æ¶i¦æªº¼s§i«Å¶Ç¡Fpºâ¾÷ºôµ¸¤Wªº¦b½u¼s§i¡F¬°¹s°â¥Øªº¦b³q°T´CÅé¤W®i¥Ü°Ó«~¡F¬°®ø¶OªÌ´£¨Ñ°Ó·~«H®§©M«ØÄ³¡]®ø¶OªÌ«ØÄ³¾÷ºc¡^¡C
[540] °Ó¼Ð :

[210] ½s¸¹ : N/242109
[220] ¥Ó½Ð¤é : 2025/06/30
[730] ¥Ó½Ð¤H : GE WILLIAM WEI
¦a§} : ¿Dªù¤W®üµó175¸¹¿Dªù¤¤µØÁ`°Ó·|¤j·H16¼ÓA
°êÄy : ¬ü°ê
¬¡°Ê : °Ó·~¤Î¤u·~
[511] Ãþ§O : 44
[511] ªA°È : ÂåÀø¶E©Ò¡FÀø¾i°|¡FÂå°|¡F«O°·¡FÂåÀø»²§U¡F²zÀø¡FÂåÀøÅ@²z¡FÂåÃĿԸߡFª«½èÀݥίf¤Hªº±d´_¡F»·µ{Âå¾ÇªA°È¡C
[540] °Ó¼Ð :

[210] ½s¸¹ : N/242110
[220] ¥Ó½Ð¤é : 2025/06/30
[730] ¥Ó½Ð¤H : GE WILLIAM WEI
¦a§} : ¿Dªù¤W®üµó175¸¹¿Dªù¤¤µØÁ`°Ó·|¤j·H16¼ÓA
°êÄy : ¬ü°ê
¬¡°Ê : °Ó·~¤Î¤u·~
[511] Ãþ§O : 5
[511] ²£«~ : Âå¥Î´îªÎ¯ù¡F¨¾·Àã¤âÅN¡F¨¾·Àã«üÀô¡F¨¾·Àã¯f°éÀô¡FÂå¥Î¯D¾¯¡F¯D¥ÎªvÀø¾¯¡FÂå¥Î»»I¡FÃÄ»s¿}ªG¡FÂå¥Î¤âÅN¡F°£¤f¯äÃĤù¡FÂåÃĥο}¼ß¡FÃÄ«~½¦Ån¡FÂåÃÄ»s¾¯¡FÂÈ»]´Î¡F·Î¦nªºÃÄ¡FÂå¥Î¼Å®Æ¡F½Ã¥Í®ø¬r¾¯¡FÃĥΧU®ø¤Æ¾¯¡FÂå¥ÎÃĪ«¡FÂå¥ÎÄq¬u¤ô¡F¥Ì»°s¡]ÃĪ«»s¾¯¡^¡FÃįù¡FÂå¥Îªo¯×¡FÃĪo¡FÂå¥ÎÃįó¡FÂå¥Î¤f»¿}¡FÂåÃĥοõ¾¯¡FÂå¥ÎÃÄ»I¡F¤ë¸g¹Ô¡F½Ã¥Í¹Ô¡F½Ã¥Í¤y¡FÂå¥ÎÃĤY¡FÅ@½§Ãľ¯¡FÃĥίóÃįù¡FÃĥν¦Ån¡FÃĥο}¡F®ê¾¯¡FÂå¥ÎÀç¾i¹«~¡F¨¾¤éÅÎÃÄ»I¡FÂå¥Î¨N¯DÆQ¡FÂå¥ÎÀç¾i¶¼«~¡F´îªÎ¥ÎÃľ¯¡F¤H¥ÎÃÄ¡FÃĪ«¶¼®Æ¡FÃĥλïÀ¡FÂå¥Î·ÏâÀ¯óÃÄ¡FÂå¥ÎÂÈ»]»s¾¯¡FÂå¥Î¤Z¤hªL¡FÂå¥ÎÀç¾i«~¡FÂå¥Îº¤¤f¾¯¡FÂå¥ÎÀç¾i²K¥[¾¯¡F³±¹D²M¬~²G¡FÂå¥ÎÀY¾v¼Wªø¾¯¡FÂå¥Î²´¸n¡C
[540] °Ó¼Ð :

[210] ½s¸¹ : N/242111
[220] ¥Ó½Ð¤é : 2025/06/30
[730] ¥Ó½Ð¤H : GE WILLIAM WEI
¦a§} : ¿Dªù¤W®üµó175¸¹¿Dªù¤¤µØÁ`°Ó·|¤j·H16¼ÓA
°êÄy : ¬ü°ê
¬¡°Ê : °Ó·~¤Î¤u·~
[511] Ãþ§O : 14
[511] ²£«~ : ¶Àµ[¬Ä¦âÄ_¥Û¡F¤H³yµ[¬Ä»s¬Ã¯]¡]À£»sªºµ[¬Ä¡^¡FÅ@¨²Å¡]º¹¢¡^¡F»È¹¢«~¡F¤âÅN¡]º¹¢¡^¡F¤p¹¢ª«¡]º¹¢¡^¡F¯Ý°w¡]º¹¢¡^¡Fª÷è¥Û¡F¶Q«ª÷Äݵ·½u¡]¯]Ä_¡^¡F¶Â¦â¤j²z¥Û¹¢«~¡FÄ_¥Û¡F¬ö©À³¹¡]Ä_¥Û¡^¡F¥¼¥[¤u©Î¥b¥[¤u¶Q«ª÷ÄÝ¡F¿ö¡F¾ñÆV¥Û¡]Ä_¥Û¡^¡F¥¼¥[¤uªºª÷©Îª÷ºä¡Fª÷½u¡]¯]Ä_¡^¡FÜj¡F¸Ë¹¢«~¡]¯]Ä_¡^¡F¶Q«ª÷Äݹ¢°w¡F¬Ã¯]¡]¯]Ä_¡^¡FÄ_¥Û¡F¹`¡]ª÷ÄÝ¡^¡F¤H³y¯]Ä_¡F¶Q«ª÷ÄݦXª÷¡F§Ù«ü¡]º¹¢¡^¡F¶Q«ª÷ÄÝÃÀ³N«~¡F¶Q«ª÷Äݲ°¡F¦ÕÀô¡F¥¼¥[¤u¡B¥¼¥´³yªº»È¡F´º®õÂź¹¢¡Fº¹¢²°¡C
[540] °Ó¼Ð :

[210] ½s¸¹ : N/242112
[220] ¥Ó½Ð¤é : 2025/06/30
[730] ¥Ó½Ð¤H : GE WILLIAM WEI
¦a§} : ¿Dªù¤W®üµó175¸¹¿Dªù¤¤µØÁ`°Ó·|¤j·H16¼ÓA
°êÄy : ¬ü°ê
¬¡°Ê : °Ó·~¤Î¤u·~
[511] Ãþ§O : 18
[511] ²£«~ : ¿ú¥]¡F¤â§ú¡F«B³Ê©Î¶§³Ê³Ê¬[¡F¾Ç¥Í¥Î®Ñ¥]¡F®Ñ¥]¡F¤p®Ñ¥]¡F®È¦æ¥Î¤j¦ç½c¡F¼u®¥Î¥Ö®M¡FI¥]¡F¿ú¥]¡F¤½¤å½c¡Fª¦¤s¥Î¤â´£³U¡F³¥Àç¤â´£³U¡F¤â´£¥]¡F®È¦æ¥]¡F¤½¤å¥]¡F®È¦æ¥Î¨ã¡]¥Ö¥ó¡^¡F®È¦æ¥]¡]½c¡^¡F¤â´£½c´£¤â¡FÃ즡ºô²´¿ú¥]¡F¥Î©ó¸Ë¤Æ§©¥Î«~ªº¤â´£¥]¡]ªÅªº¡^¡F¡]±×±¾¦bªÓ¤Wªº¡^¤l¼u±a¡F¦|¥¬I¥]¡F¹B°Ê¥]¡C
[540] °Ó¼Ð :

[210] ½s¸¹ : N/242114
[220] ¥Ó½Ð¤é : 2025/06/30
[730] ¥Ó½Ð¤H : GE WILLIAM WEI
¦a§} : ¿Dªù¤W®üµó175¸¹¿Dªù¤¤µØÁ`°Ó·|¤j·H16¼ÓA
°êÄy : ¬ü°ê
¬¡°Ê : °Ó·~¤Î¤u·~
[511] Ãþ§O : 35
[511] ªA°È : ±i¶K¼s§i¡F¤á¥~¼s§i¡F¼s§i¶Ç¼½¡F¼s§i«Å¶ÇÄæªº»s³Æ¡F³fª«®i¥X¡Fª½±µ¶l¥ó¼s§i¡F¼s§i§÷®Æ§ó·s¡F¼Ë«~´²µo¡F©ç½æ¡F¼s§i¡F¼s§i«Å¶Ç¡F¹qµø¼s§i¡F¹qµø°Ó·~¼s§i¡F¼s§i¥N²z¡F¬°¼s§i©Î±À¾P´£¨Ñ¼Ò¯S¡F¬°¥L¤H±À¾P¡F³q¹L¶lÁÊq³æ¶i¦æªº¼s§i«Å¶Ç¡Fpºâ¾÷ºôµ¸¤Wªº¦b½u¼s§i¡F¬°¹s°â¥Øªº¦b³q°T´CÅé¤W®i¥Ü°Ó«~¡F¬°®ø¶OªÌ´£¨Ñ°Ó·~«H®§©M«ØÄ³¡]®ø¶OªÌ«ØÄ³¾÷ºc¡^¡C
[540] °Ó¼Ð :

[210] ½s¸¹ : N/242119
[220] ¥Ó½Ð¤é : 2025/06/30
[730] ¥Ó½Ð¤H : ¶ÀºÑªâ
¦a§} : ¿Dªù¸ôÀôª÷®p¦Wű©|¬Ä23F B«Ç
°êÄy : ¤¤°ê
¬¡°Ê : °Ó·~
[511] Ãþ§O : 9
[511] ²£«~ : µÅT³]³Æ¡AµøÅ¥³]³Æ¡Apºâ¾÷³n¥ó¶}µo¤u¨ã¡C
[540] °Ó¼Ð :

[210] ½s¸¹ : N/242120
[220] ¥Ó½Ð¤é : 2025/06/30
[730] ¥Ó½Ð¤H : ¶ÀºÑªâ
¦a§} : ¿Dªù¸ôÀôª÷®p¦Wű©|¬Ä23F B«Ç
°êÄy : ¤¤°ê
¬¡°Ê : °Ó·~
[511] Ãþ§O : 9
[511] ²£«~ : µÅT³]³Æ¡AµøÅ¥³]³Æ¡Apºâ¾÷³n¥ó¶}µo¤u¨ã¡C
[540] °Ó¼Ð :

[210] ½s¸¹ : N/242121
[220] ¥Ó½Ð¤é : 2025/06/30
[730] ¥Ó½Ð¤H : ¶ÀºÑªâ
¦a§} : ¿Dªù¸ôÀôª÷®p¦Wű©|¬Ä23F B«Ç
°êÄy : ¤¤°ê
¬¡°Ê : °Ó·~
[511] Ãþ§O : 9
[511] ²£«~ : µÅT³]³Æ¡AµøÅ¥³]³Æ¡Apºâ¾÷³n¥ó¶}µo¤u¨ã¡C
[540] °Ó¼Ð :

[210] ½s¸¹ : N/242128
[220] ¥Ó½Ð¤é : 2025/06/30
[730] ¥Ó½Ð¤H : ÉܱÓÄR
¦a§} : ¿Dªù³Ò°Ê¸`¤j°¨¸ô±s´ºÆW¤T®y29/E
°êÄy : ¤¤°ê
¬¡°Ê : °Ó·~
[511] Ãþ§O : 5
[511] ²£«~ : ¤¤¦è¦¨ÃÄ¡AÃĪo¡A·g¾¯¡Aªo¾¯¡]·Àãªo¡B¶Ë·ªo¡B²M²Dªo¡^¡AÃÄ»I¡A¶K¾¯¡AªvÀø¿N¶Ë»s¾¯¡AªvÀø§÷®Æ¡F½Ã¥Í¥Î«~¡FÂå¥ÎÀç¾i«~¡F¶Ç²Î¤¤ÂåÃIJ£«~¡FÂåÃÄ´ö¾¯¡A´î»´¶^¥´¤Î¦Ù¦×Ãö¸`¯kµh¥Îªº¤îµh¾¯¤ÎÃĪo¡B³n»I¡C
[540] °Ó¼Ð :

[210] ½s¸¹ : N/242129
[220] ¥Ó½Ð¤é : 2025/06/30
[730] ¥Ó½Ð¤H : ÉܱÓÄR
¦a§} : ¿Dªù³Ò°Ê¸`¤j°¨¸ô±s´ºÆW¤T®y29/E
°êÄy : ¤¤°ê
¬¡°Ê : °Ó·~
[511] Ãþ§O : 30
[511] ²£«~ : «DÃĥΫO°·¹«~¡A«DÂå¥ÎÀç¾i¤fªA²G¡A«DÂå¥ÎÀç¾i«~¡A«DÂå¥ÎÀç¾i²G¡A«DÂå¥ÎÀç¾i¤ù¡A«DÂå¥ÎÀç¾i¯»¡A«DÂå¥ÎÀç¾i½¦Ån¡A«DÂå¥ÎÀç¾iºë¡C
[540] °Ó¼Ð :

[210] ½s¸¹ : N/242130
[220] ¥Ó½Ð¤é : 2025/06/30
[730] ¥Ó½Ð¤H : °Ï§Ó³Ç
¦a§} : ¿Dªù´£·þ°¨¸ô31¸¹¸U§Q¤u·~¤j·H5/B
°êÄy : ¤¤°ê
¬¡°Ê : °Ó·~
[511] Ãþ§O : 29
[511] ²£«~ : ¥¤¯»¡C
[540] °Ó¼Ð :

[591] °Ó¼ÐÃC¦â : ÂŦâ¡B¥Õ¦â¡B¶À¦â¡Bºñ¦â¡A¦p¹Ï©Ò¥Ü¡C
[210] ½s¸¹ : N/242131
[220] ¥Ó½Ð¤é : 2025/06/30
[730] ¥Ó½Ð¤H : °Ï§Ó³Ç
¦a§} : ¿Dªù´£·þ°¨¸ô31¸¹5/B
°êÄy : ¤¤°ê
¬¡°Ê : °Ó·~
[511] Ãþ§O : 30
[511] ²£«~ : «DÂå¥Î«O°·«~¡A«DÂå¥ÎÀç¾i¸É¥R¾¯¡A«DÂå¥Î»Ã¥À¿¯¹¸É¥R¾¯¡C
[540] °Ó¼Ð :

[591] °Ó¼ÐÃC¦â : ÂŦâ¡B¥Õ¦â¡B¶À¦â¡Bºñ¦â¡A¦p¹Ï©Ò¥Ü¡C
[210] ½s¸¹ : N/242136
[220] ¥Ó½Ð¤é : 2025/06/30
[730] ¥Ó½Ð¤H : ¤¤¤s¥«±d¨q·½¥Íª«¬ì§Þ¦³¤½¥q
¦a§} : ¤¤°ê¼sªF¬Ù¤¤¤s¥«ªF°Ï¼s¯]¤½¸ô69¸¹¬P¥ú§´J1¼l2603©Ð¤§¤@
°êÄy : ¤¤°ê
¬¡°Ê : °Ó·~
[511] Ãþ§O : 32
[511] ²£«~ : »s°à°s¥Î³D³Â¤l¥Ä¡F³ÁªÞ¥Ä¡]µo»Ã«á¦¨°à°s¡^¡FµL°sºëªº¶}G°s¡FµL°sºëÂû§À°s¡F°à°s¡FÁ¤¥Ä°à°s¡F³ÁªÞ°à°s¡F¥H°à°s¬°¥DªºÂû§À°s¡F¤j³Á°à°s¡F»s°à°s¥Î³ÁªÞ¥Ä¡C
[540] °Ó¼Ð :

[210] ½s¸¹ : N/242137
[220] ¥Ó½Ð¤é : 2025/06/30
[730] ¥Ó½Ð¤H : °êÃͰ¹Î¶¾¤F©Ê¡]¦ò¤s¡^ÃÄ·~¦³¤½¥q
¦a§} : ¼sªF¬Ù¦ò¤s¥«ÁI«°°Ï¦òù¤½¸ô35¸¹¤§¤@
°êÄy : ¤¤°ê
¬¡°Ê : °Ó·~¤Î¤u·~
[511] Ãþ§O : 5
[511] ²£«~ : ¤H¥ÎÃÄ¡FÂå¥ÎÃÄ»I¡F¤ù¾¯¡Fª¾¯¡F»I¾¯¡F¤¤ÃĦ¨ÃÄ¡FÃİs¡F¤¤Ãħ÷¡F·Î¦nªºÃÄ¡FÂå¥ÎÀç¾i¶¼®Æ¡C
[540] °Ó¼Ð :

[210] ½s¸¹ : N/242141
[220] ¥Ó½Ð¤é : 2025/06/30
[730] ¥Ó½Ð¤H : ¼s¦{±y¨Nº³§ë¸ê±±ªÑ¦³¤½¥q
¦a§} : ¤¤°ê¼sªF¬Ù¼s¦{¥«¥Õ¶³°Ï¦y´^¸ô395¸¹1622«Ç
°êÄy : ¤¤°ê
¬¡°Ê : °Ó·~¤Î¤u·~
[511] Ãþ§O : 3
[511] ²£«~ : ¼í¾v¨Å¡F¬~¾v²G¡FÅ@¾v¯À¡F²M¼ä»s¾¯¡FªÚ»¾¯¡]»ºëªo¡^¡F¬V¾v¾¯¡F¿S¾v¾¯¡F¤Æ§©«~¡F¼Q¾v½¦¡FªÅ®ðªÚ»¾¯¡F«cލm¡F¼ä½§¨Å²G¡F»ºëªo¡F«cŽ«á¥Î²G¡F¨àµ£¥Î¤Æ§©«~¡F¬~¾þ¥Î¤Æ§©«~¡F«DÂå¥Î¨N¯DÅS¡F°Êª«¥Î¨N¯DÅS¡]¤£§tÃĪ«ªº²M¼ä»s¾¯¡^¡F°²¾vÂH¶K¾¯¡F¤Æ§©¥Î½¦ì³J¥Õ»s¾¯¡F¾v½¤¡C
[540] °Ó¼Ð :

[210] ½s¸¹ : N/242142
[220] ¥Ó½Ð¤é : 2025/06/30
[730] ¥Ó½Ð¤H : ¼s¦{±y¨Nº³§ë¸ê±±ªÑ¦³¤½¥q
¦a§} : ¤¤°ê¼sªF¬Ù¼s¦{¥«¥Õ¶³°Ï¦y´^¸ô395¸¹1622«Ç
°êÄy : ¤¤°ê
¬¡°Ê : °Ó·~¤Î¤u·~
[511] Ãþ§O : 3
[511] ²£«~ : ¼í¾v¨Å¡F¬~¾v²G¡FÅ@¾v¯À¡F²M¼ä»s¾¯¡FªÚ»¾¯¡]»ºëªo¡^¡F¬V¾v¾¯¡F¿S¾v¾¯¡F¤Æ§©«~¡F¼Q¾v½¦¡FªÅ®ðªÚ»¾¯¡F«cލm¡F¼ä½§¨Å²G¡F»ºëªo¡F«cŽ«á¥Î²G¡F¨àµ£¥Î¤Æ§©«~¡F¬~¾þ¥Î¤Æ§©«~¡F«DÂå¥Î¨N¯DÅS¡F°Êª«¥Î¨N¯DÅS¡]¤£§tÃĪ«ªº²M¼ä»s¾¯¡^¡F°²¾vÂH¶K¾¯¡F¤Æ§©¥Î½¦ì³J¥Õ»s¾¯¡F¾v½¤¡C
[540] °Ó¼Ð :

[210] ½s¸¹ : N/242143
[220] ¥Ó½Ð¤é : 2025/06/30
[730] ¥Ó½Ð¤H : ¼s¦{±y¨Nº³§ë¸ê±±ªÑ¦³¤½¥q
¦a§} : ¤¤°ê¼sªF¬Ù¼s¦{¥«¥Õ¶³°Ï¦y´^¸ô395¸¹1622«Ç
°êÄy : ¤¤°ê
¬¡°Ê : °Ó·~¤Î¤u·~
[511] Ãþ§O : 3
[511] ²£«~ : ¼í¾v¨Å¡F¬~¾v²G¡FÅ@¾v¯À¡F²M¼ä»s¾¯¡FªÚ»¾¯¡]»ºëªo¡^¡F¬V¾v¾¯¡F¿S¾v¾¯¡F¤Æ§©«~¡F¼Q¾v½¦¡FªÅ®ðªÚ»¾¯¡F«cލm¡F¼ä½§¨Å²G¡F»ºëªo¡F«cŽ«á¥Î²G¡F¨àµ£¥Î¤Æ§©«~¡F¬~¾þ¥Î¤Æ§©«~¡F«DÂå¥Î¨N¯DÅS¡F°Êª«¥Î¨N¯DÅS¡]¤£§tÃĪ«ªº²M¼ä»s¾¯¡^¡F°²¾vÂH¶K¾¯¡F¤Æ§©¥Î½¦ì³J¥Õ»s¾¯¡F¾v½¤¡C
[540] °Ó¼Ð :

[210] ½s¸¹ : N/242144
[220] ¥Ó½Ð¤é : 2025/06/30
[730] ¥Ó½Ð¤H : ¯]®üµØµo²{¥N¹A·~¬ì§Þ§ë¸ê±±ªÑ¦³¤½¥q
¦a§} : ¤¤°ê¼sªF¬Ù¯]®ü¥«¾îµ^·s°ÏµØª÷µó58¸¹34¼h3404-3
°êÄy : ¤¤°ê
¬¡°Ê : °Ó·~¤Î¤u·~
[511] Ãþ§O : 31
[511] ²£«~ : ¥É¦Ì¡F´Óª«¡F»¶´Ô¡]´Óª«¡^¡F¬¡°Êª«¡F·sÂA¤ôªG¡F·sÂA¬U¤l´Ô¡F·sÂA½µæ¡F·sÂA»¶´Ô¡F´Óª«ºØ¤l¡F¹}®Æ¡C
[540] °Ó¼Ð :

[210] ½s¸¹ : N/242145
[220] ¥Ó½Ð¤é : 2025/06/30
[730] ¥Ó½Ð¤H : ¯]®üµØµo²{¥N¹A·~¬ì§Þ§ë¸ê±±ªÑ¦³¤½¥q
¦a§} : ¤¤°ê¼sªF¬Ù¯]®ü¥«¾îµ^·s°ÏµØª÷µó58¸¹34¼h3404-3
°êÄy : ¤¤°ê
¬¡°Ê : °Ó·~¤Î¤u·~
[511] Ãþ§O : 31
[511] ²£«~ : ¥É¦Ì¡F´Óª«¡F»¶´Ô¡]´Óª«¡^¡F¬¡°Êª«¡F·sÂA¤ôªG¡F·sÂA¬U¤l´Ô¡F·sÂA½µæ¡F·sÂA»¶´Ô¡F´Óª«ºØ¤l¡F¹}®Æ¡C
[540] °Ó¼Ð :

[210] ½s¸¹ : N/242146
[220] ¥Ó½Ð¤é : 2025/06/30
[730] ¥Ó½Ð¤H : ¯]®üµØµo²{¥N¹A·~¬ì§Þ§ë¸ê±±ªÑ¦³¤½¥q
¦a§} : ¤¤°ê¼sªF¬Ù¯]®ü¥«¾îµ^·s°ÏµØª÷µó58¸¹34¼h3404-3
°êÄy : ¤¤°ê
¬¡°Ê : °Ó·~¤Î¤u·~
[511] Ãþ§O : 31
[511] ²£«~ : ¥É¦Ì¡F´Óª«¡F»¶´Ô¡]´Óª«¡^¡F¬¡°Êª«¡F·sÂA¤ôªG¡F·sÂA¬U¤l´Ô¡F·sÂA½µæ¡F·sÂA»¶´Ô¡F´Óª«ºØ¤l¡F¹}®Æ¡C
[540] °Ó¼Ð :

[210] ½s¸¹ : N/242147
[220] ¥Ó½Ð¤é : 2025/06/30
[730] ¥Ó½Ð¤H : ¯]®üµØµo²{¥N¹A·~¬ì§Þ§ë¸ê±±ªÑ¦³¤½¥q
¦a§} : ¤¤°ê¼sªF¬Ù¯]®ü¥«¾îµ^·s°ÏµØª÷µó58¸¹34¼h3404-3
°êÄy : ¤¤°ê
¬¡°Ê : °Ó·~¤Î¤u·~
[511] Ãþ§O : 31
[511] ²£«~ : ¥É¦Ì¡F´Óª«¡F»¶´Ô¡]´Óª«¡^¡F¬¡°Êª«¡F·sÂA¤ôªG¡F·sÂA¬U¤l´Ô¡F·sÂA½µæ¡F·sÂA»¶´Ô¡F´Óª«ºØ¤l¡F¹}®Æ¡C
[540] °Ó¼Ð :

[210] ½s¸¹ : N/242148
[220] ¥Ó½Ð¤é : 2025/06/30
[730] ¥Ó½Ð¤H : ¯]®üµØµo²{¥N¹A·~¬ì§Þ§ë¸ê±±ªÑ¦³¤½¥q
¦a§} : ¤¤°ê¼sªF¬Ù¯]®ü¥«¾îµ^·s°ÏµØª÷µó58¸¹34¼h3404-3
°êÄy : ¤¤°ê
¬¡°Ê : °Ó·~¤Î¤u·~
[511] Ãþ§O : 31
[511] ²£«~ : ¥É¦Ì¡F´Óª«¡F»¶´Ô¡]´Óª«¡^¡F¬¡°Êª«¡F·sÂA¤ôªG¡F·sÂA¬U¤l´Ô¡F·sÂA½µæ¡F·sÂA»¶´Ô¡F´Óª«ºØ¤l¡F¹}®Æ¡C
[540] °Ó¼Ð :

[210] ½s¸¹ : N/242149
[220] ¥Ó½Ð¤é : 2025/06/30
[730] ¥Ó½Ð¤H : ¯]®üµØµo²{¥N¹A·~¬ì§Þ§ë¸ê±±ªÑ¦³¤½¥q
¦a§} : ¤¤°ê¼sªF¬Ù¯]®ü¥«¾îµ^·s°ÏµØª÷µó58¸¹34¼h3404-3
°êÄy : ¤¤°ê
¬¡°Ê : °Ó·~¤Î¤u·~
[511] Ãþ§O : 31
[511] ²£«~ : ¥É¦Ì¡F´Óª«¡F»¶´Ô¡]´Óª«¡^¡F¬¡°Êª«¡F·sÂA¤ôªG¡F·sÂA¬U¤l´Ô¡F·sÂA½µæ¡F·sÂA»¶´Ô¡F´Óª«ºØ¤l¡F¹}®Æ¡C
[540] °Ó¼Ð :

[210] ½s¸¹ : N/242150
[220] ¥Ó½Ð¤é : 2025/06/30
[730] ¥Ó½Ð¤H : ¤Ó·¥¶°¹Î«¼y²e³®»sÃļt¦³¤½¥q
¦a§} : ¤¤°ê«¼y¥«²e³®°Ï¤Ó·¥¤j¹D1¸¹
°êÄy : ¤¤°ê
¬¡°Ê : °Ó·~¤Î¤u·~
[511] Ãþ§O : 33
[511] ²£«~ : W¨ý°s¡F¶}G°s¡F»]ÃH¶¼®Æ¡F¯P°s¡]¶¼®Æ¡^¡F°sºë¶¼®Æ¡]°à°s°£¥~¡^¡F§t¤ôªG°sºë¶¼®Æ¡F¹w¥ý²V¦Xªº°sºë¶¼®Æ¡]¥H°à°s¬°¥Dªº°£¥~¡^¡F½\ª«»s»]ÃH°sºë¶¼®Æ¡F¨T°s¡F¶À°s¡F¹¥Î°sºë¡F¥Õ°s¡F§Q¤f°s¡F¿N°s¡F¦Ì°s¡C
[540] °Ó¼Ð :

[210] ½s¸¹ : N/242151
[220] ¥Ó½Ð¤é : 2025/06/30
[730] ¥Ó½Ð¤H : ¤Ó·¥¶°¹Î«¼y²e³®»sÃļt¦³¤½¥q
¦a§} : ¤¤°ê«¼y¥«²e³®°Ï¤Ó·¥¤j¹D1¸¹
°êÄy : ¤¤°ê
¬¡°Ê : °Ó·~¤Î¤u·~
[511] Ãþ§O : 35
[511] ªA°È : ¬°°Ó«~©MªA°Èªº¶R½æÂù¤è´£¨Ñ¦b½u¥«³õ¡F¶i¥X¤f¥N²z¡F´À¥L¤H±À¾P¡F´À¥L¤H±ÄÁÊ¡]´À¨ä¥L¥ø·~ÁʶR°Ó«~©ÎªA°È¡^¡F¥«³õÀç¾P¡F¼s§i¡F¼s§i«Å¶Ç¡F¬°¹s°â¥Øªº¦b³q°T´CÅé¤W®i¥Ü°Ó«~¡F³q¹Lºô¯¸´£¨Ñ°Ó·~«H®§¡Fpºâ¾÷ºôµ¸¤Wªº¦b½u¼s§i¡F¬°®ø¶OªÌ´£¨Ñ°Ó«~©MªA°È¿ï¾Ü¤è±ªº°Ó·~«H®§©M«ØÄ³¡F°Ó·~ºÞ²z©M²Õ´¿Ô¸ß¡F´£¨Ñ°Ó·~©M°Ó°ÈÁpô«H®§¡FÃĥΡBÃ~Âå¥Î¡B½Ã¥Í¥Î»s¾¯©MÂåÀø¥Î«~ªº¹s°âªA°È¡FÃĥΡBÃ~Âå¥Î¡B½Ã¥Í¥Î»s¾¯©MÂåÀø¥Î«~ªº§åµoªA°È¡FÃÄ«~¹s°â©Î§åµoªA°È¡FÃĥλs¾¯¹s°â©Î§åµoªA°È¡F½Ã¥Í»s¾¯¹s°â©Î§åµoªA°È¡FÂåÀø¥Î«~¹s°â©Î§åµoªA°È¡FÃ~ÃĹs°â©Î§åµoªA°È¡FÃ~Âå¥Î»s¾¯¹s°â©Î§åµoªA°È¡C
[540] °Ó¼Ð :

[210] ½s¸¹ : N/242152
[220] ¥Ó½Ð¤é : 2025/06/30
[730] ¥Ó½Ð¤H : ¤Ó·¥¶°¹Î«¼y²e³®»sÃļt¦³¤½¥q
¦a§} : ¤¤°ê«¼y¥«²e³®°Ï¤Ó·¥¤j¹D1¸¹
°êÄy : ¤¤°ê
¬¡°Ê : °Ó·~¤Î¤u·~
[511] Ãþ§O : 33
[511] ²£«~ : W¨ý°s¡F¶}G°s¡F»]ÃH¶¼®Æ¡F¯P°s¡]¶¼®Æ¡^¡F°sºë¶¼®Æ¡]°à°s°£¥~¡^¡F§t¤ôªG°sºë¶¼®Æ¡F¹w¥ý²V¦Xªº°sºë¶¼®Æ¡]¥H°à°s¬°¥Dªº°£¥~¡^¡F½\ª«»s»]ÃH°sºë¶¼®Æ¡F¨T°s¡F¶À°s¡F¹¥Î°sºë¡F¥Õ°s¡F§Q¤f°s¡F¿N°s¡F¦Ì°s¡C
[540] °Ó¼Ð :

®Ú¾Ú¸g¤Q¤G¤ë¤Q¤T¤é²Ä97/99/M¸¹ªk¥O®Ö㤧¡m¤u·~²£Åvªk«ß¨î«×¡n²Ä¤Q±ø²Ä¤@´Ú¤Î²Ä¤G´Úªº³W©w¡A¤½§G¤U¦C¦b¿Dªù¯S§O¦æ¬F°Ï´£¥Xªº°Ó¼Ðµù¥U¥Ó½Ð¤§§å¥Ü¡A¨Ã«ö·Ó¦P¤@ªk³W²Ä¤G¦Ê¤C¤Q¤±ø¦Ü²Ä¤G¦Ê¤C¤Q¤C±øªº³W©w¡A¥i©ó¥»¤½§G¤é°_¤@Ó¤ë´Á¤º´N¤U¦C§å¥Ü¦Vªì¯Åªk°|´£°_¤W¶D¡C
§åµ¹
| ½s¸¹ | µù¥U¤é´Á | §å¥Ü¤é´Á | Åv§Q¤H | Ãþ§O |
| N/224722 | 2025/07/24 | 2025/07/24 | UPJOHN MANUFACTURING IRELAND UNLIMITED COMPANY | 05 |
| N/226765 | 2025/07/24 | 2025/07/24 | ²`¦`¤Þ±æ´¼¯à§Þ³N¦³¤½¥q | 09 |
| N/226768 | 2025/07/24 | 2025/07/24 | ²`¦`¤Þ±æ´¼¯à§Þ³N¦³¤½¥q | 42 |
| N/226773 | 2025/07/24 | 2025/07/24 | Malaysia Dairy Industries Pte Ltd | 29 |
| N/226774 | 2025/07/24 | 2025/07/24 | Malaysia Dairy Industries Pte Ltd | 29 |
| N/230181 | 2025/07/24 | 2025/07/24 | ¿Dªù°ê»Úª÷Æ_°Í¨ó·| | 41 |
| N/230182 | 2025/07/24 | 2025/07/24 | ¿Dªù°ê»Úª÷Æ_°Í¨ó·| | 41 |
| N/230329 | 2025/07/24 | 2025/07/24 | LIFEREGEN INC. | 05 |
| N/231653 | 2025/07/24 | 2025/07/24 | Peak Reinsurance Company Limited | 09 |
| N/231654 | 2025/07/24 | 2025/07/24 | Peak Reinsurance Company Limited | 42 |
| N/232491 | 2025/07/24 | 2025/07/24 | ¿Dªù¯ó¥»ª÷¤è°·±d¬ì§Þ¦³¤½¥q | 03 |
| N/232492 | 2025/07/24 | 2025/07/24 | ¿Dªù¯ó¥»ª÷¤è°·±d¬ì§Þ¦³¤½¥q | 05 |
| N/232493 | 2025/07/24 | 2025/07/24 | ¿Dªù¯ó¥»ª÷¤è°·±d¬ì§Þ¦³¤½¥q | 03 |
| N/232494 | 2025/07/24 | 2025/07/24 | ¿Dªù¯ó¥»ª÷¤è°·±d¬ì§Þ¦³¤½¥q | 05 |
| N/232662 | 2025/07/24 | 2025/07/24 | ¿D®Tºî¦X«×°²ªÑ¥÷¦³¤½¥q SJM RESORTS, S.A., em inglês SJM RESORTS, LIMITED |
43 |
| N/232919 | 2025/07/24 | 2025/07/24 | Peak Reinsurance Company Limited | 36 |
| N/233283 | 2025/07/24 | 2025/07/24 | PUTNAM U.S. HOLDINGS I, LLC | 36 |
| N/233284 | 2025/07/24 | 2025/07/24 | PUTNAM U.S. HOLDINGS I, LLC | 36 |
| N/233322 | 2025/07/24 | 2025/07/24 | OLR Holdings Ltd | 25 |
| N/233947 | 2025/07/24 | 2025/07/24 | TAT HONG HOLDINGS LTD | 37 |
| N/233948 | 2025/07/24 | 2025/07/24 | TAT HONG HOLDINGS LTD | 39 |
| N/234452 | 2025/07/24 | 2025/07/24 | ¿Dªù¯ó¥»ª÷¤è°·±d¬ì§Þ¦³¤½¥q | 35 |
| N/234454 | 2025/07/24 | 2025/07/24 | ¿Dªù¯ó¥»ª÷¤è°·±d¬ì§Þ¦³¤½¥q | 35 |
| N/234455 | 2025/07/24 | 2025/07/24 | ¿Dªù¯ó¥»ª÷¤è°·±d¬ì§Þ¦³¤½¥q | 03 |
| N/234456 | 2025/07/24 | 2025/07/24 | ¿Dªù¯ó¥»ª÷¤è°·±d¬ì§Þ¦³¤½¥q | 03 |
| N/234457 | 2025/07/24 | 2025/07/24 | ¿Dªù¯ó¥»ª÷¤è°·±d¬ì§Þ¦³¤½¥q | 05 |
| N/234459 | 2025/07/24 | 2025/07/24 | ¿Dªù¯ó¥»ª÷¤è°·±d¬ì§Þ¦³¤½¥q | 35 |
| N/234816 | 2025/07/24 | 2025/07/24 | Umit Benan S.r.l. | 14 |
| N/234817 | 2025/07/24 | 2025/07/24 | Umit Benan S.r.l. | 18 |
| N/234819 | 2025/07/24 | 2025/07/24 | Umit Benan S.r.l. | 35 |
| N/234886 | 2025/07/24 | 2025/07/24 | Zespri Group Limited | 28 |
| N/234887 | 2025/07/24 | 2025/07/24 | Zespri Group Limited | 31 |
| N/234949 | 2025/07/24 | 2025/07/24 | ¿D®Tºî¦X«×°²ªÑ¥÷¦³¤½¥q SJM RESORTS, S.A., em inglês SJM RESORTS, LIMITED |
39 |
| N/234950 | 2025/07/24 | 2025/07/24 | ¿D®Tºî¦X«×°²ªÑ¥÷¦³¤½¥q SJM RESORTS, S.A., em inglês SJM RESORTS, LIMITED |
41 |
| N/234951 | 2025/07/24 | 2025/07/24 | ¿D®Tºî¦X«×°²ªÑ¥÷¦³¤½¥q SJM RESORTS, S.A., em inglês SJM RESORTS, LIMITED |
43 |
| N/234952 | 2025/07/24 | 2025/07/24 | ¿D®Tºî¦X«×°²ªÑ¥÷¦³¤½¥q SJM RESORTS, S.A., em inglês SJM RESORTS, LIMITED |
44 |
| N/234953 | 2025/07/24 | 2025/07/24 | ¿D®Tºî¦X«×°²ªÑ¥÷¦³¤½¥q SJM RESORTS, S.A., em inglês SJM RESORTS, LIMITED |
39 |
| N/234954 | 2025/07/24 | 2025/07/24 | ¿D®Tºî¦X«×°²ªÑ¥÷¦³¤½¥q SJM RESORTS, S.A., em inglês SJM RESORTS, LIMITED |
41 |
| N/234955 | 2025/07/24 | 2025/07/24 | ¿D®Tºî¦X«×°²ªÑ¥÷¦³¤½¥q SJM RESORTS, S.A., em inglês SJM RESORTS, LIMITED |
43 |
| N/234956 | 2025/07/24 | 2025/07/24 | ¿D®Tºî¦X«×°²ªÑ¥÷¦³¤½¥q SJM RESORTS, S.A., em inglês SJM RESORTS, LIMITED |
44 |
| N/234957 | 2025/07/24 | 2025/07/24 | ¿D®Tºî¦X«×°²ªÑ¥÷¦³¤½¥q SJM RESORTS, S.A., em inglês SJM RESORTS, LIMITED |
39 |
| N/234958 | 2025/07/24 | 2025/07/24 | ¿D®Tºî¦X«×°²ªÑ¥÷¦³¤½¥q SJM RESORTS, S.A., em inglês SJM RESORTS, LIMITED |
41 |
| N/234959 | 2025/07/24 | 2025/07/24 | ¿D®Tºî¦X«×°²ªÑ¥÷¦³¤½¥q SJM RESORTS, S.A., em inglês SJM RESORTS, LIMITED |
43 |
| N/234960 | 2025/07/24 | 2025/07/24 | ¿D®Tºî¦X«×°²ªÑ¥÷¦³¤½¥q SJM RESORTS, S.A., em inglês SJM RESORTS, LIMITED |
44 |
| N/234961 | 2025/07/24 | 2025/07/24 | ¿D®Tºî¦X«×°²ªÑ¥÷¦³¤½¥q SJM RESORTS, S.A., em inglês SJM RESORTS, LIMITED |
39 |
| N/234962 | 2025/07/24 | 2025/07/24 | ¿D®Tºî¦X«×°²ªÑ¥÷¦³¤½¥q SJM RESORTS, S.A., em inglês SJM RESORTS, LIMITED |
41 |
| N/234963 | 2025/07/24 | 2025/07/24 | ¿D®Tºî¦X«×°²ªÑ¥÷¦³¤½¥q SJM RESORTS, S.A., em inglês SJM RESORTS, LIMITED |
43 |
| N/234964 | 2025/07/24 | 2025/07/24 | ¿D®Tºî¦X«×°²ªÑ¥÷¦³¤½¥q SJM RESORTS, S.A., em inglês SJM RESORTS, LIMITED |
44 |
| N/234965 | 2025/07/24 | 2025/07/24 | ¿D®Tºî¦X«×°²ªÑ¥÷¦³¤½¥q SJM RESORTS, S.A., em inglês SJM RESORTS, LIMITED |
39 |
| N/234966 | 2025/07/24 | 2025/07/24 | ¿D®Tºî¦X«×°²ªÑ¥÷¦³¤½¥q SJM RESORTS, S.A., em inglês SJM RESORTS, LIMITED |
41 |
| N/234967 | 2025/07/24 | 2025/07/24 | ¿D®Tºî¦X«×°²ªÑ¥÷¦³¤½¥q SJM RESORTS, S.A., em inglês SJM RESORTS, LIMITED |
43 |
| N/234968 | 2025/07/24 | 2025/07/24 | ¿D®Tºî¦X«×°²ªÑ¥÷¦³¤½¥q SJM RESORTS, S.A., em inglês SJM RESORTS, LIMITED |
44 |
| N/234969 | 2025/07/24 | 2025/07/24 | ¿D®Tºî¦X«×°²ªÑ¥÷¦³¤½¥q SJM RESORTS, S.A., em inglês SJM RESORTS, LIMITED |
39 |
| N/234970 | 2025/07/24 | 2025/07/24 | ¿D®Tºî¦X«×°²ªÑ¥÷¦³¤½¥q SJM RESORTS, S.A., em inglês SJM RESORTS, LIMITED |
41 |
| N/234971 | 2025/07/24 | 2025/07/24 | ¿D®Tºî¦X«×°²ªÑ¥÷¦³¤½¥q SJM RESORTS, S.A., em inglês SJM RESORTS, LIMITED |
43 |
| N/234972 | 2025/07/24 | 2025/07/24 | ¿D®Tºî¦X«×°²ªÑ¥÷¦³¤½¥q SJM RESORTS, S.A., em inglês SJM RESORTS, LIMITED |
44 |
| N/234973 | 2025/07/24 | 2025/07/24 | ¿D®Tºî¦X«×°²ªÑ¥÷¦³¤½¥q SJM RESORTS, S.A., em inglês SJM RESORTS, LIMITED |
39 |
| N/234974 | 2025/07/24 | 2025/07/24 | ¿D®Tºî¦X«×°²ªÑ¥÷¦³¤½¥q SJM RESORTS, S.A., em inglês SJM RESORTS, LIMITED |
41 |
| N/234975 | 2025/07/24 | 2025/07/24 | ¿D®Tºî¦X«×°²ªÑ¥÷¦³¤½¥q SJM RESORTS, S.A., em inglês SJM RESORTS, LIMITED |
43 |
| N/234976 | 2025/07/24 | 2025/07/24 | ¿D®Tºî¦X«×°²ªÑ¥÷¦³¤½¥q SJM RESORTS, S.A., em inglês SJM RESORTS, LIMITED |
44 |
| N/234977 | 2025/07/24 | 2025/07/24 | ¿D®Tºî¦X«×°²ªÑ¥÷¦³¤½¥q SJM RESORTS, S.A., em inglês SJM RESORTS, LIMITED |
39 |
| N/234978 | 2025/07/24 | 2025/07/24 | ¿D®Tºî¦X«×°²ªÑ¥÷¦³¤½¥q SJM RESORTS, S.A., em inglês SJM RESORTS, LIMITED |
41 |
| N/234979 | 2025/07/24 | 2025/07/24 | ¿D®Tºî¦X«×°²ªÑ¥÷¦³¤½¥q SJM RESORTS, S.A., em inglês SJM RESORTS, LIMITED |
43 |
| N/234980 | 2025/07/24 | 2025/07/24 | ¿D®Tºî¦X«×°²ªÑ¥÷¦³¤½¥q SJM RESORTS, S.A., em inglês SJM RESORTS, LIMITED |
44 |
| N/234981 | 2025/07/24 | 2025/07/24 | ¿D®Tºî¦X«×°²ªÑ¥÷¦³¤½¥q SJM RESORTS, S.A., em inglês SJM RESORTS, LIMITED |
39 |
| N/234982 | 2025/07/24 | 2025/07/24 | ¿D®Tºî¦X«×°²ªÑ¥÷¦³¤½¥q SJM RESORTS, S.A., em inglês SJM RESORTS, LIMITED |
41 |
| N/234983 | 2025/07/24 | 2025/07/24 | ¿D®Tºî¦X«×°²ªÑ¥÷¦³¤½¥q SJM RESORTS, S.A., em inglês SJM RESORTS, LIMITED |
43 |
| N/234984 | 2025/07/24 | 2025/07/24 | ¿D®Tºî¦X«×°²ªÑ¥÷¦³¤½¥q SJM RESORTS, S.A., em inglês SJM RESORTS, LIMITED |
44 |
| N/234985 | 2025/07/24 | 2025/07/24 | ¿D®Tºî¦X«×°²ªÑ¥÷¦³¤½¥q SJM RESORTS, S.A., em inglês SJM RESORTS, LIMITED |
39 |
| N/234986 | 2025/07/24 | 2025/07/24 | ¿D®Tºî¦X«×°²ªÑ¥÷¦³¤½¥q SJM RESORTS, S.A., em inglês SJM RESORTS, LIMITED |
41 |
| N/234987 | 2025/07/24 | 2025/07/24 | ¿D®Tºî¦X«×°²ªÑ¥÷¦³¤½¥q SJM RESORTS, S.A., em inglês SJM RESORTS, LIMITED |
43 |
| N/234988 | 2025/07/24 | 2025/07/24 | ¿D®Tºî¦X«×°²ªÑ¥÷¦³¤½¥q SJM RESORTS, S.A., em inglês SJM RESORTS, LIMITED |
44 |
| N/234989 | 2025/07/24 | 2025/07/24 | ¿D®Tºî¦X«×°²ªÑ¥÷¦³¤½¥q SJM RESORTS, S.A., em inglês SJM RESORTS, LIMITED |
39 |
| N/234990 | 2025/07/24 | 2025/07/24 | ¿D®Tºî¦X«×°²ªÑ¥÷¦³¤½¥q SJM RESORTS, S.A., em inglês SJM RESORTS, LIMITED |
41 |
| N/234991 | 2025/07/24 | 2025/07/24 | ¿D®Tºî¦X«×°²ªÑ¥÷¦³¤½¥q SJM RESORTS, S.A., em inglês SJM RESORTS, LIMITED |
43 |
| N/234992 | 2025/07/24 | 2025/07/24 | ¿D®Tºî¦X«×°²ªÑ¥÷¦³¤½¥q SJM RESORTS, S.A., em inglês SJM RESORTS, LIMITED |
44 |
| N/234993 | 2025/07/24 | 2025/07/24 | ¿D®Tºî¦X«×°²ªÑ¥÷¦³¤½¥q SJM RESORTS, S.A., em inglês SJM RESORTS, LIMITED |
39 |
| N/234994 | 2025/07/24 | 2025/07/24 | ¿D®Tºî¦X«×°²ªÑ¥÷¦³¤½¥q SJM RESORTS, S.A., em inglês SJM RESORTS, LIMITED |
41 |
| N/234995 | 2025/07/24 | 2025/07/24 | ¿D®Tºî¦X«×°²ªÑ¥÷¦³¤½¥q SJM RESORTS, S.A., em inglês SJM RESORTS, LIMITED |
43 |
| N/234996 | 2025/07/24 | 2025/07/24 | ¿D®Tºî¦X«×°²ªÑ¥÷¦³¤½¥q SJM RESORTS, S.A., em inglês SJM RESORTS, LIMITED |
44 |
| N/234997 | 2025/07/24 | 2025/07/24 | ¿D®Tºî¦X«×°²ªÑ¥÷¦³¤½¥q SJM RESORTS, S.A., em inglês SJM RESORTS, LIMITED |
39 |
| N/234998 | 2025/07/24 | 2025/07/24 | ¿D®Tºî¦X«×°²ªÑ¥÷¦³¤½¥q SJM RESORTS, S.A., em inglês SJM RESORTS, LIMITED |
41 |
| N/234999 | 2025/07/24 | 2025/07/24 | ¿D®Tºî¦X«×°²ªÑ¥÷¦³¤½¥q SJM RESORTS, S.A., em inglês SJM RESORTS, LIMITED |
43 |
| N/235000 | 2025/07/24 | 2025/07/24 | ¿D®Tºî¦X«×°²ªÑ¥÷¦³¤½¥q SJM RESORTS, S.A., em inglês SJM RESORTS, LIMITED |
44 |
| N/235001 | 2025/07/24 | 2025/07/24 | ¿D®Tºî¦X«×°²ªÑ¥÷¦³¤½¥q SJM RESORTS, S.A., em inglês SJM RESORTS, LIMITED |
39 |
| N/235002 | 2025/07/24 | 2025/07/24 | ¿D®Tºî¦X«×°²ªÑ¥÷¦³¤½¥q SJM RESORTS, S.A., em inglês SJM RESORTS, LIMITED |
41 |
| N/235003 | 2025/07/24 | 2025/07/24 | ¿D®Tºî¦X«×°²ªÑ¥÷¦³¤½¥q SJM RESORTS, S.A., em inglês SJM RESORTS, LIMITED |
43 |
| N/235004 | 2025/07/24 | 2025/07/24 | ¿D®Tºî¦X«×°²ªÑ¥÷¦³¤½¥q SJM RESORTS, S.A., em inglês SJM RESORTS, LIMITED |
44 |
| N/235005 | 2025/07/24 | 2025/07/24 | ¿D®Tºî¦X«×°²ªÑ¥÷¦³¤½¥q SJM RESORTS, S.A., em inglês SJM RESORTS, LIMITED |
39 |
| N/235006 | 2025/07/24 | 2025/07/24 | ¿D®Tºî¦X«×°²ªÑ¥÷¦³¤½¥q SJM RESORTS, S.A., em inglês SJM RESORTS, LIMITED |
41 |
| N/235007 | 2025/07/24 | 2025/07/24 | ¿D®Tºî¦X«×°²ªÑ¥÷¦³¤½¥q SJM RESORTS, S.A., em inglês SJM RESORTS, LIMITED |
43 |
| N/235008 | 2025/07/24 | 2025/07/24 | ¿D®Tºî¦X«×°²ªÑ¥÷¦³¤½¥q SJM RESORTS, S.A., em inglês SJM RESORTS, LIMITED |
44 |
| N/235009 | 2025/07/24 | 2025/07/24 | ¿D®Tºî¦X«×°²ªÑ¥÷¦³¤½¥q SJM RESORTS, S.A., em inglês SJM RESORTS, LIMITED |
39 |
| N/235010 | 2025/07/24 | 2025/07/24 | ¿D®Tºî¦X«×°²ªÑ¥÷¦³¤½¥q SJM RESORTS, S.A., em inglês SJM RESORTS, LIMITED |
41 |
| N/235011 | 2025/07/24 | 2025/07/24 | ¿D®Tºî¦X«×°²ªÑ¥÷¦³¤½¥q SJM RESORTS, S.A., em inglês SJM RESORTS, LIMITED |
43 |
| N/235012 | 2025/07/24 | 2025/07/24 | ¿D®Tºî¦X«×°²ªÑ¥÷¦³¤½¥q SJM RESORTS, S.A., em inglês SJM RESORTS, LIMITED |
44 |
| N/235013 | 2025/07/24 | 2025/07/24 | ¿D®Tºî¦X«×°²ªÑ¥÷¦³¤½¥q SJM RESORTS, S.A., em inglês SJM RESORTS, LIMITED |
39 |
| N/235014 | 2025/07/24 | 2025/07/24 | ¿D®Tºî¦X«×°²ªÑ¥÷¦³¤½¥q SJM RESORTS, S.A., em inglês SJM RESORTS, LIMITED |
41 |
| N/235015 | 2025/07/24 | 2025/07/24 | ¿D®Tºî¦X«×°²ªÑ¥÷¦³¤½¥q SJM RESORTS, S.A., em inglês SJM RESORTS, LIMITED |
43 |
| N/235016 | 2025/07/24 | 2025/07/24 | ¿D®Tºî¦X«×°²ªÑ¥÷¦³¤½¥q SJM RESORTS, S.A., em inglês SJM RESORTS, LIMITED |
44 |
| N/235017 | 2025/07/24 | 2025/07/24 | ¿D®Tºî¦X«×°²ªÑ¥÷¦³¤½¥q SJM RESORTS, S.A., em inglês SJM RESORTS, LIMITED |
39 |
| N/235018 | 2025/07/24 | 2025/07/24 | ¿D®Tºî¦X«×°²ªÑ¥÷¦³¤½¥q SJM RESORTS, S.A., em inglês SJM RESORTS, LIMITED |
41 |
| N/235019 | 2025/07/24 | 2025/07/24 | ¿D®Tºî¦X«×°²ªÑ¥÷¦³¤½¥q SJM RESORTS, S.A., em inglês SJM RESORTS, LIMITED |
43 |
| N/235020 | 2025/07/24 | 2025/07/24 | ¿D®Tºî¦X«×°²ªÑ¥÷¦³¤½¥q SJM RESORTS, S.A., em inglês SJM RESORTS, LIMITED |
44 |
| N/235021 | 2025/07/24 | 2025/07/24 | ¿D®Tºî¦X«×°²ªÑ¥÷¦³¤½¥q SJM RESORTS, S.A., em inglês SJM RESORTS, LIMITED |
39 |
| N/235022 | 2025/07/24 | 2025/07/24 | ¿D®Tºî¦X«×°²ªÑ¥÷¦³¤½¥q SJM RESORTS, S.A., em inglês SJM RESORTS, LIMITED |
41 |
| N/235023 | 2025/07/24 | 2025/07/24 | ¿D®Tºî¦X«×°²ªÑ¥÷¦³¤½¥q SJM RESORTS, S.A., em inglês SJM RESORTS, LIMITED |
43 |
| N/235024 | 2025/07/24 | 2025/07/24 | ¿D®Tºî¦X«×°²ªÑ¥÷¦³¤½¥q SJM RESORTS, S.A., em inglês SJM RESORTS, LIMITED |
44 |
| N/235025 | 2025/07/24 | 2025/07/24 | ¿D®Tºî¦X«×°²ªÑ¥÷¦³¤½¥q SJM RESORTS, S.A., em inglês SJM RESORTS, LIMITED |
39 |
| N/235026 | 2025/07/24 | 2025/07/24 | ¿D®Tºî¦X«×°²ªÑ¥÷¦³¤½¥q SJM RESORTS, S.A., em inglês SJM RESORTS, LIMITED |
41 |
| N/235027 | 2025/07/24 | 2025/07/24 | ¿D®Tºî¦X«×°²ªÑ¥÷¦³¤½¥q SJM RESORTS, S.A., em inglês SJM RESORTS, LIMITED |
43 |
| N/235028 | 2025/07/24 | 2025/07/24 | ¿D®Tºî¦X«×°²ªÑ¥÷¦³¤½¥q SJM RESORTS, S.A., em inglês SJM RESORTS, LIMITED |
44 |
| N/235033 | 2025/07/24 | 2025/07/24 | ¿D®Tºî¦X«×°²ªÑ¥÷¦³¤½¥q SJM RESORTS, S.A., em inglês SJM RESORTS, LIMITED |
39 |
| N/235034 | 2025/07/24 | 2025/07/24 | ¿D®Tºî¦X«×°²ªÑ¥÷¦³¤½¥q SJM RESORTS, S.A., em inglês SJM RESORTS, LIMITED |
41 |
| N/235035 | 2025/07/24 | 2025/07/24 | ¿D®Tºî¦X«×°²ªÑ¥÷¦³¤½¥q SJM RESORTS, S.A., em inglês SJM RESORTS, LIMITED |
43 |
| N/235036 | 2025/07/24 | 2025/07/24 | ¿D®Tºî¦X«×°²ªÑ¥÷¦³¤½¥q SJM RESORTS, S.A., em inglês SJM RESORTS, LIMITED |
44 |
| N/235041 | 2025/07/24 | 2025/07/24 | ¿D®Tºî¦X«×°²ªÑ¥÷¦³¤½¥q SJM RESORTS, S.A., em inglês SJM RESORTS, LIMITED |
39 |
| N/235042 | 2025/07/24 | 2025/07/24 | ¿D®Tºî¦X«×°²ªÑ¥÷¦³¤½¥q SJM RESORTS, S.A., em inglês SJM RESORTS, LIMITED |
41 |
| N/235043 | 2025/07/24 | 2025/07/24 | ¿D®Tºî¦X«×°²ªÑ¥÷¦³¤½¥q SJM RESORTS, S.A., em inglês SJM RESORTS, LIMITED |
43 |
| N/235044 | 2025/07/24 | 2025/07/24 | ¿D®Tºî¦X«×°²ªÑ¥÷¦³¤½¥q SJM RESORTS, S.A., em inglês SJM RESORTS, LIMITED |
44 |
| N/235045 | 2025/07/24 | 2025/07/24 | ¿D®Tºî¦X«×°²ªÑ¥÷¦³¤½¥q SJM RESORTS, S.A., em inglês SJM RESORTS, LIMITED |
39 |
| N/235046 | 2025/07/24 | 2025/07/24 | ¿D®Tºî¦X«×°²ªÑ¥÷¦³¤½¥q SJM RESORTS, S.A., em inglês SJM RESORTS, LIMITED |
41 |
| N/235047 | 2025/07/24 | 2025/07/24 | ¿D®Tºî¦X«×°²ªÑ¥÷¦³¤½¥q SJM RESORTS, S.A., em inglês SJM RESORTS, LIMITED |
43 |
| N/235048 | 2025/07/24 | 2025/07/24 | ¿D®Tºî¦X«×°²ªÑ¥÷¦³¤½¥q SJM RESORTS, S.A., em inglês SJM RESORTS, LIMITED |
44 |
| N/235049 | 2025/07/24 | 2025/07/24 | ¿D®Tºî¦X«×°²ªÑ¥÷¦³¤½¥q SJM RESORTS, S.A., em inglês SJM RESORTS, LIMITED |
39 |
| N/235050 | 2025/07/24 | 2025/07/24 | ¿D®Tºî¦X«×°²ªÑ¥÷¦³¤½¥q SJM RESORTS, S.A., em inglês SJM RESORTS, LIMITED |
41 |
| N/235051 | 2025/07/24 | 2025/07/24 | ¿D®Tºî¦X«×°²ªÑ¥÷¦³¤½¥q SJM RESORTS, S.A., em inglês SJM RESORTS, LIMITED |
43 |
| N/235052 | 2025/07/24 | 2025/07/24 | ¿D®Tºî¦X«×°²ªÑ¥÷¦³¤½¥q SJM RESORTS, S.A., em inglês SJM RESORTS, LIMITED |
44 |
| N/235053 | 2025/07/24 | 2025/07/24 | ¿D®Tºî¦X«×°²ªÑ¥÷¦³¤½¥q SJM RESORTS, S.A., em inglês SJM RESORTS, LIMITED |
39 |
| N/235054 | 2025/07/24 | 2025/07/24 | ¿D®Tºî¦X«×°²ªÑ¥÷¦³¤½¥q SJM RESORTS, S.A., em inglês SJM RESORTS, LIMITED |
41 |
| N/235055 | 2025/07/24 | 2025/07/24 | ¿D®Tºî¦X«×°²ªÑ¥÷¦³¤½¥q SJM RESORTS, S.A., em inglês SJM RESORTS, LIMITED |
43 |
| N/235056 | 2025/07/24 | 2025/07/24 | ¿D®Tºî¦X«×°²ªÑ¥÷¦³¤½¥q SJM RESORTS, S.A., em inglês SJM RESORTS, LIMITED |
44 |
| N/235057 | 2025/07/24 | 2025/07/24 | ¿D®Tºî¦X«×°²ªÑ¥÷¦³¤½¥q SJM RESORTS, S.A., em inglês SJM RESORTS, LIMITED |
39 |
| N/235058 | 2025/07/24 | 2025/07/24 | ¿D®Tºî¦X«×°²ªÑ¥÷¦³¤½¥q SJM RESORTS, S.A., em inglês SJM RESORTS, LIMITED |
41 |
| N/235059 | 2025/07/24 | 2025/07/24 | ¿D®Tºî¦X«×°²ªÑ¥÷¦³¤½¥q SJM RESORTS, S.A., em inglês SJM RESORTS, LIMITED |
43 |
| N/235060 | 2025/07/24 | 2025/07/24 | ¿D®Tºî¦X«×°²ªÑ¥÷¦³¤½¥q SJM RESORTS, S.A., em inglês SJM RESORTS, LIMITED |
44 |
| N/235061 | 2025/07/24 | 2025/07/24 | ¿D®Tºî¦X«×°²ªÑ¥÷¦³¤½¥q SJM RESORTS, S.A., em inglês SJM RESORTS, LIMITED |
39 |
| N/235062 | 2025/07/24 | 2025/07/24 | ¿D®Tºî¦X«×°²ªÑ¥÷¦³¤½¥q SJM RESORTS, S.A., em inglês SJM RESORTS, LIMITED |
41 |
| N/235063 | 2025/07/24 | 2025/07/24 | ¿D®Tºî¦X«×°²ªÑ¥÷¦³¤½¥q SJM RESORTS, S.A., em inglês SJM RESORTS, LIMITED |
43 |
| N/235064 | 2025/07/24 | 2025/07/24 | ¿D®Tºî¦X«×°²ªÑ¥÷¦³¤½¥q SJM RESORTS, S.A., em inglês SJM RESORTS, LIMITED |
44 |
| N/235065 | 2025/07/24 | 2025/07/24 | ¿D®Tºî¦X«×°²ªÑ¥÷¦³¤½¥q SJM RESORTS, S.A., em inglês SJM RESORTS, LIMITED |
39 |
| N/235066 | 2025/07/24 | 2025/07/24 | ¿D®Tºî¦X«×°²ªÑ¥÷¦³¤½¥q SJM RESORTS, S.A., em inglês SJM RESORTS, LIMITED |
41 |
| N/235067 | 2025/07/24 | 2025/07/24 | ¿D®Tºî¦X«×°²ªÑ¥÷¦³¤½¥q SJM RESORTS, S.A., em inglês SJM RESORTS, LIMITED |
43 |
| N/235068 | 2025/07/24 | 2025/07/24 | ¿D®Tºî¦X«×°²ªÑ¥÷¦³¤½¥q SJM RESORTS, S.A., em inglês SJM RESORTS, LIMITED |
44 |
| N/235069 | 2025/07/24 | 2025/07/24 | ¿D®Tºî¦X«×°²ªÑ¥÷¦³¤½¥q SJM RESORTS, S.A., em inglês SJM RESORTS, LIMITED |
39 |
| N/235070 | 2025/07/24 | 2025/07/24 | ¿D®Tºî¦X«×°²ªÑ¥÷¦³¤½¥q SJM RESORTS, S.A., em inglês SJM RESORTS, LIMITED |
41 |
| N/235071 | 2025/07/24 | 2025/07/24 | ¿D®Tºî¦X«×°²ªÑ¥÷¦³¤½¥q SJM RESORTS, S.A., em inglês SJM RESORTS, LIMITED |
43 |
| N/235072 | 2025/07/24 | 2025/07/24 | ¿D®Tºî¦X«×°²ªÑ¥÷¦³¤½¥q SJM RESORTS, S.A., em inglês SJM RESORTS, LIMITED |
44 |
| N/235073 | 2025/07/24 | 2025/07/24 | ¿D®Tºî¦X«×°²ªÑ¥÷¦³¤½¥q SJM RESORTS, S.A., em inglês SJM RESORTS, LIMITED |
39 |
| N/235074 | 2025/07/24 | 2025/07/24 | ¿D®Tºî¦X«×°²ªÑ¥÷¦³¤½¥q SJM RESORTS, S.A., em inglês SJM RESORTS, LIMITED |
41 |
| N/235075 | 2025/07/24 | 2025/07/24 | ¿D®Tºî¦X«×°²ªÑ¥÷¦³¤½¥q SJM RESORTS, S.A., em inglês SJM RESORTS, LIMITED |
43 |
| N/235076 | 2025/07/24 | 2025/07/24 | ¿D®Tºî¦X«×°²ªÑ¥÷¦³¤½¥q SJM RESORTS, S.A., em inglês SJM RESORTS, LIMITED |
44 |
| N/235077 | 2025/07/24 | 2025/07/24 | ¿D®Tºî¦X«×°²ªÑ¥÷¦³¤½¥q SJM RESORTS, S.A., em inglês SJM RESORTS, LIMITED |
39 |
| N/235078 | 2025/07/24 | 2025/07/24 | ¿D®Tºî¦X«×°²ªÑ¥÷¦³¤½¥q SJM RESORTS, S.A., em inglês SJM RESORTS, LIMITED |
41 |
| N/235079 | 2025/07/24 | 2025/07/24 | ¿D®Tºî¦X«×°²ªÑ¥÷¦³¤½¥q SJM RESORTS, S.A., em inglês SJM RESORTS, LIMITED |
43 |
| N/235080 | 2025/07/24 | 2025/07/24 | ¿D®Tºî¦X«×°²ªÑ¥÷¦³¤½¥q SJM RESORTS, S.A., em inglês SJM RESORTS, LIMITED |
44 |
| N/235105 | 2025/07/24 | 2025/07/24 | Shenzhen Reo-link Digital Technology Co., Ltd. | 09 |
| N/235139 | 2025/07/24 | 2025/07/24 | ´I¤~¦³¤½¥q | 35 |
| N/235140 | 2025/07/24 | 2025/07/24 | ´I¤~¦³¤½¥q | 38 |
| N/235141 | 2025/07/24 | 2025/07/24 | ´I¤~¦³¤½¥q | 42 |
| N/235189 | 2025/07/24 | 2025/07/24 | Fraser Research Labs. Inc. | 03 |
| N/235215 | 2025/07/24 | 2025/07/24 | ¼s¦{¤»°é«~µPºÞ²zªA°È¦³¤½¥q | 35 |
| N/235216 | 2025/07/24 | 2025/07/24 | ¼s¦{¤»°é«~µPºÞ²zªA°È¦³¤½¥q | 25 |
| N/235222 | 2025/07/24 | 2025/07/24 | KODANSHA LTD. | 09 |
| N/235229 | 2025/07/24 | 2025/07/24 | KODANSHA LTD. | 26 |
| N/235249 | 2025/07/24 | 2025/07/24 | ¬üÃÙ¦Ú¬ü°ê±±ªÑ¦³¤½¥q MJN U.S. HOLDINGS LLC |
29 |
| N/235252 | 2025/07/24 | 2025/07/24 | ¹çªi´¼·uºôµ¸§Þ³N¦³¤½¥q Ningbo Zhihui Network Technology Co., LTD. |
09 |
| N/235460 | 2025/07/24 | 2025/07/24 | ¦ì¤¸°ó¡]¿Dªù¡^¦³¤½¥q WAI YUEN TONG (MACAU) LIMITADA, em inglês WAI YUEN TONG (MACAO) LIMITED |
05 |
| N/235461 | 2025/07/24 | 2025/07/24 | ¦ì¤¸°ó¡]¿Dªù¡^¦³¤½¥q WAI YUEN TONG (MACAU) LIMITADA, em inglês WAI YUEN TONG (MACAO) LIMITED |
35 |
| N/235462 | 2025/07/24 | 2025/07/24 | ¦ì¤¸°ó¡]¿Dªù¡^¦³¤½¥q WAI YUEN TONG (MACAU) LIMITADA, em inglês WAI YUEN TONG (MACAO) LIMITED |
44 |
| N/235463 | 2025/07/24 | 2025/07/24 | ¦ì¤¸°ó¡]¿Dªù¡^¦³¤½¥q WAI YUEN TONG (MACAU) LIMITADA, em inglês WAI YUEN TONG (MACAO) LIMITED |
05 |
| N/235464 | 2025/07/24 | 2025/07/24 | ¦ì¤¸°ó¡]¿Dªù¡^¦³¤½¥q WAI YUEN TONG (MACAU) LIMITADA, em inglês WAI YUEN TONG (MACAO) LIMITED |
35 |
| N/235465 | 2025/07/24 | 2025/07/24 | ¦ì¤¸°ó¡]¿Dªù¡^¦³¤½¥q WAI YUEN TONG (MACAU) LIMITADA, em inglês WAI YUEN TONG (MACAO) LIMITED |
44 |
| N/235466 | 2025/07/24 | 2025/07/24 | ¦ì¤¸°ó¡]¿Dªù¡^¦³¤½¥q WAI YUEN TONG (MACAU) LIMITADA, em inglês WAI YUEN TONG (MACAO) LIMITED |
05 |
| N/235467 | 2025/07/24 | 2025/07/24 | ¦ì¤¸°ó¡]¿Dªù¡^¦³¤½¥q WAI YUEN TONG (MACAU) LIMITADA, em inglês WAI YUEN TONG (MACAO) LIMITED |
35 |
| N/235468 | 2025/07/24 | 2025/07/24 | ¦ì¤¸°ó¡]¿Dªù¡^¦³¤½¥q WAI YUEN TONG (MACAU) LIMITADA, em inglês WAI YUEN TONG (MACAO) LIMITED |
44 |
| N/235469 | 2025/07/24 | 2025/07/24 | ¦ì¤¸°ó¡]¿Dªù¡^¦³¤½¥q WAI YUEN TONG (MACAU) LIMITADA, em inglês WAI YUEN TONG (MACAO) LIMITED |
05 |
| N/235470 | 2025/07/24 | 2025/07/24 | ¦ì¤¸°ó¡]¿Dªù¡^¦³¤½¥q WAI YUEN TONG (MACAU) LIMITADA, em inglês WAI YUEN TONG (MACAO) LIMITED |
35 |
| N/235471 | 2025/07/24 | 2025/07/24 | ¦ì¤¸°ó¡]¿Dªù¡^¦³¤½¥q WAI YUEN TONG (MACAU) LIMITADA, em inglês WAI YUEN TONG (MACAO) LIMITED |
44 |
| N/235472 | 2025/07/24 | 2025/07/24 | ¦ì¤¸°ó¡]¿Dªù¡^¦³¤½¥q WAI YUEN TONG (MACAU) LIMITADA, em inglês WAI YUEN TONG (MACAO) LIMITED |
05 |
| N/235473 | 2025/07/24 | 2025/07/24 | ¦ì¤¸°ó¡]¿Dªù¡^¦³¤½¥q WAI YUEN TONG (MACAU) LIMITADA, em inglês WAI YUEN TONG (MACAO) LIMITED |
35 |
| N/235474 | 2025/07/24 | 2025/07/24 | ¦ì¤¸°ó¡]¿Dªù¡^¦³¤½¥q WAI YUEN TONG (MACAU) LIMITADA, em inglês WAI YUEN TONG (MACAO) LIMITED |
44 |
| N/235475 | 2025/07/24 | 2025/07/24 | ¦ì¤¸°ó¡]¿Dªù¡^¦³¤½¥q WAI YUEN TONG (MACAU) LIMITADA, em inglês WAI YUEN TONG (MACAO) LIMITED |
05 |
| N/235476 | 2025/07/24 | 2025/07/24 | ¦ì¤¸°ó¡]¿Dªù¡^¦³¤½¥q WAI YUEN TONG (MACAU) LIMITADA, em inglês WAI YUEN TONG (MACAO) LIMITED |
35 |
| N/235477 | 2025/07/24 | 2025/07/24 | ¦ì¤¸°ó¡]¿Dªù¡^¦³¤½¥q WAI YUEN TONG (MACAU) LIMITADA, em inglês WAI YUEN TONG (MACAO) LIMITED |
44 |
| N/235478 | 2025/07/24 | 2025/07/24 | ¦ì¤¸°ó¡]¿Dªù¡^¦³¤½¥q WAI YUEN TONG (MACAU) LIMITADA, em inglês WAI YUEN TONG (MACAO) LIMITED |
05 |
| N/235479 | 2025/07/24 | 2025/07/24 | ¦ì¤¸°ó¡]¿Dªù¡^¦³¤½¥q WAI YUEN TONG (MACAU) LIMITADA, em inglês WAI YUEN TONG (MACAO) LIMITED |
35 |
| N/235480 | 2025/07/24 | 2025/07/24 | ¦ì¤¸°ó¡]¿Dªù¡^¦³¤½¥q WAI YUEN TONG (MACAU) LIMITADA, em inglês WAI YUEN TONG (MACAO) LIMITED |
44 |
| N/235528 | 2025/07/24 | 2025/07/24 | ³·ªáÂN»æ¦æ¦³¤½¥q | 30 |
| N/235537 | 2025/07/24 | 2025/07/24 | ±ç±ê®p LEONG CHI FONG |
30 |
| N/235541 | 2025/07/24 | 2025/07/24 | ¿Dªù½á§g±dÃÄ·~¦³¤½¥q | 30 |
| N/235543 | 2025/07/24 | 2025/07/24 | JSL-Material Eléctrico, S.A. | 09 |
| N/235620 | 2025/07/24 | 2025/07/24 | De Beers UK Limited | 14 |
| N/235621 | 2025/07/24 | 2025/07/24 | De Beers UK Limited | 35 |
| N/235701 | 2025/07/24 | 2025/07/24 | SABELT S.p.A. | 09 |
| N/235702 | 2025/07/24 | 2025/07/24 | SABELT S.p.A. | 12 |
| N/235704 | 2025/07/24 | 2025/07/24 | ¬üÃÙ¦Ú¬ü°ê±±ªÑ¦³¤½¥q MJN U.S. HOLDINGS LLC |
29 |
| N/235708 | 2025/07/24 | 2025/07/24 | ¬üÃÙ¦Ú¬ü°ê±±ªÑ¦³¤½¥q MJN U.S. HOLDINGS LLC |
29 |
| N/235835 | 2025/07/24 | 2025/07/24 | ¾GÀA¬Â CHEANG KAM LENG |
35 |
| N/235843 | 2025/07/24 | 2025/07/24 | Cross Studio Asia Limited | 16 |
| N/235857 | 2025/07/24 | 2025/07/24 | Shimano Inc. | 28 |
| N/235994 | 2025/07/24 | 2025/07/24 | ¬Õ¨³À\¶¼ºÞ²z§ë¸ê¦³¤½¥q | 30 |
| N/235995 | 2025/07/24 | 2025/07/24 | ¬Õ¨³À\¶¼ºÞ²z§ë¸ê¦³¤½¥q | 43 |
| N/236206 | 2025/07/24 | 2025/07/24 | ³t¶ìª÷±_±±ªÑ¡]¼s¦{¡^¦X¹Ù¥ø·~¡]´¶³q¦X¹Ù¡^ | 03 |
| N/236287 | 2025/07/24 | 2025/07/24 | ¦Ê¤tÃÄ·~¦³¤½¥q PAK CHUN MEDICAMENTO LIMITADA |
05 |
| N/236289 | 2025/07/24 | 2025/07/24 | ¤W®üªB»P䨫~µPºÞ²z¦³¤½¥q | 43 |
| N/236290 | 2025/07/24 | 2025/07/24 | ESSENTIAL EXPORT LIMITADA | 14 |
| N/236291 | 2025/07/24 | 2025/07/24 | ESSENTIAL EXPORT LIMITADA | 18 |
| N/236292 | 2025/07/24 | 2025/07/24 | ESSENTIAL EXPORT LIMITADA | 20 |
| N/236293 | 2025/07/24 | 2025/07/24 | ESSENTIAL EXPORT LIMITADA | 21 |
| N/236294 | 2025/07/24 | 2025/07/24 | ESSENTIAL EXPORT LIMITADA | 22 |
| N/236295 | 2025/07/24 | 2025/07/24 | ESSENTIAL EXPORT LIMITADA | 24 |
| N/236296 | 2025/07/24 | 2025/07/24 | ESSENTIAL EXPORT LIMITADA | 25 |
| N/236297 | 2025/07/24 | 2025/07/24 | ESSENTIAL EXPORT LIMITADA | 35 |
| N/236298 | 2025/07/24 | 2025/07/24 | ¦óª÷øÊ | 05 |
| N/236299 | 2025/07/24 | 2025/07/24 | FTG Company Corporation | 43 |
| N/236300 | 2025/07/24 | 2025/07/24 | »¯µú»ö¥Hâªä¶T©ö¤½¥q¤§¦WÀç·~ CHIU, WING YEE trading as NING SUM TRADING COMPANY |
05 |
| N/236301 | 2025/07/24 | 2025/07/24 | »¯µú»ö¥Hâªä¶T©ö¤½¥q¤§¦WÀç·~ CHIU, WING YEE trading as NING SUM TRADING COMPANY |
10 |
| N/236302 | 2025/07/24 | 2025/07/24 | ¤ý®m»¨ | 30 |
| N/236304 | 2025/07/24 | 2025/07/24 | TOPPAN Holdings Inc. | 10 |
| N/236305 | 2025/07/24 | 2025/07/24 | TOPPAN Holdings Inc. | 12 |
| N/236306 | 2025/07/24 | 2025/07/24 | TOPPAN Holdings Inc. | 17 |
| N/236307 | 2025/07/24 | 2025/07/24 | TOPPAN Holdings Inc. | 42 |
| N/236308 | 2025/07/24 | 2025/07/24 | ¼s¦{¥«¥ÍµoÀ\¶¼¦³¤½¥q Guangzhou Shengfa Catering Co., Ltd. |
29 |
| N/236309 | 2025/07/24 | 2025/07/24 | ³¢¶W | 43 |
| N/236320 | 2025/07/24 | 2025/07/24 | ¤W®ü¥@¦n¹«~ªÑ¥÷¦³¤½¥q | 30 |
| N/236321 | 2025/07/24 | 2025/07/24 | ¤W®ü¥@¦n¹«~ªÑ¥÷¦³¤½¥q | 35 |
| N/236322 | 2025/07/24 | 2025/07/24 | ¤W®ü¥@¦n¹«~ªÑ¥÷¦³¤½¥q | 43 |
| N/236324 | 2025/07/24 | 2025/07/24 | ªF²ð¥«¤T¤À¤§¤@ºÎ¯v¬ì§Þ¦³¤½¥q | 20 |
| N/236326 | 2025/07/24 | 2025/07/24 | ®è¦¡·|ªÀ¼}·s»ã MUSINSA Co., Ltd. |
04 |
| N/236327 | 2025/07/24 | 2025/07/24 | ®è¦¡·|ªÀ¼}·s»ã MUSINSA Co., Ltd. |
05 |
| N/236328 | 2025/07/24 | 2025/07/24 | ®è¦¡·|ªÀ¼}·s»ã MUSINSA Co., Ltd. |
08 |
| N/236331 | 2025/07/24 | 2025/07/24 | ®è¦¡·|ªÀ¼}·s»ã MUSINSA Co., Ltd. |
16 |
| N/236332 | 2025/07/24 | 2025/07/24 | ®è¦¡·|ªÀ¼}·s»ã MUSINSA Co., Ltd. |
18 |
| N/236333 | 2025/07/24 | 2025/07/24 | ®è¦¡·|ªÀ¼}·s»ã MUSINSA Co., Ltd. |
21 |
| N/236334 | 2025/07/24 | 2025/07/24 | ®è¦¡·|ªÀ¼}·s»ã MUSINSA Co., Ltd. |
24 |
| N/236336 | 2025/07/24 | 2025/07/24 | ®è¦¡·|ªÀ¼}·s»ã MUSINSA Co., Ltd. |
35 |
| N/236338 | 2025/07/24 | 2025/07/24 | ®è¦¡·|ªÀ¼}·s»ã MUSINSA Co., Ltd. |
04 |
| N/236339 | 2025/07/24 | 2025/07/24 | ®è¦¡·|ªÀ¼}·s»ã MUSINSA Co., Ltd. |
05 |
| N/236340 | 2025/07/24 | 2025/07/24 | ®è¦¡·|ªÀ¼}·s»ã MUSINSA Co., Ltd. |
08 |
| N/236343 | 2025/07/24 | 2025/07/24 | ®è¦¡·|ªÀ¼}·s»ã MUSINSA Co., Ltd. |
16 |
| N/236344 | 2025/07/24 | 2025/07/24 | ®è¦¡·|ªÀ¼}·s»ã MUSINSA Co., Ltd. |
18 |
| N/236345 | 2025/07/24 | 2025/07/24 | ®è¦¡·|ªÀ¼}·s»ã MUSINSA Co., Ltd. |
21 |
| N/236346 | 2025/07/24 | 2025/07/24 | ®è¦¡·|ªÀ¼}·s»ã MUSINSA Co., Ltd. |
24 |
| N/236348 | 2025/07/24 | 2025/07/24 | ®è¦¡·|ªÀ¼}·s»ã MUSINSA Co., Ltd. |
35 |
| N/236350 | 2025/07/24 | 2025/07/24 | ®è¦¡·|ªÀ¼}·s»ã MUSINSA Co., Ltd. |
04 |
| N/236351 | 2025/07/24 | 2025/07/24 | ®è¦¡·|ªÀ¼}·s»ã MUSINSA Co., Ltd. |
05 |
| N/236352 | 2025/07/24 | 2025/07/24 | ®è¦¡·|ªÀ¼}·s»ã MUSINSA Co., Ltd. |
08 |
| N/236355 | 2025/07/24 | 2025/07/24 | ®è¦¡·|ªÀ¼}·s»ã MUSINSA Co., Ltd. |
16 |
| N/236356 | 2025/07/24 | 2025/07/24 | ®è¦¡·|ªÀ¼}·s»ã MUSINSA Co., Ltd. |
18 |
| N/236357 | 2025/07/24 | 2025/07/24 | ®è¦¡·|ªÀ¼}·s»ã MUSINSA Co., Ltd. |
21 |
| N/236358 | 2025/07/24 | 2025/07/24 | ®è¦¡·|ªÀ¼}·s»ã MUSINSA Co., Ltd. |
24 |
| N/236360 | 2025/07/24 | 2025/07/24 | ®è¦¡·|ªÀ¼}·s»ã MUSINSA Co., Ltd. |
35 |
| N/236362 | 2025/07/24 | 2025/07/24 | ®è¦¡·|ªÀ¼}·s»ã MUSINSA Co., Ltd. |
04 |
| N/236363 | 2025/07/24 | 2025/07/24 | ®è¦¡·|ªÀ¼}·s»ã MUSINSA Co., Ltd. |
05 |
| N/236366 | 2025/07/24 | 2025/07/24 | ®è¦¡·|ªÀ¼}·s»ã MUSINSA Co., Ltd. |
18 |
| N/236367 | 2025/07/24 | 2025/07/24 | ®è¦¡·|ªÀ¼}·s»ã MUSINSA Co., Ltd. |
24 |
| N/236369 | 2025/07/24 | 2025/07/24 | ®è¦¡·|ªÀ¼}·s»ã MUSINSA Co., Ltd. |
35 |
| N/236372 | 2025/07/24 | 2025/07/24 | ®è¦¡·|ªÀ¼}·s»ã MUSINSA Co., Ltd. |
42 |
| N/236373 | 2025/07/24 | 2025/07/24 | ´I¤å¹«~¡]¤W®ü¡^¦³¤½¥q FOOD VENDING CHINA CO., LTD |
29 |
| N/236374 | 2025/07/24 | 2025/07/24 | ´I¤å¹«~¡]¤W®ü¡^¦³¤½¥q FOOD VENDING CHINA CO., LTD |
30 |
| N/236375 | 2025/07/24 | 2025/07/24 | ´I¤å¹«~¡]¤W®ü¡^¦³¤½¥q FOOD VENDING CHINA CO., LTD |
43 |
| N/236376 | 2025/07/24 | 2025/07/24 | PIECE PEACE STUDIO CO., Ltd. | 18 |
| N/236377 | 2025/07/24 | 2025/07/24 | PIECE PEACE STUDIO CO., Ltd. | 25 |
| N/236378 | 2025/07/24 | 2025/07/24 | PIECE PEACE STUDIO CO., Ltd. | 35 |
| N/236379 | 2025/07/24 | 2025/07/24 | ¿Dªù°ê»Ú¾÷³õ±MÀçªÑ¥÷¦³¤½¥q | 16 |
| N/236380 | 2025/07/24 | 2025/07/24 | ¿Dªù°ê»Ú¾÷³õ±MÀçªÑ¥÷¦³¤½¥q | 35 |
| N/236381 | 2025/07/24 | 2025/07/24 | ¿Dªù°ê»Ú¾÷³õ±MÀçªÑ¥÷¦³¤½¥q | 39 |
| N/236382 | 2025/07/24 | 2025/07/24 | ¿Dªù°ê»Ú¾÷³õ±MÀçªÑ¥÷¦³¤½¥q | 16 |
| N/236383 | 2025/07/24 | 2025/07/24 | ¿Dªù°ê»Ú¾÷³õ±MÀçªÑ¥÷¦³¤½¥q | 35 |
| N/236384 | 2025/07/24 | 2025/07/24 | ¿Dªù°ê»Ú¾÷³õ±MÀçªÑ¥÷¦³¤½¥q | 39 |
| N/236385 | 2025/07/24 | 2025/07/24 | ¿Dªù°ê»Ú¾÷³õ±MÀçªÑ¥÷¦³¤½¥q | 16 |
| N/236386 | 2025/07/24 | 2025/07/24 | ¿Dªù°ê»Ú¾÷³õ±MÀçªÑ¥÷¦³¤½¥q | 35 |
| N/236387 | 2025/07/24 | 2025/07/24 | ¿Dªù°ê»Ú¾÷³õ±MÀçªÑ¥÷¦³¤½¥q | 39 |
| N/236388 | 2025/07/24 | 2025/07/24 | ¿Dªù°ê»Ú¾÷³õ±MÀçªÑ¥÷¦³¤½¥q | 16 |
| N/236389 | 2025/07/24 | 2025/07/24 | ¿Dªù°ê»Ú¾÷³õ±MÀçªÑ¥÷¦³¤½¥q | 35 |
| N/236390 | 2025/07/24 | 2025/07/24 | ¿Dªù°ê»Ú¾÷³õ±MÀçªÑ¥÷¦³¤½¥q | 39 |
| N/236391 | 2025/07/24 | 2025/07/24 | ¿Dªù°ê»Ú¾÷³õ±MÀçªÑ¥÷¦³¤½¥q | 16 |
| N/236392 | 2025/07/24 | 2025/07/24 | ¿Dªù°ê»Ú¾÷³õ±MÀçªÑ¥÷¦³¤½¥q | 35 |
| N/236393 | 2025/07/24 | 2025/07/24 | ¿Dªù°ê»Ú¾÷³õ±MÀçªÑ¥÷¦³¤½¥q | 39 |
| N/236394 | 2025/07/24 | 2025/07/24 | ¿Dªù°ê»Ú¾÷³õ±MÀçªÑ¥÷¦³¤½¥q | 16 |
| N/236395 | 2025/07/24 | 2025/07/24 | ¿Dªù°ê»Ú¾÷³õ±MÀçªÑ¥÷¦³¤½¥q | 35 |
| N/236396 | 2025/07/24 | 2025/07/24 | ¿Dªù°ê»Ú¾÷³õ±MÀçªÑ¥÷¦³¤½¥q | 39 |
| N/236397 | 2025/07/24 | 2025/07/24 | ¿Dªù°ê»Ú¾÷³õ±MÀçªÑ¥÷¦³¤½¥q | 16 |
| N/236398 | 2025/07/24 | 2025/07/24 | ¿Dªù°ê»Ú¾÷³õ±MÀçªÑ¥÷¦³¤½¥q | 35 |
| N/236399 | 2025/07/24 | 2025/07/24 | ¿Dªù°ê»Ú¾÷³õ±MÀçªÑ¥÷¦³¤½¥q | 39 |
| N/236400 | 2025/07/24 | 2025/07/24 | ¿Dªù°ê»Ú¾÷³õ±MÀçªÑ¥÷¦³¤½¥q | 16 |
| N/236401 | 2025/07/24 | 2025/07/24 | ¿Dªù°ê»Ú¾÷³õ±MÀçªÑ¥÷¦³¤½¥q | 35 |
| N/236402 | 2025/07/24 | 2025/07/24 | ¿Dªù°ê»Ú¾÷³õ±MÀçªÑ¥÷¦³¤½¥q | 39 |
| N/236403 | 2025/07/24 | 2025/07/24 | ¿Dªù°ê»Ú¾÷³õ±MÀçªÑ¥÷¦³¤½¥q | 16 |
| N/236404 | 2025/07/24 | 2025/07/24 | ¿Dªù°ê»Ú¾÷³õ±MÀçªÑ¥÷¦³¤½¥q | 35 |
| N/236405 | 2025/07/24 | 2025/07/24 | ¿Dªù°ê»Ú¾÷³õ±MÀçªÑ¥÷¦³¤½¥q | 39 |
| N/236406 | 2025/07/24 | 2025/07/24 | ¿Dªù°ê»Ú¾÷³õ±MÀçªÑ¥÷¦³¤½¥q | 16 |
| N/236407 | 2025/07/24 | 2025/07/24 | ¿Dªù°ê»Ú¾÷³õ±MÀçªÑ¥÷¦³¤½¥q | 35 |
| N/236408 | 2025/07/24 | 2025/07/24 | ¿Dªù°ê»Ú¾÷³õ±MÀçªÑ¥÷¦³¤½¥q | 39 |
| N/236409 | 2025/07/24 | 2025/07/24 | ¿Dªù°ê»Ú¾÷³õ±MÀçªÑ¥÷¦³¤½¥q | 16 |
| N/236410 | 2025/07/24 | 2025/07/24 | ¿Dªù°ê»Ú¾÷³õ±MÀçªÑ¥÷¦³¤½¥q | 35 |
| N/236411 | 2025/07/24 | 2025/07/24 | ¿Dªù°ê»Ú¾÷³õ±MÀçªÑ¥÷¦³¤½¥q | 39 |
| N/236412 | 2025/07/24 | 2025/07/24 | ¿Dªù°ê»Ú¾÷³õ±MÀçªÑ¥÷¦³¤½¥q | 16 |
| N/236413 | 2025/07/24 | 2025/07/24 | ¿Dªù°ê»Ú¾÷³õ±MÀçªÑ¥÷¦³¤½¥q | 35 |
| N/236414 | 2025/07/24 | 2025/07/24 | ¿Dªù°ê»Ú¾÷³õ±MÀçªÑ¥÷¦³¤½¥q | 39 |
| N/236415 | 2025/07/24 | 2025/07/24 | ¿Dªù°ê»Ú¾÷³õ±MÀçªÑ¥÷¦³¤½¥q | 16 |
| N/236416 | 2025/07/24 | 2025/07/24 | ¿Dªù°ê»Ú¾÷³õ±MÀçªÑ¥÷¦³¤½¥q | 35 |
| N/236417 | 2025/07/24 | 2025/07/24 | ¿Dªù°ê»Ú¾÷³õ±MÀçªÑ¥÷¦³¤½¥q | 39 |
| N/236418 | 2025/07/24 | 2025/07/24 | ¿Dªù°ê»Ú¾÷³õ±MÀçªÑ¥÷¦³¤½¥q | 16 |
| N/236419 | 2025/07/24 | 2025/07/24 | ¿Dªù°ê»Ú¾÷³õ±MÀçªÑ¥÷¦³¤½¥q | 35 |
| N/236420 | 2025/07/24 | 2025/07/24 | ¿Dªù°ê»Ú¾÷³õ±MÀçªÑ¥÷¦³¤½¥q | 39 |
| N/236421 | 2025/07/24 | 2025/07/24 | ¿Dªù°ê»Ú¾÷³õ±MÀçªÑ¥÷¦³¤½¥q | 16 |
| N/236422 | 2025/07/24 | 2025/07/24 | ¿Dªù°ê»Ú¾÷³õ±MÀçªÑ¥÷¦³¤½¥q | 35 |
| N/236423 | 2025/07/24 | 2025/07/24 | ¿Dªù°ê»Ú¾÷³õ±MÀçªÑ¥÷¦³¤½¥q | 39 |
| N/236427 | 2025/07/24 | 2025/07/24 | Lee Kum Kee Company Limited | 29 |
| N/236428 | 2025/07/24 | 2025/07/24 | Lee Kum Kee Company Limited | 30 |
| N/236429 | 2025/07/24 | 2025/07/24 | Lee Kum Kee Company Limited | 32 |
| N/236430 | 2025/07/24 | 2025/07/24 | ¿D±d¶³¦³¤½¥q MACAU HEALTHFUL CLOUD COMPANY LIMITED |
35 |
| N/236431 | 2025/07/24 | 2025/07/24 | ¿D±d¶³¦³¤½¥q MACAU HEALTHFUL CLOUD COMPANY LIMITED |
39 |
| N/236432 | 2025/07/24 | 2025/07/24 | ¿D±d¶³¦³¤½¥q MACAU HEALTHFUL CLOUD COMPANY LIMITED |
44 |
| N/236433 | 2025/07/24 | 2025/07/24 | The Nexus Luxury Collection Ltd. | 41 |
| N/236434 | 2025/07/24 | 2025/07/24 | The Nexus Luxury Collection Ltd. | 42 |
| N/236435 | 2025/07/24 | 2025/07/24 | The Nexus Luxury Collection Ltd. | 43 |
| N/236436 | 2025/07/24 | 2025/07/24 | ¯]®üµØµo¶°¹Î¦³¤½¥q | 36 |
| N/236438 | 2025/07/24 | 2025/07/24 | Six Continents Limited | 36 |
| N/236441 | 2025/07/24 | 2025/07/24 | °g§A¤ò¦³¤½¥q MINIMALIST COMPANY LIMITED |
29 |
| N/236442 | 2025/07/24 | 2025/07/24 | °g§A¤ò¦³¤½¥q MINIMALIST COMPANY LIMITED |
30 |
| N/236443 | 2025/07/24 | 2025/07/24 | °g§A¤ò¦³¤½¥q MINIMALIST COMPANY LIMITED |
43 |
| N/236447 | 2025/07/24 | 2025/07/24 | °ò«ä·N°ê»Ú¦³¤½¥q Ks Creation International Limited |
09 |
| N/236449 | 2025/07/24 | 2025/07/24 | Ä˰T±±ªÑ¦³¤½¥q TENCENT HOLDINGS LIMITED |
09 |
| N/236450 | 2025/07/24 | 2025/07/24 | Ä˰T±±ªÑ¦³¤½¥q TENCENT HOLDINGS LIMITED |
42 |
| N/236451 | 2025/07/24 | 2025/07/24 | Basciano Trading Corporation Limited | 36 |
| N/236453 | 2025/07/24 | 2025/07/24 | Basciano Trading Corporation Limited | 36 |
| N/236454 | 2025/07/24 | 2025/07/24 | TDAB Sociedade Unipessoal Limitada | 09 |
| N/236456 | 2025/07/24 | 2025/07/24 | TDAB Sociedade Unipessoal Limitada | 25 |
| N/236457 | 2025/07/24 | 2025/07/24 | TDAB Sociedade Unipessoal Limitada | 41 |
| N/236458 | 2025/07/24 | 2025/07/24 | TDAB Sociedade Unipessoal Limitada | 43 |
| N/236459 | 2025/07/24 | 2025/07/24 | TDAB Sociedade Unipessoal Limitada | 09 |
| N/236461 | 2025/07/24 | 2025/07/24 | TDAB Sociedade Unipessoal Limitada | 25 |
| N/236462 | 2025/07/24 | 2025/07/24 | TDAB Sociedade Unipessoal Limitada | 41 |
| N/236463 | 2025/07/24 | 2025/07/24 | TDAB Sociedade Unipessoal Limitada | 43 |
| N/236464 | 2025/07/24 | 2025/07/24 | TDAB Sociedade Unipessoal Limitada | 09 |
| N/236466 | 2025/07/24 | 2025/07/24 | TDAB Sociedade Unipessoal Limitada | 25 |
| N/236467 | 2025/07/24 | 2025/07/24 | TDAB Sociedade Unipessoal Limitada | 41 |
| N/236468 | 2025/07/24 | 2025/07/24 | TDAB Sociedade Unipessoal Limitada | 43 |
| N/236469 | 2025/07/24 | 2025/07/24 | TDAB Sociedade Unipessoal Limitada | 09 |
| N/236471 | 2025/07/24 | 2025/07/24 | TDAB Sociedade Unipessoal Limitada | 25 |
| N/236472 | 2025/07/24 | 2025/07/24 | TDAB Sociedade Unipessoal Limitada | 41 |
| N/236473 | 2025/07/24 | 2025/07/24 | TDAB Sociedade Unipessoal Limitada | 43 |
| N/236478 | 2025/07/24 | 2025/07/24 | ¤W®ü¸U¬Û¦X¤@¤Æ§©«~¦³¤½¥q SHANGHAI WANXIANG HEYI COSMETICS CO., LTD. |
03 |
| N/236479 | 2025/07/24 | 2025/07/24 | ¤W®ü×»ô¹ê·~µo®i¦³¤½¥q | 14 |
| N/236484 | 2025/07/24 | 2025/07/24 | ÅW¼ÖÀ\¶¼¹ê·~ªÑ¥÷¦³¤½¥q | 09 |
| N/236485 | 2025/07/24 | 2025/07/24 | ÅW¼ÖÀ\¶¼¹ê·~ªÑ¥÷¦³¤½¥q | 35 |
| N/236486 | 2025/07/24 | 2025/07/24 | ÅW¼ÖÀ\¶¼¹ê·~ªÑ¥÷¦³¤½¥q | 43 |
| N/236487 | 2025/07/24 | 2025/07/24 | Ä˰T±±ªÑ¦³¤½¥q TENCENT HOLDINGS LIMITED |
09 |
| N/236488 | 2025/07/24 | 2025/07/24 | Ä˰T±±ªÑ¦³¤½¥q TENCENT HOLDINGS LIMITED |
41 |
| N/236489 | 2025/07/24 | 2025/07/24 | Ä˰T±±ªÑ¦³¤½¥q TENCENT HOLDINGS LIMITED |
09 |
| N/236490 | 2025/07/24 | 2025/07/24 | Ä˰T±±ªÑ¦³¤½¥q TENCENT HOLDINGS LIMITED |
41 |
| N/236491 | 2025/07/24 | 2025/07/24 | ¥_¨Ê¦³¦Ë©~ºôµ¸§Þ³N¦³¤½¥q Beijing Youzhuju Network Technology Co., Ltd. |
42 |
| N/236494 | 2025/07/24 | 2025/07/24 | ¥_¨Ê¦³¦Ë©~ºôµ¸§Þ³N¦³¤½¥q Beijing Youzhuju Network Technology Co., Ltd. |
09 |
| N/236495 | 2025/07/24 | 2025/07/24 | ¥_¨Ê¦³¦Ë©~ºôµ¸§Þ³N¦³¤½¥q Beijing Youzhuju Network Technology Co., Ltd. |
42 |
| N/236498 | 2025/07/24 | 2025/07/24 | ¥_¨Ê¦³¦Ë©~ºôµ¸§Þ³N¦³¤½¥q Beijing Youzhuju Network Technology Co., Ltd. |
09 |
| N/236502 | 2025/07/24 | 2025/07/24 | ¥_¨Ê¦³¦Ë©~ºôµ¸§Þ³N¦³¤½¥q Beijing Youzhuju Network Technology Co., Ltd. |
09 |
| N/236506 | 2025/07/24 | 2025/07/24 | ¥_¨Ê¦³¦Ë©~ºôµ¸§Þ³N¦³¤½¥q Beijing Youzhuju Network Technology Co., Ltd. |
09 |
| N/236511 | 2025/07/24 | 2025/07/24 | ²Î¤@¥ø·~ªÑ¥÷¦³¤½¥q Uni-President Enterprises Corp. |
30 |
| N/236512 | 2025/07/24 | 2025/07/24 | ºaÄ£²×ºÝªÑ¥÷¦³¤½¥q Honor Device Co., Ltd. |
09 |
| N/236513 | 2025/07/24 | 2025/07/24 | ¥_¨Ê¦³¦Ë©~ºôµ¸§Þ³N¦³¤½¥q Beijing Youzhuju Network Technology Co., Ltd. |
42 |
| N/236516 | 2025/07/24 | 2025/07/24 | ¥_¨Ê¦³¦Ë©~ºôµ¸§Þ³N¦³¤½¥q Beijing Youzhuju Network Technology Co., Ltd. |
09 |
| N/236517 | 2025/07/24 | 2025/07/24 | ¥_¨Ê¦³¦Ë©~ºôµ¸§Þ³N¦³¤½¥q Beijing Youzhuju Network Technology Co., Ltd. |
42 |
| N/236520 | 2025/07/24 | 2025/07/24 | ¥_¨Ê¦³¦Ë©~ºôµ¸§Þ³N¦³¤½¥q Beijing Youzhuju Network Technology Co., Ltd. |
09 |
| N/236521 | 2025/07/24 | 2025/07/24 | ªF²ð±ZÊa®a©~¦³¤½¥q | 20 |
| N/236522 | 2025/07/24 | 2025/07/24 | ªF²ð±ZÊa®a©~¦³¤½¥q | 24 |
| N/236523 | 2025/07/24 | 2025/07/24 | ¦Ê¤O¶°¹Î¦³¤½¥q COMPANHIA BAI LI GRUPO LDA. |
33 |
| N/236524 | 2025/07/24 | 2025/07/24 | ¦Ê¤O¶°¹Î¦³¤½¥q COMPANHIA BAI LI GRUPO LDA. |
33 |
| N/236525 | 2025/07/24 | 2025/07/24 | ¦Ê¤O¶°¹Î¦³¤½¥q COMPANHIA BAI LI GRUPO LDA. |
33 |
| N/236526 | 2025/07/24 | 2025/07/24 | ¦Ê¤O¶°¹Î¦³¤½¥q COMPANHIA BAI LI GRUPO LDA. |
33 |
| N/236527 | 2025/07/24 | 2025/07/24 | ¦Ê¤O¶°¹Î¦³¤½¥q COMPANHIA BAI LI GRUPO LDA. |
33 |
| N/236530 | 2025/07/24 | 2025/07/24 | ¤W®ü¸U¬Û¦X¤@¤Æ§©«~¦³¤½¥q SHANGHAI WANXIANG HEYI COSMETICS CO., LTD. |
35 |
| N/236532 | 2025/07/24 | 2025/07/24 | ALPI S.P.A. | 19 |
| N/236533 | 2025/07/24 | 2025/07/24 | ALPI S.P.A. | 20 |
| N/236534 | 2025/07/24 | 2025/07/24 | ¦«Ä_´¼¯à¤è®×¦³¤½¥q Tobot Solution Limited |
07 |
| N/236535 | 2025/07/24 | 2025/07/24 | ¦«Ä_´¼¯à¤è®×¦³¤½¥q Tobot Solution Limited |
09 |
| N/236536 | 2025/07/24 | 2025/07/24 | ¦«Ä_´¼¯à¤è®×¦³¤½¥q Tobot Solution Limited |
42 |
| N/236537 | 2025/07/24 | 2025/07/24 | CARTAMUNDI SERVICES NV | 28 |
| N/236538 | 2025/07/24 | 2025/07/24 | TOPPAN Holdings Inc. | 07 |
| N/236543 | 2025/07/24 | 2025/07/24 | TOPPAN Holdings Inc. | 42 |
| N/236545 | 2025/07/24 | 2025/07/24 | COOPERATION PHARMACEUTIQUE FRANCAISE en abrégé COOPER | 05 |
| N/236546 | 2025/07/24 | 2025/07/24 | COOPERATION PHARMACEUTIQUE FRANCAISE en abrégé COOPER | 05 |
| N/236547 | 2025/07/24 | 2025/07/24 | Ä˰T±±ªÑ¦³¤½¥q TENCENT HOLDINGS LIMITED |
09 |
| N/236548 | 2025/07/24 | 2025/07/24 | Ä˰T±±ªÑ¦³¤½¥q TENCENT HOLDINGS LIMITED |
41 |
| N/236549 | 2025/07/24 | 2025/07/24 | Ä˰T±±ªÑ¦³¤½¥q TENCENT HOLDINGS LIMITED |
42 |
| N/236550 | 2025/07/24 | 2025/07/24 | ²Î®õ¹ê·~¶°¹Î¡]¿Dªù¡^ÃÄ·~¦³¤½¥q | 05 |
| N/236551 | 2025/07/24 | 2025/07/24 | ²Î®õ¹ê·~¶°¹Î¡]¿Dªù¡^ÃÄ·~¦³¤½¥q | 32 |
| N/236552 | 2025/07/24 | 2025/07/24 | ²Î®õ¹ê·~¶°¹Î¡]¿Dªù¡^ÃÄ·~¦³¤½¥q | 35 |
| N/236553 | 2025/07/24 | 2025/07/24 | ²Î®õ¹ê·~¶°¹Î¡]¿Dªù¡^ÃÄ·~¦³¤½¥q | 32 |
| N/236554 | 2025/07/24 | 2025/07/24 | ²Î®õ¹ê·~¶°¹Î¡]¿Dªù¡^ÃÄ·~¦³¤½¥q | 32 |
| N/236555 | 2025/07/24 | 2025/07/24 | ²Î®õ¹ê·~¶°¹Î¡]¿Dªù¡^ÃÄ·~¦³¤½¥q | 32 |
| N/236556 | 2025/07/24 | 2025/07/24 | ²Î®õ¹ê·~¶°¹Î¡]¿Dªù¡^ÃÄ·~¦³¤½¥q | 05 |
| N/236557 | 2025/07/24 | 2025/07/24 | ²Î®õ¹ê·~¶°¹Î¡]¿Dªù¡^ÃÄ·~¦³¤½¥q | 32 |
| N/236558 | 2025/07/24 | 2025/07/24 | ²Î®õ¹ê·~¶°¹Î¡]¿Dªù¡^ÃÄ·~¦³¤½¥q | 35 |
| N/236561 | 2025/07/24 | 2025/07/24 | ²Î®õ¹ê·~¶°¹Î¡]¿Dªù¡^ÃÄ·~¦³¤½¥q | 32 |
| N/236562 | 2025/07/24 | 2025/07/24 | ²Î®õ¹ê·~¶°¹Î¡]¿Dªù¡^ÃÄ·~¦³¤½¥q | 05 |
| N/236563 | 2025/07/24 | 2025/07/24 | ²Î®õ¹ê·~¶°¹Î¡]¿Dªù¡^ÃÄ·~¦³¤½¥q | 32 |
| N/236564 | 2025/07/24 | 2025/07/24 | ²Î®õ¹ê·~¶°¹Î¡]¿Dªù¡^ÃÄ·~¦³¤½¥q | 35 |
| N/236566 | 2025/07/24 | 2025/07/24 | Yoshida & Co., Ltd. | 18 |
| N/236567 | 2025/07/24 | 2025/07/24 | Yoshida & Co., Ltd. | 25 |
| N/236568 | 2025/07/24 | 2025/07/24 | ¼sªF¥ìµÜ¯S¹q¾¹¦³¤½¥q | 07 |
| N/236569 | 2025/07/24 | 2025/07/24 | ¼sªF¥ìµÜ¯S¹q¾¹¦³¤½¥q | 11 |
| N/236570 | 2025/07/24 | 2025/07/24 | ¼sªF¥ìµÜ¯S¹q¾¹¦³¤½¥q | 35 |
| N/236571 | 2025/07/24 | 2025/07/24 | Galaxy Entertainment Licensing Limited | 43 |
| N/236572 | 2025/07/24 | 2025/07/24 | ¼Ú½n§g AO WAI KUAN |
30 |
| N/236574 | 2025/07/24 | 2025/07/24 | ±ç°¶强 LEONG WAI KEONG |
32 |
| N/236575 | 2025/07/24 | 2025/07/24 | ¤½±Ð¤¤¤ßºÞ²z¦³¤½¥q | 43 |
| N/236576 | 2025/07/24 | 2025/07/24 | ¤½±Ð¤¤¤ßºÞ²z¦³¤½¥q | 43 |
| N/236578 | 2025/07/24 | 2025/07/24 | ¤T®ú±±ªÑªÑ¥÷¦³¤½¥q MIURA HOLDINGS Co., Ltd |
21 |
| N/236579 | 2025/07/24 | 2025/07/24 | ¤T®ú±±ªÑªÑ¥÷¦³¤½¥q MIURA HOLDINGS Co., Ltd |
25 |
| N/236580 | 2025/07/24 | 2025/07/24 | ¦Ê¤O¶°¹Î¦³¤½¥q COMPANHIA BAI LI GRUPO LDA. |
33 |
| N/236581 | 2025/07/24 | 2025/07/24 | ·s°¶¯E¶i¥X¤f¶T©ö¦³¤½¥q COMPANHIA DE COMÉRCIO DE IMPORTAÇÃO E EXPORTAÇÃO SWH, LIMITADA |
33 |
| N/236583 | 2025/07/24 | 2025/07/24 | ¶l¹q§½ | 09 |
| N/236584 | 2025/07/24 | 2025/07/24 | ¶l¹q§½ | 16 |
| N/236585 | 2025/07/24 | 2025/07/24 | ¶l¹q§½ | 35 |
| N/236586 | 2025/07/24 | 2025/07/24 | ¶l¹q§½ | 41 |
| N/236587 | 2025/07/24 | 2025/07/24 | ¶l¹q§½ | 43 |
| N/236588 | 2025/07/24 | 2025/07/24 | ¶l¹q§½ | 09 |
| N/236589 | 2025/07/24 | 2025/07/24 | ¶l¹q§½ | 16 |
| N/236590 | 2025/07/24 | 2025/07/24 | ¶l¹q§½ | 35 |
| N/236591 | 2025/07/24 | 2025/07/24 | ¶l¹q§½ | 41 |
| N/236592 | 2025/07/24 | 2025/07/24 | ¶l¹q§½ | 09 |
| N/236593 | 2025/07/24 | 2025/07/24 | ¶l¹q§½ | 14 |
| N/236594 | 2025/07/24 | 2025/07/24 | ¶l¹q§½ | 16 |
| N/236595 | 2025/07/24 | 2025/07/24 | ¶l¹q§½ | 21 |
| N/236596 | 2025/07/24 | 2025/07/24 | ¶l¹q§½ | 35 |
| N/236597 | 2025/07/24 | 2025/07/24 | ¶l¹q§½ | 41 |
| N/236598 | 2025/07/24 | 2025/07/24 | ¶l¹q§½ | 09 |
| N/236599 | 2025/07/24 | 2025/07/24 | ¶l¹q§½ | 16 |
| N/236600 | 2025/07/24 | 2025/07/24 | ¶l¹q§½ | 35 |
| N/236601 | 2025/07/24 | 2025/07/24 | ¶l¹q§½ | 06 |
| N/236602 | 2025/07/24 | 2025/07/24 | ¶l¹q§½ | 09 |
| N/236603 | 2025/07/24 | 2025/07/24 | ¶l¹q§½ | 14 |
| N/236604 | 2025/07/24 | 2025/07/24 | ¶l¹q§½ | 16 |
| N/236605 | 2025/07/24 | 2025/07/24 | ¶l¹q§½ | 18 |
| N/236606 | 2025/07/24 | 2025/07/24 | ¶l¹q§½ | 21 |
| N/236607 | 2025/07/24 | 2025/07/24 | ¶l¹q§½ | 22 |
| N/236608 | 2025/07/24 | 2025/07/24 | ¶l¹q§½ | 25 |
| N/236609 | 2025/07/24 | 2025/07/24 | ¶l¹q§½ | 41 |
| N/236610 | 2025/07/24 | 2025/07/24 | ¶l¹q§½ | 09 |
| N/236611 | 2025/07/24 | 2025/07/24 | ¶l¹q§½ | 16 |
| N/236612 | 2025/07/24 | 2025/07/24 | ¶l¹q§½ | 18 |
| N/236613 | 2025/07/24 | 2025/07/24 | ¶l¹q§½ | 35 |
| N/236614 | 2025/07/24 | 2025/07/24 | ¶l¹q§½ | 06 |
| N/236615 | 2025/07/24 | 2025/07/24 | ¶l¹q§½ | 09 |
| N/236616 | 2025/07/24 | 2025/07/24 | ¶l¹q§½ | 14 |
| N/236617 | 2025/07/24 | 2025/07/24 | ¶l¹q§½ | 16 |
| N/236618 | 2025/07/24 | 2025/07/24 | ¶l¹q§½ | 35 |
| N/236619 | 2025/07/24 | 2025/07/24 | ¶l¹q§½ | 41 |
| N/236620 | 2025/07/24 | 2025/07/24 | ¤¸·³±±ªÑ¦³¤½¥q | 05 |
| N/236621 | 2025/07/24 | 2025/07/24 | ¤¸·³±±ªÑ¦³¤½¥q | 30 |
| N/236622 | 2025/07/24 | 2025/07/24 | ³ß°Ò®³ÂåÀø¥Î«~¡]¿Dªù¡^¦³¤½¥q | 10 |
| N/236623 | 2025/07/24 | 2025/07/24 | ³ß°Ò®³ÂåÀø¥Î«~¡]¿Dªù¡^¦³¤½¥q | 10 |
| N/236624 | 2025/07/24 | 2025/07/24 | Ä˰T±±ªÑ¦³¤½¥q TENCENT HOLDINGS LIMITED |
09 |
| N/236625 | 2025/07/24 | 2025/07/24 | Ä˰T±±ªÑ¦³¤½¥q TENCENT HOLDINGS LIMITED |
35 |
| N/236626 | 2025/07/24 | 2025/07/24 | Ä˰T±±ªÑ¦³¤½¥q TENCENT HOLDINGS LIMITED |
38 |
| N/236627 | 2025/07/24 | 2025/07/24 | Ä˰T±±ªÑ¦³¤½¥q TENCENT HOLDINGS LIMITED |
41 |
| N/236628 | 2025/07/24 | 2025/07/24 | Ä˰T±±ªÑ¦³¤½¥q TENCENT HOLDINGS LIMITED |
42 |
| N/236629 | 2025/07/24 | 2025/07/24 | Ä˰T±±ªÑ¦³¤½¥q TENCENT HOLDINGS LIMITED |
45 |
| N/236630 | 2025/07/24 | 2025/07/24 | Ä˰T±±ªÑ¦³¤½¥q TENCENT HOLDINGS LIMITED |
09 |
| N/236631 | 2025/07/24 | 2025/07/24 | Ä˰T±±ªÑ¦³¤½¥q TENCENT HOLDINGS LIMITED |
35 |
| N/236632 | 2025/07/24 | 2025/07/24 | Ä˰T±±ªÑ¦³¤½¥q TENCENT HOLDINGS LIMITED |
38 |
| N/236633 | 2025/07/24 | 2025/07/24 | Ä˰T±±ªÑ¦³¤½¥q TENCENT HOLDINGS LIMITED |
41 |
| N/236634 | 2025/07/24 | 2025/07/24 | Ä˰T±±ªÑ¦³¤½¥q TENCENT HOLDINGS LIMITED |
42 |
| N/236635 | 2025/07/24 | 2025/07/24 | Ä˰T±±ªÑ¦³¤½¥q TENCENT HOLDINGS LIMITED |
45 |
| N/236636 | 2025/07/24 | 2025/07/24 | Ä˰T±±ªÑ¦³¤½¥q TENCENT HOLDINGS LIMITED |
09 |
| N/236637 | 2025/07/24 | 2025/07/24 | Ä˰T±±ªÑ¦³¤½¥q TENCENT HOLDINGS LIMITED |
35 |
| N/236638 | 2025/07/24 | 2025/07/24 | Ä˰T±±ªÑ¦³¤½¥q TENCENT HOLDINGS LIMITED |
38 |
| N/236639 | 2025/07/24 | 2025/07/24 | Ä˰T±±ªÑ¦³¤½¥q TENCENT HOLDINGS LIMITED |
41 |
| N/236640 | 2025/07/24 | 2025/07/24 | Ä˰T±±ªÑ¦³¤½¥q TENCENT HOLDINGS LIMITED |
42 |
| N/236641 | 2025/07/24 | 2025/07/24 | Ä˰T±±ªÑ¦³¤½¥q TENCENT HOLDINGS LIMITED |
45 |
| N/236642 | 2025/07/24 | 2025/07/24 | Ä˰T±±ªÑ¦³¤½¥q TENCENT HOLDINGS LIMITED |
09 |
| N/236643 | 2025/07/24 | 2025/07/24 | Ä˰T±±ªÑ¦³¤½¥q TENCENT HOLDINGS LIMITED |
35 |
| N/236644 | 2025/07/24 | 2025/07/24 | Ä˰T±±ªÑ¦³¤½¥q TENCENT HOLDINGS LIMITED |
38 |
| N/236645 | 2025/07/24 | 2025/07/24 | Ä˰T±±ªÑ¦³¤½¥q TENCENT HOLDINGS LIMITED |
41 |
| N/236646 | 2025/07/24 | 2025/07/24 | Ä˰T±±ªÑ¦³¤½¥q TENCENT HOLDINGS LIMITED |
42 |
| N/236647 | 2025/07/24 | 2025/07/24 | Ä˰T±±ªÑ¦³¤½¥q TENCENT HOLDINGS LIMITED |
45 |
| N/236648 | 2025/07/24 | 2025/07/24 | Ä˰T±±ªÑ¦³¤½¥q TENCENT HOLDINGS LIMITED |
09 |
| N/236649 | 2025/07/24 | 2025/07/24 | Ä˰T±±ªÑ¦³¤½¥q TENCENT HOLDINGS LIMITED |
35 |
| N/236650 | 2025/07/24 | 2025/07/24 | Ä˰T±±ªÑ¦³¤½¥q TENCENT HOLDINGS LIMITED |
38 |
| N/236651 | 2025/07/24 | 2025/07/24 | Ä˰T±±ªÑ¦³¤½¥q TENCENT HOLDINGS LIMITED |
41 |
| N/236652 | 2025/07/24 | 2025/07/24 | Ä˰T±±ªÑ¦³¤½¥q TENCENT HOLDINGS LIMITED |
42 |
| N/236653 | 2025/07/24 | 2025/07/24 | Ä˰T±±ªÑ¦³¤½¥q TENCENT HOLDINGS LIMITED |
45 |
| N/236658 | 2025/07/24 | 2025/07/24 | ¤ñµo°øµØ±±ªÑ¶°¹Î¦³¤½¥q PISA LUXURY HOLDING GROUP LIMITED |
25 |
| N/236659 | 2025/07/24 | 2025/07/24 | ¤ñµo°øµØ±±ªÑ¶°¹Î¦³¤½¥q PISA LUXURY HOLDING GROUP LIMITED |
35 |
| N/236660 | 2025/07/24 | 2025/07/24 | ¬ü´Ë¦³¤½¥q MAYSUM LIMITED |
43 |
| N/236662 | 2025/07/24 | 2025/07/24 | East Ocean Seafood Restaurant (Realty) Limited | 35 |
| N/236663 | 2025/07/24 | 2025/07/24 | ¦A¹©ÂåÃÄ¡]¤W®ü¡^¦³¤½¥q | 05 |
| N/236664 | 2025/07/24 | 2025/07/24 | ´f¦{¥«¦è¹y¤u·~µo®i¦³¤½¥q | 11 |
| N/236665 | 2025/07/24 | 2025/07/24 | HANJIN KAL Corp. | 39 |
| N/236666 | 2025/07/24 | 2025/07/24 | HANJIN KAL Corp. | 39 |
| N/236667 | 2025/07/24 | 2025/07/24 | ·sÃÀ»¨¤å¤ÆÅU°Ý¦³¤½¥q | 35 |
| N/236668 | 2025/07/24 | 2025/07/24 | ·sÃÀ»¨¤å¤ÆÅU°Ý¦³¤½¥q | 35 |
| N/236669 | 2025/07/24 | 2025/07/24 | ·sÃÀ»¨¤å¤ÆÅU°Ý¦³¤½¥q | 35 |
| N/236670 | 2025/07/24 | 2025/07/24 | ¹J¨£¤pÄѰê»Ú±±ªÑ¦³¤½¥q Xiao Noodles International Holdings Limited |
30 |
| N/236671 | 2025/07/24 | 2025/07/24 | ¹J¨£¤pÄѰê»Ú±±ªÑ¦³¤½¥q Xiao Noodles International Holdings Limited |
35 |
| N/236672 | 2025/07/24 | 2025/07/24 | ¹J¨£¤pÄѰê»Ú±±ªÑ¦³¤½¥q Xiao Noodles International Holdings Limited |
43 |
| N/236676 | 2025/07/24 | 2025/07/24 | ´Â¤é¶¼®Æ®è¦¡·|ªÀ Asahi Soft Drinks Co., Ltd. |
33 |
| N/236680 | 2025/07/24 | 2025/07/24 | ´Â¤é¶¼®Æ®è¦¡·|ªÀ Asahi Soft Drinks Co., Ltd. |
33 |
| N/236684 | 2025/07/24 | 2025/07/24 | ´Â¤é¶¼®Æ®è¦¡·|ªÀ Asahi Soft Drinks Co., Ltd. |
33 |
| N/236686 | 2025/07/24 | 2025/07/24 | ¼Æ¾Ç«äºû±Ð¨|¦³¤½¥q MATHCONCEPT EDUCATION LIMITED |
41 |
| N/236713 | 2025/07/24 | 2025/07/24 | ¯Î¤å¼y IONG MAN HENG |
30 |
| N/236714 | 2025/07/24 | 2025/07/24 | POLA CHEMICAL INDUSTRIES, INC. | 01 |
| N/236715 | 2025/07/24 | 2025/07/24 | POLA CHEMICAL INDUSTRIES, INC. | 03 |
| N/236716 | 2025/07/24 | 2025/07/24 | Â@³Ó«Ø§÷¦³¤½¥q | 37 |
| N/236719 | 2025/07/24 | 2025/07/24 | µØ¬°§Þ³N¦³¤½¥q Huawei Technologies Co., Ltd. |
35 |
| N/236720 | 2025/07/24 | 2025/07/24 | ¹z´É | 25 |
| N/236721 | 2025/07/24 | 2025/07/24 | ªF²ð¥«¦Ñ¶º©±¦³¤½¥q | 43 |
| N/236724 | 2025/07/24 | 2025/07/24 | ¤¤°ê¦X²±¤¸¤j°·±d²£·~¦³¤½¥q CHINA HE SHENG YUAN GREAT HEALTH INDUSTRY LIMITED |
05 |
| N/236726 | 2025/07/24 | 2025/07/24 | ¼s¦{¥«¥]¹DÀ\¶¼ºÞ²zªA°È¦³¤½¥q | 30 |
| N/236739 | 2025/07/24 | 2025/07/24 | VITA GREEN HEALTH PRODUCTS COMPANY LIMITED | 10 |
| N/236740 | 2025/07/24 | 2025/07/24 | VITA GREEN HEALTH PRODUCTS COMPANY LIMITED | 21 |
| N/236761 | 2025/07/24 | 2025/07/24 | ¥[´P¶T©ö¦³¤½¥q | 03 |
| N/236762 | 2025/07/24 | 2025/07/24 | ©¾¸ÛÃĩЦ³¤½¥q | 30 |
| N/236763 | 2025/07/24 | 2025/07/24 | ©¾¸ÛÃĩЦ³¤½¥q | 30 |
| N/236764 | 2025/07/24 | 2025/07/24 | HANJIN KAL Corp. | 39 |
| N/236765 | 2025/07/24 | 2025/07/24 | HANJIN KAL Corp. | 39 |
| N/236766 | 2025/07/24 | 2025/07/24 | HANJIN KAL Corp. | 39 |
| N/236767 | 2025/07/24 | 2025/07/24 | HANJIN KAL Corp. | 39 |
| N/236771 | 2025/07/24 | 2025/07/24 | »ÊÂE·½¶T©ö¡]¯]®ü¡^¦³¤½¥q Minghongyuan Trading (Zhuhai) Limited Company |
03 |
| N/236772 | 2025/07/24 | 2025/07/24 | ªF²ð¥«µØ¬ü¹«~¦³¤½¥q Dongguan Huamei Food Co., Ltd. |
30 |
| N/236773 | 2025/07/24 | 2025/07/24 | Argenx B.V. | 05 |
| N/236774 | 2025/07/24 | 2025/07/24 | Argenx B.V. | 35 |
| N/236775 | 2025/07/24 | 2025/07/24 | Argenx B.V. | 42 |
| N/236776 | 2025/07/24 | 2025/07/24 | Argenx B.V. | 44 |
| N/236783 | 2025/07/24 | 2025/07/24 | Abercrombie & Fitch Europe Sagl | 25 |
| N/236785 | 2025/07/24 | 2025/07/24 | Abercrombie & Fitch Europe Sagl | 25 |
| N/236789 | 2025/07/24 | 2025/07/24 | õ»´ä¦³¤½¥q CHIT HONG KONG LIMITED |
33 |
| N/236790 | 2025/07/24 | 2025/07/24 | õ»´ä¦³¤½¥q CHIT HONG KONG LIMITED |
35 |
| N/236791 | 2025/07/24 | 2025/07/24 | ¦wºÖ¿¤®ü¯à¹ê·~ªÑ¥÷¦³¤½¥q | 07 |
| N/236792 | 2025/07/24 | 2025/07/24 | ¦wºÖ¿¤®ü¯à¹ê·~ªÑ¥÷¦³¤½¥q | 09 |
| N/236793 | 2025/07/24 | 2025/07/24 | ¦wºÖ¿¤®ü¯à¹ê·~ªÑ¥÷¦³¤½¥q | 11 |
| N/236794 | 2025/07/24 | 2025/07/24 | ¦wºÖ¿¤®ü¯à¹ê·~ªÑ¥÷¦³¤½¥q | 21 |
| N/236795 | 2025/07/24 | 2025/07/24 | §õµúµY ISMAILOVA ELMIRA |
43 |
| N/236796 | 2025/07/24 | 2025/07/24 | ¨äµ`¤å¤Æ³Ð·N¤@¤H¦³¤½¥q | 28 |
| N/236797 | 2025/07/24 | 2025/07/24 | ¼w¤Æ¤ë°O窑³³²¡¦³³d¥ô¤½¥q Dehua Yueji Kiln Porcelain Company Limited |
21 |
| N/236798 | 2025/07/24 | 2025/07/24 | ªC¦{®ö¼á¥Íª«¬ì§Þ¦³¤½¥q | 03 |
| N/236799 | 2025/07/24 | 2025/07/24 | «C®q«D¤ñ´M¹q¤l°Ó°È¦³¤½¥q | 25 |
| N/236800 | 2025/07/24 | 2025/07/24 | Ãú¼v¤u§@«Ç¦³¤½¥q Hazelight Studios AB |
09 |
| N/236801 | 2025/07/24 | 2025/07/24 | Ãú¼v¤u§@«Ç¦³¤½¥q Hazelight Studios AB |
35 |
| N/236802 | 2025/07/24 | 2025/07/24 | Ãú¼v¤u§@«Ç¦³¤½¥q Hazelight Studios AB |
41 |
| N/236803 | 2025/07/24 | 2025/07/24 | Ãú¼v¤u§@«Ç¦³¤½¥q Hazelight Studios AB |
42 |
| N/236804 | 2025/07/24 | 2025/07/24 | «C®q¥K¾í¼Æ¦r§Þ³N¦³¤½¥q | 25 |
| N/236805 | 2025/07/24 | 2025/07/24 | Ãú¼v¤u§@«Ç¦³¤½¥q Hazelight Studios AB |
09 |
| N/236806 | 2025/07/24 | 2025/07/24 | Ãú¼v¤u§@«Ç¦³¤½¥q Hazelight Studios AB |
35 |
| N/236807 | 2025/07/24 | 2025/07/24 | Ãú¼v¤u§@«Ç¦³¤½¥q Hazelight Studios AB |
41 |
| N/236808 | 2025/07/24 | 2025/07/24 | Ãú¼v¤u§@«Ç¦³¤½¥q Hazelight Studios AB |
42 |
| N/236810 | 2025/07/24 | 2025/07/24 | èp¹©ª«¬y¤¤¿D¹B¿é¦³¤½¥q | 39 |
| N/236818 | 2025/07/24 | 2025/07/24 | ÂI¤l©@°Ø¶°¹Î¦³¤½¥q | 43 |
| N/236821 | 2025/07/24 | 2025/07/24 | Galaxy Entertainment Licensing Limited | 41 |
| N/236822 | 2025/07/24 | 2025/07/24 | Galaxy Entertainment Licensing Limited | 41 |
| N/236824 | 2025/07/24 | 2025/07/24 | H World Holdings Singapore Pte. Ltd. | 35 |
| N/236825 | 2025/07/24 | 2025/07/24 | H World Holdings Singapore Pte. Ltd. | 43 |
| N/236828 | 2025/07/24 | 2025/07/24 | H World Holdings Singapore Pte. Ltd. | 35 |
| N/236829 | 2025/07/24 | 2025/07/24 | H World Holdings Singapore Pte. Ltd. | 43 |
| N/236830 | 2025/07/24 | 2025/07/24 | H World Holdings Singapore Pte. Ltd. | 35 |
| N/236831 | 2025/07/24 | 2025/07/24 | H World Holdings Singapore Pte. Ltd. | 43 |
| N/236832 | 2025/07/24 | 2025/07/24 | H World Holdings Singapore Pte. Ltd. | 35 |
| N/236833 | 2025/07/24 | 2025/07/24 | H World Holdings Singapore Pte. Ltd. | 43 |
| N/236834 | 2025/07/24 | 2025/07/24 | H World Holdings Singapore Pte. Ltd. | 35 |
| N/236835 | 2025/07/24 | 2025/07/24 | H World Holdings Singapore Pte. Ltd. | 43 |
| N/236837 | 2025/07/24 | 2025/07/24 | DOPAT, SA | 25 |
| N/236838 | 2025/07/24 | 2025/07/24 | DOPAT, SA | 35 |
| N/236848 | 2025/07/24 | 2025/07/24 | ¶¾§µØ FONG IOK WA |
29 |
| N/236850 | 2025/07/24 | 2025/07/24 | ¶¾§µØ FONG IOK WA |
43 |
| N/236851 | 2025/07/24 | 2025/07/24 | ¶¾§µØ FONG IOK WA |
29 |
| N/236853 | 2025/07/24 | 2025/07/24 | ¶¾§µØ FONG IOK WA |
43 |
| N/236854 | 2025/07/24 | 2025/07/24 | ¶¾§µØ FONG IOK WA |
29 |
| N/236856 | 2025/07/24 | 2025/07/24 | ¶¾§µØ FONG IOK WA |
43 |
| N/236857 | 2025/07/24 | 2025/07/24 | Aristocrat Technologies Australia Pty Ltd | 28 |
| N/236858 | 2025/07/24 | 2025/07/24 | Aristocrat Technologies Australia Pty Ltd | 28 |
| N/236859 | 2025/07/24 | 2025/07/24 | Aristocrat Technologies Australia Pty Ltd | 28 |
| N/236862 | 2025/07/24 | 2025/07/24 | Cathay Pacific Airways Limited | 39 |
| N/236863 | 2025/07/24 | 2025/07/24 | Cathay Pacific Airways Limited | 41 |
| N/236865 | 2025/07/24 | 2025/07/24 | Cathay Pacific Airways Limited | 44 |
| N/236868 | 2025/07/24 | 2025/07/24 | Cathay Pacific Airways Limited | 39 |
| N/236869 | 2025/07/24 | 2025/07/24 | Cathay Pacific Airways Limited | 41 |
| N/236871 | 2025/07/24 | 2025/07/24 | Cathay Pacific Airways Limited | 44 |
| N/236882 | 2025/07/24 | 2025/07/24 | ¼s¦{Àu¶H¤å¤Æ¥Î«~¦³¤½¥q Guangzhou Youxiang Cultural Supplies Co.,Ltd. |
11 |
| N/236883 | 2025/07/24 | 2025/07/24 | ¼s¦{Àu¶H¤å¤Æ¥Î«~¦³¤½¥q Guangzhou Youxiang Cultural Supplies Co.,Ltd. |
14 |
| N/236884 | 2025/07/24 | 2025/07/24 | ¼s¦{Àu¶H¤å¤Æ¥Î«~¦³¤½¥q Guangzhou Youxiang Cultural Supplies Co.,Ltd. |
20 |
| N/236889 | 2025/07/24 | 2025/07/24 | ¤é°·¥ø·~¦³¤½¥q J. Health Enterprise Limited |
05 |
| N/236890 | 2025/07/24 | 2025/07/24 | ¤é°·¥ø·~¦³¤½¥q J. Health Enterprise Limited |
35 |
| N/236891 | 2025/07/24 | 2025/07/24 | ¤é°·¥ø·~¦³¤½¥q J. Health Enterprise Limited |
05 |
| N/236892 | 2025/07/24 | 2025/07/24 | ¤é°·¥ø·~¦³¤½¥q J. Health Enterprise Limited |
35 |
| N/236894 | 2025/07/24 | 2025/07/24 | ·çµM±d¦³¤½¥q Evergreen Health Limited |
35 |
| N/236896 | 2025/07/24 | 2025/07/24 | ·çµM±d¦³¤½¥q Evergreen Health Limited |
35 |
| N/236898 | 2025/07/24 | 2025/07/24 | ±d·ù¦³¤½¥q Concord Alliance Limited |
35 |
| N/236901 | 2025/07/24 | 2025/07/24 | ¦h¦Ì¡]»´ä¡^¦³¤½¥q Domi (Hong Kong) Limited |
09 |
| N/236902 | 2025/07/24 | 2025/07/24 | ¦h¦Ì¡]»´ä¡^¦³¤½¥q Domi (Hong Kong) Limited |
35 |
| N/236903 | 2025/07/24 | 2025/07/24 | ¦h¦Ì¡]»´ä¡^¦³¤½¥q Domi (Hong Kong) Limited |
42 |
| N/236904 | 2025/07/24 | 2025/07/24 | ¦h¦Ì¡]»´ä¡^¦³¤½¥q Domi (Hong Kong) Limited |
09 |
| N/236905 | 2025/07/24 | 2025/07/24 | ¦h¦Ì¡]»´ä¡^¦³¤½¥q Domi (Hong Kong) Limited |
35 |
| N/236906 | 2025/07/24 | 2025/07/24 | ¦h¦Ì¡]»´ä¡^¦³¤½¥q Domi (Hong Kong) Limited |
42 |
| N/236907 | 2025/07/24 | 2025/07/24 | ¦h¦Ì¡]»´ä¡^¦³¤½¥q Domi (Hong Kong) Limited |
09 |
| N/236908 | 2025/07/24 | 2025/07/24 | ¦h¦Ì¡]»´ä¡^¦³¤½¥q Domi (Hong Kong) Limited |
35 |
| N/236909 | 2025/07/24 | 2025/07/24 | ¦h¦Ì¡]»´ä¡^¦³¤½¥q Domi (Hong Kong) Limited |
42 |
| N/236910 | 2025/07/24 | 2025/07/24 | ºaÄ£²×ºÝªÑ¥÷¦³¤½¥q Honor Device Co., Ltd. |
09 |
| N/236911 | 2025/07/24 | 2025/07/24 | ¥_¨Ê¥ÛÀY¥@¬ö¬ì§ÞªÑ¥÷¦³¤½¥q | 07 |
| N/236912 | 2025/07/24 | 2025/07/24 | ¥_¨Ê¥ÛÀY¥@¬ö¬ì§ÞªÑ¥÷¦³¤½¥q | 09 |
| N/236913 | 2025/07/24 | 2025/07/24 | ÄÁ¤åÀé Zhong Wencan |
25 |
| N/236914 | 2025/07/24 | 2025/07/24 | ¸UÀ°¼Æ¦r¯à·½ªÑ¥÷¦³¤½¥q ¸UÀ°¬P¬P¥R¹q¬ì§Þ¦³¤½¥q |
40 |
| N/236915 | 2025/07/24 | 2025/07/24 | ¿Õªù¹êÅç«Ç¦³¤½¥q LABORATORIOS NORMON, S.A. |
03 |
| N/236916 | 2025/07/24 | 2025/07/24 | ¿Õªù¹êÅç«Ç¦³¤½¥q LABORATORIOS NORMON, S.A. |
05 |
| N/236917 | 2025/07/24 | 2025/07/24 | ¿Õªù¹êÅç«Ç¦³¤½¥q LABORATORIOS NORMON, S.A. |
10 |
| N/236928 | 2025/07/24 | 2025/07/24 | ®ý¦¿¦N§Q±±ªÑ¶°¹Î¦³¤½¥q ZHEJIANG GEELY HOLDING GROUP CO., LTD. |
12 |
| N/236929 | 2025/07/24 | 2025/07/24 | MOON¥X¤J¤f¶T©ö¤@¤H¦³¤½¥q | 25 |
| N/236930 | 2025/07/24 | 2025/07/24 | ¦w´¼¥Íª«¬ì§Þ¦³¤½¥q AD BIO MEDICAL LIMTED |
44 |
| N/236931 | 2025/07/24 | 2025/07/24 | Ä_°aÀ\¶¼ºÞ²z¤@¤H¦³¤½¥q | 43 |
| N/236932 | 2025/07/24 | 2025/07/24 | Ä_°aÀ\¶¼ºÞ²z¤@¤H¦³¤½¥q | 43 |
| N/236933 | 2025/07/24 | 2025/07/24 | MOON¥X¤J¤f¶T©ö¤@¤H¦³¤½¥q | 03 |
| N/236934 | 2025/07/24 | 2025/07/24 | MOON¥X¤J¤f¶T©ö¤@¤H¦³¤½¥q | 14 |
| N/236935 | 2025/07/24 | 2025/07/24 | MOON¥X¤J¤f¶T©ö¤@¤H¦³¤½¥q | 25 |
| N/236936 | 2025/07/24 | 2025/07/24 | ©_·ç¨T¨®ªÑ¥÷¦³¤½¥q | 12 |
| N/236937 | 2025/07/24 | 2025/07/24 | ©_·ç¨T¨®ªÑ¥÷¦³¤½¥q | 37 |
| N/236938 | 2025/07/24 | 2025/07/24 | ©_·ç¨T¨®ªÑ¥÷¦³¤½¥q | 12 |
| N/236939 | 2025/07/24 | 2025/07/24 | MOON¥X¤J¤f¶T©ö¤@¤H¦³¤½¥q | 14 |
| N/236944 | 2025/07/24 | 2025/07/24 | ¯Î¤å¼y IONG MAN HENG |
30 |
| N/236947 | 2025/07/24 | 2025/07/24 | «¼yªø¦w¨T¨®ªÑ¥÷¦³¤½¥q CHONGQING CHANGAN AUTOMOBILE CO., LTD. |
12 |
| N/236948 | 2025/07/24 | 2025/07/24 | «¼yªø¦w¨T¨®ªÑ¥÷¦³¤½¥q CHONGQING CHANGAN AUTOMOBILE CO., LTD. |
12 |
| N/236949 | 2025/07/24 | 2025/07/24 | §f±Ó | 05 |
| N/236950 | 2025/07/24 | 2025/07/24 | ¥_¨Ê¥ÛÀY¥@¬ö¬ì§ÞªÑ¥÷¦³¤½¥q | 07 |
| N/236951 | 2025/07/24 | 2025/07/24 | ¥_¨Ê¥ÛÀY¥@¬ö¬ì§ÞªÑ¥÷¦³¤½¥q | 11 |
| N/236960 | 2025/07/24 | 2025/07/24 | Akzo Nobel Coatings International B.V. | 02 |
| N/236961 | 2025/07/24 | 2025/07/24 | ¿Dªù¸Û¼w°ê»Ú¦³¤½¥q | 32 |
| N/236962 | 2025/07/24 | 2025/07/24 | ¼s¦{¶ø·ç¹q¤l°Ó°È¦³¤½¥q GUANGZHOU AORUI E-COMMERCE CO., LTD |
03 |
| N/236963 | 2025/07/24 | 2025/07/24 | ¼s¦{¶ø·ç¹q¤l°Ó°È¦³¤½¥q GUANGZHOU AORUI E-COMMERCE CO., LTD |
35 |
| N/236964 | 2025/07/24 | 2025/07/24 | ¥_¨Ê«H«h¹F¬ì§Þ¦³¤½¥q Beijing Xinzeda Technology Co., Ltd. |
09 |
| N/236965 | 2025/07/24 | 2025/07/24 | ©u°¶ªF Ji Weidong |
29 |
| N/236966 | 2025/07/24 | 2025/07/24 | ¤W®üÁâ¹\Õ߬ö¬ì§Þ¦³¤½¥q Shanghai Magnesium Uranium Krypton Technology Co., Ltd. |
35 |
| N/236967 | 2025/07/24 | 2025/07/24 | ±ç¤êªL | 12 |
| N/236968 | 2025/07/24 | 2025/07/24 | ªLÄR¼ü LAM LAI IENG |
04 |
| N/236970 | 2025/07/24 | 2025/07/24 | 菓¤l¼ô¤F¡]«n¨Ê¡^¹«~¦³¤½¥q Ripe Fruit (Nanjing) Food Inc. |
32 |
| N/236971 | 2025/07/24 | 2025/07/24 | ºß¬PÃÄ·~¬ì§Þ¡]¤W®ü¡^¦³¤½¥q | 05 |
| N/236973 | 2025/07/24 | 2025/07/24 | µØ¤HÃÄ·~¡]»´ä¡^¦³¤½¥q Chinese Pharmaceuticals (HK) Co., Limited |
05 |
| N/236974 | 2025/07/24 | 2025/07/24 | µØ¤HÃÄ·~¡]»´ä¡^¦³¤½¥q Chinese Pharmaceuticals (HK) Co., Limited |
05 |
| N/236975 | 2025/07/24 | 2025/07/24 | Deungchon Shabu Noodle Co. | 43 |
| N/236976 | 2025/07/24 | 2025/07/24 | ¿Õªù¹êÅç«Ç¦³¤½¥q LABORATORIOS NORMON, S.A. |
03 |
| N/236977 | 2025/07/24 | 2025/07/24 | ¿Õªù¹êÅç«Ç¦³¤½¥q LABORATORIOS NORMON, S.A. |
05 |
| N/236978 | 2025/07/24 | 2025/07/24 | ¿Õªù¹êÅç«Ç¦³¤½¥q LABORATORIOS NORMON, S.A. |
10 |
| N/236980 | 2025/07/24 | 2025/07/24 | Ferrari S.p.A. | 12 |
| N/236985 | 2025/07/24 | 2025/07/24 | ±i¬Û½÷ Zhang Xianghui |
35 |
| N/236986 | 2025/07/24 | 2025/07/24 | ¨H°ê¨} Shen Guoliang |
41 |
| N/236987 | 2025/07/24 | 2025/07/24 | ¨H°ê¨} Shen Guoliang |
41 |
| N/236988 | 2025/07/24 | 2025/07/24 | Ĭ¦{ùÚ©µ²»°ê»Ú¶T©ö¦³¤½¥q Suzhou Hengyanxiang International Trade Co., Ltd. |
29 |
| N/236989 | 2025/07/24 | 2025/07/24 | Ĭ¦{ùÚ©µ²»°ê»Ú¶T©ö¦³¤½¥q Suzhou Hengyanxiang International Trade Co., Ltd. |
35 |
| N/236990 | 2025/07/24 | 2025/07/24 | ¾GªQ±l | 30 |
| N/236991 | 2025/07/24 | 2025/07/24 | L'Oreal | 03 |
| N/236992 | 2025/07/24 | 2025/07/24 | Suntory Holdings Limited | 33 |
| N/236993 | 2025/07/24 | 2025/07/24 | Ä˰T±±ªÑ¦³¤½¥q TENCENT HOLDINGS LIMITED |
09 |
| N/236996 | 2025/07/24 | 2025/07/24 | Ä˰T±±ªÑ¦³¤½¥q TENCENT HOLDINGS LIMITED |
09 |
| N/236997 | 2025/07/24 | 2025/07/24 | Ä˰T±±ªÑ¦³¤½¥q TENCENT HOLDINGS LIMITED |
35 |
| N/236998 | 2025/07/24 | 2025/07/24 | Ä˰T±±ªÑ¦³¤½¥q TENCENT HOLDINGS LIMITED |
38 |
| N/236999 | 2025/07/24 | 2025/07/24 | Ä˰T±±ªÑ¦³¤½¥q TENCENT HOLDINGS LIMITED |
41 |
| N/237000 | 2025/07/24 | 2025/07/24 | Ä˰T±±ªÑ¦³¤½¥q TENCENT HOLDINGS LIMITED |
42 |
| N/237001 | 2025/07/24 | 2025/07/24 | Ä˰T±±ªÑ¦³¤½¥q TENCENT HOLDINGS LIMITED |
45 |
| N/237002 | 2025/07/24 | 2025/07/24 | Ä˰T±±ªÑ¦³¤½¥q TENCENT HOLDINGS LIMITED |
09 |
| N/237003 | 2025/07/24 | 2025/07/24 | Ä˰T±±ªÑ¦³¤½¥q TENCENT HOLDINGS LIMITED |
35 |
| N/237004 | 2025/07/24 | 2025/07/24 | Ä˰T±±ªÑ¦³¤½¥q TENCENT HOLDINGS LIMITED |
38 |
| N/237005 | 2025/07/24 | 2025/07/24 | Ä˰T±±ªÑ¦³¤½¥q TENCENT HOLDINGS LIMITED |
41 |
| N/237006 | 2025/07/24 | 2025/07/24 | Ä˰T±±ªÑ¦³¤½¥q TENCENT HOLDINGS LIMITED |
42 |
| N/237007 | 2025/07/24 | 2025/07/24 | Ä˰T±±ªÑ¦³¤½¥q TENCENT HOLDINGS LIMITED |
45 |
| N/237008 | 2025/07/24 | 2025/07/24 | ¿A¥Ã¦³¤½¥q | 03 |
| N/237009 | 2025/07/24 | 2025/07/24 | ¿A¥Ã¦³¤½¥q | 05 |
| N/237010 | 2025/07/24 | 2025/07/24 | ¿A¥Ã¦³¤½¥q | 30 |
| N/237011 | 2025/07/24 | 2025/07/24 | ¿A¥Ã¦³¤½¥q | 35 |
| N/237012 | 2025/07/24 | 2025/07/24 | ¿A¥Ã¦³¤½¥q | 03 |
| N/237013 | 2025/07/24 | 2025/07/24 | ¿A¥Ã¦³¤½¥q | 05 |
| N/237014 | 2025/07/24 | 2025/07/24 | ¿A¥Ã¦³¤½¥q | 30 |
| N/237015 | 2025/07/24 | 2025/07/24 | ¿A¥Ã¦³¤½¥q | 35 |
| N/237016 | 2025/07/24 | 2025/07/24 | ¿A¥Ã¦³¤½¥q | 03 |
| N/237017 | 2025/07/24 | 2025/07/24 | ¿A¥Ã¦³¤½¥q | 05 |
| N/237018 | 2025/07/24 | 2025/07/24 | ¿A¥Ã¦³¤½¥q | 30 |
| N/237019 | 2025/07/24 | 2025/07/24 | ¿A¥Ã¦³¤½¥q | 35 |
| N/237020 | 2025/07/24 | 2025/07/24 | ¿A¥Ã¦³¤½¥q | 03 |
| N/237021 | 2025/07/24 | 2025/07/24 | ¿A¥Ã¦³¤½¥q | 05 |
| N/237022 | 2025/07/24 | 2025/07/24 | ¿A¥Ã¦³¤½¥q | 30 |
| N/237023 | 2025/07/24 | 2025/07/24 | ¿A¥Ã¦³¤½¥q | 35 |
| N/237024 | 2025/07/24 | 2025/07/24 | ¿A¥Ã¦³¤½¥q | 03 |
| N/237025 | 2025/07/24 | 2025/07/24 | ¿A¥Ã¦³¤½¥q | 05 |
| N/237026 | 2025/07/24 | 2025/07/24 | ¿A¥Ã¦³¤½¥q | 30 |
| N/237027 | 2025/07/24 | 2025/07/24 | ¿A¥Ã¦³¤½¥q | 35 |
| N/237028 | 2025/07/24 | 2025/07/24 | ¿A¥Ã¦³¤½¥q | 03 |
| N/237029 | 2025/07/24 | 2025/07/24 | ¿A¥Ã¦³¤½¥q | 05 |
| N/237030 | 2025/07/24 | 2025/07/24 | ¿A¥Ã¦³¤½¥q | 30 |
| N/237031 | 2025/07/24 | 2025/07/24 | ¿A¥Ã¦³¤½¥q | 35 |
| N/237032 | 2025/07/24 | 2025/07/24 | ¬u¦{¥«¸UÅÃÅé¨|¥Î«~¦³¤½¥q | 25 |
| N/237033 | 2025/07/24 | 2025/07/24 | ¬u¦{¥«¾U¤OÅé¨|¥Î«~¦³¤½¥q | 35 |
| N/237034 | 2025/07/24 | 2025/07/24 | ¤Ñ¬z¸Uº¸¬ì§Þ¦³¤½¥q | 07 |
| N/237035 | 2025/07/24 | 2025/07/24 | ¦ã´µ´¶·ç¡]¼s¦{¡^¹«~¦³¤½¥q | 05 |
| N/237036 | 2025/07/24 | 2025/07/24 | ¦ã´µ´¶·ç¡]¼s¦{¡^¹«~¦³¤½¥q | 29 |
| N/237037 | 2025/07/24 | 2025/07/24 | ¦ã´µ´¶·ç¡]¼s¦{¡^¹«~¦³¤½¥q | 30 |
| N/237038 | 2025/07/24 | 2025/07/24 | ¦ã´µ´¶·ç¡]¼s¦{¡^¹«~¦³¤½¥q | 29 |
| N/237039 | 2025/07/24 | 2025/07/24 | ¦ã´µ´¶·ç¡]¼s¦{¡^¹«~¦³¤½¥q | 30 |
| N/237040 | 2025/07/24 | 2025/07/24 | IICOMBINED Co., Ltd. | 09 |
| N/237042 | 2025/07/24 | 2025/07/24 | IICOMBINED Co., Ltd. | 25 |
| N/237043 | 2025/07/24 | 2025/07/24 | IICOMBINED Co., Ltd. | 35 |
| N/237044 | 2025/07/24 | 2025/07/24 | IICOMBINED Co., Ltd. | 09 |
| N/237046 | 2025/07/24 | 2025/07/24 | IICOMBINED Co., Ltd. | 25 |
| N/237047 | 2025/07/24 | 2025/07/24 | IICOMBINED Co., Ltd. | 35 |
| N/237049 | 2025/07/24 | 2025/07/24 | Kabushiki Kaisha Lawson (also trading as Lawson, Inc.) | 29 |
| N/237050 | 2025/07/24 | 2025/07/24 | Kabushiki Kaisha Lawson (also trading as Lawson, Inc.) | 30 |
| N/237051 | 2025/07/24 | 2025/07/24 | Kabushiki Kaisha Lawson (also trading as Lawson, Inc.) | 31 |
| N/237052 | 2025/07/24 | 2025/07/24 | Kabushiki Kaisha Lawson (also trading as Lawson, Inc.) | 32 |
| N/237053 | 2025/07/24 | 2025/07/24 | Kabushiki Kaisha Lawson (also trading as Lawson, Inc.) | 33 |
| N/237054 | 2025/07/24 | 2025/07/24 | Kabushiki Kaisha Lawson (also trading as Lawson, Inc.) | 35 |
| N/237055 | 2025/07/24 | 2025/07/24 | Kabushiki Kaisha Lawson (also trading as Lawson, Inc.) | 43 |
| N/237056 | 2025/07/24 | 2025/07/24 | DFI International Brands Limited | 31 |
³¡¤À§åµ¹¤Î³¡¤À©Úµ´
| ½s¸¹ | N/234550¤ÎN/234551 |
| µù¥U¤é´Á | 2025/07/24 |
| §å¥Ü¤é´Á | 2025/07/24 |
| Åv§Q¤H | °ê«°ÂåÃĦ³¤½¥q |
| ¤ÀÃþ | 5 |
| ®Ú¾Ú²Ä216±ø¡Aµ²¦X²Ä214±ø²Ä2´Úa¡^¶µªº³W©w¡A©Úµ´¡§ÃĪo¡FÃĥγn»I¡¨²£«~ªºµù¥U¡A¦Ó§åµ¹¡§Ãľ¯¡F¯óÃÄ»s¾¯¡F¤¤ÂåÃİt¤è¡F¤H¥ÎÃÄ¡FÃĪ«¶¼®Æ¡FÂå¥ÎÃĪ«¡FÂå¥ÎÃĤY¡FÃĥν¦Ån¡F¤¤ÃĦ¨ÃÄ¡FÂå¥ÎÀç¾i«~¡FÂå¥Î°·±d¹«~¡¨²£«~ªº°Ó¼Ðµù¥U¥Ó½Ð¡C | |
| ½s¸¹ | N/230093¤ÎN/230094 |
| µù¥U¤é´Á | 2025/07/24 |
| §å¥Ü¤é´Á | 2025/07/24 |
| Åv§Q¤H | Sit Wo Tong Ng Po Powder Factory Limited |
| ¤ÀÃþ | 5 |
| ®Ú¾Ú²Ä216±ø¡Aµ²¦X²Ä214±ø²Ä2´Úa¡^¶µªº³W©w¡A©Úµ´¡§alimentos para bebés; gessos, materiais para pensos; chumbo para dentes, cera dental; desinfectantes; preparados para a destruição de animais nocivos; fungicidas, herbicidas¡¨²£«~ªºµù¥U¡A¦Ó§åµ¹¡§medicamentos patenteados chineses; preparados farmacêuticos e veterinários; preparados sanitários para fins médicos; substâncias dietéticas adaptadas para uso médico¡¨²£«~ªº°Ó¼Ðµù¥U¥Ó½Ð¡C | |
©Úµ´
| ½s¸¹ | §å¥Ü¤é´Á | ¥Ó½Ð¤H | Ãþ§O | ³Æµù ®Ú¾Ú12¤ë13¤é²Ä97/99/M¸¹ªk¥O |
| N/226585 | 2025/07/24 | °Ï§®¨} AO MIO LEONG |
43 | ²Ä214±ø²Ä1´Úa¡^¶µ¡Aµ²¦X²Ä9±ø²Ä1´Úe¡^¶µ¡A¥H¤Î²Ä214±ø²Ä2´Úb¡^¶µ¡Aµ²¦X²Ä215±ø²Ä1´Ú¡C |
| N/227673 | 2025/07/16 | «Ø©÷²±®ü¨ý¦³¤½¥q | 29 | ²Ä214±ø²Ä2´Úb¡^¶µ¡Aµ²¦X²Ä215±ø²Ä1´Ú¡A¥H¤Î²Ä214±ø²Ä1´Úa¡^¶µ¡Aµ²¦X²Ä9±ø²Ä1´Úe¡^¶µ¡C |
| N/227674 | 2025/07/16 | «Ø©÷²±®ü¨ý¦³¤½¥q | 30 | ²Ä214±ø²Ä2´Úb¡^¶µ¡Aµ²¦X²Ä215±ø²Ä1´Ú¡A¥H¤Î²Ä214±ø²Ä1´Úa¡^¶µ¡Aµ²¦X²Ä9±ø²Ä1´Úe¡^¶µ¡C |
| N/228285 | 2025/07/24 | ±i±ö ZHANG MEI |
30 | ²Ä214±ø²Ä2´Úb¡^¶µ¡Aµ²¦X²Ä215±ø²Ä1´Ú¡A¥H¤Î²Ä214±ø²Ä1´Úa¡^¶µ¡Aµ²¦X²Ä9±ø²Ä1´Úe¡^¶µ¡C |
| N/228286 | 2025/07/24 | ±i±ö ZHANG MEI |
31 | ²Ä214±ø²Ä2´Úb¡^¶µ¡Aµ²¦X²Ä215±ø²Ä1´Ú¡A¥H¤Î²Ä214±ø²Ä1´Úa¡^¶µ¡Aµ²¦X²Ä9±ø²Ä1´Úe¡^¶µ¡C |
| N/228287 | 2025/07/24 | ±i±ö ZHANG MEI |
35 | ²Ä214±ø²Ä2´Úb¡^¶µ¡Aµ²¦X²Ä215±ø²Ä1´Ú¡A¥H¤Î²Ä214±ø²Ä1´Úa¡^¶µ¡Aµ²¦X²Ä9±ø²Ä1´Úe¡^¶µ¡C |
| N/228288 | 2025/07/24 | ±i±ö ZHANG MEI |
43 | ²Ä214±ø²Ä2´Úb¡^¶µ¡Aµ²¦X²Ä215±ø²Ä1´Ú¡A¥H¤Î²Ä214±ø²Ä1´Úa¡^¶µ¡Aµ²¦X²Ä9±ø²Ä1´Úe¡^¶µ¡C |
| N/228289 | 2025/07/24 | ±i±ö ZHANG MEI |
30 | ²Ä214±ø²Ä2´Úb¡^¶µ¡Aµ²¦X²Ä215±ø²Ä1´Ú¡A¥H¤Î²Ä214±ø²Ä1´Úa¡^¶µ¡Aµ²¦X²Ä9±ø²Ä1´Úe¡^¶µ¡C |
| N/228290 | 2025/07/24 | ±i±ö ZHANG MEI |
35 | ²Ä214±ø²Ä2´Úb¡^¶µ¡Aµ²¦X²Ä215±ø²Ä1´Ú¡A¥H¤Î²Ä214±ø²Ä1´Úa¡^¶µ¡Aµ²¦X²Ä9±ø²Ä1´Úe¡^¶µ¡C |
| N/230359 | 2025/07/24 | MR LADY INTERNATIONAL LTD. | 43 | ²Ä214±ø²Ä1´Úa¡^¶µ©M²Ä2´Úb¡^¶µ¡Aµ²¦X²Ä9±ø²Ä1´Úe¡^¶µ©M²Ä215±ø²Ä1´Ú¡C |
| N/231487 | 2025/07/24 | º¿µY¿ß¬ì§Þ¡]¯]®ü¡^¦³¤½¥q | 05 | ²Ä214±ø²Ä1´Úa¡^¶µ©M²Ä2´Úb¡^¶µ¡Aµ²¦X²Ä9±ø²Ä1´Úe¡^¶µ©M²Ä215±ø²Ä1´Ú¡C |
| N/231488 | 2025/07/24 | º¿µY¿ß¬ì§Þ¡]¯]®ü¡^¦³¤½¥q | 35 | ²Ä214±ø²Ä1´Úa¡^¶µ©M²Ä2´Úb¡^¶µ¡Aµ²¦X²Ä9±ø²Ä1´Úe¡^¶µ©M²Ä215±ø²Ä1´Ú¡C |
| N/232109 | 2025/07/15 | Áé»à ZHONG SHAO |
29 | ²Ä214±ø²Ä2´Úb¡^¶µ¡Aµ²¦X²Ä215±ø²Ä1´Ú¡A¥H¤Î²Ä214±ø²Ä1´Úa¡^¶µ¡Aµ²¦X²Ä9±ø²Ä1´Úe¡^¶µ¡C |
| N/233572 | 2025/07/16 | ªC¦{¸·ªN¶T©ö¦³¤½¥q Hangzhou Yujie Trading Co., Ltd. |
25 | ²Ä9±ø²Ä1´Úc¡^¶µ¡A¾A¥Î©ó²Ä214±ø²Ä1´Úa¡^¶µ¡C |
| N/233597 | 2025/07/30 | ¸¤Ñ¦³¤½¥q FEI TIN COMPANHIA LIMITADA |
44 | ²Ä214±ø²Ä2´Úb¡^¶µ¡Aµ²¦X²Ä215±ø¤Î²Ä9±ø²Ä1´Úc¡^¶µ¡A¾A¥Î©ó²Ä214±ø²Ä1´Úa¡^¶µ¡C |
| N/233642 | 2025/07/22 | »¯«T³Ç CHIO CHON KIT |
30 | ²Ä214±ø²Ä2´Úb¡^¤Îe¡^¶µ¡A¥H¤Î²Ä9±ø²Ä1´Úa¡^¶µ¡A¾A¥Î©ó²Ä214±ø²Ä1´Úa¡^¶µ¡C |
Äò´Á
| ½s¸¹ | ||||||
| P/000539 (484-M) |
P/000991 (896-M) |
P/001057 (962-M) |
P/001103 (1008-M) |
P/001524 (1428-M) |
P/001525 (1429-M) |
P/001633 (1537-M) |
| P/002218 (2121-M) |
P/002221 (2124-M) |
P/002222 (2125-M) |
P/002223 (2126-M) |
P/002224 (2127-M) |
P/002227 (2130-M) |
P/002230 (2133-M) |
| P/002231 (2134-M) |
P/002235 (2138-M) |
P/002419 (2315-M) |
P/002453 (2349-M) |
P/002972 (2867-M) |
P/002975 (2870-M) |
P/002976 (2871-M) |
| P/002977 (2872-M) |
P/003008 (2903-M) |
P/003239 (3118-M) |
P/003285 (3164-M) |
P/003287 (3166-M) |
P/003783 (3654-M) |
P/009826 (9650-M) |
| P/009827 (9651-M) |
P/009828 (9652-M) |
P/009829 (9653-M) |
P/010744 (10579-M) |
P/010745 (10580-M) |
P/012437 (12503-M) |
P/012446 (12512-M) |
| P/012641 (12600-M) |
P/013504 (13420-M) |
P/013505 (13421-M) |
N/002240 | N/002241 | N/002242 | N/002243 |
| N/002249 | N/002255 | N/002305 | N/002306 | N/002307 | N/002314 | N/002395 |
| N/002493 | N/002640 | N/002745 | N/010611 | N/010612 | N/010613 | N/010614 |
| N/012421 | N/012429 | N/013510 | N/013690 | N/013691 | N/013692 | N/013693 |
| N/013694 | N/013695 | N/013703 | N/013951 | N/014153 | N/014155 | N/014242 |
| N/014252 | N/014664 | N/014665 | N/014702 | N/014862 | N/014887 | N/014888 |
| N/052572 | N/053849 | N/053850 | N/054112 | N/054113 | N/054114 | N/054498 |
| N/055161 | N/055162 | N/055176 | N/055396 | N/055397 | N/055469 | N/055470 |
| N/055471 | N/055472 | N/055473 | N/055563 | N/055564 | N/055565 | N/055614 |
| N/055757 | N/055818 | N/055819 | N/056413 | N/056414 | N/056415 | N/056416 |
| N/056557 | N/056607 | N/056608 | N/056609 | N/056610 | N/057029 | N/057030 |
| N/057031 | N/057032 | N/057033 | N/057034 | N/057035 | N/057036 | N/057037 |
| N/057038 | N/057039 | N/057442 | N/057443 | N/057525 | N/057526 | N/057528 |
| N/057756 | N/057989 | N/058196 | N/058281 | N/058282 | N/058283 | N/058284 |
| N/058285 | N/058286 | N/058640 | N/058866 | N/058867 | N/058868 | N/112435 |
| N/112436 | N/124869 | N/127356 | N/127357 | N/127358 | N/127359 | N/127360 |
| N/127361 | N/127619 | N/127620 | N/127621 | N/128792 | N/128915 | N/128916 |
| N/128917 | N/128918 | N/128919 | N/128920 | N/129973 | N/130128 | N/130129 |
| N/130130 | N/132192 | N/132236 | N/132259 | N/132260 | N/132261 | N/132262 |
| N/132263 | N/132264 | N/132265 | N/132266 | N/132371 | N/132712 | N/132779 |
| N/132780 | N/132781 | N/132782 | N/132808 | N/133007 | N/133008 | N/133009 |
| N/133027 | N/133033 | N/133153 | N/133202 | N/133513 | N/133519 | N/133520 |
| N/133702 | N/133703 | N/133704 | N/133705 | N/133706 | N/133707 | N/133708 |
| N/133714 | N/133715 | N/133752 | N/133890 | N/133891 | N/133948 | N/133949 |
| N/134416 | N/134451 | N/134484 | N/134498 | N/134499 | N/134501 | N/134775 |
| N/134884 | N/134887 | N/134961 | N/134962 | N/134963 | N/135019 | N/135020 |
| N/135021 | N/135022 | N/135147 | N/135209 | N/135270 | N/135271 | N/135272 |
| N/135273 | N/135393 | N/135394 | N/135395 | N/135396 | N/135397 | N/135398 |
| N/135399 | N/135400 | N/135401 | N/135402 | N/135421 | N/135422 | N/135442 |
| N/135443 | N/135444 | N/135445 | N/135446 | N/135447 | N/135448 | N/135449 |
| N/135450 | N/135451 | N/135452 | N/135453 | N/135454 | N/135455 | N/135456 |
| N/135457 | N/135536 | N/135621 | N/135622 | N/135623 | N/135624 | N/135625 |
| N/135626 | N/135627 | N/135628 | N/135629 | N/135630 | N/135632 | N/135653 |
| N/136001 | N/136002 | N/136038 | N/136250 | N/136358 | N/136359 | N/136456 |
| N/136457 | N/136477 | N/136479 | N/136480 | N/136481 | N/136482 | N/136619 |
| N/136620 | N/136621 | N/136623 | N/136624 | N/136625 | N/136626 | N/136627 |
| N/136629 | N/136630 | N/136631 | N/136632 | N/136633 | N/136719 | N/136883 |
| N/136884 | N/136890 | N/136893 | N/136904 | N/136906 | N/136926 | N/136986 |
| N/136987 | N/136988 | N/136989 | N/136991 | N/136992 | N/136993 | N/136994 |
| N/137045 | N/137046 | N/137047 | N/137048 | N/137049 | N/137050 | N/137059 |
| N/137060 | N/137230 | N/137231 | N/137232 | N/137233 | N/137249 | N/137397 |
| N/137398 | N/137399 | N/137400 | N/137401 | N/137402 | N/137403 | N/137404 |
| N/137405 | N/137406 | N/137407 | N/137408 | N/137409 | N/137410 | N/137411 |
| N/137412 | N/137413 | N/137414 | N/137415 | N/137416 | N/137417 | N/137418 |
| N/137419 | N/137420 | N/137421 | N/137466 | N/137467 | N/137468 | N/137631 |
| N/137675 | N/137676 | N/137677 | N/137756 | N/137757 | N/137758 | N/137759 |
| N/137773 | N/137779 | N/137850 | N/137851 | N/137921 | N/138080 | N/138082 |
| N/138086 | N/138087 | N/138088 | N/138089 | N/138090 | N/138091 | N/138092 |
| N/138093 | N/138094 | N/138095 | N/138096 | N/138097 | N/138098 | N/138099 |
| N/138100 | N/138101 | N/138182 | N/138256 | N/138257 | N/138258 | N/138259 |
| N/138382 | N/138410 | N/138411 | N/138464 | N/138755 | N/138756 | N/138757 |
| N/138951 | N/138998 | N/138999 | N/139000 | N/139002 | N/139192 | N/139193 |
| N/139703 | N/139704 | N/139705 | N/139706 | N/139707 | N/139708 | N/139709 |
| N/139765 | N/139766 | N/139767 | N/139768 | N/139769 | N/139770 | N/139771 |
| N/139772 | N/139773 | N/139774 | N/139775 | N/139776 | N/139777 | N/139778 |
| N/139857 | N/140043 | N/140196 | N/140292 | N/140714 | N/141102 | N/141103 |
| N/141323 | N/141324 | N/141325 | N/141326 | N/141327 | N/141468 | N/141543 |
| N/141544 | N/141822 | N/141862 | N/141945 | N/141946 | N/141954 | N/141955 |
| N/141956 | N/142002 | N/142003 | N/142004 | N/142005 | N/142006 | N/142007 |
| N/142008 | N/142009 | N/142010 | N/142149 | N/142246 | N/142247 | N/142248 |
| N/142249 | N/142250 | N/142264 | N/142404 | N/142405 | N/142534 | N/142535 |
ªþµù
| ½s¸¹ | §å¥Ü¤é´Á | ªþµù¤§©Ê½è | Åv§Q¤H/¥Ó½Ð¤H | ¤º®e | |
| P/002643 (2539-M) P/002905 (2801-M) P/002949 (2845-M) P/002950 (2846-M) P/002951 (2847-M) P/002952 (2848-M) P/002953 (2849-M) P/002954 (2850-M) P/002956 (2851-M) P/002957 (2852-M) P/002958 (2853-M) P/002959 (2854-M) P/002960 (2855-M) P/002961 (2856-M) P/002962 (2857-M) P/002963 (2858-M) P/003137 (3032-M) P/007250 (7020-M) P/012419 (12485-M) P/012420 (12486-M) P/013680 (13608-M) P/013681 (13609-M) P/013682 (13610-M) P/013683 (13611-M) P/013777 (13722-M) P/013778 (13723-M) P/013779 (13724-M) P/014005 (13934-M) P/015372 (15282-M) P/015526 (15484-M) N/000358 N/000360 N/000361 |
N/001008 N/001009 N/002006 N/002007 N/002010 N/002011 N/003055 N/003379 N/003511 N/003512 N/003513 N/003516 N/003519 N/003520 N/005609 N/005610 N/005828 N/007656 N/007657 N/008682 N/008683 N/008751 N/008752 N/008753 N/008754 N/008755 N/008982 N/008983 N/008984 N/008985 N/009228 N/009229 N/009230 N/009231 N/009232 N/014111 N/014112 N/014113 N/014114 N/014115 N/015378 N/020369 N/022282 N/022283 N/022331 N/022332 N/031194 N/035677 N/035678 N/036778 N/048681 N/048953 N/066570 N/066571 N/070682 N/078232 N/078282 N/114916 N/114917 N/114918 N/114919 N/144790 |
2025/07/22 | §ó§ï¦a§} | Kenvue Inc. | 1 Kenvue Way, Summit, New Jersey 07901, USA |
| P/004915 (4777-M) P/010914 (10736-M) P/014486 (14391-M) P/015082 (14990-M) |
N/000923 N/000924 N/002585 N/003598 N/006006 N/119581 |
2025/07/16 | ÂàÅý | Cedente: Merck Sharp & Dohme Corp. |
Cessionário: N.V. Organon, com sede em Kloosterstraat 6 NL-5349 AB Oss, The Netherlands |
| P/006608 (6394-M) |
2025/07/16 | ÂàÅý | Cedente: MERCK SHARP & DOHME, LDA. |
Cessionário: N.V. Organon, com sede em Kloosterstraat 6 NL-5349 AB Oss, The Netherlands |
|
| N/002638 | 2025/07/16 | §ó§ï»{§O¸ê®Æ | Tulip Food Company GmbH | Danish Crown Foods Germany GmbH | |
| N/002745 | 2025/07/21 | §ó§ï¦a§} | SOCIEDADE DE CIMENTOS DE MACAU, S.A.R.L., representado pelo MA YINGSU e IU HOI | ¿Dªù¸ôÀô¤E¿D¸t¥À°¨¸ô206¤Î898 | |
| N/008915 N/008916 N/008917 N/008918 N/008919 |
N/008920 N/008923 N/101606 N/149108 N/149109 |
2025/07/21 | §ó§ï»{§O¸ê®Æ | Ipsen Consumer HealthCare | MAYOLY PHARMA FRANCE |
| §ó§ï¦a§} | MAYOLY PHARMA FRANCE | 3 Place Renault, 92500 Rueil-Malmaison, France | |||
| N/012073 | 2025/07/16 | ÂàÅý | Cedente: MSD INTERNATIONAL GMBH |
Cessionário: N.V. Organon, com sede em Kloosterstraat 6 NL-5349 AB Oss, The Netherlands |
|
| N/013195 N/013196 |
2025/07/16 | §ó§ï¦a§} | Balenciaga | 16-18 rue Vaneau, 75007 Paris, France | |
| N/018393 N/018394 N/018397 N/018398 N/018399 N/018400 N/018401 N/018402 N/018403 N/018404 |
N/018405 N/018406 N/018407 N/025583 N/025584 N/043807 N/043808 N/067626 N/067627 |
2025/07/16 | §ó§ï¦a§} | DREAMWELL, LTD. | 2451 Industry Avenue, Doraville, Georgia 30360 (USA) |
| N/021651 N/021652 |
2025/07/21 | ÂàÅý | ÂàÅý¤H¡G ªô®a¤¯ IAO KA IAN |
¨üÅý¤H¡G ªôà±»ö¡A¦a§}¬°¤¤°ê¼sªF¬Ù¤¤¤s¥«¤®Û¤s°Ïªø©R¤ô§øªô«Î¥¿µó58¸¹ |
|
| N/051788 N/051789 N/051790 N/051791 |
N/051792 N/051793 N/051794 |
2025/07/21 | ÂàÅý | Cedente: Accessorize Limited |
Cessionário: Accessorize TM Limited, com sede em 1 Nicholas Road, London W11 4AN, United Kingdom |
| N/076465 | 2025/07/16 | §ó§ï¦a§} | ¹©ºÍ¦A«OÀI¦³¤½¥q Peak Reinsurance Company Limited |
13/F-15M/F WKCDA Tower, No. 8 Austin Road West, West Kowloon Cultural District, Kowloon, Hong Kong | |
| N/081003 | 2025/07/21 | §ó§ï»{§O¸ê®Æ | HANEL COMPANY LIMITED | HANEL JOINT STOCK COMPANY | |
| N/093943 N/093944 |
2025/07/16 | ¦X¨ÖÂàÅý | KABUSHIKI KAISHA POKELABO (POKELABO, INC.) | WFS, Inc., com sede em 6-11-1 Roppongi, Minato-ku, Tokyo, Japan | |
| N/094324 N/094325 N/094326 |
2025/07/21 | ÂàÅý | ÂàÅý¤H¡G BALLIN PROJECT S.R.L. |
¨üÅý¤H¡G ¤ÚªL¨p¤H¤½¥q¡A¦a§}¬°·s¥[©Y³ìªv°ê¤ý¤j¹D¼y³Ç¤j·H346C¶l½s208577 BALLIN PTE. LTD., com sede em 346C King George¡¦s Avenue, King George¡¦s Building, Singapore (208577) |
|
| N/097066 N/097067 N/098567 N/106755 N/106756 N/106757 N/106758 N/106759 N/106760 |
N/106761 N/106762 N/142689 N/142690 N/142691 N/142692 N/175591 N/175592 |
2025/07/21 | ÂàÅý | ÂàÅý¤H¡G ¤j¦t¸ê°TªÑ¥÷¦³¤½¥q |
¨üÅý¤H¡G °ªµn¤j¹D¶°¹Î¦³¤½¥q¡A¦a§}¬°Âļ¯¨Èªü¥Ö¨È¨FÅy¸ôNPF¤j·H1¼h·çP¹F¥ø·~ªA°È¤¤¤ß |
| N/104366 | 2025/07/16 | ÂàÅý | Cedente: PERTUISANE PRODUCTIONS |
Cessionário: 1. DAVID MEIL, com sede em 31 Avenue du General Sarrail 75016, Paris-France 2. KIMBERLY JONES, com sede em 31 Avenue du General Sarrail 75016, Paris-France |
|
| N/132118 | 2025/07/21 | §ó§ï¦a§} | GOTICO LTD | Room 09-12, 1/F., Brill Plaza, 84 To Kwa Wan Road, To Kwa Wan, Kowloon, Hong Kong | |
| N/134498 N/134499 |
2025/07/21 | ÂàÅý | ÂàÅý¤H¡G DBE INTERNATIONAL HOLDING LIMITED |
¨üÅý¤H¡G Ãö¬ü¼_¡A¦a§}¬°¤@¼Ó¡A23¸¹®M©Ð¡A·çP¹F¥ø·~ªA°È¤¤¤ß¡A¥ì¨l¶é¼s³õ¡A¥ì¨l¶é®q¡A°¨®J®q¡A¶ë®uº¸ KWAN Mei Han May, com sede em Vistra Corporate Services Centre, Suite 23, 1st Floor, Eden Plaza, Eden Island, Mahé, Seychelles |
|
| N/139409 N/139410 |
2025/07/21 | §ó§ï¦a§} | ¿Dªù¹©ºÖ¹«~¦³¤½¥q | ¿Dªù°Ï¯«¤÷µó229¸¹¤K¹F·s§ø¦ë§Q¼Ó15¼ÓAU | |
| N/139411 N/139412 |
2025/07/21 | §ó§ï¦a§} | ³¯ºÖ°Oá¦×¹«~¡]¿Dªù¡^¦³¤½¥q | ¿Dªù°Ï¯«¤÷µó229¸¹¤K¹F·s邨¦ë§Q¼Ó15¼ÓAU | |
| N/153644 | 2025/07/16 | ÂàÅý | ÂàÅý¤H¡G «¼y¥«¦h»ò¹«~¦³¤½¥q |
¨üÅý¤H¡G ÉQ¹©¡]«¼y¡^¥ø·~ºÞ²z¦³¤½¥q¡A¦a§}¬°¤¤°ê«¼y¥«´ü¤¤°Ï¤ÆÀs¾ôµó¹D·ç¤Ñ¸ô64¸¹ªþ2¸¹ |
|
| N/157197 N/157198 N/193649 N/193650 |
2025/07/21 | ÂàÅý | Cedente: MANIFATTURE DADDATO S.P.A. |
Cessionário: 1. MANIFATTURE DADDATO S.P.A., com sede em Via Strasburgo, 11-13-15 - 76121 Barletta (BT), Italy 2. DADDATO OPERATIONS S.R.L., com sede em Via dell¡¦ Unione Europea, 62-76121 Barletta (BT)-Italy |
|
| N/158185 N/158186 |
2025/07/21 | §ó§ï¦a§} | ²`¦`¥«ÁyµÞ¬ì§Þ¦³¤½¥q Shenzhen Lianmeng Technology Co., Ltd. |
¤¤°ê²`¦`¥««n¤s°Ï©Û°Óµó¹D¤ôÆWªÀ°Ï¤Ó¤l¸ô51¸¹¤Ó¤l¼s³õ1104 1104, Taizi Plaza, No. 51 Taizi Road, Shuiwan Community, Zhaoshang Street, Nanshan District, Shenzhen, China |
|
| ÂàÅý | ÂàÅý¤H¡G ²`¦`¥«ÁyµÞ¬ì§Þ¦³¤½¥q Shenzhen Lianmeng Technology Co., Ltd. |
¨üÅý¤H¡G Lemon Inc., com sede em P.O. Box 31119 Grand Pavilion, Hibiscus Way, 802 West Bay Road, Grand Cayman, KY1-1205, Cayman Islands |
|||
| N/168486 N/168487 N/168632 N/178069 N/178070 |
N/178071 N/180556 N/211385 N/231875 |
2025/07/21 | §ó§ï»{§O¸ê®Æ | Ipsen Consumer Healthcare | MAYOLY PHARMA FRANCE |
| §ó§ï¦a§} | MAYOLY PHARMA FRANCE | 3 Place Renault, 92500 Rueil-Malmaison, France | |||
| N/169995 N/169996 N/169997 |
2025/07/21 | §ó§ï¦a§} | Bytedance Ltd. | P.O. Box 31119 Grand Pavilion, Hibiscus Way, 802 West Bay Road, Grand Cayman, KY1-1205, Cayman Islands | |
| ÂàÅý | Cedente: Bytedance Ltd. |
Cessionário: Lemon Inc., com sede em P.O. Box 31119 Grand Pavilion, Hibiscus Way, 802 West Bay Road, Grand Cayman, KY1-1205, Cayman Islands |
|||
| N/186123 N/186124 |
2025/07/16 | ÂàÅý | ÂàÅý¤H¡G ²`¦`¥«ªF¤è¹Å¸Î¹ê·~¦³¤½¥q Shenzhen Oriental Jiayu Industrial Co., Ltd. |
¨üÅý¤H¡G ²`¦`¥«©P¤»ºÖ¹s°â¹q°Ó¦³¤½¥q¡A¦a§}¬°¤¤°ê¼sªF¬Ù²`¦`¥«Ã¹´ò°Ï½¬¶íµó¹DÄP¿³ªÀ°ÏÄP¿³¸ô2¸¹ÄP°ò¤u·~°Ï702´É¤»¼h Shenzhen Zhou Liu Fu E-commerce Co., Ltd., com sede em Floor 6, Building 702, Pengji Industrial Zone, No. 2 Pengxing Road, Pengxing Community, Liantang Street, Luohu District, Shenzhen, Guangdong, China |
|
| N/189306 N/189307 N/189308 N/189309 N/189310 N/189311 |
2025/07/16 | ¸Ñ°£¬d«Ê | ªì¯Åªk°|³Ò°Êªk®xªk©x»Õ¤U-¨÷©v½s¸¹ LB1-20-0227-LAC-A Mm.º Juíz do Juízo Laboral do Tribunal Judicial de Base - Proc. n.º LB1-20-0227-LAC-A |
ANTÓNIO GRUPO LIMITADA | |
| N/198188 | 2025/07/21 | §ó§ï»{§O¸ê®Æ | ¬ü¦w©~ª«·~¦³¤½¥q | ¬ü¦w©~À\¶¼¦³¤½¥q | |
| §ó§ï»{§O¸ê®Æ | ¬ü¦w©~À\¶¼¦³¤½¥q | ¬ü¦w©~¬ü®e¦³¤½¥q | |||
| N/201931 N/201932 N/201933 N/201934 N/201935 N/201936 N/201937 N/201938 N/201939 N/201940 N/201941 N/201942 N/201943 N/201944 |
N/201945 N/201946 N/201947 N/201948 N/202590 N/202591 N/202592 N/202593 N/202594 N/202595 N/202596 N/202597 N/202598 |
2025/07/22 | §ó§ï¦a§} | Kenvue Inc. | 1 Kenvue Way, Summit, New Jersey 07901, United States of America |
| N/202970 N/202971 |
2025/07/21 | ÂàÅý | Cedente: MANIFATTURE DADDATO S.P.A. |
Cessionário: DADDATO OPERATIONS S.R.L., com sede em Via dell¡¦Unione Europea, 62-76121 Barletta (BT)-Italy |
|
| N/208539 | 2025/07/16 | ¸Ñ°£¬d«Ê | ªì¯Åªk°|³Ò°Êªk®xªk©x»Õ¤U-¨÷©v½s¸¹ LB1-20-0227-LAC-A Mm.º Juíz do Juízo Laboral do Tribunal Judicial de Base - Proc. n.º LB1-20-0227-LAC-A |
¦wªF¥§¶ø¶°¹Î¦³¤½¥q ANTÓNIO GRUPO LIMITADA |
|
| N/212786 N/212787 N/212788 N/212789 N/212790 N/212791 |
2025/07/16 | §ó§ï¦a§} | Áp¦X°ö¶i±Ð¨|¥Xª©¡]»´ä¡^¦³¤½¥q UNITED PRIME EDUCATIONAL PUBLISHING (HK) LIMITED |
»´äÆ[¶íÂE¹Ï¹D22¸¹«T滙¤¤¤ß28¼Ó 28/F, Elite Centre, 22 Hung To Road, Kwun Tong, Hong Kong |
|
| N/218067 | 2025/07/21 | ÂàÅý | ÂàÅý¤H¡G °ê·½¤ÑµMÃĪ«¦³¤½¥q |
¨üÅý¤H¡G ¿Dªù¦ã¤à«Â¥Íª«¬ì§Þ¦³¤½¥q¡A¦a§}¬°¿Dªù¥Ã¹ç¼s³õ147¸¹寳·u®ü´ºªá¶é寳µo»Õ¦a¤UR¾Q |
|
| N/226963 | 2025/07/21 | ÂàÅý | ÂàÅý¤H¡G ²`¦`¥«°¨´µ¯S¾÷±ñ¦³¤½¥q Shenzhen Masite Machinery Co., Ltd. |
¨üÅý¤H¡G ¶h¬Õ¾i°·±d¬ì§Þ¡]¨H¶§¡^¦³¤½¥q¡A¦a§}¬°¤¤°ê¿ñ¹ç¬Ù¨H¶§¥«¨Hªe°Ï«C¦~¤jµó1-1¸¹¨H¶§¥«©²ùÚ¶©¼s³õ¿ì¤½¼Ó1®y1215³æ¤¸ Yiyingyang Health Technology (Shenyang) Co., Ltd., com sede em Unit 1215, Building 1, Henglong Plaza Office Building, Shenyang City Government, No. 1-1 Qingnian Street, Shenhe District, Shenyang City, Liaoning Province, China 110000 |
|
| N/228928 | 2025/07/22 | §ó§ï¦a§} | KENVUE INC. | 1 Kenvue Way, Summit, New Jersey 07901, USA | |
| N/231989 N/231990 N/231991 N/231992 N/231993 N/231994 |
2025/07/16 | ÂàÅý | ÂàÅý¤H¡G »´äµLÄ֥ͪ«¬ì§Þ¦³¤½¥q POLARIS COSMETICS LIMITED |
¨üÅý¤H¡G ¥_¨ÊµLÄ֥ͪ«¬ì§Þ¦³¤½¥q¡A¦a§}¬°¤¤°ê¥_¨Ê¥«¤j¿³°Ï¤¤Ãö§ø¬ì§Þ¶é°Ï¤j¿³¥Íª«ÂåÃIJ£·~°ò¦a²»·ç¤jµó35¸¹°|1¸¹¼Ó3¼h337«Ç Beijing Wuling Biotechnology Co., Ltd. , com sede em Room 337, 3rd Floor, Building 1, No. 35 Xiangrui Street, Daxing Biomedicine Industry Base, Zhongguancun Science Park, Daxing District, Beijing, China |
|
¥qªk§P¨M
| ½s¸¹ | ¥Ó½Ð¤H¡þÅv§Q¤H | ªk°| | ¨÷©v½s¸¹ | ½T©w§P¨M¤é´Á |
| 1 N/217704 | Islestarr Holdings Limited | ªì¯Åªk°| | CV1-24-0112-CRJ | 2025/01/20 |
| 2 N/217705 | Islestarr Holdings Limited | ¤¤¯Åªk°| | Ac. de 2025/06/19 Proc. n.º 331/2025 |
2025/07/07 |
| 3 N/218838 N/218840 |
¾¤¾å¿P LAI HIO IN |
ªì¯Åªk°| | CV1-24-0126-CRJ | 2025/01/27 |
| 4 N/225477 N/225478 |
°ª´fµÓ Kou Wai Peng |
ªì¯Åªk°| | CV4-25-0030-CRJ | 2025/06/23 |
| 1 ªì¯Åªk°|ºû«ù©Úµ´¦³Ãö°Ó¼Ðµù¥U¤§§å¥Ü¡C 2 ¤¤¯Åªk°|ºû«ù©Úµ´¦³Ãö°Ó¼Ðµù¥U¤§§å¥Ü¡C 3 ªì¯Åªk°|½T»{¤W¶D¤§ºM¦^¡C 4 ªì¯Åªk°|¼o¤î©Úµ´¦³Ãö°Ó¼Ðµù¥U¤§§å¥Ü¡C |
||||
©ñ±ó
| ½s¸¹ | §å¥Ü¤é´Á | Åv§Q¤H/¥Ó½Ð¤H | Ãþ别 |
| N/234928 | 2025/07/16 | «n¥úÂåÀøºÞ²zÅU°Ý¦³¤½¥q | 05 |
³¡¤À©ñ±ó
| ½s¸¹ | §å¥Ü¤é´Á | Åv§Q¤H | ©ñ±ó³¡¤À |
| N/231824 | 2025/07/24 | MEGMILK SNOW BRAND CO., LTD. | Cervejas; mosto de cerveja; extratos de lúpulo para fazer cerveja; pós para bebidas efervescentes; pastilhas para bebidas efervescentes; bebidas carbonatadas [bebidas refrescantes]; bebidas de soro de leite. |
«Å§G¥¢®Ä¤§¥Ó½Ð
| ½s¸¹ | ´£¥æ¤é´Á | Åv§Q¤H | «Å¥¬¥¢®Ä¥Ó½Ð¤H |
| N/150471 | 2025/07/29 | Maxim¡¦s Caterers Limited | ¬ü¤ß»æ©±¦³¤½¥q PADARIA E PASTELARIA MAXIM¡¦S LIMITADA |
| N/167333 | 2025/07/29 | ¬ü¤ß¹«~¦³¤½¥q Maxim¡¦s Caterers Limited |
¬ü¤ß»æ©±¦³¤½¥q PADARIA E PASTELARIA MAXIM¡¦S LIMITADA |
Án©ú²§Ä³
| ½s¸¹ | ´£¥æ¤é´Á | ¥Ó½Ð¤H | Án©ú²§Ä³¤H |
| N/233568 | 2025/06/16 | ¥_¨Ê¹A¤Ò¾Q¤l§Þ³N¬ã¨s°| | Apple Inc. |
| N/235931 | 2025/06/16 | ¥ÉÀsÂåÀø¬ì§Þ¦³¤½¥q LONGEVITY MEDICAL TECHNOLOGY LIMITED |
The North Face Apparel Corp. |
| N/235935 | 2025/06/16 | ¥ÉÀsÂåÀø¬ì§Þ¦³¤½¥q LONGEVITY MEDICAL TECHNOLOGY LIMITED |
The North Face Apparel Corp. |
| N/235936 | 2025/06/16 | ¥ÉÀsÂåÀø¬ì§Þ¦³¤½¥q LONGEVITY MEDICAL TECHNOLOGY LIMITED |
The North Face Apparel Corp. |
| N/235937 | 2025/06/16 | ¥ÉÀsÂåÀø¬ì§Þ¦³¤½¥q LONGEVITY MEDICAL TECHNOLOGY LIMITED |
The North Face Apparel Corp. |
| N/235938 | 2025/06/16 | ¥ÉÀsÂåÀø¬ì§Þ¦³¤½¥q LONGEVITY MEDICAL TECHNOLOGY LIMITED |
The North Face Apparel Corp. |
| N/235939 | 2025/06/16 | ¥ÉÀsÂåÀø¬ì§Þ¦³¤½¥q LONGEVITY MEDICAL TECHNOLOGY LIMITED |
The North Face Apparel Corp. |
| N/238402 | 2025/07/29 | ³ü¦Ì§Ö¹B¥þ²y¦³³d¥ô¤½¥q YIMI CARGO GLOBAL PTE. LTD. |
¿Dªù¥DÃD¤½¶é´ç°²§øªÑ¥÷¦³¤½¥q MACAU PARQUE TEMÁTICO E RESORT S.A., em Inglês MACAU THEME PARK AND RESORT LIMITED |
| N/238888 | 2025/07/30 | Maxim¡¦s Caterers Limited | ¬ü¤ß»æ©±¦³¤½¥q PADARIA E PASTELARIA MAXIM¡¦S LIMITADA |
榏G
| ½s¸¹ | ´£¥æ¤é´Á | ¥Ó½Ð¤H | Án©ú²§Ä³¤H |
| N/231595 | 2025/06/16 | CHANEL | BREITLING SA. |
Àç·~³õ©Ò¦WºÙ¤Î¼Ð»xªº«OÅ@
®Ú¾Ú¸g¤Q¤G¤ë¤Q¤T¤é²Ä97/99/M¸¹ªk¥O®Ö㤧¡m¤u·~²£Åvªk«ß¨î«×¡n²Ä¤Q±ø²Ä¤@´Ú¤Î²Ä¤G´Úªº³W©w¡A¤½§G¤U¦C¦b¿Dªù¯S§O¦æ¬F°Ï´£¥XªºÀç·~³õ©Ò¦WºÙ¤Î¼Ð»xµn°O¥Ó½Ð¤§§å¥Ü¡A¨Ã«ö·Ó¦P¤@ªk³W²Ä¤G¦Ê¤C¤Q¤±ø¦Ü²Ä¤G¦Ê¤C¤Q¤C±øªº³W©w¡A¥i©ó¥»¤½§G¤é°_¤@Ó¤ë´Á¤º´N¤U¦C§å¥Ü¦Vªì¯Åªk°|´£°_¤W¶D¡C
Äò´Á
| ½s¸¹ | ||||||
| E/000236 | ||||||
³]p¤Î·s«¬ªº«OÅ@
¥Ó½Ð
®Ú¾Ú¸g¤Q¤G¤ë¤Q¤T¤é²Ä97/99/M¸¹ªk¥O®Ö㤧¡m¤u·~²£Åvªk«ß¨î«×¡n²Ä¤Q±ø¡B²Ä¤@¦Ê¤»¤Q¤±ø¤Î²Ä¤@¦Ê¤»¤Q¤»±ø²Ä¤@´Úªº³W©w¡A¤½§G¤U¦C¦b¿Dªù¯S§O¦æ¬F°Ï´£¥Xªº³]p¤Î·s«¬µù¥U¥Ó½Ð¡A¦Û¥»³q§i¤½§G¤é°_¦Üµ¹¤©µù¥U¤§¤é¤î¡A¥ô¦ó²Ä¤T¤H§¡±o´£¥XÁn©ú²§Ä³¡C
[21] ½s¸¹ : D/003719
[22] ¥Ó½Ð¤é : 2024/08/08
[71] ¥Ó½Ð¤H : »AµØ«~µP¡]»´ä¡^¦³¤½¥q
¦a§} : »´ä·s¬É¨F¥Ð¦wÄ£µó3¸¹¶×¹F¤j·H2¼Ó1-6«Ç
°êÄy : ®Ú¾Ú»´äªk¨Ò¦¨¥ß
[72] ³Ð§@¤H : ²ö¤l©_ Mok Tsz Ki
[51] ¤ÀÃþ : 20 - 99
[54] ¼ÐÃD : ¦N²»ª«¡C
[57] ºKn : ¥»³]p«Y¦³Ãö©ó¤@ºØ¡u¦N²»ª«¡v¡A¸Ó¡u¦N²»ª«¡v¬O¥H¤@ºØ¥d³q¤Hª«§Î¶H¡A¥Î©ó¥Nªí¥Ó½Ð¤H¡Cªíz©ÒÅã¥Üªºª««~ªº§Îª¬¡Bºc§Î¡B¦¡¼Ë¤Î/©Î¸Ë¹¢¬OÁnºÙ¨ã¦³·s¿o©Êªº¥~Æ[³]p¯S¦â¡C
ªþ¹Ï :

[21] ½s¸¹ : D/003822
[22] ¥Ó½Ð¤é : 2024/11/08
[71] ¥Ó½Ð¤H : ªÜ¥§¸¦¶°¹Î
¦a§} : Vanity Group Sydney, 4-6 Meeks Road, Marrickville, NSW 2204, Australia
°êÄy : ¿D¤j§Q¨È
[72] ³Ð§@¤H : «Où¡DÂħQ¦N´µ Paul Tsalikis
[51] ¤ÀÃþ : 23 - 08
[54] ¼ÐÃD : ¨m²G¾¹¡C
[57] ºKn : ¦¹¥~Æ[³]pªº·s¿o©Ê¡A¦b©ó¦¹µ¥ªíz©Ò¥Üª««~ªº§Îª¬¡Bºc§Î¡B¦¡¼Ë©Î¸Ë¹¢ªº¯S¦â¡C
ªþ¹Ï :

[30] Àu¥ýÅv : 2024/08/16¡A¤¤°ê¤º¦a China¡A½s¸¹N.º 2024305218661
[21] ½s¸¹ : D/003874
[22] ¥Ó½Ð¤é : 2025/01/22
[71] ¥Ó½Ð¤H : HERMES SELLIER (SOCIÉTÉ PAR ACTIONS SIMPLIFIÉE)
¦a§} : 24, Rue du Faubourg Saint-Honoré 75008 Paris, France
°êÄy : ªk°ê
[72] ³Ð§@¤H : Pierre-Alexis DUMAS
[51] ¤ÀÃþ : 3 - 01
[54] ¼ÐÃD : ¤k¤h¤â³U¡C
[57] ºKn : As características do desenho para o qual é reivindicada a novidade consistem numa bolsa de senhora em couro. A carteira tem duas alças na parte superior, não extensíveis e que permitem apenas que a bolsa seja transportada na mão e não a tiracolo. Todas as faces são fechadas, excepto a superior, pela qual se acede ao conteúdo da bolsa. A bolsa tem um formato rectangular e na parte superior o fecho da mesma faz-se através de uma aba rectangular que se sobrepõe ao corpo da mala. Na aba que fecha a bolsa estão desenhados vários recortes com função ornamental. Na face traseira está desenhado o perfil da bolsa por meio de um pesponto que acompanha o desenho da mesma e estão também colocadas duas fivelas de couro horizontal que, na parte frontal da bolsa, permitem o fecho da mesma. Desta face consta ainda um pequena bolsa rectangular mais pequena que está fixada na bolsa mas sobressai da mesma. Nas faces laterais é visível o sistema de dobras em couro que permite à bolsa aumentar de volume quando colocado conteúdo no seu interior. A parte inferior é achada mas larga, por forma a manter a bolsa na vertical.
ªþ¹Ï :

[30] Àu¥ýÅv : 2024/08/06¡A¥@¬Éª¾ÃѲ£Åv²Õ´ WIPO¡A½s¸¹N.º WIPO151683
®Ú¾Ú¸g¤Q¤G¤ë¤Q¤T¤é²Ä97/99/M¸¹ªk¥O®Ö㤧¡m¤u·~²£Åvªk«ß¨î«×¡n²Ä¤Q±ø²Ä¤@´Ú¤Î²Ä¤G´Úªº³W©w¡A¤½§G¤U¦C¦b¿Dªù¯S§O¦æ¬F°Ï´£¥Xªº³]p¤Î·s«¬µù¥U¥Ó½Ð¤§§å¥Ü¡A¨Ã«ö·Ó¦P¤@ªk³W²Ä¤G¦Ê¤C¤Q¤±ø¦Ü²Ä¤G¦Ê¤C¤Q¤C±øªº³W©w¡A¥i©ó¥»¤½§G¤é°_¤@Ó¤ë´Á¤º´N¤U¦C§å¥Ü¦Vªì¯Åªk°|´£°_¤W¶D¡C
§åµ¹
| ½s¸¹ | µù¥U¤é´Á | §å¥Ü¤é´Á | Åv§Q¤H |
| D/003843 | 2025/07/17 | 2025/07/17 | Omega SA (Omega AG) (Omega Ltd) |
| D/003850 | 2025/07/17 | 2025/07/17 | ¼sªFªø¶©¶°¹Î¦³¤½¥q GUANGDONG CHIMELONG GROUP CO., LTD. |
| D/003851 | 2025/07/17 | 2025/07/17 | SONY INTERACTIVE ENTERTAINMENT INC. |
©Úµ´
| ½s¸¹ | §å¥Ü¤é´Á | ¥Ó½Ð¤H | ³Æµù ®Ú¾Ú12¤ë13¤é²Ä97/99/M¸¹ªk¥O |
| D/003157 | 2025/07/18 | ¥_¨Ê¬L¼w§ë¸ê¶°¹Î¦³¤½¥q BEIJING ZHAODE INVESTMENT GROUP CO., LTD |
²Ä173±øa¡^¶µ¡Aµ²¦X²Ä9±ø²Ä1´Úa¡^¶µ¡B²Ä152±ø¤Î²Ä153±ø¡C |
| D/003161 | 2025/07/18 | ¥_¨Ê¤W¶§»O°s·~¦³¤½¥q Beijing Shangyangtai Liquor Co., Ltd. |
²Ä173±øa¡^¶µ¡Aµ²¦X²Ä9±ø²Ä1´Úa¡^¶µ¡B²Ä152±ø¤Î²Ä153±ø¡C |
µo©ú±M§Q©µ¦ùªº«OÅ@
®Ú¾Ú¸g¤Q¤G¤ë¤Q¤T¤é²Ä97/99/M¸¹ªk¥O®Ö㤧¡m¤u·~²£Åvªk«ß¨î«×¡n²Ä¤Q±ø²Ä¤@´Ú¤Î²Ä¤G´Ú¡Aµ²¦X¡m°ê®aª¾ÃѲ£Åv§½©M¿Dªù¯S§O¦æ¬F°Ï¬F©²¸gÀÙ§½Ãö©ó²`¤Æ¦bª¾ÃѲ£Åv»â°ì¥æ¬y¦X§@ªº¦w±Æ¡n²Ä¤»±øªº³W©w¡A¤½§G¤U¦C¦b¿Dªù¯S§O¦æ¬F°Ï´£¥Xªºµo©ú±M§Q©µ¦ù¥Ó½Ð¤§§å¥Ü¡A¨Ã«ö·Ó¦P¤@ªk³W²Ä¤G¦Ê¤C¤Q¤±ø¦Ü²Ä¤G¦Ê¤C¤Q¤C±øªº³W©w¡A¥i©ó¥»¤½§G¤é°_p¤@Ó¤ë´Á¤º´N¤U¦C§å¥Ü¦Vªì¯Åªk°|´£°_¤W¶D¡C
¤w±ÂÅvµo©ú±M§Qªº©µ¦ù
[21] ½s¸¹ : J/008499
[22] ¥Ó½Ð¤é : 2024/08/14
[24] §å¥Ü¤é : 2025/07/29
[73] Åv§Q¤H : ªk°ê¦å²G¾÷ºc
¦a§} : 20 Avenue Du Stade De France 93218 La Plaine Saint Denis Cedex, France
°êÄy : ªk°ê
[73] Åv§Q¤H : °ê®a°·±d»PÂå¾Ç¬ã¨s°|
¦a§} : 101, Rue De Tolbiac, 75654 Paris Cedex 13, France
°êÄy : ªk°ê
[73] Åv§Q¤H : ¨©®áªQ¤j¾ÇªþÄÝÂå°|
¦a§} : 3 Boulevard Alexandre Fleming-25000 Besançon, France
°êÄy : ªk°ê
[73] Åv§Q¤H : ¥±®Ô¤°-¤Õ®õ¤j¾Ç
¦a§} : 1 Rue Claude Goudimel 25000 Besancon, France
°êÄy : ªk°ê
[72] µo©ú¤H : §J¨½´µ¦«¤Ò¡D¶O®Ô, º¿ÄR®R¡D¼w©|, ªk¥¬¨½´µ¡D©Ô¬¥ÂÄ
°ê®aª¾ÃѲ£Åv§½µo©ú±M§Q : ±M§Q¸¹N.º de patente ZL201880075795.9¡A¥Ó½Ð¤éData de pedido 2018/11/14¡A±ÂÅv¤½§i¸¹N.º de anúncio da concessão CN 111712517B¡A2024/05/14
[51] ¤ÀÃþ : C07K16/28, C07K14/715, A61K39/00
[54] ¼ÐÃD : ¹v¦VIL-1RAPªºCAR-T²ÓM¤Î¥¦Ìªº¥Î³~¡C
[57] ºKn : ¥»µo©ú¯A¤Î¡G½s½X´O¦X§Üì¨üÅé¡]CAR¡^ªº¤ÀÂ÷ªº®Ö»Ä¤À¤l¡A¨ä¤¤¡A©ÒzCAR¥]§t§ÜÅé©Î§ÜÅé¤ù¬q¡A©ÒzCAR¥]§t§ÜIL-1RAPµ²¦Xµ²ºc°ì¡F¥Ñ¸Ó®Ö»Ä¤À¤l½s½Xªº¦h肽¡F¥]§t¦¹Ãþ§ÜÅé©Î§ÜÅé¤ù¬qªº¤ÀÂ÷ªº´O¦X§Üì¨üÅé¡]CAR¡^¤À¤l¡F¥]§t½s½XCARªº®Ö»Ä¤À¤lªº¸üÅé¡F¥H¤Î¥]§t©Òz¸üÅ骺T²ÓM¡C¥»µo©úÁÙ¯A¤Î¸Óªí¹FCAR¤À¤lªºT²ÓM¡]¦ÛÅé©Î¦PºØ²§Åé¡^ªvÀø÷¨Å°Êª«ªº¼W´Þ©Ê¯e¯fªº¥Î³~¡C
[30] Àu¥ýÅv : 2017/11/23¡A¼Ú¬wÁp·ù União Europeia¡A½s¸¹N.º 17306630.9
[21] ½s¸¹ : J/009279
[22] ¥Ó½Ð¤é : 2025/03/11
[24] §å¥Ü¤é : 2025/07/29
[73] Åv§Q¤H : ·ç¿A®¦»sÃĤ½¥q
¦a§} : 777 Old Saw Miller River Road, Tarrytown, New York 10591, USA
°êÄy : ¬ü°ê
[72] µo©ú¤H : X¡D¤ý, Y¡D¶À, W¡D¤ý, Q¡D»¯
°ê®aª¾ÃѲ£Åv§½µo©ú±M§Q : ±M§Q¸¹N.º de patente ZL201980025487.X¡A¥Ó½Ð¤éData de pedido 2019/02/18¡A±ÂÅv¤½§i¸¹N.º de anúncio da concessão CN 112119464B¡A2024/12/13
[51] ¤ÀÃþ : G16B20/30
[54] ¼ÐÃD : ¥Î©óMHC肽µ²¦X¹w´úªºGAN-CNN¡C
[57] ºKn : ¥»µo©ú¤½¶}¤F¥Î©óµ²¦X¨÷¿n¯«¸gºôµ¸¡]CNN¡^¨Ó°V½m¥Í¦¨¹ï§Üºôµ¸¡]GAN¡^ªº¤èªk¡C©ÒzGAN©M©ÒzCNN¥i¥H¨Ï¥Î½Ñ¦p³J¥Õ½è¬Û¤¬§@¥Î¼Æ¾Úªº¥Íª«¾Ç¼Æ¾Ú¨Ó°V½m¡C©ÒzCNN¥i¥H¥Î©ó±N·s¼Æ¾Úų©w¬°¥¿ªº©Îtªº¡C¥»µo©ú¤½¶}¤F¥Î©ó¦X¦¨»P³Qų©w¬°¥¿ªº·s³J¥Õ½è¬Û¤¬§@¥Î¼Æ¾Ú¬ÛÃöÁpªº¦h肽ªº¤èªk¡C
ªþ¹Ï :

[30] Àu¥ýÅv : 2018/02/17¡A¬ü°ê Estados Unidos da América¡A½s¸¹N.º 62/631,710
[21] ½s¸¹ : J/009376
[22] ¥Ó½Ð¤é : 2025/04/03
[24] §å¥Ü¤é : 2025/07/29
[73] Åv§Q¤H : ¬ü°Ç´µ¤½¥q
¦a§} : Uppsalalaan 17, 3e en 4e verdieping, 3584 CT Utrecht, The Netherlands
°êÄy : ²üÄõ
[72] µo©ú¤H : ¶ë¦è§Q¨È¡D¦w®R¡D«Â·G©ú®R¡D¼ö©µ GEUIJEN, Cecilia Anna Wilhelmina, ¯S¨½´µ©Z¡D¸ô©ö´µ¡D¦N®¦¡D¥[µÜ¯Ç GALLENNE, Tristan Louis Jean, °¨§J¡D«äù´µ¤ñ THROSBY, Mark, ¬ì¤º§Q´µ¡Dªü¼w¨½¦w¡D¼w§J§f¤Ò DE KRUIF, Cornelis Adriaan
°ê®aª¾ÃѲ£Åv§½µo©ú±M§Q : ±M§Q¸¹N.º de patente ZL202210129458.1¡A¥Ó½Ð¤éData de pedido 2020/02/13¡A±ÂÅv¤½§i¸¹N.º de anúncio da concessão CN 114426578B¡A2025/03/21
[51] ¤ÀÃþ : C07K16/28, C07K16/32, A61K39/395, A61P35/00
[54] ¼ÐÃD : 结¦XEGFR¡BHER2¤ÎHER3ªº结¦X³¡¤Àªº组¦X¡C
[57] ºKn : ¥»µo©ú¯A¤Îµ²¦XEGFR¡BHER2¤ÎHER3ªºµ²¦X³¡¤Àªº²Õ¦X¡A§ó¨ãÅé¦a´£¨Ñ¤@ºØ¥]¬A¨âөΧó¦hÓµ²¦X³¡¤Àªº²Õ¦Xª«¡A¨ä¤¤©Òzµ²¦X³¡¤À¤¤ªº¨C¤@Óµ²¦X³¡¤À¥]¬Aµ²¦X¦ÜEGFRªº²ÓM¥~³¡¤Àªº¥iÅܵ²ºc°ì¡F¨Ã¥B¨ä¤¤©Òzµ²¦X³¡¤À¤¤ªº²Ä¤@µ²¦X³¡¤À¥]¬Aµ²¦X¦ÜHER2ªº²ÓM¥~³¡¤Àªº¥iÅܵ²ºc°ì¡A¨Ã¥B©Òzµ²¦X³¡¤À¤¤ªº²Ä¤Gµ²¦X³¡¤À¥]¬Aµ²¦X¦ÜHER3ªº²ÓM¥~³¡¤Àªº¥iÅܵ²ºc°ì¡C¥»µo©úÁÙ¯A¤Î¥Î©ó¥Í¦¨²Õ¦Xª«¥H¤Î¥Î©Òz²Õ¦Xª«¨ÓªvÀøÓÅ骺¸Ë¸m©M¤èªk¡C
ªþ¹Ï :

[30] Àu¥ýÅv : 2019/02/14¡A¼Ú¬wÁp·ù União Europeia¡A½s¸¹N.º 19157302.1
2019/06/05¡A¼Ú¬wÁp·ù União Europeia¡A½s¸¹N.º 19178564.1
[21] ½s¸¹ : J/009382
[22] ¥Ó½Ð¤é : 2025/04/09
[24] §å¥Ü¤é : 2025/07/29
[73] Åv§Q¤H : ®¦µø±±ªÑ¦³¤½¥q
¦a§} : Suite 3.02, Level 3, Lakes Business Park, 2A Lord Street, Botany, Sydney, New South Wales, 2019, Australia
°êÄy : ¿D¤j§Q¨È
[73] Åv§Q¤H : ¦ë®õ¥ú¾ÇªÑ¥÷¦³¤½¥q
¦a§} : 6th Floor, Number 150, Section 4, Chengde Road, Shilin District, Taipei City, 11167, Taiwan, China
[72] µo©ú¤H : ©Ôºû¡D¿ú¼w©Ô¡D¤Ú¥d©Ô¦¶ BAKARAJU, Ravi Chandra, §J³Ò´µ¡D®Jº¸°Ò EHRMANN, Klaus, ªk¤ñ¦w¡D±d©Ô¼w CONRAD, Fabian
°ê®aª¾ÃѲ£Åv§½µo©ú±M§Q : ±M§Q¸¹N.º de patente ZL202080067307.7¡A¥Ó½Ð¤éData de pedido 2020/09/23¡A±ÂÅv¤½§i¸¹N.º de anúncio da concessão CN 114667477B¡A2025/01/10
[51] ¤ÀÃþ : G02C7/04
[54] ¼ÐÃD : ¥Î©óªñµøºÞ²zªº±µÄ²³zÃè¸Ñ¨M¤è®×¡C
[57] ºKn : ¥»¤½¶}¯A¤Î¥Î©ó»P±w¦³²´¶bªø«×¬ÛÃöªº¯e¯f¤ñ¦pªñµøªº²´·ú¤@°_¨Ï¥Îªº±µÄ²³zÃè¡C¥»µo©ú¯A¤Î¤@ºØ¥Î©óºÞ²z²´·úªºªñµøªº±µÄ²³zÃè¡F¨ä¤¤¡A±µÄ²³zÃè°t¸m¦³¡G¥ú¾Ç°Ï¡A¸Ó¥ú¾Ç°Ï³Q©w¦¨°ò¥»¤WÃö©ó¸Ó±µÄ²³zÃ誺¥ú¶b©w¤¤¤ß¡A¸Ó¥ú¾Ç°Ï¥Î¥H¬°²´·ú´£¨Ñ°ò¥»¤WÀô¦±±ªº©Î´²¥úªº¤è¦V©Ê´£¥Ü¡F¥H¤Î³ò¶¥ú¾Ç°Ïªº«D¥ú¾Ç©PÃä¸üÅé°Ï¡A¸Ó«D¥ú¾Ç©PÃä¸üÅé°Ï°t¸m¦³°ò¥»¤W±ÛÂà¹ïºÙªº«p«×½ü¹ø¡A¥H¶i¤@¨B´£¨Ñ¦b®É¶¡¤W©MªÅ¶¡¤WÅܤƪº°±¤î«H¸¹¡A¶i¦Ó´îºC¡B§ïµ½¡B±±¨î¡B§í¨î©Î°§CªñµøÀHµÛ®É¶¡ªº¶i®i³t²v¡C
ªþ¹Ï :

[30] Àu¥ýÅv : 2019/09/25¡A¿D¤j§Q¨È Austrália¡A½s¸¹N.º 2019903580
2020/02/14¡A¿D¤j§Q¨È Austrália¡A½s¸¹N.º 2020900412
[21] ½s¸¹ : J/009384
[22] ¥Ó½Ð¤é : 2025/04/09
[24] §å¥Ü¤é : 2025/07/29
[73] Åv§Q¤H : ·s³ÍªvÀø¦³¤½¥q
¦a§} : 303A College Road East, Princeton, New Jersey 08540, U.S.A.
°êÄy : ¬ü°ê
[72] µo©ú¤H : S¡D³Õº¸Âĸ¦¨È BORSADIA, SURESH, K¡D©¬¯Sº¸ PATEL, KALPANA, K¡D©Ô¥Ëº¸ RAVAL, KRUNAL
°ê®aª¾ÃѲ£Åv§½µo©ú±M§Q : ±M§Q¸¹N.º de patente ZL202080093996.9¡A¥Ó½Ð¤éData de pedido 2020/11/23¡A±ÂÅv¤½§i¸¹N.º de anúncio da concessão CN 115003289B¡A2025/01/10
[51] ¤ÀÃþ : A61K31/05, A61K31/352, A61K31/4045
[54] ¼ÐÃD : ¤j³Â¤G×ô©M/©Î¦Ò¤ñ¥q¥LÁp¦XÃĪ«Àøªk¡C
[57] ºKn : ¤½¶}¤F¥]§t¤j³Â¤G×ô©M¤@©Î¦hºØ¤Æ¦Xª«ªº²Õ¦Xª«¡A©Òz¤@©Î¦hºØ¤Æ¦Xª«¬OCYP2C19©MCYP3A4酶ªº§í¨î¾¯¡CÁÙ´£¨Ñ¤F¨Ï¥Î¦¹Ãþ²Õ¦Xª«ªvÀø¯kµh¡BÅöíw¡BºÎ¯vé¹Ü¡B¹Ã¦R¡Bäú¤ß¡Bºë¯«¯f¡BµJ¼{¡B§íÆ{¡B¹B°Ê»Ùê©M¨ä¥¦¯«¸gºë¯«¯f¾Ç©Î¯«¸g·½©Ê¯e¯fªº¤èªk¡C´£¨Ñ¥]§t¦Ò¤ñ¥q¥L©Î¨äÃľǤW¥i±µ¨üªº²§ºcÅé¡BÆQ©M/©Î·»¾¯¤Æª«¡F©M¦Ü¤Ö¤@ºØ¥ÑCYP2C19©M¥ô¿ï¦aCYP3A4¥NÁªºªvÀø¾¯ªº²Õ¦Xª«¡CÁÙ´£¨Ñ¤F¥Î©ó§í¨î¦³»Ýnªº±wªÌÅ餺ªºCYP2C19©M¥ô¿ï¦aCYP3A4ªº¤èªk¡A¨ä¥]§t¦V©Òz±wªÌ¬I¥Î¦³®Ä§í¨î©Òz±wªÌÅ餺ªºCYP2C19©M¥ô¿ï¦aCYP3A4ªº¶qªº¦Ò¤ñ¥q¥L©Î¨äÃľǤW¥i±µ¨üªº²§ºcÅé¡BÆQ©M/©Î·»¾¯¤Æª«¡C
[30] Àu¥ýÅv : 2019/11/21¡A¬ü°ê Estados Unidos da América¡A½s¸¹N.º 62/938,877
[21] ½s¸¹ : J/009410
[22] ¥Ó½Ð¤é : 2025/04/22
[24] §å¥Ü¤é : 2025/07/29
[73] Åv§Q¤H : ¯]®ü¾îµ^·R©i´µ©Z¥Íª«¬ì§Þ¦³¤½¥q
¦a§} : ¼sªF¬Ù¯]®ü¥«¾îµ^·s°ÏÀô®qªF¸ô1889¸¹¾îµ^³Ð·N¨¦3´É¡]²Ä¤T¼h·|ij«Ç°£¥~¡^
°êÄy : ¤¤°ê
[73] Åv§Q¤H : ·Ó¶}°ê»Ú¦³¤½¥q
¦a§} : ¿Dªù¬Ó´Â¤Ú¾¤µó«n©¤ªá¶é228¸¹AU¦a¾Q
°êÄy : ®Ú¾Ú¿Dªùªk¨Ò¦¨¥ß
[72] µo©ú¤H : ¦ó¸Î²Æ, ³¯³s§Ö, ¤ý¤p¤è, ¶À·Ó¶}, ·¨µµ·ì
°ê®aª¾ÃѲ£Åv§½µo©ú±M§Q : ±M§Q¸¹N.º de patente ZL202411177266.3¡A¥Ó½Ð¤éData de pedido 2024/08/26¡A±ÂÅv¤½§i¸¹N.º de anúncio da concessão CN 118902966B¡A2025/04/04
[51] ¤ÀÃþ : A61K8/98, A61Q19/00, C12N5/0775
[54] ¼ÐÃD : ·F²ÓM¥~ªcÅé²Õ¦Xª«¤Î¨ä»s³Æ¤èªk©MÀ³¥Î¡C
[57] ºKn : ¥»µo©ú¤½¶}¤FFL·F²ÓM¨Ó·½¶¡¥R½è¼Ë·F²ÓM¥~ªcÅé²Õ¦Xª«¤Î¨ä»s³Æ¤èªk©MÀ³¥Î¡F©Òz¥~ªcÅ鬰FL·F²ÓM¨Ó·½ªº¶¡¥R½è¼Ë·F²ÓM¥~ªcÅé¡C¥»µo©ú´¦¥Ü¤F¨Ó¦ÛFL·F²ÓMªº¶¡¥R½è¼Ë·F²ÓM¥~ªcÅé¹ï«P¶i²ÓM¼W´Þ¡B¾E²¾¨ã¦³ÅãµÛ§@¥Î¡C¥O¤H·N¥~ªº¬O¡A¦b0.18-0.22g/L©M0.38-0.42g/Lªº¯S©w¿@«×¤U¡A³o¨Ç¥~ªcÅéÅãµÛ¼W±j¤F¥Ö½§¦¨ÅÖºû²ÓMªº½¦ì³J¥Õªí¹F¡C¦¹¥~¡A¬ã¨sÁÙµo²{¡A¦b¬Û¦Pªº¥~ªcÅé¿@«×¤U¡AFL·F²ÓM¨Ó·½ªº¶¡¥R½è¼Ë·F²ÓM¥~ªcÅé¤ñÂÀ±a¶¡¥R½è·F²ÓM¥~ªcÅé§ó¦³®Ä¦a«P¶i¥Ö½§¦¨ÅÖºû²ÓMªº¾E²¾¡C³o¨Çµo²{¬°¶}µo·s«¬¥Ö½§×´_©M¦A¥ÍÀøªk´£¨Ñ¤F«nªº²z½×¨Ì¾Ú¡C
ªþ¹Ï :

[30] Àu¥ýÅv : 2023/09/12¡A¤¤°ê¤º¦a China¡A½s¸¹N.º 202311172772.9
[21] ½s¸¹ : J/009481
[22] ¥Ó½Ð¤é : 2025/05/16
[24] §å¥Ü¤é : 2025/07/29
[73] Åv§Q¤H : ¸â´Ë¥Íª«¬ì§Þ¤½¥q
¦a§} : 800/850 Ridgeview Drive, Horsham, PA 19044, USA
°êÄy : ¬ü°ê
[73] Åv§Q¤H : ªü©i´µ¯S¤¦¤j¾ÇÂå¾Ç¤¤¤ß°òª÷·|
¦a§} : De Boelelaan 1117, 1081 HV Amsterdam, (NL)
°êÄy : ²üÄõ
[72] µo©ú¤H : H¡D¨È·í´µ, F¡D°ª¼w¯S, K¡D¥±¹p¨½©_´µ, N¡DS¼wªF¬ì, C¡Dºûº¸µÜ³Ç
°ê®aª¾ÃѲ£Åv§½µo©ú±M§Q : ±M§Q¸¹N.º de patente ZL201980038160.6¡A¥Ó½Ð¤éData de pedido 2019/05/15¡A±ÂÅv¤½§i¸¹N.º de anúncio da concessão CN 112368019B¡A2025/03/18
[51] ¤ÀÃþ : A61K39/395, A61P35/00, C07K16/28, C07K16/30, C07K16/46, C07K19/00
[54] ¼ÐÃD : ªvÀøÀù¯g¨Ã¼W±jT²ÓM«©w¦VªvÀø¾¯ªº¥\®Äªº¤èªk¡C
[57] ºKn : ¥»¤½¶}´£¨Ñ¤FªvÀø¨ü¸ÕªÌªºÀù¯g©M/©Î±þ¶Ë¸~½F²ÓMªº¤èªk¡A¸Ó¤èªk¥]¬A¦V©Òz¨ü¸ÕªÌ¬I¥ÎªvÀø¦³®Ä¶qªº§ÜCD38§ÜÅé©MT²ÓM«©w¦VªvÀø¾¯¥HªvÀø©ÒzÀù¯g¡C¥»¤½¶}´£¨Ñ¤F¤@ºØ¼W±jT²ÓM«©w¦VªvÀø¾¯¦b±w¦³Àù¯gªº¨ü¸ÕªÌ¤¤ªº¥\®Äªº¤èªk¡A¸Ó¤èªk¥]¬A¦V©Òz¨ü¸ÕªÌ¬I¥Î§ÜCD38§ÜÅé¡C¥»¤½¶}ÁÙ´£¨Ñ¤F¤@ºØªvÀø¨ü¸ÕªÌªº¦hµo©Ê°©Åè½Fªº¤èªk¡A¸Ó¤èªk¥]¬A¦V©Òz¨ü¸ÕªÌ¬I¥ÎªvÀø¦³®Ä¶qªºBCMA¡ÑCDSÂù¯S²§©Ê§ÜÅé©M§ÜCD38§ÜÅé¥HªvÀø©Òz¦hµo©Ê°©Åè½F¡C¥»¤½¶}ÁÙ´£¨Ñ¤F¤@ºØ¥]§tGPRC5D¡ÑCD3Âù¯S²§©Ê§ÜÅ骺ÃĪ«²Õ¦X¡C¥»¤½¶}ÁÙ´£¨Ñ¤F¤@ºØ¥]§tÃĪ«²Õ¦Xª«ªº¸Õ¾¯²°¡A©ÒzÃĪ«²Õ¦Xª«¥]§tBCMA¡ÑCD3Âù¯S²§©Ê§ÜÅé©M§ÜCD38§ÜÅé¡C
ªþ¹Ï :

[30] Àu¥ýÅv : 2018/05/16¡A¬ü°ê Estados Unidos da América¡A½s¸¹N.º 62/672222
2018/09/26¡A¬ü°ê Estados Unidos da América¡A½s¸¹N.º 62/736804
2019/05/02¡A¬ü°ê Estados Unidos da América¡A½s¸¹N.º 62/842080
[21] ½s¸¹ : J/009484
[22] ¥Ó½Ð¤é : 2025/05/19
[24] §å¥Ü¤é : 2025/07/29
[73] Åv§Q¤H : ¼sªFÃĬì¤j¾Ç
¦a§} : ¤¤°ê¼sªF¬Ù¼s¦{¥«µf¬ë°Ï¼s¦{¤j¾Ç«°¥~ÀôªF¸ô280¸¹
°êÄy : ¤¤°ê
[73] Åv§Q¤H : ±d¥¿°ê»Ú¦³¤½¥q
¦a§} : Flat 1106, 11/F, The Metropolis Tower, 10 Metropolis Drive, Hung Hom, Kl, Hong Kong
°êÄy : ®Ú¾Ú»´äªk¨Ò¦¨¥ß
[72] µo©ú¤H : ¨v³·, ¤ý¦|, °¨«ä»·, ¤ý¼ÖµX, ³¯±Ò¤å
°ê®aª¾ÃѲ£Åv§½µo©ú±M§Q : ±M§Q¸¹N.º de patente ZL202410936763.0¡A¥Ó½Ð¤éData de pedido 2024/07/12¡A±ÂÅv¤½§i¸¹N.º de anúncio da concessão CN 118634301B¡A2025/02/25
[51] ¤ÀÃþ : A61K36/9066, A61P1/00, A61P1/04, A23L33/105, A23L33/10, A23L33/16, A61K33/00, A61K35/618
[54] ¼ÐÃD : ¤¤ÃĽƤè¤Î¨ä¦b»s³Æ¨¾ªvGÂH½¤·l¶Ë²£«~¤¤ªºÀ³¥Î¡C
[57] ºKn : ¥»µo©úÄÝ©ó¤¤Ãħ޳N»â°ì¡A¤½¶}¤F¤@ºØ¤¤ÃĽƤè¤Î¨ä¦b»s³Æ¨¾ªvGÂH½¤·l¶Ë²£«~¤¤ªºÀ³¥Î¡A©ÒzÀ³¥Î¬°¤¤ÃĽƤè¦b»s³Æ¥Î©ó³q¹L½Õ¸`ª¢¯g²ÓM¦]¤l°§CªvÀø¯e¯fªº²£«~¤¤ªºÀ³¥Î¡B¤¤ÃĽƤè¦b»s³Æ¥Î©ó¹w¨¾©M¡þ©ÎªvÀøGÂH½¤·l¶Ë²£«~¤¤ªºÀ³¥Î¥H¤Î¤¤ÃĽƤè¦b»s³Æ³q¹L×´_GÂH½¤·l¶ËªvÀø¯e¯fªº²£«~¤¤ªºÀ³¥Î¡C©Òz¤¤ÃĽƤè¥]¬A¦p¤U²Õ¤À¡G¤B»¡BÁ¤¶À¡BµUÀYÛ£¡BµU¨àÀô¡B®üî_ÀT¡BÁ¡²ü©MºÒ»Ä²B¶u¡C¹êÅçÃÒ©ú¡A¥»µo©úªº¤¤ÃĽƤè¥i¨Ï¤j¹«¦å²M¤¤CRP¡BIL-6¡BPGE2¤ÎTNF-£\µ¥ª¢¯g²ÓM¦]¤l¤ô¥°§C¡A¦P®É¡A¤É°ª¦å²M¤¤SOD§t¶q¤ô¥¡A¤U°MDA§t¶q¤ô¥¡A¹ïGÂH½¤·l¶Ë¨ã¦³¸û¦nªº«OÅ@§@¥Î¡C
ªþ¹Ï :

[21] ½s¸¹ : J/009495
[22] ¥Ó½Ð¤é : 2025/05/23
[24] §å¥Ü¤é : 2025/07/29
[73] Åv§Q¤H : ªü}°¨¥¬¦³³d¥ô¤½¥q
¦a§} : 7 Lucent Drive, Lebanon, New Hampshire 03766, USA
°êÄy : ¬ü°ê
[72] µo©ú¤H : J¡D»\®Ú GEOGHEGAN, James, B¡D´¶ªL¯ý PRINZ, Bianka, R¡D¨Ø«¢º¸ PEJCHAL, Robert
°ê®aª¾ÃѲ£Åv§½µo©ú±M§Q : ±M§Q¸¹N.º de patente ZL202080033843.5¡A¥Ó½Ð¤éData de pedido 2020/06/08¡A±ÂÅv¤½§i¸¹N.º de anúncio da concessão CN 114144437B¡A2025/02/25
[51] ¤ÀÃþ : C07K16/30, C07K16/28, C07K16/32
[54] ¼ÐÃD : ¤uµ{¤ÆªºpH¨Ì¿à©Ê§ÜCD3§ÜÅé¤Î¨ä²£¥Í©M¨Ï¥Î¤èªk¡C
[57] ºKn : ´£¨Ñ¤F¯S§O¬O¨ã¦³´Á±æªºT²ÓM¬¡¤Æ©M¡]«·s¡^¤Þ¾Éªº¹v²ÓM±þ¶Ë®Ä¤O©M¥i¶}µo©Ê·§ªpªº¤uµ{¤ÆªºpH¨Ì¿à©Ê§ÜCD3µ²¦Xµ²ºc°ì¥H¤Î¥]§t¨äªº§ÜÅé©M/©Î§Üìµ²¦Xµ²ºc°ì¡A¥]¬A¦h¯S²§©Ê§ÜÅé¡F¥H¤Î¥¦ÌªºÅ³©w¡B¤ÀÂ÷©M²£¥Í¤èªk¡F¥H¤Î¥¦Ìªº»s³Æ©M¨Ï¥Î¤èªk¡C
ªþ¹Ï :

[30] Àu¥ýÅv : 2019/06/07¡A¬ü°ê Estados Unidos da América¡A½s¸¹N.º 62/858,968
[21] ½s¸¹ : J/009503
[22] ¥Ó½Ð¤é : 2025/05/27
[24] §å¥Ü¤é : 2025/07/29
[73] Åv§Q¤H : ¬ü°Ç´µ¤½¥q
¦a§} : Uppsalalaan 17, 3e en 4e verdieping, 3584 CT Utrecht, The Netherlands
°êÄy : ²üÄõ
[72] µo©ú¤H : ¬ì¤º§Q´µ¡Dªü¼w¨½¦w¡D¼w§J§f¤Ò DE KRUIF, Cornelis, Adriaan, ªL¹F¡D¬ù¿«®R¡DªüµÜ¹F¡D¦ë¼w¨½§J´µ HENDRIKS, Linda, Johanna, Aleida, ´°¡D¬¥®æ¼ð§B®æ LOGTENBERG, Ton
°ê®aª¾ÃѲ£Åv§½µo©ú±M§Q : ±M§Q¸¹N.º de patente ZL202111365429.7¡A¥Ó½Ð¤éData de pedido 2013/04/19¡A±ÂÅv¤½§i¸¹N.º de anúncio da concessão CN 114163530B¡A2025/04/29
[51] ¤ÀÃþ : C07K16/30, C07K16/28, C12N5/10, A61K39/395
[54] ¼ÐÃD : ¥Î©ó²£¥Í§K¬Ì²y³J¥Õ¼Ë¤À¤lªº¤èªk©M¤â¬q¡C
[57] ºKn : ¥»µo©ú¯A¤Î¥Î©ó²£¥Í§K¬Ì²y³J¥Õ¼Ë¤À¤lªº¤èªk©M¤â¬q¡C¥»µo©ú´£¨Ñ¤F¥Î©ó¦b³æÓ±J¥D²ÓM¤¤²£¥Í¤@ºØ©Î§ó¦hºØ§K¬Ì²y³J¥Õ¼Ë¤À¤lªº¤â¬q©M¤èªk¡C¤]´£¨Ñ¤F¯à°÷²£¥Í¥Øªº³æ¯S²§©Ê©M/©ÎÂù¯S²§©Ê§K¬Ì²y³J¥Õ¼Ë¤À¤lªº·sªºCH3¬ðÅÜ¡C
ªþ¹Ï :

[30] Àu¥ýÅv : 2012/04/20¡A¬ü°ê Estados Unidos da América¡A½s¸¹N.º 61/635,935
[21] ½s¸¹ : J/009520
[22] ¥Ó½Ð¤é : 2025/05/30
[24] §å¥Ü¤é : 2025/07/29
[73] Åv§Q¤H : ¥Íª«ÅçÃÒ¨t²ÎªÑ¥÷¤½¥q
¦a§} : Hochbergerstrasse 60c, C/o Technologiepark, CH-4057 Basel, Switzerland
°êÄy : ·ç¤h
[72] µo©ú¤H : S¡D¬¥°ò¯Qù, S¡D¤ñ©ù}, G¡DE¡DÀ¹º¸, M¡D¥¬Ã¹¯S, M¡D¦N¯S«C®æ
°ê®aª¾ÃѲ£Åv§½µo©ú±M§Q : ±M§Q¸¹N.º de patente ZL202080005144.X¡A¥Ó½Ð¤éData de pedido 2020/08/03¡A±ÂÅv¤½§i¸¹N.º de anúncio da concessão CN 113015519B¡A2025/03/28
[51] ¤ÀÃþ : A61K9/08, A61K31/439, A61K47/10, A61K47/12, A61K47/18, A61K47/22, A61K47/20, A61K47/04, A61P31/04
[54] ¼ÐÃD : §QºÖ¥¬¥ÅªvÀø¤èªk¡B¥Î³~©M²Õ¦Xª«¡C
[57] ºKn : ¤@ºØ§QºÖ¥¬¥Å½Õ°tª«¡A¨ä¦b»Ä¡B¤ô©M¾A¦X©ó«P¶i©Òz§QºÖ¥¬¥Å·»¸Ñªº·»¾¯ªº¦s¦b¤U¥Ñ§QºÖ¥¬¥Å¯»¥½¥Í²£¡C¤@ºØ»s³Æ§QºÖ¥¬¥Å½Õ°tª«ªº¤èªk¡A©Òz¤èªk¥]¬A¡G»s³Æ¥]¬A·»¾¯¡B¤ô©M»Äªº·»²G¡F©M±N©Òz·»²G¥[¤J§QºÖ¥¬¥Å¯»¥½¡A±q¦Ó¨Ï©Òz§QºÖ¥¬¥Å·»¸Ñ¦b©Òz·»²G¤¤¡C¤@ºØ»s³Æ§QºÖ¥¬¥Å½Õ°tª«ªº¤èªk¡A©Òz¤èªk¥]¬A¡G»s³Æ¥]¬A¤ô©M»Äªº·»²G¡F©M±N©Òz·»²G¥[¤J¦b¬Y¤@·»¾¯¤¤ªº§QºÖ¥¬¥Å·»²G¡A±q¦Ó¥Í²£¤ô©Ê§QºÖ¥¬¥Å½Õ°tª«¡C¤@ºØªvÀø¨ü¸ÕªÌ¤¤ªº²Óµß·P¬Vªº¤èªk¡A©Òz¤èªk¥]¬A¦b¥iª`®g½Õ°tª«¤¤©Î³q¹L§l¤J¬I¥ÎªvÀø¦³®Ä¶qªº§QºÖ¥¬¥Å¡C
ªþ¹Ï :

[30] Àu¥ýÅv : 2019/09/12¡A¬ü°ê Estados Unidos da América¡A½s¸¹N.º 62/899,257
2019/09/18¡A¬ü°ê Estados Unidos da América¡A½s¸¹N.º 62/902,019
2019/11/27¡A¬ü°ê Estados Unidos da América¡A½s¸¹N.º 62/941,160
[21] ½s¸¹ : J/009541
[22] ¥Ó½Ð¤é : 2025/06/10
[24] §å¥Ü¤é : 2025/07/29
[73] Åv§Q¤H : ¤sªF¥ýÁn¥Íª«»sÃĦ³¤½¥q
¦a§} : ¤¤°ê¤sªF¬Ù·Ï¥x¥«·Ï¥x¸gÀÙ§Þ³N¶}µo°Ï¶ÂÀs¦¿¸ô1¸¹¡A264000
°êÄy : ¤¤°ê
[72] µo©ú¤H : »¯·s¿P ZHAO, Xinyan, »¯¾å®p ZHAO, Xiaofeng, ¿c¤h±j LU, Shiqiang, ÃeµM PANG, Ran, §õøÊøÊ LI, Xinxin, ¥ô®Ê¥Í REN, Jinsheng
°ê®aª¾ÃѲ£Åv§½µo©ú±M§Q : ±M§Q¸¹N.º de patente ZL202080005657.0¡A¥Ó½Ð¤éData de pedido 2020/07/31¡A±ÂÅv¤½§i¸¹N.º de anúncio da concessão CN 112955470B¡A2025/03/11
[51] ¤ÀÃþ : C07K16/28, C12N15/13, A61K39/395, A61P35/00, A61P35/04
[54] ¼ÐÃD : §ÜTNFR2§ÜÅé¤Î¨ä¥Î³~¡C
[57] ºKn : ¤@ºØ¯à°÷¯S²§©Ê¦aµ²¦XTNFR2ªº§ÜÅé©Î¨ä§Üìµ²¦X¤ù¬q¡A©Òz§ÜÅé©Î¨ä§Üìµ²¦X¤ù¬q¯à°÷½Õ¸`§K¬Ì²ÓMªº¥\¯à¡A¥i§@¬°ÃĪ«ªvÀø»P§K¬Ì²§±`¦³Ãöªº¯e¯f¡A¨Ò¦p¸~½F¡C
ªþ¹Ï :

[30] Àu¥ýÅv : 2019/08/02¡A¤¤°ê¤º¦a China¡A½s¸¹N.º 201910713742.1
[21] ½s¸¹ : J/009548
[22] ¥Ó½Ð¤é : 2025/06/12
[24] §å¥Ü¤é : 2025/07/29
[73] Åv§Q¤H : »¨¤ÒÁÚ¡Dù¤ó¦³¤½¥q
¦a§} : Grenzacherstrasse 124, 4070 Basel, Switzerland
°êÄy : ·ç¤h
[72] µo©ú¤H : L¡DC¡D¦è»X´µ, N¡D¥¬Äõ¬ì¡D¶ð©Ô¸U
°ê®aª¾ÃѲ£Åv§½µo©ú±M§Q : ±M§Q¸¹N.º de patente ZL202080010293.5¡A¥Ó½Ð¤éData de pedido 2020/01/22¡A±ÂÅv¤½§i¸¹N.º de anúncio da concessão CN 113330027B¡A2025/03/28
[51] ¤ÀÃþ : C07K16/00, C07K16/46
[54] ¼ÐÃD : ¦b¯u®Ö±J¥D²ÓM¤¤²£¥Í¦h»EÅé³J¥Õ½èªº¤èªk¡C
[57] ºKn : ¥»¤½¶}¯A¤Î¦b¯u®Ö±J¥D²ÓM¤¤²£¥Í¦h»EÅé¦h肽¡]¨Ò¦p¡A¥]§t¨âөΧó¦hӨȰò¡A¨CӨȰò¥]§t¨â±ø©Î§ó¦h±ø¦h肽Ãì¡A½Ñ¦p¦h¯S²§©Ê©ÎÂù¯S²§©Ê§ÜÅé¡^¡C¦b¤@¨Ç¹ê¬I¨Ò¤¤¡A¥»¤å´£¨Ñ¨Ï¥Î¥]§t¦h®Ö苷»Äªº±J¥D²ÓM¦b¯u®Ö±J¥D²ÓM¤¤²£¥Í¦h»EÅé¦h肽ªº¤èªk¡A©Òz¦h®Ö苷»Ä¥]§t»P½s½X©Òz¦h»EÅé¦h肽ªº¨CÓ¦h肽ªº¶}©ñ¾\Ū®Ø¥i¾Þ§@¦a³s±µªºÂ½Ä¶°_©l§Ç¦C¡C¦³§Q¦a¡A¥»¤½¶}ÃÒ©ú¤F½Õ¸`»P¨CÓ¶}©ñ¾\Ū®Ø³s±µªºÂ½Ä¶°_©l§Ç¦Cªº±j«×¤¹³\¥H¦b§ó¤Ö¿ù»~²Õ¸Ëªº°Æ²£ª«ªº±¡ªp¤U¦h»EÅé¦h肽ªº§ó°ª²£¶q¡C¥»¤½¶}¶i¤@¨B´£¨Ñ»P¨ä¬ÛÃöªº²ÓM¡B¿z¿ï¤èªk©M¸Õ¾¯²°¡C
ªþ¹Ï :

[30] Àu¥ýÅv : 2019/01/23¡A¬ü°ê Estados Unidos da América¡A½s¸¹N.º 62/796,014
[21] ½s¸¹ : J/009549
[22] ¥Ó½Ð¤é : 2025/06/12
[24] §å¥Ü¤é : 2025/07/29
[73] Åv§Q¤H : ÆQ³¥¸q»sÃĮ覡·|ªÀ
¦a§} : ¤é¥»¤j¨Á©²¤j¨Á¥«¤¤¥¡°Ï¹D×Ëm3¤B¥Ø1µf8¸¹
°êÄy : ¤é¥»
[72] µo©ú¤H : ¤ô¨¦ª½¤], ´Ë¥»¨j¨É, ©£³¡¯u§Æ, ¥ìÃÃ¥¿®Ì, ¤ì§ø»¨
°ê®aª¾ÃѲ£Åv§½µo©ú±M§Q : ±M§Q¸¹N.º de patente ZL201980038190.7¡A¥Ó½Ð¤éData de pedido 2019/04/23¡A±ÂÅv¤½§i¸¹N.º de anúncio da concessão CN 112236146B¡A2025/04/15
[51] ¤ÀÃþ : A61K31/53, A61K9/20, A61K47/02, A61K47/04, A61K47/14, A61K47/22, A61K47/26, A61K47/38, A61P31/16
[54] ¼ÐÃD : éw©ÊÀu¨}ªº©TÅé»s¾¯¡C
[57] ºKn : ¥»µo©ú´£¨Ñ¤@ºØ©TÅé»s¾¯¡A¨ä§t¦³¦¡¡]I¡^©Ò¥Ü¤Æ¦Xª«©Î¨äÃľǤW¥i±µ¨üªºÆQ¡Béw¾¯¡B¿}¾J¤Î/©Î¿}Ãþ¡B¤ô·»©Ê»E¦Xª«¡B¥H¤ÎµL¾÷ª«¡A«ez©TÅé»s¾¯ªºÃ©w©Ê¡B¤ô¤¤Äa¯B©Ê¤Î¬y°Ê©Ê¨}¦n¡C
ªþ¹Ï :

[30] Àu¥ýÅv : 2018/04/24¡A¤é¥» Japão¡A½s¸¹N.º 2018-083006
[21] ½s¸¹ : J/009550
[22] ¥Ó½Ð¤é : 2025/06/12
[24] §å¥Ü¤é : 2025/07/29
[73] Åv§Q¤H : ELC ºÞ²z¦³³d¥ô¤½¥q
¦a§} : 155 Pinelawn Road, Suite 345 South, Melville, NY 11747, USA
°êÄy : ¬ü°ê
[72] µo©ú¤H : F¡D¿p¨uÀq¼w, A¡D¬dº¸¿Õ¶ð
°ê®aª¾ÃѲ£Åv§½µo©ú±M§Q : ±M§Q¸¹N.º de patente ZL202080104039.1¡A¥Ó½Ð¤éData de pedido 2020/06/11¡A±ÂÅv¤½§i¸¹N.º de anúncio da concessão CN 116034099B¡A2025/04/29
[51] ¤ÀÃþ : C07C67/60, A61Q19/00, A61K8/37, C07C69/94
[54] ¼ÐÃD : ¥ÕòÔξJ¤A¾J»Äà©M°s¥Û»Äàl¥Íª«ªº¼W·»¡C
[57] ºKn : ¤½¶}¤F¤@ºØ³q¹L¥[¼ö¥ÕòÔξJ¤A¾J»Äà©M±N¥ÕòÔξJ¤A¾J»Äà»P¤@ºØ©Î¦hºØ¤G¾J²V¦X¦Ó¼W·»¥ÕòÔξJ¤A¾J»Äà¤Æ¦Xª«ªº¤èªk©Î¤uÃÀ¡C
ªþ¹Ï :

[21] ½s¸¹ : J/009552
[22] ¥Ó½Ð¤é : 2025/06/13
[24] §å¥Ü¤é : 2025/07/29
[73] Åv§Q¤H : ·ç¹|ÂåÃĤ½¥q
¦a§} : ¬ü°ê°¨ÂĽѶë¦{ªi¤h¹y¥«®ü´ä¤j¹D121¸¹
°êÄy : ¬ü°ê
[72] µo©ú¤H : ¤p¥¬¾|´µ¡DA¡D¦w¼w¨½¦w, D¡DL¡DÁ¨½¤¦, P¡DP¡D©Z¥¬·ç¥§
°ê®aª¾ÃѲ£Åv§½µo©ú±M§Q : ±M§Q¸¹N.º de patente ZL202110517494.0¡A¥Ó½Ð¤éData de pedido 2015/03/06¡A±ÂÅv¤½§i¸¹N.º de anúncio da concessão CN 113416254B¡A2025/05/09
[51] ¤ÀÃþ : C07K16/40
[54] ¼ÐÃD : ¨ã¦³§ïµ½ªºÃĪ«°Ê¤O¾Çªº§ÜC5§ÜÅé¡C
[57] ºKn : ¥»µo©ú´£¨Ñ¤×¨ä¾A¥Î©ó§í¨î¥½ºÝ¸ÉÅé¡]¨Ò¦pC5b-9TCCªº²Õ¸Ë©M/©Î¬¡©Ê¡^©MC5a¹L±Ó¬r¯À¤¶¾É©Êµoª¢¥B±q¦ÓªvÀø¸ÉÅé¬ÛÃö¯f¯gªº§ÜÅé¡C¬Û¹ï©ó¦ã®w²Õ³æ§Ü¡]eculizumab¡^¡A©Òz§ÜÅ骺¦hºØ¯S©Ê§ïµ½¡A¥]¬A¨Ò¦p¦b¤HÅ餤ªº¦å²M¥b°I´Á©µªø¡C
ªþ¹Ï :

[30] Àu¥ýÅv : 2014/03/07¡A¬ü°ê Estados Unidos da América¡A½s¸¹N.º 61/949,932
[21] ½s¸¹ : J/009553
[22] ¥Ó½Ð¤é : 2025/06/16
[24] §å¥Ü¤é : 2025/07/29
[73] Åv§Q¤H : LIB ÀøªkªÑ¥÷¦³¤½¥q
¦a§} : 5335 Medpace Way. Cincinnati Oh 45227 USA
°êÄy : ¬ü°ê
[72] µo©ú¤H : T¡DS¡D¦Ì¤Áº¸ MITCHELL, Tracy, S., ²z¬d¼w¡D¦Ì¹p MEALEY, Richard
°ê®aª¾ÃѲ£Åv§½µo©ú±M§Q : ±M§Q¸¹N.º de patente ZL201980047552.9¡A¥Ó½Ð¤éData de pedido 2019/05/16¡A±ÂÅv¤½§i¸¹N.º de anúncio da concessão CN 112423790B¡A2025/05/16
[51] ¤ÀÃþ : A61K47/64, C12N9/64
[54] ¼ÐÃD : ¥]§t结¦XPCSK9ªº¤À¤lªº组¦Xª«©M¨Ï¥Î¤èªk¡C
[57] ºKn : ¥»¤½¶}´£¨Ñ¤F¥]§t°ò©óÅÖ³s³J¥Õªº¤ä¬[µ²ºc°ì³J¥ÕªºÃĪ«²Õ¦Xª«¡A©Òz°ò©óÅÖ³s³J¥Õªº¤ä¬[µ²ºc°ì³J¥Õµ²¦X¨Ò¦p«e³J¥ÕÂà¤Æ酶¬\¯ó±ìµß³J¥Õ酶kexin-9¡]PCSK9¡^¡C
ªþ¹Ï :

[30] Àu¥ýÅv : 2018/05/16¡A¬ü°ê Estados Unidos da América¡A½s¸¹N.º 62/672,187
[21] ½s¸¹ : J/009554
[22] ¥Ó½Ð¤é : 2025/06/16
[24] §å¥Ü¤é : 2025/07/29
[73] Åv§Q¤H : ¤s¦èÀAªi¥Íª«ÂåÃĪѥ÷¦³¤½¥q
¦a§} : ¤¤°ê¤s¦è¬Ù¤Ó쥫¤s¦èºî§ï¥Ü½d°Ï¤Óìðºi¶é°ÏÀAªiµó18¸¹ 030032
°êÄy : ¤¤°ê
[72] µo©ú¤H : ±i¥Ã°· ZHANG, Yongjian, Äõ¤p»« LAN, Xiaobin, ¤ý¬Â¬Â WANG, Lingling, ·¨Áø YANG, Xia
°ê®aª¾ÃѲ£Åv§½µo©ú±M§Q : ±M§Q¸¹N.º de patente ZL202310983181.3¡A¥Ó½Ð¤éData de pedido 2023/08/04¡A±ÂÅv¤½§i¸¹N.º de anúncio da concessão CN 116813751B¡A2025/03/21
[51] ¤ÀÃþ : C07K14/78, C12N15/70, C07K1/107, C12N15/12, C12N1/21, C12R1/19
[54] ¼ÐÃD : ¦Û¥æÁp«²Õ¤H·½¤Æ½¦ì³J¥Õ°ª¤À¤l¥Íª«§÷®Æ¤Î¨ä»s³Æ¤èªk¡C
[57] ºKn : ¥»µo©ú¯A¤Î¦Û¥æÁp«²Õ¤H·½¤Æ½¦ì³J¥Õ°ª¤À¤l¥Íª«§÷®Æ¤Î¨ä»s³Æ¤èªk¡C¥»µo©ú´£¨Ñ¤F¤@ºØ½¦ì³J¥Õ¦Û²Õ¸Ë¤¸¥ó¡A¨ä¥]§t¦pSEQ ID NO.1©Ò¥Üªº®ò°ò»Ä§Ç¦CªºCºÝªº¦Ü¤Ö21Ó³sÄòªº®ò°ò»Ä¡F©Î¦p¡]i¡^©Òzªº®ò°ò»Ä§Ç¦C¤¤¨ú¥N¡B¯Ê¥¢©Î²K¥[¤@өΦhÓ®ò°ò»Ä¡A¥B«O¯d«P¶i«²ÕIII«¬¤H·½¤Æ½¦ì³J¥Õ¦Û¥æÁp§Î¦¨¤TÁ³±Ûµ²ºcªº¥\¯àªº®ò°ò»Ä§Ç¦C¡F©Î»P¡]i¡^©Òzªº®ò°ò»Ä§Ç¦C¨ã¦³¦Ü¤Ö90%¡B92%¡B95%¡B96%¡B97%¡B98%©Î99%¦P¤@©Ê¡A¥B«O¯d«P¶i«²ÕIII«¬¤H·½¤Æ½¦ì³J¥Õ¦Û¥æÁp§Î¦¨¤TÁ³±Ûµ²ºcªº¥\¯àªº®ò°ò»Ä§Ç¦C¡C¸Ó¤¸¥ó¥i¥H¦³®Ä«P¶i«²ÕIII«¬¤H·½¤Æ½¦ì³J¥Õ¦Û¥æÁp§Î¦¨¤TÁ³±Ûµ²ºc¡C
ªþ¹Ï :

[21] ½s¸¹ : J/009556
[22] ¥Ó½Ð¤é : 2025/06/17
[24] §å¥Ü¤é : 2025/07/29
[73] Åv§Q¤H : ¯S¨F¿Õ¦³¤½¥q
¦a§} : Corporation Service Company, 251 Little Falls Drive, Wilmington, DE 19808, USA
°êÄy : ¬ü°ê
[72] µo©ú¤H : A¡OJ¡O´µ¹Ïº¸¯S, Y¡O¤ý, G¡O§d, J¡O¤¨
°ê®aª¾ÃѲ£Åv§½µo©ú±M§Q : ±M§Q¸¹N.º de patente ZL201980078366.1¡A¥Ó½Ð¤éData de pedido 2019/10/03¡A±ÂÅv¤½§i¸¹N.º de anúncio da concessão CN 113166071B¡A2025/03/21
[51] ¤ÀÃþ : C07D231/56, A61K31/454, A61P35/00
[54] ¼ÐÃD : ¥§©Ô©¬§QÆQ¡C
[57] ºKn : ´£¨Ñ¤F·s«¬¥§©Ô©¬§QªºÆQ¡CÁÙ´£¨Ñ¤F¥]§t¨º¨ÇÆQªºÃĪ«²Õ¦Xª«¡A¥H¤Î»P¤§¬ÛÃöªº¤èªk©M¥Î³~¡C
[30] Àu¥ýÅv : 2018/10/03¡A¬ü°ê Estados Unidos da América¡A½s¸¹N.º 62/740,872
[21] ½s¸¹ : J/009557
[22] ¥Ó½Ð¤é : 2025/06/17
[24] §å¥Ü¤é : 2025/07/29
[73] Åv§Q¤H : ¦B¬w¥Û¥Íª«¬ì§Þ¤½¥q
¦a§} : 760 Parkside Avenue, Room 213, Brooklyn, NY 11226, USA
°êÄy : ¬ü°ê
[72] µo©ú¤H : S±¶, Y¡O¿ú, W¡O¦ó, ¼B©V
°ê®aª¾ÃѲ£Åv§½µo©ú±M§Q : ±M§Q¸¹N.º de patente ZL202080092528.X¡A¥Ó½Ð¤éData de pedido 2020/04/13¡A±ÂÅv¤½§i¸¹N.º de anúncio da concessão CN 115003295B¡A2025/05/06
[51] ¤ÀÃþ : C07D311/00, A61K31/352, A61K31/353, A61K31/4035, C07D209/46, C07D311/20
[54] ¼ÐÃD : ¨ã¦³»Û¿E¯À¨üÅ鰸Ѭ¡©Êªº·s«¬¦âº¡l¥Íª«¤Î¨ä¥Î³~¡C
[57] ºKn : ¥»¤½¶}¯A¤Î·s¤Æ¦Xª«¡B§t¦³¦¹Ãþ¤Æ¦Xª«ªºÃĪ«²Õ¦Xª«¡A¥H¤Î¥¦Ì¦b¹w¨¾©MªvÀøÀù¯g¤Î¬ÛÃö¯e¯f©M¯f¯g¤¤ªº¥Î³~¡C
[30] Àu¥ýÅv : 2019/12/12¡A¬ü°ê Estados Unidos da América¡A½s¸¹N.º 62/947,213
[21] ½s¸¹ : J/009558
[22] ¥Ó½Ð¤é : 2025/06/17
[24] §å¥Ü¤é : 2025/07/29
[73] Åv§Q¤H : ²ö¦ò¶ë´µ¤½¥q
¦a§} : Semmelweisstrasse 7, 82152 Planegg, Germany
°êÄy : ¼w°ê
[72] µo©ú¤H : D¡D§J¶©§J KLUNKER, Daniel, R¡D³Õ§J´µ«¢Àq BOXHAMMER, Rainer, S¡D«¢¯Sº¸ HÄRTLE, Stefan, S¡D¬I®õ¼wº¸ STEIDL, Stefan, T¡D¨È¾|¶ð¯S JARUTAT, Tiantom
°ê®aª¾ÃѲ£Åv§½µo©ú±M§Q : ±M§Q¸¹N.º de patente ZL202080021080.2¡A¥Ó½Ð¤éData de pedido 2020/03/13¡A±ÂÅv¤½§i¸¹N.º de anúncio da concessão CN 113574071B¡A2025/03/25
[51] ¤ÀÃþ : C07K16/28, A61K39/00, A61P13/12
[54] ¼ÐÃD : ¥Î©óªvÀø¦Û¨§ÜÅ餶¾Éªº¦Û¨§K¬Ì¯e¯fªº§Ü-CD38§ÜÅé¤Î¨äÃĪ«²Õ¦Xª«¡C
[57] ºKn : ¥»µo©ú¯A¤Î¹ïCD38¨ã¦³¯S²§©Êªº§ÜÅé©Î§ÜÅé¤ù¬q¦b¹w¨¾©M/©ÎªvÀø¦Û¨§ÜÅ餶¾Éªº¦Û¨§K¬Ì¯f¤¤ªº¥Î³~¡C®Ú¾Ú¥»µo©ú¡A§Ü-CD38§ÜÅé¥i¦³®ÄªvÀø§Ü-PLA2R¶§©Êªº½¤©ÊµÇ¤p²yµÇ¯f¡C
[30] Àu¥ýÅv : 2019/03/15¡A¼Ú¬wÁp·ù União Europeia¡A½s¸¹N.º 19163036.7
[21] ½s¸¹ : J/009559
[22] ¥Ó½Ð¤é : 2025/06/17
[24] §å¥Ü¤é : 2025/07/29
[73] Åv§Q¤H : Àq¨FªF¦³³d¥ô¤½¥q
¦a§} : 126 East Lincoln Avenue, Rahway, NJ, 07065-0907, U.S.A.
°êÄy : ¬ü°ê
[72] µo©ú¤H : R¡OH¡O¥Öº¸´µ, P¡O³Õ®¦, L¡O±ç, M¡O¤ñ°Ç
°ê®aª¾ÃѲ£Åv§½µo©ú±M§Q : ±M§Q¸¹N.º de patente ZL202110381996.5¡A¥Ó½Ð¤éData de pedido 2013/12/18¡A±ÂÅv¤½§i¸¹N.º de anúncio da concessão CN 113321731B¡A2025/06/13
[51] ¤ÀÃþ : C07K16/28, C12N15/13, G01N33/577, G01N33/68
[54] ¼ÐÃD : µ²¦X¤Hµ{§Ç©Ê¦º¤`°tÅé1(PD-L1)ªº§ÜÅé¡C
[57] ºKn : ¥»µo©ú´£¨Ñ¯S²§©Êµ²¦X¤Hµ{§Ç©Ê¦º¤`°tÅé1¡]PD-L1¡^ªº¤ÀÂ÷ªº§ÜÅé¥H¤Î¦¹Ãþ§ÜÅ骺§Üìµ²¦X¤ù¬q¡A¥H¤Î¥]§t©Òz§ÜPD-L1§ÜÅé©Îµ²¦X¤ù¬q©M¤@²Õ¥Î©óÀË´úµ²¦X¤HPD-L1ªº©Òz§ÜÅé©Î¨ä§Üìµ²¦X¤ù¬qªº½Æ¦Xª«ªº¸Õ¾¯ªº¸Õ¾¯²°¡C¥»µo©úªº§ÜÅé©M§Üìµ²¦X¤ù¬q¾A¥Î©ó²Õ´¼Ë«~¤¤¤HPD-L1ªí¹Fªº§K¬Ì²Õ´¤Æ¾ÇÀË´ú¡CÁÙ´£¨Ñ½s½X¥»µo©úªº§ÜÅé©M§Üìµ²¦X¤ù¬qªº®Ö»Ä¤À¤l¥H¤Î¥Î©ó¨äªí¹Fªºªí¹F¸üÅé©M±J¥D²ÓM¡C
ªþ¹Ï :

[30] Àu¥ýÅv : 2012/12/21¡A¬ü°ê Estados Unidos da América¡A½s¸¹N.º 61/745386
[21] ½s¸¹ : J/009560
[22] ¥Ó½Ð¤é : 2025/06/17
[24] §å¥Ü¤é : 2025/07/29
[73] Åv§Q¤H : ¥ìµÜ§Q§Q¤½¥q
¦a§} : Lilly Corporate Center, Indianapolis, Indiana 46285, USA
°êÄy : ¬ü°ê
[72] µo©ú¤H : S¡DR¡D¬ìªâ, M¡DO¡D¥±¨½¼w¨½§J, A¡D¸ëÄõ, N¡DJ¡D¥dº¸°Ò, M¡DE¡D¬ì©¬©_, K¡DD¡DÁɧB¯S, S¡DV¡D·¡¥d¿Õ¤Ò
°ê®aª¾ÃѲ£Åv§½µo©ú±M§Q : ±M§Q¸¹N.º de patente ZL202080011536.7¡A¥Ó½Ð¤éData de pedido 2020/01/28¡A±ÂÅv¤½§i¸¹N.º de anúncio da concessão CN 113330024B¡A2025/06/13
[51] ¤ÀÃþ : C07K14/605
[54] ¼ÐÃD : »s³ÆGIP/GLP1Âù«¿E°Ê¾¯ªº¤èªk¡C
[57] ºKn : ¥»µo©ú´£¨Ñ¦b»s³ytirzepatide©Î¨äÃľǥi±µ¨üªºÆQ¤¤¦³¥Îªº·s«¬¤¤¶¡Åé©M¤èªk¡C
[30] Àu¥ýÅv : 2019/01/29¡A¬ü°ê Estados Unidos da América¡A½s¸¹N.º 62/797963
2019/03/07¡A¬ü°ê Estados Unidos da América¡A½s¸¹N.º 62/815053
2019/03/14¡A¬ü°ê Estados Unidos da América¡A½s¸¹N.º 62/818342
[21] ½s¸¹ : J/009561
[22] ¥Ó½Ð¤é : 2025/06/18
[24] §å¥Ü¤é : 2025/07/29
[73] Åv§Q¤H : »«¤iªk¥§¨È¤j¾Ç¸³¨Æ·|
¦a§} : Center for Technology Transfer, 3160 Chestnut Street, Suite 200, Philadelphia, PA 19104-6283, U.S.A.
°êÄy : ¬ü°ê
[72] µo©ú¤H : »¯¶§§L, J¡D¥ô, X¡D¼B, C¡DH¡Dã
°ê®aª¾ÃѲ£Åv§½µo©ú±M§Q : ±M§Q¸¹N.º de patente ZL202111354276.6¡A¥Ó½Ð¤éData de pedido 2015/10/15¡A±ÂÅv¤½§i¸¹N.º de anúncio da concessão CN 114836385B¡A2025/04/04
[51] ¤ÀÃþ : C12N5/10, C12N15/85, C12N15/113, A61K35/26, A61K39/00, A61P35/00, A61P37/06
[54] ¼ÐÃD : §ïÅÜCART²ÓM¤¤ªº°ò¦]ªí¹F¤Î¨ä¥Î³~¡C
[57] ºKn : ¥»µo©ú¯A¤Î§ïÅÜCAR T²ÓM¤¤ªº°ò¦]ªí¹F¤Î¨ä¥Î³~¡C¥»µo©ú¯A¤Î¨Ï¥Î¯à°÷¤U½Õ¤º·½°ò¦]ªí¹F¡X¡X¨ä¿ï¦ÛTCR£\Ãì¡BTCR£]Ãì¡B£]-2·L²y³J¥Õ¡BHLA¤À¤l¡BCTLA-4¡BPD1©MFAS¡X¡Xªº®Ö»Ä¥Í¦¨×¹¢ªºT²ÓMªº²Õ¦Xª«©M¤èªk¡A¨ä¶i¤@¨B¥]¬A½s½X×¹¢ªºT²ÓM¨üÅé¡]TCR¡^¡X¡X¨ä¥]¬A¹ï¹v²ÓM¤Wªí±§Ü쪺¿Ë©M¤O¡X¡Xªº®Ö»Ä©Î½s½X´O¦X§Üì¨üÅé¡]CAR¡^ªº¹q¬ï¤Õªº®Ö»Ä¡CÁÙ¥]¬A¥Î©ó¹LÄ~Àøªk©MªvÀø¯f¯g¤ñ¦p¦Û¨§K¬Ì©Ê¯e¯fªº¤èªk©M¥]§t×¹¢ªºT²ÓMªºÃĪ«²Õ¦Xª«¡C
ªþ¹Ï :

[30] Àu¥ýÅv : 2014/10/31¡A¬ü°ê Estados Unidos da América¡A½s¸¹N.º 62/073,651
[21] ½s¸¹ : J/009562
[22] ¥Ó½Ð¤é : 2025/06/18
[24] §å¥Ü¤é : 2025/07/29
[73] Åv§Q¤H : ½Ã§÷R&DºÞ²z¦³¤½¥q
¦a§} : 6-10, Koishikawa, 4-chome, Bunkyo-ku, Tokyo, 112-8088, Japan
°êÄy : ¤é¥»
[72] µo©ú¤H : N¡Dµá¤°ª÷, T¡DÂݨ©Ô¬ì®¦, J¡D©¬©Ô¦è¿Õ, K¡D·s¤«, Y¡D¤p¦Ë, ¤j¤[«O¯u¤], §ø¤««h¤Ò, ®c³¥¶®¤§
°ê®aª¾ÃѲ£Åv§½µo©ú±M§Q : ±M§Q¸¹N.º de patente ZL201980081875.X¡A¥Ó½Ð¤éData de pedido 2019/12/12¡A±ÂÅv¤½§i¸¹N.º de anúncio da concessão CN 113271981B¡A2025/04/11
[51] ¤ÀÃþ : A61K47/68, A61P35/00
[54] ¼ÐÃD : ²ü§B§Æ¤G²m§ÜÅé-ÃĪ«ºó¦Xª«¤Î¨Ï¥Î¤èªk¡C
[57] ºKn : ¥»©ÜÅS¯A¤Îµ²¦X¦Ü¤HÃþ¸~½F¾Ç¹v¼Ðªº±µÀY-ÃĪ«¤Æ¦Xª«¤Î§ÜÅé-ÃĪ«ºó¦Xª«¡C³oÃþ±µÀY-ÃĪ«¤Æ¦Xª«¤Î§ÜÅé-ÃĪ«ºó¦Xª«¥]§t²ü§B§Æ¤G²m°Å±µ½Õ¸`¤lÃĪ«³¡¤À¡C¥»©ÜÅS¶i¤@¨B¯A¤Î¥Î©ó³q¹L¬I¥Î¥»¤å©Ò´£¨Ñªº³oÃþ§ÜÅé-ÃĪ«ºó¦Xª«¨ÓªvÀøÂإͩʯf¯gªº¤èªk¤Î²Õ¦Xª«¡CÁÙn¨D«OÅ@²ü§B§Æ¤G²m¥»¨¡C¶i¤@¨Bn¨D«OÅ@¨ä¥Î³~¡A¥H¤Î¥Ñ²ü§B§Æ¤G²m©Î¨äADC²£¥Íªº·s§Ü쪺¥Î³~¡A©Î°w¹ï¸Ó·s§Ü쪺¬Ì]¡C
[30] Àu¥ýÅv : 2018/12/13¡A¬ü°ê Estados Unidos da América¡A½s¸¹N.º 62/779,400
2018/12/13¡A¬ü°ê Estados Unidos da América¡A½s¸¹N.º 62/779,406
2019/11/27¡A¬ü°ê Estados Unidos da América¡A½s¸¹N.º 62/941,220
[21] ½s¸¹ : J/009563
[22] ¥Ó½Ð¤é : 2025/06/19
[24] §å¥Ü¤é : 2025/07/29
[73] Åv§Q¤H : ¯]®ü¾îµ^¥þ¬PÂåÀø¬ì§Þ¦³¤½¥q
¦a§} : ¯]®ü¥«¾îµ^Àô®qªF¸ô3242¸¹1407¿ì¤½«Ç
°êÄy : ¤¤°ê
[72] µo©ú¤H : ¦¶¼z^, ¦¶ÁoÙy, ¨L±Ò«G
°ê®aª¾ÃѲ£Åv§½µo©ú±M§Q : ±M§Q¸¹N.º de patente ZL202510213513.9¡A¥Ó½Ð¤éData de pedido 2025/02/26¡A±ÂÅv¤½§i¸¹N.º de anúncio da concessão CN 119722989B¡A2025/05/02
[51] ¤ÀÃþ : G06T17/20, G06T7/579, G06T7/11, G06T7/136, G06V10/762
[54] ¼ÐÃD : °ò©ó§ÎºA¾Ç±è«×»P¤¤¤ß¯S¼x´£¨úªºCT¹Ï¹³¤Tºû««Ø¤èªk¤Î¬ÛÃö¸Ë¸m¡C
[57] ºKn : ¥»¥Ó½Ð¤½¶}¤F¤@ºØ°ò©ó§ÎºA¾Ç±è«×»P¤¤¤ß¯S¼x´£¨úªºCT¹Ï¹³¤Tºû««Ø¤èªk¤Î¬ÛÃö¸Ë¸m¡C¸Ó¤èªk¥]¬A¡GÀò¨ú¥Ø¼Ð¹ï¶HªºÂå¾ÇCT¹Ï¹³¡F±qÂå¾ÇCT¹Ï¹³¤¤¤À³Î´£¨ú±o¨ìÂå¾ÇCT¤À³Î¥Ø¼Ð¹ï¶H¹Ï¹³¡F±q©ÒzÂå¾ÇCT¤À³Î¥Ø¼Ð¹ï¶H¹Ï¹³¤¤Àò¨ú¦hµø¨¤¤Á±§Ç¦C¡A¹ï¦hµø¨¤¤Á±§Ç¦C¶i¦æ§ÎºA¾Ç±è«×®t¹Bºâ¡A±o¨ì¤£¦Pµø¨¤¤Á±¤Uªº¥Ø¼Ð¹ï¶H¯S¼xÂI¶°¼Æ¾Ú¡A°O¬°¦hµø¨¤¯S¼xÂI¶°¡F¹ï¦hµø¨¤¯S¼xÂI¶°¡A¶i¦æ¦Û¾AÀ³¤¤¤ßÂI¶°´£¨ú¡A±o¨ì¦hµø¨¤¤¤¤ß¯S¼xÂI¶°¡F¸ò¾Ú¦hµø¨¤¤¤¤ß¯S¼xÂI¶°¼Æ¾Ú¡A¶i¦æ¤Tºû«ºc¼Æ¾Ú¥Í¦¨¡A¶i¦Ó±o¨ì¾ãӥؼЪ«ªº¤Tºû«ºc¼Æ¾Ú¡F±N¤Tºû«ºc¼Æ¾Ú¶i¦æªyªQ·§²v¤À§G±o¨ì³»ÂIÂI¶°¡A«á®Ú¾Ú³»ÂIÂI¶°««Ø¡A±o¨ì¤Tºû««Ø¼Ò«¬¡C¥»µo©ú¦³®Ä´î¤Ö««Ø¼Æ¾Ú¡A´£¤É««Ø³t«×¡C
ªþ¹Ï :

[21] ½s¸¹ : J/009564
[22] ¥Ó½Ð¤é : 2025/06/19
[24] §å¥Ü¤é : 2025/07/29
[73] Åv§Q¤H : ªü´Ë}´µÃĪ«°©¯e¯fªÑ¥÷¦³¤½¥q
¦a§} : Tuborg Boulevard 5, 2900 Hellerup, Denmark
°êÄy : ¤¦³Á
[72] µo©ú¤H : K¡D´µ´¶Ã¹®æ, F¡D§J§Q°Ò, G¡DÁÚ¯Sù, M¡D§J¾|»®, T¡D³®æ, J¡Dµ¦¯S°Ç
°ê®aª¾ÃѲ£Åv§½µo©ú±M§Q : ±M§Q¸¹N.º de patente ZL202210310529.8¡A¥Ó½Ð¤éData de pedido 2017/02/28¡A±ÂÅv¤½§i¸¹N.º de anúncio da concessão CN 115025239B¡A2025/03/21
[51] ¤ÀÃþ : A61K47/60, A61K47/54, A61K38/29, A61P5/18
[54] ¼ÐÃD : PTH«eÃÄ¡C
[57] ºKn : ¥»µo©ú¯A¤ÎPTH«eÃÄ¡B¥]§t³oÃþPTH«eÃĪºÃĪ«ÃĪ«²Õ¦Xª«¤Î¨ä¥Î³~¡C
[30] Àu¥ýÅv : 2016/03/01¡A¼Ú¬wÁp·ù União Europeia¡A½s¸¹N.º 16158048.5
2016/07/13¡A¼Ú¬wÁp·ù União Europeia¡A½s¸¹N.º 16179294.0
2016/09/29¡A¼Ú¬wÁp·ù União Europeia¡A½s¸¹N.º 16191484.1
2017/02/13¡A¼Ú¬wÁp·ù União Europeia¡A½s¸¹N.º 17155839.8
[21] ½s¸¹ : J/009565
[22] ¥Ó½Ð¤é : 2025/06/19
[24] §å¥Ü¤é : 2025/07/29
[73] Åv§Q¤H : ¤sªF§»ÀÙ°ó»sÃͰ¹ÎªÑ¥÷¦³¤½¥q
¦a§} : ¤¤°ê¤sªF¬ÙÀÙ«n¥«¾ä«°°Ï¸g¤QªF¸ô30766¸¹§»ÀÙ°ó¤¤ÃĬã¨s°|
°êÄy : ¤¤°ê
[72] µo©ú¤H : ±i¤j¹ç, ¸³¾å§Ì, ©s¥ü«C, ®}µX, ³æ¬ö], ±i¿o, ¼BÄR²M, ±iµÏµX, §õÄå
°ê®aª¾ÃѲ£Åv§½µo©ú±M§Q : ±M§Q¸¹N.º de patente ZL202311427902.9¡A¥Ó½Ð¤éData de pedido 2023/10/31¡A±ÂÅv¤½§i¸¹N.º de anúncio da concessão CN 117243995B¡A2025/04/22
[51] ¤ÀÃþ : A61K36/752, A61P13/12
[54] ¼ÐÃD : ¤@ºØªvÀøºC©ÊµÇ°Iªº¤¤ÃIJզXª«¤Î¨ä»s³Æ¤èªk©MÀ³¥Î¡C
[57] ºKn : ¥»µo©ú¤½¶}¤F¤@ºØªvÀøºC©ÊµÇ°Iªº¤¤ÃIJզXª«¤Î¨ä»s³Æ¤èªk©MÀ³¥Î¡AÄÝ©ó¤¤ÃÄ»s³Æ§Þ³N»â°ì¡A¨ä¥Ñ¥H¤U«¶q¥÷¼Æªºì®Æ»s¦¨¡G¶À芪2¡ã4¥÷¡B¤j¶À¬´3¡ã4¥÷¡B¥Í¤j¶À3¡ã4¥÷¡B¤tË|1¡ã3¥÷¡B¸É°©¯×1¡ã3¥÷¡B»Z¤½^12¡ã15¥÷¡Bª£¨M©ú¤l12¡ã15¥÷¡BÏL´ß1¡ã3¥÷¡B¥bªK½¬5¡ã7¥÷¡C¥»µo©ú²Õ¤è¬ì¾Ç¡A°t¤ñºëã¡A¨ã¦³¸ÉµÇ¬¡¦å¡B°¿B±Æ¬r¡B¦w©M¤Å¦ªº¥\®Ä¡A¬°ªvÀøºC©ÊµÇ°Iªº¦³®Ä¤èÃÄ¡A¥Î©ó¦UºØì¦]©ÒPºC©ÊµÇ¥\¯à°IºÜ¤§µÇµê¦å·ï¡B¿B¬r¤WÂZÃҪ̡C¥»µo©ú´£¨Ñªº¤¤ÃIJզXª«¾ãÅéÀø®Ä½T¤Á¡A¨Ï¦å²MScr¤ô¥ÅãµÛ°§C¡AACR¡BeGFR¡BBUN¡BHbªvÀø«e«á¨ã¦³ÅãµÛ©Ê®t²§¡A¯à°÷ÅãµÛ§ïµ½ºC©ÊµÇ°I±wªÌµÇ¥\¯à«ü¼Ð¡A¨Ã©µ½wºC©ÊµÇŦ¯fªºµo®i¶iµ{¡A¦³®Ä´£°ª±wªÌ¥Í¬¡½è¶q¡C
[21] ½s¸¹ : J/009566
[22] ¥Ó½Ð¤é : 2025/06/19
[24] §å¥Ü¤é : 2025/07/29
[73] Åv§Q¤H : ¦¨³£¶øºÍÃÄ·~¦³¤½¥q
¦a§} : ¤¤°ê¥|¤t¬Ù¦¨³£¥«¤¤°ê(¥|¤t)¦Û¥Ñ¶T©ö¸ÕÅç°Ï¦¨³£°ª·s°Ï©M¥Áµó16¸¹2¸¹¼Ó9¼h901¡B902¸¹,10¼h1001¡B1002¸¹610000
°êÄy : ¤¤°ê
[72] µo©ú¤H : ·¨³Ó«i, ¶Àºû, Á¨ΫB, J®ü, §õ¤É, ºµ¯q¦n, §d§µ¥þ, ¶À©_
°ê®aª¾ÃѲ£Åv§½µo©ú±M§Q : ±M§Q¸¹N.º de patente ZL202211486877.7¡A¥Ó½Ð¤éData de pedido 2022/11/24¡A±ÂÅv¤½§i¸¹N.º de anúncio da concessão CN 116178337B¡A2025/04/25
[51] ¤ÀÃþ : C07D401/04, C07D401/14, C07D403/04, C07F5/02, A61K31/5513, A61K31/69, A61P11/00, A61P9/00, A61P29/00, A61P37/02, A61P27/02, A61P25/00, A61P3/10, A61P37/06, A61P31/00
[54] ¼ÐÃD : f¦}¤G´áÂø䓬Ãþ¤Æ¦Xª«¤Î¨ä§@¬°Rho¿E酶§í¨î¾¯ªºÀ³¥Î¡C
[57] ºKn : ¥»¤½¶}¯A¤Î¤@ºØ¨ã¦³¦¡¡]I¡^©Ò¥Üµ²ºcªºf¦}¤G´áÂø䓬Ãþ¤Æ¦Xª«¡A©Òz¤Æ¦Xª«§@¬°ROCKII¿E酶§í¨î¾¯¡A¨ã¦³¬¡©Ê°ª¡A¿ï¾Ü©Ê¦n¥B¬r°Æ§@¥Î§Cµ¥ÀuÂI¡A¥»¤½¶}ÁÙ¯A¤Î¸Ó¤Æ¦Xª«¦bRho¿E酶§í¨î¾¯ÃĪ«¤¤ªºÀ³¥Î©M»s³Æ¤èªk¡C
ªþ¹Ï :

[30] Àu¥ýÅv : 2021/11/24¡A¤¤°ê¤º¦a China¡A½s¸¹N.º 202111404952.6
[21] ½s¸¹ : J/009567
[22] ¥Ó½Ð¤é : 2025/06/20
[24] §å¥Ü¤é : 2025/07/29
[73] Åv§Q¤H : OPKO ¥Íª«¬ì¾Ç¦³¤½¥q
¦a§} : 16 Ashlegan St., Kiryat Gat 8211804, Israel
°êÄy : ¥H¦â¦C
[72] µo©ú¤H : ¯Q}¡D®J¨Èº¸¡Dµáº¿ FIMA, Udi Eyal, ¦N¨½¡D«¢¯S HART, Gili
°ê®aª¾ÃѲ£Åv§½µo©ú±M§Q : ±M§Q¸¹N.º de patente ZL202110524582.3¡A¥Ó½Ð¤éData de pedido 2016/06/19¡A±ÂÅv¤½§i¸¹N.º de anúncio da concessão CN 113289009B¡A2025/05/02
[51] ¤ÀÃþ : A61K38/48, A61K9/00, A61P7/04, A61K47/12, A61K47/18, A61K47/02
[54] ¼ÐÃD : ªø®Ä¾®©T¦]¤l¤Î¨ä²£¥Í¤èªk¡C
[57] ºKn : ¥»µo©ú¯A¤Î¤@ºØªø®Ä¾®©T¦]¤l¤Î¨ä²£¥Í¤èªk¡C¤½¶}¤F¦h肽¥H¤Î¹ï¨ä¶i¦æ½s½Xªº¦h®Ö苷»Ä¡A©Òz¦h肽¥]¬A³Qªþ±µ¦Ü¾®©T¦]¤lªºßn°ò¥½ºÝ¦Ó«D®ò°ò¥½ºÝªº¦Ü¤Ö¤@Óµ³¤ò½¤«P©Ê¸¢¿E¯Àßn°ò¥½ºÝ肽¡]CTP¡^¡CÁÙ¤½¶}¤F¥]¬A¥»¤½¶}ªº¦h肽©M¦h®Ö苷»ÄªºÃĪ«²Õ¦Xª«©MÃĪ«»s¾¯¤Î¨ä¨Ï¥Î©M²£¥Í¤èªk¡C
ªþ¹Ï :

[30] Àu¥ýÅv : 2015/06/19¡A¬ü°ê Estados Unidos da América¡A½s¸¹N.º 62/182,370
[21] ½s¸¹ : J/009568
[22] ¥Ó½Ð¤é : 2025/06/20
[24] §å¥Ü¤é : 2025/07/29
[73] Åv§Q¤H : RA »sÃĤ½¥q
¦a§} : 87 Cambridge Park Drive Cambridge, Massachusetts 02140 (US)
°êÄy : ¬ü°ê
[72] µo©ú¤H : S¡DJ¡D¼w°¨¬ì Steven James DEMARCO, M¡DD¡DÀNº¸¸¦ Michelle Denise HOARTY, G¡DV¡D©¬§J Grace Victoria PARKER, A¡D¨½¥d¦h Alonso RICARDO, S¡D¦«¤ñ Sylvia TOBE, D¡DA¡D¯S¹p¬ì Douglas A. TRECO
°ê®aª¾ÃѲ£Åv§½µo©ú±M§Q : ±M§Q¸¹N.º de patente ZL202210878127.8¡A¥Ó½Ð¤éData de pedido 2016/12/07¡A±ÂÅv¤½§i¸¹N.º de anúncio da concessão CN 115920000B¡A2025/04/25
[51] ¤ÀÃþ : A61K38/10, A61K38/12, A61K9/00, A61K47/02, A61K45/06, A61M5/30, A61P9/12, A61P15/00, A61P21/04
[54] ¼ÐÃD : ¸ÉÅ鬡©Êªº½Õ¸`¾¯¡C
[57] ºKn : ¥»µo©ú¯A¤Î¸ÉÅ鬡©Êªº½Õ¸`¾¯¡A¨ãÅé¦Ó¨¥¡A¥»µo©ú¯A¤Î¸ÉÅ鬡©Êªº¦h肽½Õ¸`¾¯¡A¥]¬AÀôª¬¦h肽½Õ¸`¾¯¡C¥]¬A§Q¥Î³o¼Ëªº½Õ¸`¾¯§@¬°ªvÀø¾¯ªº¤èªk¡C
ªþ¹Ï :

[30] Àu¥ýÅv : 2015/12/16¡A¬ü°ê Estados Unidos da América¡A½s¸¹N.º 62/268,360
2016/05/03¡A¬ü°ê Estados Unidos da América¡A½s¸¹N.º 62/331,320
2016/06/08¡A¬ü°ê Estados Unidos da América¡A½s¸¹N.º 62/347,486
[21] ½s¸¹ : J/009569
[22] ¥Ó½Ð¤é : 2025/06/20
[24] §å¥Ü¤é : 2025/07/29
[73] Åv§Q¤H : ¨½®æº¸ÃÄ«~ªÑ¥÷¦³¤½¥q
¦a§} : 611 Gateway Boulevard, Suite 900, South San Francisco, California 94080, United States of America
°êÄy : ¬ü°ê
[72] µo©ú¤H : ¥ì«¢¤R¡D¹Fº¸ºû¤°, §E®a·s, ³¯¿P, ®J´µ¯S¯Z¡D°¨Ä¬¹F, ¥Ë©g²ï¡D®õ°Ç
°ê®aª¾ÃѲ£Åv§½µo©ú±M§Q : ±M§Q¸¹N.º de patente ZL201980045150.5¡A¥Ó½Ð¤éData de pedido 2019/05/02¡A±ÂÅv¤½§i¸¹N.º de anúncio da concessão CN 112384510B¡A2025/06/13
[51] ¤ÀÃþ : C07D413/14, C07D413/12, A61P37/02, A61P29/00, A61K31/553
[54] ¼ÐÃD : RIP1§í¨î©Ê¤Æ¦Xª«¥H¤Î»s³Æ©M¨Ï¥Î¨äªº¤èªk¡C
[57] ºKn : ¥»¤å¤½¶}¤F¿E酶§í¨î©Ê¤Æ¦Xª«¡A¨Ò¦p¨üÅé¬Û¤¬§@¥Î³J¥Õ-1¡]RIP1¡^¿E酶§í¨î¾¯¤Æ¦Xª«¡A¥H¤Î¥]§t¦¹Ãþ§í¨î©Ê¤Æ¦Xª«ªºÃĪ«²Õ¦Xª«©M²Õ¦X¡C¤½¶}ªº¤Æ¦Xª«¡BÃĪ«²Õ¦Xª«©M/©Î²Õ¦X¥i¥H¥Î©ó¦bÅ餺©ÎÂ÷Åé§í¨îRIP1¿E酶¡A¨Ã¥BÁÙ¥i¥HªvÀø©Î¹w¨¾¿E酶¬ÛÃö¯e¯f©Î¯f¯g¡A¯S§O¬ORIP1¬ÛÃö¯e¯f©Î¯f¯g¡C
[30] Àu¥ýÅv : 2018/05/03¡A¬ü°ê Estados Unidos da América¡A½s¸¹N.º 62/666,452
[21] ½s¸¹ : J/009570
[22] ¥Ó½Ð¤é : 2025/06/20
[24] §å¥Ü¤é : 2025/07/29
[73] Åv§Q¤H : «ô¦Õ¤½¥q
¦a§} : Kaiser-Wilhelm-Allee 1, Leverkusen 51373, Germany
°êÄy : ¼w°ê
[72] µo©ú¤H : A¡D´¶°Ç, J¡D¥d§Q¿Õ¤Ò´µ°ò, S¡D¬I¤º§J¡V¨©§Jº¸, M¡D¨Øº¸´µ§J, L¡DÁÂ¥±¯S
°ê®aª¾ÃѲ£Åv§½µo©ú±M§Q : ±M§Q¸¹N.º de patente ZL202080072811.6¡A¥Ó½Ð¤éData de pedido 2020/10/02¡A±ÂÅv¤½§i¸¹N.º de anúncio da concessão CN 114555811B¡A2025/03/25
[51] ¤ÀÃþ : C12N15/74, C12N1/21, C12P19/26, C12N15/31, C12N15/54, C12N15/60, C12R1/045
[54] ¼ÐÃD : ¥Î©ó§ïµ½ªü¥dªi¿}§Î¦¨ªº¤èªk¡C
[57] ºKn : ¥»µo©ú¯A¤Î¥Î©ó§ïµ½ªü¥dªi¿}§Î¦¨ªº©ñ½uµßµß®è¡C¥»µo©ú´£¨Ñ¤F¸g¤uµ{¤Æ¥H¹Lªí¹FdTDP-D-¸²µå¿}-4,6-²æ¤ô酶¡]AcbB¡^©M/©Î§¿苷ñQÂಾ酶¡]GtaB¡^ªº©ñ½uµß¥Øµß®è¡CÁÙ´£¨Ñ¸g¤uµ{¤Æ¥H¨ã¦³°§Cªº©Î¤£¦s¦bªº¤pºÒ¤ô¤Æ¦Xª«µ²¦X³J¥Õ¡]Cgt¡^ªºªí¹F©M/©Î°§Cªº©Î¤£¦s¦bªºÃþJÅÚ½³¯À¦X¦¨©Ò¥²»Ýªº°ò¦]ªºªí¹Fªº©ñ½uµß¥Øµß®è¡CÁÙ´£¨Ñ¥Í¦¨³o¨Çµß®èªº¤u¨ã¡B¤èªk©M¤â¬q¡C
ªþ¹Ï :

[30] Àu¥ýÅv : 2019/10/16¡A¼Ú¬wÁp·ù União Europeia¡A½s¸¹N.º 19203693.7
[21] ½s¸¹ : J/009572
[22] ¥Ó½Ð¤é : 2025/06/23
[24] §å¥Ü¤é : 2025/07/29
[73] Åv§Q¤H : »¨¤ÒÁÚ¡Dù¤ó¦³¤½¥q
¦a§} : Grenzacherstrasse 124, 4070 Basel, Switzerland
°êÄy : ·ç¤h
[72] µo©ú¤H : N¡D¬ìº¸´µ, M¡D®æ´µºÖ¼w, A¡DD¡D¿Õ¨½´µ, M¡D¥Õ±T
°ê®aª¾ÃѲ£Åv§½µo©ú±M§Q : ±M§Q¸¹N.º de patente ZL201980090495.2¡A¥Ó½Ð¤éData de pedido 2019/11/26¡A±ÂÅv¤½§i¸¹N.º de anúncio da concessão CN 113366302B¡A2025/04/25
[51] ¤ÀÃþ : G01N21/88, G01N21/90
[54] ¼ÐÃD : ¤p²~Àˬd¤èªk©M¾¹±ñ¡C
[57] ºKn : ¥»¤½¶}´£¨Ñ¤@ºØ¬Á¼þ¤p²~·Ó©ú©MÀˬd¨t²Î¡A©Òz¨t²Î¥i¥H³]¸m¦³¥ú·½©M¤ä¬[¡C©Òz¤ä¬[¥i¥H¨ã¦³ºc³y¦¨±µ¯Ç©Òz¥ú·½ªº¦Ü¤Ö¤@³¡¤Àªº¤ºµÄ¡C©Òz¤ä¬[¤¤¥i©w¦ì¦³¥W¤f¡A¨Ã¥B©Òz¥W¤fºc³y¦¨±µ¯Ç¬Á¼þ¤p²~ªº¦Ü¤Ö¤@³¡¤À¡C©Òz¤ä¬[¥i¥Hºc³y¦¨±N±q©Òz¥ú·½¿é¥Xªº¥ú¹ï·Ç©Òz¬Á¼þ¤p²~¥H·Ó©ú©Òz¤p²~¡C©Òz¤ä¬[¥i¥Hºc³y¦¨¦w¸m©Òz¤p²~¡A¥H«KÀˬdû¥i¥H¹ï¸g·Ó©úªº¤p²~¤â°ÊÀˬd¯Ê³´¡C¥t¥~ÁÙ¤½¶}¤F¨Ï¥Î¤èªk¡C
ªþ¹Ï :

[30] Àu¥ýÅv : 2018/11/30¡A¬ü°ê Estados Unidos da América¡A½s¸¹N.º 62/773,985
2019/04/23¡A¬ü°ê Estados Unidos da América¡A½s¸¹N.º 62/837,521
[21] ½s¸¹ : J/009573
[22] ¥Ó½Ð¤é : 2025/06/23
[24] §å¥Ü¤é : 2025/07/29
[73] Åv§Q¤H : §ù¤ñ°ê»Ú¤½¥q
¦a§} : c/o Apollo Building, 3E, Herikerbergweg 1-35, 1101 CN, Amsterdam Zuid-Oost, NL
°êÄy : ·ç¨å
[72] µo©ú¤H : ¨È¾ú¤s¤j¡D§J¾|®æ, ´µ¤å¡D¬ìº¸ªF
°ê®aª¾ÃѲ£Åv§½µo©ú±M§Q : ±M§Q¸¹N.º de patente ZL202111089841.0¡A¥Ó½Ð¤éData de pedido 2015/06/22¡A±ÂÅv¤½§i¸¹N.º de anúncio da concessão CN 113808600B¡A2025/04/04
[51] ¤ÀÃþ : G10L19/04, G10L19/24, G10L19/008
[54] ¼ÐÃD : °w¹ïHOA¼Æ¾Ú´Vªí¥ÜªºÀ£ÁY½T©wªí¥Ü«D®t¤À¼W¯qȩһݪº³Ì¤p¾ã¼Æ¤ñ¯S¼Æªº¤èªk¡C
[57] ºKn : ¥»µo©ú¤½¶}¤F°w¹ïHOA¼Æ¾Ú´Vªí¥ÜªºÀ£ÁY½T©wªí¥Ü«D®t¤À¼W¯qȩһݪº³Ì¤p¾ã¼Æ¤ñ¯S¼Æªº¤èªk¡C·í¹ïHOA¼Æ¾Ú´Vªí¥Ü¶i¦æÀ£ÁY®É¡A¦b¨CÓ³q¹D«H¸¹³Q·Pª¾¦a½s½X¡]16¡^¤§«e¹ï¨ä¹ê¬I¼W¯q±±¨î¡]15¡A151¡^¡C¼W¯qȧ@¬°Ãä«H®§¥H®t¤Àªº¤è¦¡³Q¶Ç¿é¡CµM¦Ó¡A¬°¤F¶}©l¹ï³o¼Ëªº¬y¦¡À£ÁYHOA¼Æ¾Ú´Vªí¥Ü¶i¦æ¸Ñ½X¡A»Ýnµ´¹ï¼W¯qÈ¡AÀ³·í¥H³Ì¤p¼Æ¶qªº¤ñ¯S¹ï¸Óµ´¹ï¼W¯qȶi¦æ½s½X¡C¬°¤F½T©w³o¼Ëªº³Ì¤p¾ã¼Æ¤ñ¯S¶q{£]e¡^¡A¦bªÅ¶¡°ì¤¤±NHOA¼Æ¾Ú´Vªí¥Ü¡]C¡]k¡^¡^´è¬V¬°¦ì©ó³æ¦ì²yÅé¤WªºµêÀÀ´Án¾¹«H¸¹¡AÀH«á¹ïHOA¼Æ¾Ú´Vªí¥Ü¡]C¡]k¡^¡^¶i¦æÂk¤@¤Æ¡CµM«á¡A±N³Ì¤p¾ã¼Æ¤ñ¯S¼Æ³]¸m¬°¡]AA¡^¡C
ªþ¹Ï :

[30] Àu¥ýÅv : 2014/06/27¡A¼Ú¬wÁp·ù União Europeia¡A½s¸¹N.º 14306026.7
[21] ½s¸¹ : J/009574
[22] ¥Ó½Ð¤é : 2025/06/23
[24] §å¥Ü¤é : 2025/07/29
[73] Åv§Q¤H : ¦N§Q¼w¬ì¾Ç¤½¥q
¦a§} : 333 Lakeside Drive, Foster City, CA 94404, U.S.A.
°êÄy : ¬ü°ê
[72] µo©ú¤H : M¡DO¡DH¡D§J©Ô§J, J¡DY¡DÂ×, R¡D³ì¤¦, R¡DL¡D°¨§J°Ò, A¡DS¡D¹p, D¡D¦è®æº¸
°ê®aª¾ÃѲ£Åv§½µo©ú±M§Q : ±M§Q¸¹N.º de patente ZL201680066796.8¡A¥Ó½Ð¤éData de pedido 2016/09/16¡A±ÂÅv¤½§i¸¹N.º de anúncio da concessão CN 108348526B¡A2025/04/25
[51] ¤ÀÃþ : A61K31/53, A61K31/664, A61K31/683, A61K31/675, A61K31/685, A61P31/12
[54] ¼ÐÃD : ªvÀø¨F²É¯f¬r¬ì©M«aª¬¯f¬r¬ì¯f¬r·P¬Vªº¤èªk¡C
[57] ºKn : ´£¨Ñ¤F³q¹L¬I¥Î¦¡Iªº®Ö苷¤Î¨ä«eÃĨӪvÀø¨F²É¯f¬r¬ì©M«aª¬¯f¬r¬ì¯f¬r·P¬Vªº¤èªk¡A¨ä¤¤®Ö苷¿}ªº1¡¦¦ì³Q¨ú¥N¡C©Ò´£¨Ñªº¤Æ¦Xª«¡B²Õ¦Xª«©M¤èªk¹ï©óªvÀø©Ô¨F¯f¬r©MJ¹ç¯f¬r·P¬V¯S§O¦³¥Î¡C
ªþ¹Ï :

[30] Àu¥ýÅv : 2015/09/16¡A¬ü°ê Estados Unidos da América¡A½s¸¹N.º 62/219,302
2015/10/09¡A¬ü°ê Estados Unidos da América¡A½s¸¹N.º 62/239,696
[21] ½s¸¹ : J/009575
[22] ¥Ó½Ð¤é : 2025/06/24
[24] §å¥Ü¤é : 2025/07/29
[73] Åv§Q¤H : ªä¼é¬y¡]¯]®ü¡^¬ì§Þ¦³¤½¥q
¦a§} : ¤¤°ê¯]®ü¥«¾îµ^·s°ÏÀô®qªF¸ô1889¸¹17´É127-128«Ç
°êÄy : ¤¤°ê
[72] µo©ú¤H : ©P¾åªi, ¤ý°¶, ¼BÙy, »¯®ü§L
°ê®aª¾ÃѲ£Åv§½µo©ú±M§Q : ±M§Q¸¹N.º de patente ZL202510416767.0¡A¥Ó½Ð¤éData de pedido 2025/04/02¡A±ÂÅv¤½§i¸¹N.º de anúncio da concessão CN 119921891B¡A2025/06/20
[51] ¤ÀÃþ : H04J3/06, H04L7/00
[54] ¼ÐÃD : ¥Î©óSerDesµo®gºÝªº¦h¬Û¦ì®ÉÄÁ®Õ·Ç¤èªk©M¸Ë¸m¡C
[57] ºKn : ®Ú¾Ú¥»¤½¶}ªº¹ê¬I¨Ò¡A´£¨Ñ¤F¤@ºØ¥Î©óSerDesµo®gºÝªº¦h¬Û¦ì®ÉÄÁ®Õ·Ç¸Ë¸m©M¤èªk¡C¸Ó¸Ë¸m¥]¬A½Æ»sªº¿é¥XÅX°Ê¯Å¡A¨ä¥Î©ó¥Í¦¨»P¿é¥XÅX°Ê¯Åªº¿é¥X«H¸¹¦¨¤ñ¨Òªº½Æ»s«H¸¹¡FÂoªi¾¹¡A¨ä³s±µ¦Ü©Òz½Æ»sªº¿é¥XÅX°Ê¯Åªº¿é¥XºÝ¡F¼Ò¼ÆÂà´«¾¹¡A¨ä±µ¦¬©ÒzÂoªi¾¹¿é¥XªºÂoªi«áªº¼ÒÀÀ«H¸¹¡A±NÂoªi«áªº¼ÒÀÀ«H¸¹Âà´«¬°¼Æ¦r«H¸¹¡F¬Û¦ì»~®tÀË´ú³æ¤¸¡A¨äpºâ¬Û¾F¿é¥X«H¸¹¤§¶¡ªº¦Û¬ÛÃö¨ç¼Æ¡A¨Ã®Ú¾Ú¦Û¬ÛÃö¨ç¼Æªº¤ñ¸ûµ²ªG¥Í¦¨¬Û¦ì½Õ¸`«H¸¹¡F®ÉÄÁ¬Û¦ì½Õ¾ã³æ¤¸¡A¨ä®Ú¾Ú¬Û¦ì½Õ¸`«H¸¹½Õ¾ã¦h¬Û¦ì®ÉÄÁ«H¸¹ªº¬Û¦ì¡A©Òz¦h¬Û¦ì®ÉÄÁ«H¸¹¥Î©óÅX°ÊSerDesµo®gºÝªº¦h¸ô½Æ¥Î¾¹¥H¹ï¨Ã¦æ¼Æ¦r«H®§¶i¦æ¦ê¦æ¤Æ¡C¥»¤½¶}ªº¹ê¬I¨Ò³q¹L¹ï¦h¬Û¦ì®ÉÄÁ«H¸¹ªº½Õ¸`¥i¥H½T«OSerDesµo®gºÝ¿é¥X«H¸¹ªº·Ç½T©Ê¡C
ªþ¹Ï :

[21] ½s¸¹ : J/009576
[22] ¥Ó½Ð¤é : 2025/06/24
[24] §å¥Ü¤é : 2025/07/29
[73] Åv§Q¤H : ¥¿¤j¤Ñ´¸ÃÄ·~¶°¹ÎªÑ¥÷¦³¤½¥q
¦a§} : ¤¤°ê¦¿Ä¬¬Ù³s¶³´ä¥«§¦{«n¸ô369¸¹¡A ¶l½s222062
°êÄy : ¤¤°ê
[73] Åv§Q¤H : ³s¶³´ä¼í²³»sÃĦ³¤½¥q
¦a§} : ¤¤°ê¦¿Ä¬¬Ù³s¶³´ä¥«³s¶³´ä¸gÀÙ§Þ³N¶}µo°Ï¤j®ú¤u·~°Ïª÷¾ô¸ô16¸¹¡A ¶l½s222069
°êÄy : ¤¤°ê
[73] Åv§Q¤H : ºÃı±ªÑ¡]¥_¨Ê¡^ªÑ¥÷¦³¤½¥q
¦a§} : ¤¤°ê¥_¨Ê¥«¤j¿³°Ï¥_¨Ê¸gÀÙ§Þ³N¶}µo°ÏºaµØ¤¤¸ô10¸¹1¼lA®y22¼h2205¡A¶l½s100176
°êÄy : ¤¤°ê
[72] µo©ú¤H : ±ç¬x»Ê, ±i³ß¥þ, ¤ý°V±j, ¤_¹©, ¤ý´É, ¸¯µX, ¤ý¬L, ¤ýºY±Ý
°ê®aª¾ÃѲ£Åv§½µo©ú±M§Q : ±M§Q¸¹N.º de patente ZL202180008532.8¡A¥Ó½Ð¤éData de pedido 2021/03/09¡A±ÂÅv¤½§i¸¹N.º de anúncio da concessão CN114981272B¡A2025/04/11
[51] ¤ÀÃþ : C07D487/04, A61K31/519, A61P7/00
[54] ¼ÐÃD : 吡«£¦}áGÔr¤Æ¦Xª«ªºªvÀø¾½¦å²ÓMºî¦X¼xªº¥Î³~¡C
[57] ºKn : 吡«£¦}áGÔr¤Æ¦Xª«ªvÀø¾½¦å²ÓMºî¦X¼xªº¥Î³~¡A¨ãÅé¯A¤Î¦¡¡]I¡^¤Æ¦Xª«¡B¨ä¥ßÅé²§ºcÅé¡B©Î¨äÃľǤW¥i±µ¨üªºÆQ¤Î¨äÃĪ«²Õ¦Xª«ªvÀø¾½¦å²ÓMºî¦X¼xªº¥Î³~¡C
ªþ¹Ï :

[30] Àu¥ýÅv : 2020/03/09¡A¤¤°ê¤º¦a China¡A½s¸¹N.º 202010157375.4
[21] ½s¸¹ : J/009577
[22] ¥Ó½Ð¤é : 2025/06/24
[24] §å¥Ü¤é : 2025/07/29
[73] Åv§Q¤H : §ù¤ñ°ê»Ú¤½¥q
¦a§} : c/o Apollo Building, 3E, Herikerbergweg 1-35, 1101 CN, Amsterdam Zuid-Oost, NL
°êÄy : ·ç¨å
[72] µo©ú¤H : ´µ¤å¡D¬ìº¸ªF, ¨È¾ú¤s¤j¡D§J¾|®æ
°ê®aª¾ÃѲ£Åv§½µo©ú±M§Q : ±M§Q¸¹N.º de patente ZL202110160575.X¡A¥Ó½Ð¤éData de pedido 2015/06/22¡A±ÂÅv¤½§i¸¹N.º de anúncio da concessão CN 112951254B¡A2025/03/28
[51] ¤ÀÃþ : G10L19/08, G10L19/038, G10L19/008, H04S7/00
[54] ¼ÐÃD : °w¹ïHOA¼Æ¾Ú´Vªí¥ÜªºÀ£ÁY½T©wªí¥Ü«D®t¤À¼W¯qȩһݪº³Ì¤p¾ã¼Æ¤ñ¯S¼Æªº¤èªk©M³]³Æ¡C
[57] ºKn : ¥»¤½¶}¯A¤Î°w¹ïHOA¼Æ¾Ú´Vªí¥ÜªºÀ£ÁY½T©wªí¥Ü«D®t¤À¼W¯qȩһݪº³Ì¤p¾ã¼Æ¤ñ¯S¼Æªº¤èªk©M³]³Æ¡C·í¹ïHOA¼Æ¾Ú´Vªí¥Ü¶i¦æÀ£ÁY®É¡A¦b¨CÓ³q¹D«H¸¹³Q·Pª¾¦a½s½X¡]16¡^¤§«e¹ï¨ä¹ê¬I¼W¯q±±¨î¡]15¡A151¡^¡C¼W¯qȧ@¬°Ãä«H®§¥H®t¤Àªº¤è¦¡³Q¶Ç¿é¡CµM¦Ó¡A¬°¤F¶}©l¹ï³o¼Ëªº¬y¦¡À£ÁYHOA¼Æ¾Ú´Vªí¥Ü¶i¦æ¸Ñ½X¡A»Ýnµ´¹ï¼W¯qÈ¡AÀ³·í¥H³Ì¤p¼Æ¶qªº¤ñ¯S¹ï¸Óµ´¹ï¼W¯qȶi¦æ½s½X¡C¬°¤F½T©w³o¼Ëªº³Ì¤p¾ã¼Æ¤ñ¯S¶q{£]e¡^¡A¦bªÅ¶¡°ì¤¤±NHOA¼Æ¾Ú´Vªí¥Ü¡]C¡]k¡^¡^´è¬V¬°¦ì©ó³æ¦ì²yÅé¤WªºµêÀÀ´Án¾¹«H¸¹¡AÀH«á¹ïHOA¼Æ¾Ú´Vªí¥Ü¡]C¡]k¡^¡^¶i¦æÂk¤@¤Æ¡CµM«á¡A±N³Ì¤p¾ã¼Æ¤ñ¯S¼Æ³]¸m¬°¡]¨£ºKnªþ¹Ï¡^¡C
ªþ¹Ï :

[30] Àu¥ýÅv : 2014/06/27¡A¼Ú¬wÁp·ù União Europeia¡A½s¸¹N.º 14306023.4
[21] ½s¸¹ : J/009578
[22] ¥Ó½Ð¤é : 2025/06/25
[24] §å¥Ü¤é : 2025/07/29
[73] Åv§Q¤H : ºÖº¸¸¦´µ¤½¥q
¦a§} : 1100 S. Flower St., Ste 3100, Los Angeles, CA 90015-2127, U.S.A.
°êÄy : ¬ü°ê
[72] µo©ú¤H : ºÖ¨½´µ¯S¡DS¡D¶ë¯ý SEITZ, FORREST S., ¬ù®Ñ¨È¡DK¡DÀN¥ì¯S HOYT, JOSHUA K., ¤Ú¯S§Q¡DA¡D¬ù¿«»¹ JOHNSON, BARTLEY A., ®õ°Ç¡DJ¡D¶ë¯ý SEITZ, TYLER J.
°ê®aª¾ÃѲ£Åv§½µo©ú±M§Q : ±M§Q¸¹N.º de patente ZL202210482062.5¡A¥Ó½Ð¤éData de pedido 2018/11/15¡A±ÂÅv¤½§i¸¹N.º de anúncio da concessão CN 114819029B¡A2025/05/30
[51] ¤ÀÃþ : G06K19/077, H01Q1/22, H01Q21/00
[54] ¼ÐÃD : ¥Î©ó¹CÀ¸ªºRFID¤Ñ½u°}¦C¡C
[57] ºKn : ¥»¥Ó½Ð®×¯A¤Î¥Î©ó¹CÀ¸ªºRFID¤Ñ½u°}¦C¡C¤@ºØRFID¨t²Î¥]§t¦hӤѽu¨Ã¥B¨Ï¥Î¨C¤@¤Ñ½u±µ¦¬ªºRFID«H¸¹ªº®¶´T©M¬Û¦ì«H®§½T©wªþªñªºRFID¼Ðñªº¦ì¸m¡C¦h©ó¤@Ӥѽu¥i¦b³æÓŪ¨ú´`Àô´Á¶¡±µ¦¬©ÒzRFID«H¸¹¡A¨Ï©ÒzRFID¨t²Î¯à°÷¤ñ³æ¿W¦a¬°¤Ñ½u¨Ñ¯àªº¨t²Î§ó§Ö³t¦a¾Þ§@¡C
ªþ¹Ï :

[30] Àu¥ýÅv : 2017/11/15¡A¬ü°ê Estados Unidos da América¡A½s¸¹N.º 15/814,170
2018/08/27¡A¬ü°ê Estados Unidos da América¡A½s¸¹N.º 16/114,018
[21] ½s¸¹ : J/009579
[22] ¥Ó½Ð¤é : 2025/06/25
[24] §å¥Ü¤é : 2025/07/29
[73] Åv§Q¤H : ¦ÊÀÙ¯«¦{¦³¤½¥q
¦a§} : ^Äݶ}°Ò¸s®q¤j¶}°Ò®q¥dº¿¯Ç®üÆW¯Á¯Ç·ç´µ¤j¹D94¸¹
°êÄy : ¶}°Ò¸s®q
[72] µo©ú¤H : ±i°ê¨}, ]«Ø§§, ©P©÷¤Í, ³¯è
°ê®aª¾ÃѲ£Åv§½µo©ú±M§Q : ±M§Q¸¹N.º de patente ZL202080013393.3¡A¥Ó½Ð¤éData de pedido 2020/02/06¡A±ÂÅv¤½§i¸¹N.º de anúncio da concessão CN 113423708B¡A2025/04/22
[51] ¤ÀÃþ : C07D487/04, A61K31/395, A61P35/00
[54] ¼ÐÃD : §@¬°TLR7¿E°Ê¾¯ªº«}Ðü¦}[2, 1-F][1, 2, 4]¤T嗪-4-Óil¥Íª«¡C
[57] ºKn : ¥»¤å©ÜÅS¤F¥i¥Î§@TLR7¿E°Ê¾¯ªº«}Ðü¦}[2,1-f][1,2,4]¤T嗪-4-Óil¥Íª«©Î¨ä¥ßÅé²§ºcÅé¡B©Î¨äÃľǤW¥i±µ¨üªºÆQ¡A¥H¤Î¥]§t©Òz«}Ðü¦}[2,1-f][1,2,4]¤T嗪-4-Óil¥Íª«©Î¨ä¥ßÅé²§ºcÅé¡B©Î¨äÃľǤW¥i±µ¨üªºÆQªºÃĪ«²Õ¦Xª«¡C¥»¤åÁÙ©ÜÅS¤F¨Ï¥Î©Òz«}Ðü¦}[2,1-f][1,2,4]¤T嗪-4-Óil¥Íª«©Î¨ä¥ßÅé²§ºcÅé¡B©Î¨äÃľǤW¥i±µ¨üªºÆQ§@¬°TLR7¿E°Ê¾¯ªvÀøÀù¯gªº¤èªk¡C
[30] Àu¥ýÅv : 2019/02/07¡A¤¤°ê¤º¦a China¡A½s¸¹N.º PCT/CN2019/074732
2019/07/31¡A¤¤°ê¤º¦a China¡A½s¸¹N.º PCT/CN2019/098757
2020/01/22¡A¤¤°ê¤º¦a China¡A½s¸¹N.º PCT/CN2020/073673
[21] ½s¸¹ : J/009580
[22] ¥Ó½Ð¤é : 2025/06/25
[24] §å¥Ü¤é : 2025/07/29
[73] Åv§Q¤H : ªZº~®Ô¨Ó¬ì§Þµo®i¦³¤½¥q
¦a§} : ¤¤°ê´ò¥_¬ÙªZº~¥«ªF´ò·s§Þ³N¶}µo°Ï°ª·s¤j¹D666¸¹ªZº~°ê®a¥Íª«²£·~°ò¦a¶µ¥ØB¡BC¡BD°Ï¬ãµo¼ÓB1´É¡]¬ãµo°ÏC2-2¡^
°êÄy : ¤¤°ê
[72] µo©ú¤H : ¤ý«G, °úx, ¬xµØ¶³, ³¢¾å¤¦, ¿úÄR®R, ±i¶c²[, ³¯¥Ã³Í, ¤ý´ÂªF
°ê®aª¾ÃѲ£Åv§½µo©ú±M§Q : ±M§Q¸¹N.º de patente ZL202110705814.5¡A¥Ó½Ð¤éData de pedido 2021/06/24¡A±ÂÅv¤½§i¸¹N.º de anúncio da concessão CN 113929677B¡A2025/05/30
[51] ¤ÀÃþ : C07D471/04, A61K31/5377, A61P11/00, A61P11/06, A61P13/00, A61P37/02, A61P13/10, A61P25/16, A61P25/28, A61P25/08, A61P25/20, A61P25/18, A61P9/10, A61P29/00, A61P7/00, A61P7/12, A61P27/00
[54] ¼ÐÃD : ÂøÀôÃþ¤Æ¦Xª«ªº´¹«¬¤Î¨ä»s³Æ¤èªk©MÀ³¥Î¡C
[57] ºKn : ¥»µo©ú¤½¶}¤F¤@ºØÂøÀôÃþ¤Æ¦Xª«ªº´¹«¬¤Î¨ä»s³Æ¤èªk©MÀ³¥Î¡C¥»µo©ú´£¨Ñ¤F¤@ºØ¦p¦¡A©Ò¥Üªº¤Æ¦Xª«ªº´¹«¬¡G©Òz´¹«¬¬O´¹«¬I¡B´¹«¬II¡B´¹«¬III¡B´¹«¬IV¡B´¹«¬V¡B´¹«¬VI¡B´¹«¬VII¡B´¹«¬VIII©Î´¹«¬IX¡A¨Ã¤½¶}¤F¨ä»s³Æ¤èªk¡B²Õ¦Xª«¥H¤Î¨ä¦b»s³ÆP2X3¨üÅé«ú§Ü¾¯¤¤ªºÀ³¥Î¡A©ÎªÌ¦b»s³Æ¥Î©ó¹w¨¾©M/©ÎªvÀø¯kµh¡Bªc§¿¹D¯e¯f©Î©I§l¨t²Î¯e¯fªºÃĪ«¤¤ªºÀ³¥Î¡C¨ã¦³°ªªºP2X3«ú§Ü¬¡©Ê¡A¥B¨ã¦³¸û¦nªº¿ï¾Ü©Ê¡A¬r©Ê¸û§C¡B¥NÁÂéw©Ê¸û¦n¡B¨ýı¼vÅT¸û¤p¡C¡]¨£ºKnªþ¹Ï¡^
ªþ¹Ï :

[30] Àu¥ýÅv : 2020/06/29¡A¤¤°ê¤º¦a China¡A½s¸¹N.º 202010610052.6
[21] ½s¸¹ : J/009581
[22] ¥Ó½Ð¤é : 2025/06/25
[24] §å¥Ü¤é : 2025/07/29
[73] Åv§Q¤H : ¤¤¥~»sÃĮ覡·|ªÀ
¦a§} : 5-1, Ukima 5-chome, Kita-ku, Tokyo 115-8543, Japan
°êÄy : ¤é¥»
[73] Åv§Q¤H : °ê¥ß¤j¾Çªk¤H¤j¨Á¤j¾Ç
¦a§} : 1-1, Yamadaoka, Suita-shi, Osaka 565-0871 Japan
°êÄy : ¤é¥»
[72] µo©ú¤H : °í¥Ð¤¯, ¨°¤x¥[©`¤l, ªQ¥Ðöø, ²M¤ôÂ@, ¤W§ø±N¾ð, ¤p´Ë¹t«h, Ô³¸Î¦¸, ¤«¤t´¼¤§, ªe¤º§»¾ð, ªL§»¾ð, 坂¤f§Ó¤å, ¶i¼e©ú
°ê®aª¾ÃѲ£Åv§½µo©ú±M§Q : ±M§Q¸¹N.º de patente ZL202280044888.1¡A¥Ó½Ð¤éData de pedido 2022/06/24¡A±ÂÅv¤½§i¸¹N.º de anúncio da concessão CN 117545779B¡A2025/04/04
[51] ¤ÀÃþ : C07K16/28, C12N15/13, A61P43/00, A61P35/00, A61K45/00, A61K39/395
[54] ¼ÐÃD : §ÜCTLA-4§ÜÅ骺¥Î³~¡C
[57] ºKn : ¥»¤½¶}´£¨Ñ¤F§ÜCTLA-4§ÜÅé¥H¤Î²£¥Í©M¨Ï¥Î©Òz§ÜÅ骺¤èªk¡C¥»¤½¶}ÁÙ´£¨Ñ¤F½s½X§ÜCTLA-4§ÜÅ骺®Ö»Ä©M§t¦³©Òz®Ö»Äªº±J¥D²ÓM¡C¦¹¥~¡A¥»¤½¶}´£¨Ñ¤F§t¦³ÅÜÅéFc°Ïªº¦h肽¥H¤Î²£¥Í©M¨Ï¥Î©Òz¦h肽ªº¤èªk¡A©ÒzÅÜÅéFc°Ï¥]§t¿Ë¥»Fc°Ï¤¤ªº®ò°ò»Ä§ïÅÜ¡C
[30] Àu¥ýÅv : 2021/06/25¡A¤é¥» Japão¡A½s¸¹N.º 2021-105823
[21] ½s¸¹ : J/009583
[22] ¥Ó½Ð¤é : 2025/06/25
[24] §å¥Ü¤é : 2025/07/29
[73] Åv§Q¤H : ¥_¨ÊªF¤è¦Ê®õ¥Íª«¬ì§ÞªÑ¥÷¦³¤½¥q
¦a§} : ¤¤°ê¥_¨Ê¥«¤j¿³°Ï¥_¨Ê¸gÀÙ§Þ³N¶}µo°Ïºa¨ÊªFµó2¸¹1¼l406«Ç
°êÄy : ¤¤°ê
[73] Åv§Q¤H : ¥_¨Êºë¯q®õµ¾§Þ³Nµo®i¦³¤½¥q
¦a§} : ¤¤°ê¥_¨Ê¥«¤j¿³°Ï¥_¨Ê¸gÀÙ§Þ³N¶}µo°Ïºa¨ÊªFµó2¸¹
°êÄy : ¤¤°ê
[72] µo©ú¤H : ¥Õ¸q
°ê®aª¾ÃѲ£Åv§½µo©ú±M§Q : ±M§Q¸¹N.º de patente ZL202310652547.9¡A¥Ó½Ð¤éData de pedido 2023/06/05¡A±ÂÅv¤½§i¸¹N.º de anúncio da concessão CN 119080927B¡A2025/06/24
[51] ¤ÀÃþ : C07K16/24, G01N33/68, A61K39/395, A61P29/00, A61P35/00, A61P37/02
[54] ¼ÐÃD : ¤@ºØµ²¦XIL-11ªº§ÜÅé¡B¨ä§Üìµ²¦X¤ù¬q¤ÎÀ³¥Î¡C
[57] ºKn : ¥»µo©ú¯A¤Î¥Íª«ÂåÃÄ»â°ì¡A¨ãÅé´£¨Ñ¤F¤@ºØµ²¦XIL-11ªº§ÜÅé©Î¨ä§Üìµ²¦X¤ù¬q¡A¥]¬A3Ó¤À§O¥ÎHCDR1¡BHCDR2©MHCDR3ªí¥Üªº«Ã줬¸É¨M©w°Ï©M3Ó¤À§O¥ÎLCDR1¡BLCDR2©MLCDR3ªí¥Üªº»´Ã줬¸É¨M©w°Ï¡A©Òz§ÜÅé©Î¨ä§Üìµ²¦X¤ù¬q¿ï¦ÛA-I¡BA-¢º¡BA-¢»©ÎA-¢¼¡C¥»µo©ú´£¨Ñªº§ÜÅé©Î¨ä§Üìµ²¦X¤ù¬q»PIL-11§Üì¨ã¦³¸û°ªªºµ²¦X¯à¤O¡A¯à°÷ªýÂ_IL-11§Üì»P¨ä¨üÅ骺µ²¦X¡A¶i¦Ó¦³®Ä§í¨îIL-11ªº«PÅÖºû¤Æ§@¥Î¡A§í¨î©Î¹w¨¾ÅÖºû²ÓMªº²£¥Í©Î¼W´Þ¡A¯à°÷¦³®Ä¥Î©óªvÀø©Î¹w¨¾¤HÃþÅÖºû¤Æ¯e¯f¡Bª¢¯g¡BÀù¯g©Î¦Û¨§K¬Ì©Ê¯e¯f¡C
ªþ¹Ï :

[21] ½s¸¹ : J/009584
[22] ¥Ó½Ð¤é : 2025/06/26
[24] §å¥Ü¤é : 2025/07/29
[73] Åv§Q¤H : ¦¿¤¤ÃÄ·~ªÑ¥÷¦³¤½¥q
¦a§} : ¤¤°ê¦¿¦è¬Ù«n©÷¥«¤õ¬²¤j¹D788¸¹¶l½s 330096
°êÄy : ¤¤°ê
[72] µo©ú¤H : ¼B¤å§g Wenjun LIU, ¶ÀÀR Jing HUANG, ºµÆvÁø Yanxia XIONG, «¸ÕæÃY Lingjuan JIANG, ¾G³·ÄR Xueli ZHENG, §õ¨Î»¨ Jiahao LI, ±i¶§ Yang ZHANG, ³¯¨R Chong CHEN, ±öÄR¨È Liya MEI, ®æ¤é°Ç Rile GE, °K»T Rong YUAN, ¨v®R®R Nana XIAO
°ê®aª¾ÃѲ£Åv§½µo©ú±M§Q : ±M§Q¸¹N.º de patente ZL202411856443.0¡A¥Ó½Ð¤éData de pedido 2024/12/17¡A±ÂÅv¤½§i¸¹N.º de anúncio da concessão CN 119331785B¡A2025/04/04
[51] ¤ÀÃþ : C12N1/20, A61K35/745, A61P1/00, A61P1/04, A61P1/10, A23L33/135, C12R1/01
[54] ¼ÐÃD : ½w¸Ñ¼ìºÅ©Êµ²¸zª¢¤Î«K¯µªº°Êª«Âùª[±ìµß¨Å¨ÈºØ¤Î¨äÀ³¥Î¡C
[57] ºKn : ¥»µo©ú¤½¶}¤F½w¸Ñ¼ìºÅ©Êµ²¸zª¢¤Î«K¯µªº°Êª«Âùª[±ìµß¨Å¨ÈºØ¤Î¨äÀ³¥Î¡AÄÝ©ó·L¥Íª«»â°ì¡C¥»µo©ú¿z¿ï¥X¤@®è¥À¨Å·½°Êª«Âùª[±ìµß¨Å¨ÈºØ¡]Bifidobacterium animalis subsp. lactis¡^LIHUO 01¡A¸Óµß®è©ó2024¦~11¤ë20¤é«OÂéó¼sªF¬Ù·L¥Íª«µßºØ«OÂ䤤ߡA«OÂýs¸¹¬°GDMCC No:65512¡C¦¹°Êª«Âùª[±ìµß¨Å¨ÈºØLIHUO 01¨ã¦³¨}¦nªºÅé¥~¯q¥Í¯S©Ê¡A¨ã¦³½w¸Ñ¼ìºÅ©Êµ²¸zª¢¡B§ïµ½«K¯µ¡B½Õ¸`¸z¹Dµß¸sªº§@¥Î¡A¦b»s³Æ½w¸Ñ¼ìºÅ©Êµ²¸zª¢©Î§ïµ½«K¯µ©Î¸z¹Dµß¸s½Õ¸`ªº¹«~©Î«O°·«~©ÎÃÄ«~¨ã¦³«Ü¦nªºÀ³¥Î«e´º¡C
ªþ¹Ï :
[21] ½s¸¹ : J/009585
[22] ¥Ó½Ð¤é : 2025/06/26
[24] §å¥Ü¤é : 2025/07/29
[73] Åv§Q¤H : µøÂI»sÃĤ½¥q
¦a§} : 480 Pleasant St., Ste. A-210, Watertown, MA. 02472, United States
°êÄy : ¬ü°ê
[72] µo©ú¤H : S¡D¶ë©i, M¡DÀNµØ¼w¡D´µ©¬§J´µ, D¡D©¬°òÔÕ¹p¿Õ, B¡D¥d¶
°ê®aª¾ÃѲ£Åv§½µo©ú±M§Q : ±M§Q¸¹N.º de patente ZL202211200614.5¡A¥Ó½Ð¤éData de pedido 2021/09/13¡A±ÂÅv¤½§i¸¹N.º de anúncio da concessão CN 115531352B¡A2025/04/25
[51] ¤ÀÃþ : A61K9/70, A61K9/00, A61K31/4045, A61K47/32, A61P27/02, A61P9/10, A61P3/10
[54] ¼ÐÃD : ¥i¥Íª«»k¸Ñªº²´³¡ÃĪ«»¼°e´¡¤J¾¯¤ÎªvÀø¤èªk¡C
[57] ºKn : ¥»µo©ú¯A¤Î¥Î©ó¦V²´·úÄÀ©ñ¬¡©ÊÃĪ«¦¨¤Àªº¥i´Ó¤Jªº¥Íª«¥i»k¸Ñªº´¡¤J¾¯¡C¥»µo©úÁÙ¯A¤Î¨Ï¥Î³oºØ´¡¤J¾¯ªºªvÀø¤èªk¥H¤Î»s³y³oºØ´¡¤J¾¯ªº¤èªk¡C
ªþ¹Ï :

[30] Àu¥ýÅv : 2020/09/14¡A¬ü°ê Estados Unidos da América¡A½s¸¹N.º 63/078,265
2021/04/19¡A¬ü°ê Estados Unidos da América¡A½s¸¹N.º 63/176,430
2021/05/18¡A¬ü°ê Estados Unidos da América¡A½s¸¹N.º 63/190,052
[21] ½s¸¹ : J/009586
[22] ¥Ó½Ð¤é : 2025/06/26
[24] §å¥Ü¤é : 2025/07/29
[73] Åv§Q¤H : «ô¶ø¥d¼wÁp¦XªÑ¥÷¤½¥q
¦a§} : Liter A, BLD. 34, Svyazi St. Strelna, Petrodvortsoviy District St. Petersburg, 198515 Russian Federation
°êÄy : «Xù´µÁp¨¹
[72] µo©ú¤H : K¡DV¡DÁ³¨½¿Õ¤Ò, S¡DA¡D¤°°¨¬ì¤Ò, D¡DN¡Dªü¶ð²ö¿Õ«½, I¡DI¡D°ª¨È¹ç, O¡DS¡D¿p¨Fù«½, I¡DV¡D¥Ö´µ®w¿Õ«½, I¡DV¡D¶O¦hù«½, T¡DI¡D¯ª¥¬¬ì, M¡DA¡DÀN¦hº¸¬ì¤Ò´µ°ò, G¡DE¡Dªi¨©¥[¬¥¤Ò, A¡DN¡Dªüº¸ÁÂ¥§¯I¤Ò, P¡DA¡DÁɺ¸¬ì«½, A¡DA¡D¥Ë¦è¦C«½, T¡DO¡Dªü¶ð²ö¿Õ«½, M¡DV¡Dªü¥¬©Ô²ö«½
°ê®aª¾ÃѲ£Åv§½µo©ú±M§Q : ±M§Q¸¹N.º de patente ZL201980090346.6¡A¥Ó½Ð¤éData de pedido 2019/11/26¡A±ÂÅv¤½§i¸¹N.º de anúncio da concessão CN 113785055B¡A2025/06/20
[51] ¤ÀÃþ : C12N9/22, C12N15/55, C12N15/113, C12N15/90
[54] ¼ÐÃD : DNA¤Á³Î¾¯¡C
[57] ºKn : ¥»µo©ú´yz¤F¨Ó¦Û¸ÑÅÖºû±ôµß²ÓµßªºCRISPR-Cas9¨t²Îªº·s²Óµß®Ö»Ä酶¡A¥H¤Î©Òz®Ö»Ä酶¥Î©ó¦bDNA¤À¤l¤¤²£¥ÍÄY®æ¯S²§©ÊÂùÃìÂ_µõªº¥Î³~¡C¥»µo©úªº®Ö»Ä酶ªí²{¥X¤£´M±`ªº«~½è¡A¨Ã¥B¥i¥H¥Î§@¥Î©ó±NÅܤƤޤJ¦b³æ²ÓM¥Íª«©M¦h²ÓM¥Íª«ªº°ò¦]²ÕDNA§Ç¦C¤¤ÄY®æ³W©wªº¦ìÂIªº¤u¨ã¡C¦]¦¹¡A¥»µo©ú¼W¥[¤F¥i¥ÎªºCRISPR-Cas9¨t²Îªº¦h¥\¯à©Ê¡A¨ä¨Ï±o¯à°÷¨Ï¥Î¨Ó¦Û¦UºØ¥Íª«ªºCas9®Ö»Ä酶¡A¥H«K¦b¤j¶q¯S²§©Ê¦ìÂI©M¼eªº·Å«×½d³ò¤º¤Á³Î°ò¦]²ÕDNA©M½è²ÉDNA¡C¥»µo©úÁÙ²¤Æ¤F¥Íª«§Þ³N¬ÛÃöªº¸ÑÅÖºû±ôµß²Óµßªº°ò¦]²Õªº½s¿è¡C
ªþ¹Ï :

[30] Àu¥ýÅv : 2018/11/26¡A«Xù´µÁp¨¹ Federação da Rússia¡A½s¸¹N.º 2018141524
[21] ½s¸¹ : J/009587
[22] ¥Ó½Ð¤é : 2025/06/26
[24] §å¥Ü¤é : 2025/07/29
[73] Åv§Q¤H : ¨½®æº¸ÃÄ«~ªÑ¥÷¦³¤½¥q
¦a§} : 611 Gateway Boulevard, Suite 900, South San Francisco, California 94080, United States of America
°êÄy : ¬ü°ê
[72] µo©ú¤H : ®J´µ¯S¯Z¡D°¨Ä¬¹F, ¦è»X¡D¨v, ¥Ë©g²ï¡D®õ°Ç, ¯Á°¨¶ë¥d¡D¤Ú¦Ì}©¬´£
°ê®aª¾ÃѲ£Åv§½µo©ú±M§Q : ±M§Q¸¹N.º de patente ZL201980045101.1¡A¥Ó½Ð¤éData de pedido 2019/05/02¡A±ÂÅv¤½§i¸¹N.º de anúncio da concessão CN 112368278B¡A2025/06/17
[51] ¤ÀÃþ : C07D413/14, C07D413/12, A61P37/02, A61P29/00, A61K31/553
[54] ¼ÐÃD : RIP1§í¨î©Ê¤Æ¦Xª«¥H¤Î»s³Æ©M¨Ï¥Î¨äªº¤èªk¡C
[57] ºKn : ¥»¤å¤½¶}¤F¿E酶§í¨î©Ê¤Æ¦Xª«¡A¨Ò¦p¨üÅé¬Û¤¬§@¥Î³J¥Õ-1¡]RIP1¡^¿E酶§í¨î¾¯¤Æ¦Xª«¡A¥H¤Î¥]§t¦¹Ãþ§í¨î©Ê¤Æ¦Xª«ªºÃĪ«²Õ¦Xª«©M²Õ¦X¡C¤½¶}ªº¤Æ¦Xª«¡BÃĪ«²Õ¦Xª«©M/©Î²Õ¦X¥i¥H¥Î©óªvÀø©Î¹w¨¾¿E酶¬ÛÃö¯e¯f©Î¯f¯g¡A¯S§O¬ORIP1¬ÛÃö¯e¯f©Î¯f¯g¡C
[30] Àu¥ýÅv : 2018/05/03¡A¬ü°ê Estados Unidos da América¡A½s¸¹N.º 62/666,462
[21] ½s¸¹ : J/009588
[22] ¥Ó½Ð¤é : 2025/06/27
[24] §å¥Ü¤é : 2025/07/29
[73] Åv§Q¤H : ·ç¿A®¦»sÃĤ½¥q
¦a§} : 777 Old Saw Mill River Road, Tarrytown, New York 10591, United States of America
°êÄy : ¬ü°ê
[72] µo©ú¤H : C¡DÀ¹§Q, G¡D·æ´µ¹y, N¡D©¬©¬¦õ´¶¬¥´µ
°ê®aª¾ÃѲ£Åv§½µo©ú±M§Q : ±M§Q¸¹N.º de patente ZL202080042521.7¡A¥Ó½Ð¤éData de pedido 2020/04/09¡A±ÂÅv¤½§i¸¹N.º de anúncio da concessão CN 113993898B¡A2025/05/27
[51] ¤ÀÃþ : C07K16/28, C12N15/13, A61K39/395, A61K45/06, A61P35/00, A61P35/02, A61P29/00, A61P25/04, A61P25/00
[54] ¼ÐÃD : µ²¦XRETªº¤H§ÜÅé¤Î¨ä¨Ï¥Î¤èªk¡C
[57] ºKn : ¥»µo©ú´£¨Ñ»PRET¨üÅé¹T®ò»Ä¿E酶µ²¦Xªº¥þ¤H§ÜÅé¡B¥]§t©Òz§ÜÅ骺²Õ¦Xª«©M¨Ï¥Î¤èªk¡C¥»µo©úªº§ÜÅé¾A¥Î©óªvÀø»P©ÒzRET¨üÅé¹T®ò»Ä¿E酶°ò¦]©Î¨ä«±Æ§Î¦¡ªºªí¹F¡B¬¡¤Æ©Î«H¸¹¶Ç¾É¬ÛÃöªº¯e¯f¡B¯f¯g©Î¯fªp¡A¥]¬AÀù©Ê¯fªp©M»PÀù¯g¬ÛÃöªº¯kµh¡A©Î¾A¥Î©ó´î»´»P¦Ü¤Ö³¡¤À¦aÂk¦]©óRETªºªí¹F¡B¬¡¤Æ©Î«H¸¹¶Ç¾Éªº¨ä¥¦¯fªp¬ÛÃöªº¯kµh¡C¹ïRET¨ã¦³¯S²§©Êªº©Òz§ÜÅé¥i¾A¥Î©ó©µ½w¸~½F²ÓM¥Íªø©Î¸~½F²ÓM¼W´Þ¡A¨Ã¥B¤]¥i¾A¥Î©ó´î»´»P©ÒzÀù¯g©M¨ä¥¦¯fªp¬ÛÃöªº¯kµh¡C©Òz§ÜÅé¤]¥i¾A¥Î©ó¶EÂ_»PRET¬¡¤Æ©Î«H¸¹¶Ç¾É¬ÛÃöªº¯e¯f¡B¯f¯g©Î¯fªp¡C
[30] Àu¥ýÅv : 2019/04/10¡A¬ü°ê Estados Unidos da América¡A½s¸¹N.º 62/832,218
[21] ½s¸¹ : J/009589
[22] ¥Ó½Ð¤é : 2025/06/27
[24] §å¥Ü¤é : 2025/07/29
[73] Åv§Q¤H : PVTE¦³¤½¥q
¦a§} : 69/169 Moo 1, Tambol Ban Mai, Aumphor Pakkret, Nonthaburi 11120, Thailand
°êÄy : ®õ°ê
[72] µo©ú¤H : T¡D§Q©Ô¬ù«½ Tanunt LEELAYOOVA, U¡Dªi©¬} Uracha POOPAKDEE
°ê®aª¾ÃѲ£Åv§½µo©ú±M§Q : ±M§Q¸¹N.º de patente ZL202080006361.0¡A¥Ó½Ð¤éData de pedido 2020/02/04¡A±ÂÅv¤½§i¸¹N.º de anúncio da concessão CN 113167632B¡A2025/06/13
[51] ¤ÀÃþ : G01F25/10
[54] ¼ÐÃD : ²GÅé¬y¶qpªº®Õ·Ç¤èªk¡C
[57] ºKn : ¤@ºØ¥Î©ó²GÅé¬y¶qpªº®Õ·Ç¤èªk¡A©Òz®Õ·Ç¤èªk¥]¬A¡G´£¨Ñ¥Î©ó±µ¦¬«Ý´ú¶qªº²GÅ骺²Ä¤@Åø¡]12¡^©M³s±µ¨ì²Ä¤@Åø¡]12¡^ªº²GÅéÀxÅø¡]14¡^¡F´£¨Ñ¥Î©ó±N²GÅé±q²GÅéÀxÅø¡]14¡^¿é°e¨ì¥~³¡¸Ë¸mªº²GÅ黼°eºÞ½u¡]9¡^¡F´£¨Ñ¥Î©ó¹ï®e¯Ç¦b²Ä¤@Åø¡]12¡^©Î²GÅéÀxÅø¡]14¡^¤¤ªº²GÅé¶i¦æºÙ«ªººÙ«¶Ç·P¾¹¡]22¡^¡A¨ä¤¤¡A¦b¹ï¬y¶qp¡]20¡^°õ¦æ®Õ·Ç´Á¶¡¡G±N²GÅ黼°eºÞ½u¡]9¡^¦b¿é°e¤è¦V¤W¦b²GÅé¬y¶qp¡]20¡^ªº¤U´å»P¥~³¡¸Ë¸mÂ_¶}¡F±N²GÅ黼°eºÞ½u¡]9¡^¦b¿é°e¤è¦V¤W¦b²GÅé¬y¶qp¡]20¡^ªº¤U´å³s±µ¨ì®Õ·ÇºÞ½u¡]7¡^¡A©Òz®Õ·ÇºÞ½u³s±µ¨ì²Ä¤@Åø¡]12¡^¡F¥H¤Î°ò©ó¥ÑºÙ«¶Ç·P¾¹¡]22¡^´ú±oªº²GÅé«¶q¦b¹w©w®É¶¡¶¡¹j¤ºªº§ïÅܨӽT©w©Ò¿é°eªº²GÅé¦b¹w©w®É¶¡¶¡¹j¤ºªº¬y³t¡A¨ä¤¤¡A±N²GÅé±q²GÅéÀxÅø¡]14¡^³q¹L²GÅ黼°eºÞ½u¡]9¡^»¼°e¦^¨ì²Ä¤@Åø¡]12¡^¡A¨Ã¥B¬°¤F¨Ï²GÅé±q²GÅéÀxÅø¡]14¡^¨ì²Ä¤@Åø¡]12¡^ªº¬y³t¦b®Õ·Ç´Á¶¡°ò¥»¤WùÚ©w¦Ó¹ï©Òz¬y³t¶i¦æ±±¨î¡C
ªþ¹Ï :

[30] Àu¥ýÅv : 2019/04/10¡A®õ°ê Tailândia¡A½s¸¹N.º 1903000869
[21] ½s¸¹ : J/009590
[22] ¥Ó½Ð¤é : 2025/06/27
[24] §å¥Ü¤é : 2025/07/29
[73] Åv§Q¤H : ¿W¥ß¦æ¬Fªk¤H°ê¥ß°ªµ¥±Mªù¾Ç®Õ¾÷ºc
¦a§} : 701-2, Higashiasakawa-machi, Hachioji-shi, Tokyo 1930834, JP
°êÄy : ¤é¥»
[73] Åv§Q¤H : ®è¦¡·|ªÀ®cªF³¥¯ó¬ã¨s©Ò
¦a§} : 7-7, Kodan-cho, Myoko-shi, Niigata, Japan
°êÄy : ¤é¥»
[72] µo©ú¤H : °ª«ÎªB¹ü Tomoaki KOUYA, ¥Û¤s¬v¥ Yohei ISHIYAMA
°ê®aª¾ÃѲ£Åv§½µo©ú±M§Q : ±M§Q¸¹N.º de patente ZL202180047869.X¡A¥Ó½Ð¤éData de pedido 2021/02/19¡A±ÂÅv¤½§i¸¹N.º de anúncio da concessão CN 115836121B¡A2025/04/11
[51] ¤ÀÃþ : C12N1/20, C12N15/11, A23L33/135, A23L2/52, A23C9/123
[54] ¼ÐÃD : ¨Å»Äµß¤Î¨ä¨ú±o¤èªk¥H¤Î§t¨Å»Äµßªº¶¼¹«~¡C
[57] ºKn : ¥»µo©ú´£¨Ñ¤@ºØ¦b§CpH¥B°ª½©¿}Àô¹Ò¤U¨}¦n¥Íªøªº¨Å»Äµß¡C¤@ºØ¨Å»Äµß¡A¨ä¬O¥H«OÂø¹¡GNITE
ªþ¹Ï :

[30] Àu¥ýÅv : 2020/10/12¡A¤é¥» Japão¡A½s¸¹N.º 2020-171989
2020/12/23¡A¤é¥» Japão¡A½s¸¹N.º 2020-214170
[21] ½s¸¹ : J/009591
[22] ¥Ó½Ð¤é : 2025/06/27
[24] §å¥Ü¤é : 2025/07/29
[73] Åv§Q¤H : ¥_¨Ê¨Ó¤]ºôµ¸¬ì§Þ¦³¤½¥q
¦a§} : ¤¤°ê¥_¨Ê¥«®ü¾ý°Ï¤¦Ù±¸ô3¸¹¤¤°ê¹q¤l¤j·H19¼h1902¡A¶l½s 100080
°êÄy : ¤¤°ê
[73] Åv§Q¤H : ¨Ó¤]¬ì§Þ¡]¥_¨Ê¡^¦³¤½¥q
¦a§} : ¤¤°ê¥_¨Ê¥«®ü¾ý°Ï¤¦Ù±µó3¸¹B®y14¼h58
°êÄy : ¤¤°ê
[72] µo©ú¤H : ¨L«a¬K, J¤@¤t, »u·ç, §õÞ³, ¿cªi, ¶À¦w, ¤ý«Ø©P
°ê®aª¾ÃѲ£Åv§½µo©ú±M§Q : ±M§Q¸¹N.º de patente ZL202010788851.2¡A¥Ó½Ð¤éData de pedido 2020/08/07¡A±ÂÅv¤½§i¸¹N.º de anúncio da concessão CN 112115774B¡A2025/04/18
[51] ¤ÀÃþ : G06V30/412, G06V30/14, G06V30/146, G06V30/148, G06V30/19
[54] ¼ÐÃD : µ²¦XRPA©MAIªº¤å¦rÃѧO¤èªk¡B¸Ë¸m¡B¹q¤l³]³Æ©M¦sÀx¤¶½è¡C
[57] ºKn : ¥»¥Ó½Ð´£¥X¤@ºØµ²¦XRPA©MAIªº¤å¦rÃѧO¤èªk¡B¸Ë¸m¡B¹q¤l³]³Æ©M¦sÀx¤¶½è¡A¯A¤Î¤H¤u´¼¯à§Þ³N»â°ì¡A¨ä¤¤¡A¨ãÅ餽¶}ªº§Þ³N¤è®×¬°¡GAI¥»O±µ¦¬RPA¾÷¾¹¤Hµo°eªº¹Ï¹³¡AAI¥»O±q¹Ï¹³¤¤Àò¨úªí®æ°Ï°ì¹Ï¹³¡FAI¥»O±qªí®æ°Ï°ì¹Ï¹³¤¤´£¨ú¦Uӳ椸®æ¡FAI¥»O®Ú¾Ú¦Uӳ椸®æªº¦ì¸m«H®§ºc«Øªí®æ¡FAI¥»O±q¹Ï¹³¤¤´£¨ú¦Uӳ椸®æ¤ºªº¤å¦r«H®§¡A¨Ã®Ú¾Ú¤å¦r«H®§©Mªí®æ¥Í¦¨¤å¦rÃѧOµ²ªGµo°eµ¹RPA¾÷¾¹¤H¡C¥Ñ¦¹¡A¸Ñ¨M¤F²{¦³§Þ³N¤¤¤å¦rÃѧO·Ç½T©Ê®t¡B®Ä²v§Cªº§Þ³N°ÝÃD¡A³q¹Lº¥ýºc«Ø¹Ï¹³¤¤ªºªí®æ¡A¦A±q¹Ï¹³¤¤´£¨úªí®æ¤ºªº¤å¦r«H®§¡A¯à°÷§Ö³t·Ç½T§¹¦¨¹Ï¹³¤¤ªº¤å¦rÃѧO¡C
ªþ¹Ï :

[21] ½s¸¹ : J/009592
[22] ¥Ó½Ð¤é : 2025/06/27
[24] §å¥Ü¤é : 2025/07/29
[73] Åv§Q¤H : ¥_¨Ê¨Ó¤]ºôµ¸¬ì§Þ¦³¤½¥q
¦a§} : ¤¤°ê¥_¨Ê¥«®ü¾ý°Ï¤¦Ù±¸ô3¸¹¤¤°ê¹q¤l¤j·H19¼h1902¡A¶l½s 100080
°êÄy : ¤¤°ê
[73] Åv§Q¤H : ¨Ó¤]¬ì§Þ¡]¥_¨Ê¡^¦³¤½¥q
¦a§} : ¤¤°ê¥_¨Ê¥«®ü¾ý°Ï¤¦Ù±µó3¸¹B®y14¼h58
°êÄy : ¤¤°ê
[72] µo©ú¤H : ¤ý°ê´É, ±i«i, ¨L«a¬K, J¤@¤t, »u·ç, §õÞ³
°ê®aª¾ÃѲ£Åv§½µo©ú±M§Q : ±M§Q¸¹N.º de patente ZL202111619018.6¡A¥Ó½Ð¤éData de pedido 2021/12/27¡A±ÂÅv¤½§i¸¹N.º de anúncio da concessão CN 114416888B¡A2025/04/18
[51] ¤ÀÃþ : G06F16/28, G06F8/30, G06Q10/10
[54] ¼ÐÃD : µ²¦XRPA©MAIªº¼Æ¾Ú³B²z¤èªk¡B¸Ë¸m¡B¹q¤l³]³Æ¤Î¦sÀx¤¶½è¡C
[57] ºKn : ¥»¤½¶}´£¥X¤@ºØµ²¦XRPA©MAIªº¼Æ¾Ú³B²z¤èªk¡B¸Ë¸m¡B¹q¤l³]³Æ¤Î¦sÀx¤¶½è¡AÀ³¥Î©ó¦ÛµM»y¨¥³B²z¡]Natural Language Processing¡ANLP¡^¡A¸Ó¤èªk¥]¬A¡G±Ä¥Î¾÷¾¹¤H¬yµ{¦Û°Ê¤ÆRPA¤èªk±µ¦¬³B²z½Ð¨D¡A³B²z½Ð¨D¥]¬A¡G¹êÅ鮨¬[¤¤«Ý³B²z¼Æ¾Úªº¼ÐÃÑ¡F±Ä¥ÎRPA¤èªk®Ú¾Ú¼ÐÃÑ¡AÀò¨ú¼Æ¾Ú³B²z¤èªk¡F¥H¤Î±Ä¥ÎRPA¤èªkµ²¦X¤H¤u´¼¯àAI¡A®Ú¾Ú¼Æ¾Ú³B²z¤èªk¡A³B²z«Ý³B²z¼Æ¾Ú©MÃöÁp¼Æ¾Ú¡A¨ä¤¤¡A«Ý³B²z¼Æ¾Ú©MÃöÁp¼Æ¾Ú¤§¶¡¨ã¦³¹êÅ鮨¬[¤¤ªºÃä½tÃöÁpÃö«Y¡C¦b§Q¥Î¤H¤u´¼¯àAIµ²¦X¾÷¾¹¤H¬yµ{¦Û°Ê¤ÆRPA¶i¦æ¼Æ¾Ú³B²z®É¡A¹ê²{¼Æ¾Úªº¦Û°Ê¤ÆªºÃöÁp³B²z¡A¦³®Ä°§C¼Æ¾ÚÃöÁp³B²z¹Lµ{¤¤©Ò®ø¯Óªº¦¨¥»¡A·í°ò©ó¹êÅ鮨¬[¤¤«Ý³B²z¼Æ¾Úªº¼ÐÃѽT©w¹ïÀ³¼Æ¾Ú³B²z¤èªk®É¡A¯à°÷¦³®ÄÝÅU¼Æ¾ÚÃöÁp³B²zªº¦Û°Ê¤Æµ{«×©MÃöÁp³B²zªº¥i¾a©Ê¡C
ªþ¹Ï :

[21] ½s¸¹ : J/009593
[22] ¥Ó½Ð¤é : 2025/06/27
[24] §å¥Ü¤é : 2025/07/29
[73] Åv§Q¤H : ¦Ê®É¬ü¬I¶QÄ_¤½¥q
¦a§} : Rt.206 and Province Line Road, Princeton, New Jersey 08543-4000,U.S.A.
°êÄy : ¬ü°ê
[72] µo©ú¤H : M¡D´µ¯S©Ô·æ´µ, J¡DH¡DÀ¹ºû´µ, M¡DL¡D¹Dº¸, P¡DA¡D°¨}¨È
°ê®aª¾ÃѲ£Åv§½µo©ú±M§Q : ±M§Q¸¹N.º de patente ZL201980033780.0¡A¥Ó½Ð¤éData de pedido 2019/03/27¡A±ÂÅv¤½§i¸¹N.º de anúncio da concessão CN 112154153B¡A2025/05/23
[51] ¤ÀÃþ : C07K14/55, C07K14/715, A61K38/20
[54] ¼ÐÃD : ¥Õ¤¶¯À-2/¥Õ¤¶¯À-2¨üÅé£\¿Ä¦X³J¥Õ¥H¤Î¨Ï¥Î¤èªk¡C
[57] ºKn : ¥»¤å¤½¶}¤F¿Ä¦X³J¥Õ¡A¨ä¥]§t¡G¡]a¡^¥]§t¥Õ¤¶¯À-2¡]IL2¡^ªº²Ä¤@¦h肽¡F©M¡]b¡^»P©Òz²Ä¤@¦h肽®Ø¤º¿Ä¦Xªº²Ä¤G¦h肽¡A¨ä¤¤©Òz²Ä¤G¦h肽¥]§t¥Õ¤¶¯À-2¨üÅé£\¡]IL2R£\¡^ªºM¥~µ²ºc°ì¡A¨ä¤¤IL2©ÎIL2R£\»P¤ÑµMIL2©Î¤ÑµMIL2R£\¬Û¤ñ¡A¥]§t¦Ü¤Ö¤Ö¤@Ó¿}°ò¤Æ¦ìÂI¡CÁÙ¤½¶}¤F©Òz¿Ä¦X³J¥Õªº¥Í²£¤èªk©MªvÀø¨Ï¥Îªº¤èªk¡C
[30] Àu¥ýÅv : 2018/03/28¡A¬ü°ê Estados Unidos da América¡A½s¸¹N.º 62/649,379
[21] ½s¸¹ : J/009594
[22] ¥Ó½Ð¤é : 2025/06/27
[24] §å¥Ü¤é : 2025/07/29
[73] Åv§Q¤H : ¦ã«ä¯q«H®§À³¥Î§Þ³NªÑ¥÷¤½¥q
¦a§} : 35-2, Takadanobaba 3-chome, Shinjuku-ku, Tokyo 1690075, Japan
°êÄy : ¤é¥»
[72] µo©ú¤H : ¶Â¥ÐÁo Satoshi KURODA
°ê®aª¾ÃѲ£Åv§½µo©ú±M§Q : ±M§Q¸¹N.º de patente ZL202180005310.0¡A¥Ó½Ð¤éData de pedido 2021/04/30¡A±ÂÅv¤½§i¸¹N.º de anúncio da concessão CN 114424183B¡A2025/04/15
[51] ¤ÀÃþ : G06F16/22, G06F16/2455, G06F16/28, G06N3/045, G06V10/82, G06Q10/0639, G06Q30/02, G06V20/52
[54] ¼ÐÃD : «H®§³B²z¸Ë¸m©M«H®§³B²z¤èªk¡C
[57] ºKn : ´£¨Ñ¦p¤Uªº«H®§³B²z¸Ë¸m¡G¤£¶i¦æ¤j³W¼Òªº«H®§ªº«ºc¡A¦b¨Ï¥ÎªÌ»Ýn®É¡A¦V¨Ï¥ÎªÌ´£¥Ü¨Ï¥ÎªÌ»Ýnªº¶qªº«H®§¡C´£¨Ñ¤@ºØ«H®§³B²z¸Ë¸m¡A¨ä¿é¥X»PÀ³¹ïªÌ¶i¦æªº§@·~¦³Ãöªº«H®§§Y§@·~«H®§¡A¨ä¤¤¡A«H®§³B²z¸Ë¸m¨ã¦³¡G¹Ï¹³¨ú±o³¡¡A¨ä¨ú±o¥]§t³QÀ³¹ïªÌ©M¦hÓ³QÀ³¹ïª«ªº¹Ï¹³§Yì©l¹Ï¹³¡F¹Ï¹³¤À³Î³¡¡A¨ä¹ïì©l¹Ï¹³¶i¦æ¤À³Î¡A¤À³Î¦¨©çÄᦳ³QÀ³¹ïªÌªº³QÀ³¹ïªÌ¹Ï¹³©M©çÄᦳ¦UÓ³QÀ³¹ïª«ªº¦hÓ³QÀ³¹ïª«¹Ï¹³¡F³õ´º¦ôp³¡¡A¨ä¨Ï¥Î²Ä1¾Ç²ß§¹¦¨¼Ò«¬¦ôp³õ´º¡A²Ä1¾Ç²ß§¹¦¨¼Ò«¬¦sÀx¦³³QÀ³¹ïªÌ¹Ï¹³»P°ß¤@¦aªí¥Ü§@¬°À³¹ïªÌ¶i¦æªº¨Æ¥óªº³õ´ºªº³õ´ºID¤§¶¡ªºÃöÁp©Ê¡F¼Æ¾Ú¶ô¦ôp³¡¡A¨ä¨Ï¥Î¦hÓ²Ä2¾Ç²ß§¹¦¨¼Ò«¬¤¤ªº¤@Ó²Ä2¾Ç²ß§¹¦¨¼Ò«¬¦ôp¼Æ¾Ú¶ô¡A²Ä2¾Ç²ß§¹¦¨¼Ò«¬¦sÀx¦³¦hÓ³QÀ³¹ïª«¹Ï¹³»P1өΦhӼƾڶô¥Î¤¸ID¤§¶¡ªºÃöÁp©Ê¡A¼Æ¾Ú¶ô¥Î¤¸ID»P°ß¤@¦aªí¥Ü¹ï§@·~«H®§¶i¦æ¤F¤À³Î©Î´£¥Üªº«H®§§Y¼Æ¾Ú¶ôªº¼Æ¾Ú¶ôID¤@¹ï¤@¦a¹ïÀ³¡F¥H¤Î¿é¥X³¡¡A¨ä¿é¥X¼Æ¾Ú¶ô¡A¼Æ¾Ú¶ô¦ôp³¡¨Ï¥Î»P³õ´ºID¤@¹ï¤@¦a¹ïÀ³ªº¼Ò«¬ID¿ï©w¦hÓ²Ä2¾Ç²ß§¹¦¨¼Ò«¬¤¤ªº¤@Ó²Ä2¾Ç²ß§¹¦¨¼Ò«¬¡A¼Æ¾Ú¶ô¥Î¤¸ID°ß¤@¦aªí¥Ü»P³QÀ³¹ïª«ªº©Ê½è¦³Ãöªº«H®§§Y¼Æ¾Ú¶ô¥Î¤¸È¡C
ªþ¹Ï :

[30] Àu¥ýÅv : 2020/05/07¡A¤é¥» Japão¡A½s¸¹N.º 2020-082018
[21] ½s¸¹ : J/009595
[22] ¥Ó½Ð¤é : 2025/06/30
[24] §å¥Ü¤é : 2025/07/29
[73] Åv§Q¤H : ·R¬ü«È§Þ³Nµo®iªÑ¥÷¦³¤½¥q
¦a§} : ¤¤°ê¥_¨Ê¥«´Â¶§°Ï«Ø°ê¸ô¥Ò92¸¹¥@Z¤j·HC®y22¼h 100022
°êÄy : ¤¤°ê
[72] µo©ú¤H : §õºÍ´¼, ¨¦¸Ö°¶, ±i堃
°ê®aª¾ÃѲ£Åv§½µo©ú±M§Q : ±M§Q¸¹N.º de patente ZL202211397949.0¡A¥Ó½Ð¤éData de pedido 2022/11/09¡A±ÂÅv¤½§i¸¹N.º de anúncio da concessão CN 116173293B¡A2025/05/16
[51] ¤ÀÃþ : A61L27/18, A61L27/20, A61L27/12, A61L27/02, A61L27/52, A61L27/58, A61L27/50, C08J3/24, C08L5/08, C08L67/04
[54] ¼ÐÃD : ¤@ºØ½Æ¦X¾®½¦¡B»s³Æ¤èªk¤ÎÀ³¥Î¡C
[57] ºKn : ¥»µo©ú´£¨Ñ¤F¤@ºØ½Æ¦X¾®½¦¡B»s³Æ¤èªk¤ÎÀ³¥Î¡A¯A¤Î¥Íª«Âå¥Î§÷®Æ§Þ³N»â°ì¡C©Òz½Æ¦X¾®½¦¥Ñ»E¨Å»Ä©M¯Ç¦Ì¯ÅµL¾÷§÷®Æ²Õ¦¨ªºÂù¬Û·L²y»P³z©ú½è»Ä¥æÁp»s±o¡F©Òz¤èªk¥]¬A±NÂù¬Û·L²y»P³z©ú½è»Ä¶i¦æ¥æÁp§Î¦¨¤T¬Û¾®½¦¡C¥»µo©ú»s³Æªº½Æ¦X¾®½¦¶°¤TºØ§÷®ÆªºÀu¶Õ©ó¤@Åé¡A¥i¥Î©ó¥Íª«²Õ´ªº¶ñ¥R»P×´_¡C
ªþ¹Ï :

[30] Àu¥ýÅv : 2021/11/29¡A¤¤°ê¤º¦a China¡A½s¸¹N.º 202111431502.6
ªþµù
| ½s¸¹ | §å¥Ü¤é´Á | ªþµù¤§©Ê½è | Åv§Q¤H/¥Ó½Ð¤H | ¤º®e |
| J/003917 | 2025/07/17 | §ó§ï»{§O¸ê®Æ | 1.¥¿¤j¤Ñ´¸ÃÄ·~¶°¹ÎªÑ¥÷¦³¤½¥q 2.ºÃı±ªÑ¡]¥_¨Ê¡^¦³¤½¥q 3.³s¶³´ä¼í衆»sÃĦ³¤½¥q |
1.¥¿¤j¤Ñ´¸ÃÄ·~¶°¹ÎªÑ¥÷¦³¤½¥q 2.ºÃı±ªÑ¡]¥_¨Ê¡^ªÑ¥÷¦³¤½¥q 3.³s¶³´ä¼í衆»sÃĦ³¤½¥q |
| 1.¥¿¤j¤Ñ´¸ÃÄ·~¶°¹ÎªÑ¥÷¦³¤½¥q 2.ºÃı±ªÑ¡]¥_¨Ê¡^ªÑ¥÷¦³¤½¥q 3.³s¶³´ä¼í衆»sÃĦ³¤½¥q |
1.¤¤°ê¦¿Ä¬¬Ù³s¶³´ä¥«§¦{«n¸ô369¸¹¡A¶l½s222062 2.¤¤°ê¥_¨Ê¥«¤j¿³°Ï¥_¨Ê¸gÀÙ§Þ³N¶}µo°ÏºaµØ¤¤¸ô10¸¹1¼lA®y22¼h2205¡A¶l½s¡G100176 3.¤¤°ê¦¿Ä¬¬Ù³s¶³´ä¥«³s¶³´ä¸gÀÙ§Þ³N¶}µo°Ï¤j®ú¤u·~°Ïª÷¾ô¸ô16¸¹¶l½s¡G222069 |
|||
| J/004041 | 2025/07/17 | §ó§ï¦a§} | 1.«n¨Ê·R¼wµ{ÂåÃĬì§Þ¦³¤½¥q 2.¥¿¤j¤Ñ´¸ÃÄ·~¶°¹ÎªÑ¥÷¦³¤½¥q |
1.¤¤°ê¦¿Ä¬¬Ù«n¨Ê¥«¦¿¹ç°ÏÄR¿A¸ô99¸¹6¼l303«Ç¡A¶l½s¡G211100 2.¤¤°ê¦¿Ä¬¬Ù³s¶³´ä¥«§¦{«n¸ô369¸¹¡A¶l½s¡G222062 |
| J/004675 J/005517 |
2025/07/17 | §ó§ï¦a§} | 1.¥¿¤j¤Ñ´¸ÃÄ·~¶°¹ÎªÑ¥÷¦³¤½¥q 2.¥_¨ÊÁɪL®õÂåÃħ޳N¦³¤½¥q 3.³s¶³´ä¼í²³»sÃĦ³¤½¥q 1.CHIA TAI TIANQING PHARMACEUTICAL GROUP CO., LTD. 2.CENTAURUS BIOPHARMA CO., LTD. 3.LIANYUNGANG RUNZHONG PHARMACEUTICAL CO., LTD. |
1.¤¤°ê¦¿Ä¬¬Ù³s¶³´ä¥«§¦{«n¸ô369¸¹ 2.¤¤°ê¥_¨Ê¥«®ü¾ý°Ï¶{²ø¸ô3¸¹¥É¬u¼z¨¦15¸¹¼Ó¤@¼h01«Ç¡A¶l½s¡G100195 3.¤¤°ê¦¿Ä¬¬Ù³s¶³´ä¥«³s¶³´ä¸gÀÙ§Þ³N¶}µo°Ï¤j®ú¤u·~°Ïª÷¾ô¸ô16¸¹ 1.No. 369 Yuzhou South Rd., Lianyungang, Jiangsu 222062, China 3.No. 16 Jinqiao Road, Dapu Industry Park China, Lianyungang Economy and Technology Development Zone, Lianyungang City, Jiangsu 222069, China |
| J/006305 | 2025/07/17 | §ó§ï»{§O¸ê®Æ | ´ò¥_¹Ú¶§ÃÄ·~ªÑ¥÷¦³¤½¥q HUBEI MONYAN PHARMACEUTICAL CO., LTD. |
¹Ú¶§ÃÄ·~ªÑ¥÷¦³¤½¥q MONYAN PHARMACEUTICAL CO., LTD. |
«·sÂର¦³®Ä
| ½s¸¹ | «·sÂର ¦³®Ä¤§¤é´Á |
§å¥Ü¤é´Á | Åv§Q¤H |
| J/006891 | 2025/07/17 | 2025/07/17 | ¥ìµÜ§Q§Q¤½¥q |
µo©ú±M§Qªº«OÅ@
®Ú¾Ú¸g¤Q¤G¤ë¤Q¤T¤é²Ä97/99/M¸¹ªk¥O®Ö㤧¡m¤u·~²£Åvªk«ß¨î«×¡n²Ä¤Q±ø²Ä¤@´Ú¤Î²Ä¤G´Úªº³W©w¡A¤½§G¤U¦C¦b¿Dªù¯S§O¦æ¬F°Ï´£¥Xªºµo©ú±M§Qµù¥U¥Ó½Ð¤§§å¥Ü¡A¨Ã«ö·Ó¦P¤@ªk³W²Ä¤G¦Ê¤C¤Q¤±ø¦Ü²Ä¤G¦Ê¤C¤Q¤C±øªº³W©w¡A¥i©ó¥»¤½§G¤é°_¤@Ó¤ë´Á¤º´N¤U¦C§å¥Ü¦Vªì¯Åªk°|´£°_¤W¶D¡C
©Úµ´
| ½s¸¹ | §å¥Ü¤é´Á | ¥Ó½Ð¤H | ³Æµù ®Ú¾Ú12¤ë13¤é²Ä97/99/M¸¹ªk¥O |
| I/001535 | 2025/07/24 | ¤Ñ¨Ï¶°¹ÎªÑ¥÷¦³¤½¥q | ²Ä98±ø¡A³s¦P²Ä9±ø²Ä1´Úa¡^¶µ©M²Ä61±ø¡C |
¥qªk§P¨M
| ½s¸¹ | ¥Ó½Ð¤H¡þÅv§Q¤H | ªk°| | ¨÷©v½s¸¹ | ½T©w§P¨M¤é´Á |
| 1 I/001775 | Energie-Innovation AG | ªì¯Åªk°| | CV1-24-0096-CRJ | 2025/04/10 |
| 1 ªì¯Åªk°|ºû«ù©Úµ´¦³Ãöµo©ú±M§Qµù¥U¥Ó½Ð¤§§å¥Ü¡C | ||||
¹ê¥Î±M§Qªº«OÅ@
¥Ó½Ð
®Ú¾Ú¸g¤Q¤G¤ë¤Q¤T¤é²Ä97/99/M¸¹ªk¥O®Ö㤧¡m¤u·~²£Åvªk«ß¨î«×¡n²Ä¤Q±ø¤Î²Ä¤@¦Ê¤G¤Q¥|±øªº³W©w¡A¤½§G¤U¦C¦b¿Dªù¯S§O¦æ¬F°Ï´£¥Xªº¹ê¥Î±M§Qµù¥U¥Ó½Ð¡A¦Û¥»³q§i¤½§G¤é°_¦Ü±Â¤©±M§Q¤§¤é¤î¡A¥ô¦ó²Ä¤T¤H§¡±o´£¥XÁn©ú²§Ä³¡C
[21] ½s¸¹ : U/000469
[22] ¥Ó½Ð¤é : 2025/02/12
[71] ¥Ó½Ð¤H : MULTIPLY BY EIGHT CO., LTD.
¦a§} : No. 8 Rangnam Rd., Thanon Phayathai Sub-District, Ratchathewi District, Bangkok 10400, Thailand
°êÄy : ®õ°ê
[72] µo©ú¤H : Ravi Itiravivong, Chaowalit Wiroontanawong, Nonthakan Mongkut, Setthanan Tangkhunsiri
[51] ¤ÀÃþ : A61M15/00
[54] ¼ÐÃD : Âù»«¬¯óÃħl¤J¾¹²~¡C
[57] ºKn : ¥»¹ê¥Î·s«¬¯A¤ÎÂù»«¬¯óÃħl¤J¾¹²~¡A¥]¬A²~Åé¡A³»³¡Ãä½t³B¨ã¦³¥~Á³¯¾¡A¥H±ÛÂà¤è¦¡Âê¤J²~»\°ò³¡ªº¤ºÁ³¯¾¡A²~»\¨ã¦³U§Î¼Ñ¡A¥Î©ó©ñ¸m«ü¦y¥H¦V¤W±À°Ê»\¸n³¡ªºÃä½t¡C»\¸n³¡ªº³»³¡°Ï°ì¥Ã¤[ªþ±µ¦Ü±¾Ã·¡C²~Å骺©³ºÝ¨ã¦³¤ä«ùªÚ»¯óÃÄ®e¾¹¨Ï¥Îªº¾÷ºc¡A¨ä¬°S§Î¬ð¦ù³¡¡A¥ª¥k¨â°¼¨ã¦³²`¥W¼Ñ¡A»P²Ä¤@¯óÃÄ»«¬¹j«Ç©M²Ä¤G¯óÃÄ»«¬¹j«Çªº¦ì¸m¹ï»ô¡CªÚ»¯óÃÄ®e¾¹¤º³¡¨ã¦³S§Î¤À¹j¥ó¡A¥Î©ó¤À¹j²Ä¤@¯óÃÄ»«¬¹j«Ç©M²Ä¤G¯óÃÄ»«¬¹j«Ç¡CªÚ»¯óÃÄ®e¾¹ªº³»³¡°Ï°ì³]¦³¯à©î¨øªºªÚ»¯óÃĹj«Ç»\¸n¡A¨ä¬°±a¦³S§Î¤À¹j¥óªº¶ê§Î®æ¬]¡A±q¦Ó¤¹³\»P²Ä¤@¯óÃÄ»«¬¹j«Ç©M²Ä¤G¯óÃÄ»«¬¹j«Ç¹ï»ô¦aÃö³¬¡C²~»\°ò³¡ªº¤¤¶¡°Ï°ì³]¦³S§Î¤À¹j¥ó¡A±N²~»\°ò³¡ªº¤¤¶¡°Ï°ì¤À¬°±K«Ê³¡©M»®ðÄÀ©ñ³¡¡C
ªþ¹Ï :

[30] Àu¥ýÅv : 2024/02/14¡A®õ°ê Tailândia¡A½s¸¹N.º 2403000434
[21] ½s¸¹ : U/000470
[22] ¥Ó½Ð¤é : 2025/02/12
[71] ¥Ó½Ð¤H : MULTIPLY BY EIGHT CO., LTD.
¦a§} : No. 8 Rangnam Rd., Thanon Phayathai Sub-District, Ratchathewi District, Bangkok 10400, Thailand
°êÄy : ®õ°ê
[72] µo©ú¤H : Ravi Itiravivong, Nonthakan Mongkut, Setthanan Tangkhunsiri
[51] ¤ÀÃþ : A61M15/00
[54] ¼ÐÃD : Â\°Ê´U¦¡Âù»®ð§l¤J¾¹ºÞ¡C
[57] ºKn : ¥»¹ê¥Î·s«¬¯A¤ÎÂ\°Ê´U¦¡Âù»®ð§l¤J¾¹ºÞ¡A¥]¬A¨ã¦³³æÓ»®ðÄÀ©ñ³¡¤Àªº§l¤J¾¹ºÞ¡A§l¤J¾¹ºÞÅé¨â°¼¨ã¦³ºg¾P¡AÂê©w¨ì§l¤J¾¹´U»L³¡¤Wªº¥W¼Ñ¡C¤Õ¦ì©ó§l¤J¾¹´Uªº³»ºÝ¡C¦b§l¤J¾¹ºÞÅ骺³»³¡Ãä½tªº¤¤¤ß°Ï°ì³B¨ã¦³U§Î¶}¤f§@¬°§l¤J¾¹ºÞªºÀô±øªºªÓ³¡¡AªÓ³¡ªº¥ª°¼©M¥k°¼¬O±K«Êªº¥ß¬W¡C¨Cӥ߬Wªº³»ºÝÆp¦³1Ó¤Õ¡C¨ã¦³¦ì©ó®e¯Ç§l¤J¾¹¶ñ¥Rª«ªº®e¾¹ªº¤¤¤ß°Ï°ì¤¤ªºµÄÅé¡A¥Î©ó¦w¸Ë§l¤J¾¹ºÞªº©³ºÝ¡C§l¤J¾¹ºÞªº©³ºÝ¶È¦b¤@°¼¦³U§Î¶}¤f§@¬°»®ð±µ¦¬¾¹¡A¥t¤@°¼±K«Ê¡C§l¤J¾¹ºÞªºÀô±ø±±¨î»®ð±µ¦¬¾¹ªº±ÛÂà©M©w¦ì¡A¨Ï¨ä»P®e¾¹¥ª°¼ªº²Ä¤@»®ð¶ñ¥Rª«¹j«Ç©M¥k°¼ªº²Ä¤G»®ð¶ñ¥Rª«¹j«Ç¹ï»ô¡C§l¤J¾¹ºÞÅ骺©³³¡Ãä½t©P³òªº°Ï°ì¦³¥W¼Ñ¡A»P®e¾¹ªº³»³¡Ãä½tªººg¾PÂê©w¡C
ªþ¹Ï :

[30] Àu¥ýÅv : 2024/02/14¡A®õ°ê Tailândia¡A½s¸¹N.º 2403000436
®Ú¾Ú¸g¤Q¤G¤ë¤Q¤T¤é²Ä97/99/M¸¹ªk¥O®Ö㤧¡m¤u·~²£Åvªk«ß¨î«×¡n²Ä¤Q±ø²Ä¤@´Ú¤Î²Ä¤G´Úªº³W©w¡A¤½§G¤U¦C¦b¿Dªù¯S§O¦æ¬F°Ï´£¥Xªº¹ê¥Î±M§Qµù¥U¥Ó½Ð¤§§å¥Ü¡A¨Ã«ö·Ó¦P¤@ªk³W²Ä¤G¦Ê¤C¤Q¤±ø¦Ü²Ä¤G¦Ê¤C¤Q¤C±øªº³W©w¡A¥i©ó¥»¤½§G¤é°_¤@Ó¤ë´Á¤º´N¤U¦C§å¥Ü¦Vªì¯Åªk°|´£°_¤W¶D¡C
§åµ¹
| ½s¸¹ | µù¥U¤é´Á | §å¥Ü¤é´Á | Åv§Q¤H |
| U/000400 | 2025/07/24 | 2025/07/24 | ³³®ÔÀô«O§Þ³N¡]·Hªù¡^¦³¤½¥q Tomra Recycling Technology (Xiamen) Co., Ltd. |
§ó¥¿
À³¦U¥Ó½Ð¤H¡þÅv§Q¤H¤§n¨D¡A§ó¥¿¦p¤U¡G
| ½s¸¹ | §ó¥¿¶µ¥Ø | ì¤å | À³§ï¬° |
| P/002975 (2870-M) P/002976 (2871-M) P/002977 (2872-M) P/003239 (3118-M) |
¦a§}¡]2003¦~5¤ë7¤é²Ä19´Á²Ä¤G²Õ¡m¿Dªù¯S§O¦æ¬F°Ï¤½³ø¡n¡^ | Route des Biches 10, Villars-sur-Glane, Suica | Route des Biches 10, 1752 Villars-sur-Glâne, Switzerland |
| N/236228 | ²£«~¡]2025¦~7¤ë16¤é²Ä29´Á²Ä¤G²Õ¡m¿Dªù¯S§O¦æ¬F°Ï¤½³ø¡n¡^ | ¡K ¡Kunidades de lâmpadas solares; coletores solares incineradores; bidés; lavatórios individuais ¡K ¡K | ¡K ¡Kunidades de lâmpadas solares; coletores solares; incineradores; bidés; lavatórios individuais ¡K ¡K |
¤G¹s¤G¤¦~¤C¤ë¤T¤Q¤é©ó¸gÀ٤άì§Þµo®i§½¡X¡X§½ªø ªô¼íµØ



